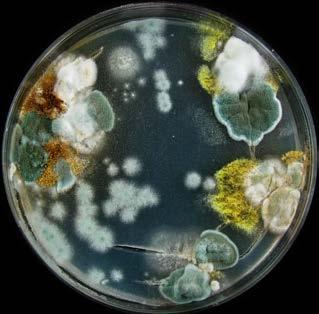

SCIENZE vi venti

Educazione
Gruppo Editoriale ELi
Il piacere di apprendere
Fabio Calvino
Rita Poletti
Marinella Torri
Il viaggio di Darwin STORYTELLING
Science Reel di Marco Martinelli Metodo IBSE

Costruire il futuro insieme
Il Gruppo Editoriale ELi
offre proposte editoriali che coprono tutti i gradi e i rami scolastici, all’insegna della qualità, del rigore e dell’innovazione.
INTELLIGENZA
ARTIFICIALE
Percorsi didattici con attività pratiche che mirano ad approfondire i principali strumenti di IA generativa per favorirne un utilizzo critico e il tool VELIA a disposizione dei docenti per personalizzare l’attività didattica.
EQUILIBRI
Progetto di ricerca costante che mira a eliminare gli stereotipi di genere nei testi scolastici ponendo particolare attenzione alla scelta dei contenuti, a una valutazione iconografica ragionata e all’utilizzo di un linguaggio testuale inclusivo.
INCLUSIONE

Sviluppo di una cultura dell’inclusione attraverso contenuti accessibili e adeguati ai diversi stili di apprendimento.
ORIENTAMENTO
Approccio educativo e formativo volto a favorire la conoscenza di sé, delle proprie attitudini e delle proprie capacità, oltre a sviluppare le competenze non cognitive e trasversali necessarie per le scelte del futuro.
EDUCAZIONE
CIVICA secondo le NUOVE Linee guida
Aggiornamento e ampliamento dei nuclei tematici attorno ai quali si articolano le competenze e gli obiettivi di apprendimento: Costituzione, Sviluppo economico e sostenibilità, Cittadinanza digitale
STEM/STEAM, CLIL
Attivazione del pensiero scientifico e computazionale, approccio interdisciplinare e laboratoriale, sviluppo della competenza multilinguistica, attraverso attività STEM, STEAM e CLIL.
DIGITALE
Acquisizione delle competenze digitali e dell’alfabetizzazione informatica come aiuto all’inclusione sociale e alla cittadinanza attiva.
EDUCAZIONE ALLE RELAZIONI
Percorsi incentrati sullo sviluppo di competenze relazionali che arricchiscono la consapevolezza del vissuto personale in relazione con la realtà circostante.
Gruppo Editoriale
Gruppo Editoriale
ELi
ELi


L ’ unit FONDAMENTALE DELLA VITA











Parla la scienza
unità 2
La classificazione degli organismi



Racconto geniale: Carlo Linneo


Lezioni in Podcast Test interattivi



TEMA 2 VIVENTI
Lo
studio dei viventi
unità 3
Il mondo dei microrganismi



Le malattie virali Il ciclo riproduttivo dei batteriofagi

Archeobatteri in vetrina
Racconto geniale:


Dai batteri alla cellula eucariote
Parla la scienza




I regni dei funghi
e delle piante
1. Le piante e le loro caratteristiche
2. Piante con il corpo
4. Le pteridofite, le
spermatofite,

3 La radice e il fusto
La traspirazione
La riproduzione vegetativa
Il fiore









unità 5
Il regno degli animali: gli invertebrati
lezione 1 Sostegno, movimento, risposta agli stimoli
1. Che cos’è un animale
La simmetria
Il celoma
4. Movimento e strutture di sostegno
5. Sensibilità e coordinamento
lezione 2 Nutrizione, respirazione, circolazione e riproduzione
1. Nutrizione e digestione
2. Respirazione
3. Circolazione ed escrezione
Riproduzione
3 Poriferi e cnidari
Gli invertebrati
Poriferi
3. Cnidari o celenterati
4 Vermi e molluschi
1. I platelminti
2. I nematodi
3. Gli anellidi
caratteristiche
Gli echinodermi



L’evoluzione degli animali

Gli adattamenti all’ambiente subaereo


Le caratteristiche degli invertebrati Molluschi in vetrina


Artropodi da record
Un insetto sotto la lente


Lezioni in Podcast Test interattivi

Listening




Pesci fuor d’acqua








TEMA 3 VIVENTI
La conservazione della natura








Parla la scienza


Biosfera e biomi
2. I biomi dei climi freddi
3. I biomi dei climi temperati
4. I biomi dei climi caldi
lezione 5 I biomi acquatici
1. La componente abiotica dei biomi acquatici
2. Il bioma marino
3. I biomi d’acqua dolce
L’importanza della biodiversità









Il comportamento appreso
L’imprinting




I biomi terrestri
Gli abitanti del mare Rischi climatici
Criosfera in pericolo
Lezioni in Podcast
La società delle termiti Lezioni


evoluzione alla luce
della genetica
L’evoluzione della vita
La teoria dell’evoluzione
1. Prima di Darwin
L’ipotesi di Lamarck
3. Le osservazioni di Darwin
4. L’evoluzione per selezione naturale
5. I pilastri della teoria dell’evoluzione
2 L’origine delle specie
1. Le prove a favore dell’evoluzione
2. Come nasce una nuova specie
3 La storia della vita
1. L’origine della vita
2. Dai batteri alla cellula eucariote
3. I principali eventi delle ere geologiche
lezione 4 Origine ed evoluzione della specie umana
1. Le somiglianze tra scimmie antropomorfe ed esseri umani
2. Dalle foreste alla savana
3. I nostri più antichi progenitori
4. L’uomo che lavorava le pietre
5. Lo scopritore del fuoco
6. La specie scomparsa
L’uomo moderno


LEZIONI IN POWERPOINT

Il viaggio di Darwin

Racconto geniale: Charles Darwin
Fringuelli famosi


Dalla generazione spontanea alla biogenesi L’esperimento di Miller



La storia del pianeta Terra La scala cronostratigrafica L’uomo di Neanderthal L’evoluzione dei primati


L’evoluzione umana


Lezioni in Podcast
Test interattivi
1 Gli acidi nucleici: il
1. Il “libretto” delle informazioni genetiche
2. La molecola del DNA
3. La duplicazione del DNA

LEZIONI IN POWERPOINT
geniale:
Parla la scienza
Racconto
Rosalind Franklin
lezione 2 La sintesi delle proteine
1. DNA e proteine
2. La molecola dell’RNA
3. Il codice genetico
4. La trascrizione, la sintesi dell’RNA messaggero
5. La traduzione delle informazioni e la sintesi delle proteine
lezione 3 Le leggi di Mendel
1. Il padre della genetica
2. Il metodo di Mendel
3. Linee pure e ibridi
4. La prima legge di Mendel
5. La seconda legge di Mendel
6. La terza legge di Mendel
lezione 4 Geni e cromosomi
1. Dai fattori di Mendel ai geni
2. Cromosomi, alleli e caratteri
3. L’interpretazione delle leggi di Mendel
lezione 5 La genetica umana
1. I cromosomi che determinano il sesso
2. La determinazione del sesso
3. I caratteri mendeliani nella specie umana
4. Le malattie genetiche autosomiche
5. Le malattie genetiche portate dai cromosomi sessuali
1. Dalla selezione artificiale all’ingegneria genetica
2. La tecnica del DNA ricombinante
Gli OGM
4. La clonazione


La sintesi delle proteine I meccanismi dell’ereditarietà Racconto geniale: Gregor Mendel






La nascita della genetica moderna Il quadrato di Punnet Il Progetto Genoma Umano I colori della pelle Le biotecnologie La pecora Dolly, il primo animale clonato


Lezioni in Podcast Test interattivi
1 VIVENTI L ’ unit fondamentale della vita
Se qualcuno ti chiedesse perché sei vivo, le tue risposte sarebbero semplici e immediate: “Perché respiro, mangio, cammino, penso...”. Eppure sono decenni che la scienza cerca di dare una definizione al fenomeno della vita, senza riuscirci fino in fondo. Malgrado secoli di discussioni, esperimenti, riflessioni e progressi scientifici, nessuna delle definizioni di “vita” proposte finora riesce a distinguere in modo soddisfacente ciò che è animato da ciò che consideriamo inanimato, non vivo. Sappiamo che gli elementi costituenti entrambe le realtà sono atomi e molecole ma è la complessità della loro organizzazione che rende gli organismi viventi capaci di svolgere funzioni uniche, come adattarsi all’ambiente e modificarsi nel tempo. La scienza che studia la vita è la biologia, un complesso di discipline molto varie che abbraccia tutti gli aspetti del mondo vivente, dalla composizione chimica delle molecole che formano gli organismi, oggetto della biologia molecolare, al funzionamento della cellula, oggetto di studio della citologia, alla classificazione dei viventi svolta dalla sistematica. È solo grazie alla collaborazione tra i molti e diversi settori della biologia che la scienza riesce a progredire nella comprensione del fenomeno della vita.






La cellula unità 1 degli organismi La classificazioneunità 2
GIACOMO ROSA, dottorandoinZoologiaeBiologia della Conservazione
Giacomo si è laureato in Scienze dei Sistemi Naturali presso l’Università di Genova, dove lavora. Si occupa della gestione e conservazione di anfibi e rettili della Liguria e ha partecipato a numerosi progetti di ricerca su questi animali, in Italia e in Francia. È socio della Societas Herpetologica Italica e autore di numerosi articoli scientifici.

ROBERTA TOTA, naturalista


La grande passione di Roberta per la natura le ha fatto scegliere la facoltà di Scienze naturali e poi la specializzazione in Biologia dell’ambiente. Ama la fotografia naturalistica ed è sensibile ai temi della salvaguardia dell’ambiente e della biodiversità. Oggi Roberta lavora in un Museo di Scienze Naturali dove si occupa della tutela, della conservazione e della valorizzazione dei beni naturalistici.
FRANCESCO DELVILLANI, insegnantediScienze
Dopo la laurea in Biologia, Francesco ha lavorato per oltre quattro anni in università come ricercatore, ma poi ha deciso di intraprendere la carriera di docente e oggi insegna matematica e scienze nella scuola secondaria di primo grado. È un professore attento a promuovere e a stimolare le capacità di alunni e alunne, attivando nella scuola sempre nuovi progetti.
Carlo Linneo

PARLA LA SCIENZA
La cellula unità 1 VIVENTI
lezione 1
le caratteristiche dei viventi
lezione 2
I viventi sono costituiti da cellule
VISUAL

lezione 3
Un modello vincente
La struttura della cellula
lezione 4
La riproduzione della cellula

LEZIONI POWERPOINT in


BUONE NOTIZIE PER IL FUTURO
Imitare le piante per produrre energia
La capacità dei vegetali di utilizzare l’energia solare per produrre sostanze nutritive potrà presto diventare anche per noi una grande opportunità.
Gli scienziati lavorano da anni sulla fotosintesi artificiale, un processo chimico simile a quello compiuto dai vegetali, ma capace di produrre carburanti alternativi ai combustibili fossili e permettere transizione energetica sostenibile.
Nei laboratori si stanno sperimentando diversi tipi fotocatalizzatori capaci di assorbire l’energia e di immagazzinarla per utilizzarla
L’ossido di ferro, per esempio, una sostanza molto comune ed economica, è in grado di favorire la scissione della molecola dell’acqua. Con la scissione della molecola di acqua si potrebbero risolvere due problemi: quello energetico, in quanto l’idrogeno che si forma è un ottimo combustibile, e quello ambientale, perché la reazione non libera anidride carbonica né altri gas responsabili del riscaldamento . Grazie all’energia accumulata con la fotosintesi artificiale sarà possibile produrre anche altri tipi di combustibili.
SCIENCE REEL


Virus: sono davvero vivi?
Le caratteristiche dei viventi lezione 1

Vivente o non vivente?
Guarda il video e scrivi le risposte sul quaderno.
1. Perché non è sempre semplice distinguere un essere vivente da un oggetto inanimato? Indica almeno un esempio che può trarre in inganno.
2. Ti è mai capitato di confondere un animale con una pianta?
3. Come si chiama la disciplina che si occupa dello studio degli esseri viventi? Qual è la sua etimologia?
ORA FERMA L’IMMAGINE!
Rivedi il video, trova le immagini e scrivi per ciascuna una didascalia.


1 Le caratteristiche comuni degli esseri viventi
Anche se sono molto diversi l’uno dall’altro, gli organismi viventi possiedono un insieme di caratteristiche comuni che ci consentono di affermare che sono vivi. Gli esseri viventi:
• sono costituiti da cellule;
• ricavano dall’ambiente sostanze nutritive ed energia, cioè si nutrono;
• respirano e producono rifiuti che eliminano;
• si muovono (almeno in una fase della loro vita);
• reagiscono agli stimoli;
• si adattano al proprio ambiente;
• crescono;
• si riproducono;
• infine muoiono.
Nutrirsi, respirare, muoversi, reagire agli stimoli, adattarsi al proprio ambiente, crescere, riprodursi e morire sono le funzioni vitali degli organismi.
La scienza che studia gli esseri viventi è la biologia
2 Gli esseri viventi sono costituiti da cellule
La cellula è la più piccola unità dei viventi. Vi sono esseri viventi unicellulari, cioè costituiti da una sola cellula capace di svolgere tutte le funzioni vitali e organismi pluricellulari, cioè costituiti da più cellule organizzate tra loro.
3 Gli esseri viventi si nutrono
Gli esseri viventi devono procurarsi le sostanze nutritive di cui hanno bisogno. Le piante, grazie alla luce del Sole, trasformano l’acqua, i sali minerali e l’anidride carbonica ricavati dall’ambiente nelle sostanze nutritive di cui hanno bisogno. Questo processo è chiamato fotosintesi
Gli animali, a differenza delle piante, non sono in grado di fabbricare le sostanze nutritive di cui hanno bisogno; devono perciò nutrirsi di altri esseri viventi 1 .
Le piante sono organismi autotrofi.
Gli animali sono organismi eterotrofi
Un tipo particolare di organismi eterotrofi sono i funghi: non sono in grado di produrre sostanze nutritive e non possono neppure mangiare e digerire altri organismi. Per questo si nutrono grazie all’assorbimento delle sostanze prodotte da altri organismi oppure le ricavano dai resti di organismi morti in decomposizione 2


1 A ognuno il suo cibo.
a) La mucca è erbivora. b) La volpe è carnivora. c) Il corvo è onnivoro.


4 Gli esseri viventi respirano ed eliminano rifiuti
Oltre alle sostanze nutritive, gli esseri viventi ricavano dal cibo anche l’energia necessaria per compiere le funzioni vitali.
La respirazione è il processo che permette agli organismi di trarre energia dagli alimenti. a b c
Attraverso la respirazione gli esseri viventi introducono nel loro organismo ossigeno (un gas presente nell’aria e nell’acqua) e lo utilizzano per trasformare gli zuccheri e liberare energia e anidride carbonica. Esistono tuttavia altri modi di estrarre energia dagli alimenti: per esempio i lieviti, i microrganismi aggiunti all’impasto del pane e della pizza ricavano energia dagli zuccheri senza bisogno di ossigeno, grazie a un processo chiamato fermentazione.
Nel corso delle numerose trasformazioni che gli alimenti subiscono per essere utilizzati dagli organismi, vengono prodotte anche sostanze di rifiuto. Questi materiali sarebbero dannosi se si accumulassero all’interno dell’organismo; pertanto devono essere eliminati e riversati nell’ambiente.
Il processo di eliminazione delle sostanze di rifiuto è chiamato escrezione.
2 I funghi assorbono le sostanze nutritive dalla pianta su cui crescono.


Gli esseri viventi si muovono e reagiscono agli stimoli
Quasi tutti gli animali si muovono utilizzando zampe, ali, pinne, piedi o altre strutture . Grazie al movimento gli animali si procurano il cibo, sfuggono ai pericoli, si spostano negli ambienti che presentano condizioni favorevoli alla loro sopravvivenza. Le piante, invece, appaiono per lo più ferme; in realtà compiono dei movimenti in risposta a stimoli provenienti dall’esterno. I girasoli, per esempio, ruotano le foglie e i fiori in risposta a uno stimolo luminoso, i raggi di Sole; la mimosa pudica, invece, risponde a uno stimolo tattile e se toccata ripiega le sue foglioline in un decimo di secondo 4 .
In genere gli animali percepiscono gli stimoli che provengono dall’esterno (rumori, odori, luce, variazioni di temperaorgani di senso. Sono poi in grado di reagire a essi, modificando il proprio aspetto oppure il comportamento.
Gli
esseri viventi si adattano al proprio ambiente
Quando cambiano le condizioni di vita, gli esseri viventi modificano, entro certi limiti e in tempi molto lunghi, le proprie funzioni biologiche o l’organizzazione corporea. Queadattamento.
7 Gli esseri viventi nascono, crescono e si riproducono
Gli animali, le piante e i funghi nascono da individui della stessa specie, simili in tutto a loro, e poi crescono, cioè aumentano le loro dimensioni e il loro peso.
Gli animali crescono fino a quando raggiungono l’età adulta. Le piante, se sono nelle condizioni adatte, continuano a crescere per tutta la durata della loro vita.
Ogni organismo è capace di generare altri esseri viventi in tutto simili a se stesso, assicurando così la sopravvivenza della specie alla quale appartiene. Questa particolare caratteristica degli esseri viventi si chiama riproduzione
La riproduzione può essere asessuata, se avviene con l’intervento di un solo organismo, oppure sessuata, se intervengono un individuo maschio e un individuo fem mina. Nella riproduzione sessuata il nuovo individuo si forma a partire dall’unione di due cellule specializzate: il gamete maschile e il gamete femminile. Questa funzione è chiamata fecondazione
La sequenza di avvenimenti che si ripete sempre uguale nel corso della vita di ogni
4 Il girasole ruota le foglie e i fiori in direzione del Sole per ricevere più luce.

essere vivente si chiama ciclo vitale. Il ciclo vitale di un organismo inizia con la sua nascita e continua con il suo sviluppo, per poi terminare con la morte, processo che può avvenire per cause accidentali o per l’invecchiamento dell’organismo. Per questo, la durata della vita è un carattere che varia da specie a specie.
Quali sono gli animali che vivono più a lungo?
Gli elefanti e le tartarughe sono gli animali terrestri più longevi. L’elefante può arrivare a vivere fino a 70 anni mentre la tartaruga delle Galapagos vive in media fino a 100 anni, anche se molti esemplari li hanno abbondantemente superati. Il primato di longevità spetta però a un mammifero acquatico: la balena della Groenlandia, Balaena mysticetus, che può vivere fino a 200 anni!
FISSA I CONTENUTI
ESSENZIALI



Completa le frasi con i termini corretti. lunghi cellule autotrofi asessuata adattamento eliminazione
1. Gli esseri viventi sono costituiti da
2. Il processo di delle sostanze di rifiuto è chiamato escrezione.
3. Gli esseri viventi si riproducono esclusivamente per via sessuata e .
4. L’ è la capacità degli organismi di adattarsi alle variazioni ambientali in tempi molto
5. Le piante sono organismi .
VERSO LE COMPETENZE
Il disegno mostra il ciclo vitale delle rane. Completa con i termini corretti le frasi che descrivono le tappe del processo.
1. Le uova sono deposte dalla femmina nell’acqua. È il segnale che è avvenuta la .

4. La durata della vita di una rana è di circa cinque anni: il ciclo vitale si conclude con la dell’animale.
3. I girini gradualmente subiscono molti cambiamenti.
La e lo sviluppo del corpo trasformano i giriniin rane adulte.
2. Dalle uova fecondate escono i piccoli della rana, i girini. Questa fase del ciclo vitale è la .
i viventi sono costituiti da cellule lezione 2
LAB STEM
TESSUTI ANIMALI E VEGETALI AL MICROSCOPIO
Basta un microscopio ottico piuttosto semplice per osservare dei tessuti, cioè degli insiemi di cellule dello stesso tipo.
■ REALIZZA L’ESPERIMENTO
MATERIALI
• un microscopio ottico
• vetrini portaoggetto e coprioggetto
• un contagocce
• acqua
• bastoncini cotonati
• una cipolla
• una pinzetta






PROCEDIMENTO
1. Inizia con la preparazione del campione di tessuto animale. Usa il bastoncino cotonato per strofinare l’interno della tua guancia e disponi i frammenti di tessuto sul vetrino portaoggetto. Preleva un po’ d’acqua con il contagocce e versa una goccia sul campione, poi ricopri il tutto con il vetrino coprioggetto.
2. Prepara il campione di tessuto vegetale. Preleva con la pinzetta un frammento di pellicola di cipolla dalla parte viva e umida. Fai in modo che sia il più sottile possibile. Appoggia la pellicola sul vetrino e coprila con il vetrino coprioggetto.
3. Ora puoi procedere con l’osservazione dei due campioni: inizia con un ingrandimento 100× e poi passa a 400×
■ OSSERVA E RISPONDI
1. Che forma hanno le cellule che costituiscono il tessuto prelevato all’interno della tua bocca?
2. Che forma hanno le cellula della cipolla?
3. Quale dei due tipi di cellula ha una forma più regolare?
4. Che cosa riesci a vedere all’interno delle cellule? È visibile in entrambe un grosso corpuscolo di forma sferica?
5. Osservi altri particolari che distinguono la cellula animale da quella vegetale?
6. Scrivi la relazione dell’esperimento.
Che cos’è la cellula
Ti sei mai fermato a osservare la varietà degli edifici che trovi lungo la strada che ti porta a scuola? Piccoli condomini, villette, palazzi, anche se diversi hanno molti elementi in comune: per esempio, hanno porte e finestre, impianti idraulici ed elettrici, un tetto e sono generalmente costruiti con mattoni. Lo stesso si può dire per gli esseri viventi. All’apparenza sono molto diversi per forma, dimensioni, tipo di movimento, modo di nutrirsi, ma tutti hanno una caratteristica in comune: sono fatti di cellule
La cellula è la più piccola unità dei viventi in grado di svolgere tutte le funzioni vitali.
Per esprimere le dimensioni delle cellule bisogna ricorrere a un’unità di misura molto piccola, il micrometro. Un micrometro equivale a un millesimo di millimetro e si indica con il simbolo µm. Pensa che il nostro occhio da solo non può distinguere oggetti più piccoli di 0,1 mm, cioè 100 µm!
2 Organismi unicellulari e organismi pluricellulari
Una cellula può costituire da sola un vero e proprio organismo: in questo caso si parla di organismo unicellulare. Sono organismi unicellulari i batteri, formati da un tipo di cellula molto semplice, la cellula procariote delle dimensioni di pochi micrometri.. Piante, funghi e animali sono organismi pluricellulari, formati cioè da un grandissimo numero di cellule 1 . Le cellule dei pluricellulari sono cellule eucariote: sono più grandi delle procariote e presentano una struttura e un’organizzazione molto più complesse. Esistono anche organismi unicellulari formati da una sola cellula eucariote, per esempio i lieviti, le muffe 2 , le alghe unicellulari e i parameci.



3 L’organizzazione degli organismi pluricellulari
Negli unicellulari, come un batterio e un paramecio, la cellula costituisce l’intero organismo. Nei pluricellulari, invece, le cellule si specializzano e assumono forme specifiche in relazione alle funzioni che svolgono. Per questo motivo una cellula che costituisce un muscolo è diversa da una cellula che costituisce, per esempio, il cervello. Le cellule che svolgono lo stesso compito presentano forma e dimensione uguali; costituiscono un tessuto, specializzato per esempio nel proteggere l’organismo, produrre delle sostanze oppure farlo muovere.
2 Coltura di laboratorio di diversi tipi di muffe.
1 Lo scoiattolo e il
Foto al microscopio di una cellula ossea.
Foto al microscopio di tessuto osseo.
La vertebra è un organo. Le ossa della tigre formano il suo sistema scheletrico.
ANIMALI




La tigre è un organismo.
Cellula
La cellula è l’unità costitutiva di base di tutti i viventi.
Tessuto
Un tessuto è l’insieme di cellule tra loro simili, che svolgono la stessa funzione. Piante e animali possiedono tessuti per sostenere e rivestire il corpo e per trasportare sostanze.
Organo
Un organo è l’insieme di tessuti diversi che cooperano per svolgere una funzione vitale.
Apparato o sistema
Quando più organi collaborano allo svolgimento di una stessa funzione, si forma un sistema oppure un apparato: un sistema è costituito da più organi formati dallo stesso tessuto; un apparato è un insieme di organi formati da tessuti diversi.

3 I livelli di organizzazione negli animali e nelle piante.
Organismo
Un organismo è formato dall’insieme degli apparati e dei sistemi e rappresenta il livello di organizzazione più alto.
PIANTE





Foto al microscopio di una cellula di foglia.
Foto al microscopio del tessuto che riveste una foglia.
La foglia è un organo.
Le foglie formano l’apparato fogliare dell’albero.
La betulla è un organismo.
I tessuti, a loro volta, sono organizzati in organi, poi in sistemi o apparati e infine in un organismo 3
4
Gli strumenti che permettono di osservare la cellula
A parte poche eccezioni, le cellule sono invisibili a occhio nudo. Per poterle osservare occorre utilizzare il microscopio, uno strumento capace di ingrandire le immagini di oggetti molto piccoli, dell’ordine del micrometro. I laboratori scolastici sono generalmente attrezzati con microscopi ottici che possono ingrandire di centinaia di volte i preparati da osservare 4 . I campioni da osservare devono essere trasparenti alla luce prodotta dalla lampada collocata sotto il tavolino portaoggetti; per questo i preparati da porre sul vetrino devono essere estremamente sottili.
Le parti del microscopio che effettivamente ingrandiscono l’immagine di un oggetto sono le lenti, cioè l’oculare e l’obiettivo. L’obiettivo produce una prima immagine ingrandita dell’oggetto da osservare; questa, a sua volta, viene ulteriormente ingrandita dall’oculare
Lo stativo è la parte di sostegno del microscopio; contiene anche il tavolino portaoggetti sul quale viene posto il vetrino con il campione da osservare.


Per conoscere l’ingrandimento fornito dal microscopio occorre moltiplicare il numero scritto sull’oculare per il numero scritto sull’obiettivo utilizzato. Se per esempio sull’oculare è scritto 10× e sull’obiettivo 40×, l’ingrandimento totale è 10 × 40, cioè di 400 volte.
Il potere di ingrandimento di un microscopio ottico può essere potenziato fino a 2000 volte con vari accorgimenti, per esempio montando un maggior numero di lenti oppure utilizzando lenti più potenti. Tuttavia non è possibile aumentare il potere di risoluzione, cioè la capacità dello strumento di mettere a fuoco l’immagine mantenendo le proporzioni dell’oggetto che si osserva. Questo accade perché il microscopio ottico sfrutta le onde che formano la luce, che possiedono certe caratteristiche.
Negli anni ’50 del secolo scorso è stato inventato il microscopio elettronico che, invece della luce visibile, utilizza gli elettroni, particelle contenute negli atomi 5 . Il microscopio elettronico riesce a ingrandire un oggetto fino a 100 000 volte e il suo potere di risoluzione permette di osservare strutture delle cellule migliaia di volte più piccole di quelle che si possono vedere con un buon microscopio ottico 6
Grazie al microscopio elettronico è possibile osservare i componenti più piccoli delle cellule.
FISSA I CONTENUTI ESSENZIALI
Segna con una crocetta se vero (V) o falso (F).
1. Gli organismi unicellulari sono tutti procarioti.
2. Le cellule dei pluricellulari sono cellule eucariote.
Le lenti dell’oculare e dell’obiettivo costituiscono la parte ottica.
Una lampada a intensità regolabile illumina i preparati da osservare. Nei microscopi meno recenti la lampada è sostituita da uno specchietto.


6 Granuli di polline al microscopio elettronico.
3. Il microscopio ottico è lo strumento con il massimo ingrandimento.
4. Il microscopio elettronico può ingrandire fino a 100000 volte.
5 Il microscopio elettronico.
Come funziona il microscopio ottico
VISUAL vincente Un modello

Esistono cellule con forme e dimensioni molto diverse, a seconda delle funzioni che svolgono e dell’ambiente in cui vivono, ma tutte presentano un modello base comune, formato dalla membrana plasmatica, dal citoplasma e dal materiale genetico. Sembra semplice ma è un modello vincente, perché ha reso possibile l’evoluzione della vita nelle innumerevoli forme che conosciamo.
DUE FLAGELLI PER MUOVERSI MEGLIO
Le Chlamydomonas sono alghe unicellulari che si muovono grazie a due flagelli. In particolari condizioni ambientali possono produrre gas idrogeno invece che ossigeno.
Gli scienziati sperano di poterle usare per la produzione industriale dell’idrogeno, un combustibile che libera grandi quantità di energia, senza emettere anidride carbonica.
CELLULE CON LE GEMME
Anche i funghi, infatti, sono formati da cellule eucariote. Le cellule fungine non possiedono cloroplasti, perché i funghi non sono organismi autotrofi, ma come le cellule vegetali sono rivestite da una parete cellulare composta non da cellulosa ma da chitina, un polisaccaride presente anche nelle strutture animali, per esempio nel rivestimento esterno degli insetti.
CELLULE CON LA PARETE



La forma delle cellule vegetali che costituiscono il tessuto epiteliale è determinata dalla presenza della parete cellulare. Le cellule, appiattite e di forma regolare, aderiscono strettamente le une alle altre come piastrelle di un pavimento e formano un tessuto resistente agli attacchi degli agenti esterni.






CELLULE CAPACI DI ALLUNGARSI E DI ACCORCIARSI


Le cellule dei tessuti muscolari hanno una forma stretta e allungata perché devono contrarsi e rilassarsi; in questo modo permettono il movimento del corpo e delle sue componenti. Per esempio, le cellule che costituiscono il tessuto cardiaco devono continuamente contrarsi perché il cuore possa pulsare e pompare il sangue.





UNA FORMA PER INGLOBARE
La cellula di un’ameba ha la membrana capace di allungarsi e di formare dei prolungamenti, gli pseudopodi (che significa “falsi piedi”).
Grazie agli pseudopodi l’ameba può muoversi ma anche circondare e inglobare i microrganismi e le particelle di cibo.
CELLULE ADATTE A COMUNICARE
I neuroni, le cellule del tessuto che forma il cervello e i nervi, ricevono e trasmettono gli impulsi nervosi. Per comunicare meglio con le cellule vicine, il neurone ha una forma stellata. Un neurone è composto dal corpo cellulare, che contiene il nucleo, dai dendriti, le ramificazioni che ricevono le informazioni dall’ambiente, e dall’assone, lungo il quale viaggiano i segnali verso altri neuroni.
UNA CELLULA CON UN APPARATO DIGERENTE
Il paramecio è un organismo formato da un’unica cellula eucariote. Il cibo entra dall’apertura orale, è digerito dai vacuoli alimentari e i rifiuti sono espulsi dal poro anale. Si può dire che il paramecio possiede un primitivo apparato digerente formato da organuli cellulari!

La struttura della cellula lezione 3
CARTA PENNA COMPUTER

Guarda il video e scrivi le risposte sul quaderno.
1. Chi osservò per primo un organismo microscopico?
2. Quale teoria formularono i biologi basandosi sulle osservazioni al microscopio?
3. Quali sono i punti fondamentali di questa teoria?
ORA FERMA L’IMMAGINE!
Rivedi il video, trova l’immagine e spiega che cosa rappresenta.
4. Chi fu lo scienziato che utilizzò il termine “cellula”?

CONTENUTI DIGITALI
DNA membrana plasmatica citoplasma
1 Le parti fondamentali della cellula
Osservando alcune cellule al microscopio, i biologi si sono accorti che compaiono sempre tre parti fondamentali 1

Le parti fondamentali della cellula sono la membrana plasmatica, il DNA e il citoplasma.
La membrana plasmatica, o membrana cellulare, è un rivestimento sottile ed elastico che delimita la cellula e la separa dall’ambiente esterno. È composta da molecole di varia natura che le conferiscono due caratteristiche peculiari: non è rigida e può “riconoscere” le cellule adiacenti. Attraverso la membrana plasmatica entrano le sostanze necessarie alla cellula ed escono i prodotti di rifiuto o altre sostanze prodotte dalla cellula.
1 La foto al microscopio mostra le parti fondamentali.
La teoria cellulare
Il DNA è il materiale genetico che contiene tutte le informazioni necessarie alla vita della cellula e dell’organismo. Il citoplasma è una sostanza gelatinosa costituita da acqua, sali minerali e sostanze organiche che riempie l’interno della cellula; nel citoplasma sono immersi gli organuli, piccole strutture specializzate nello svolgimento di una funzione particolare.
2 La cellula procariote
Come anticipato, esistono due tipi di cellule: la cellula procariote e la cellula eucariote, che differiscono tra loro per la complessità strutturale.
La cellula procariote ha una struttura relativamente semplice e forma solo organismi unicellulari 2 . Essa è priva di nucleo, cioè di un compartimento interno in cui conservare il DNA; di conseguenza il materiale genetico è immerso nel citoplasma. Questo tipo di cellula è protetto da un rivestimento esterno chiamato parete cellulare, che dà sostegno e conferisce una certa forma alla cellula. Al di sotto della parete cellulare si trova una sottile membrana plasmatica. Il citoplasma contiene un solo tipo di organuli, i ribosomi, che hanno la funzione di formare le proteine.
2
Organizzazione della cellula procariote.
La cellula procariote di molti batteri è dotata di flagelli, lunghi filamenti che, ruotando come eliche, permettono il movimento nei liquidi. La superficie cellulare, inoltre, è ricoperta da strutture più corte e sottili, i pili.
Nel citoplasma sono immersi numerosi ribosomi, gli organuli che producono le proteine.

Membrane a mosaico
Alcuni batteri possiedono, oltre alla parete cellulare e alla membrana plasmatica, anche una capsula, un rivestimento che avvolge la parete e protegge la cellula dalla disidratazione.
Il citoplasma contiene un filamento di DNA, localizzato nella zona della cellula chiamata nucleoide. Spesso sono presenti altri piccoli anelli di DNA, i plasmidi, responsabili della resistenza agli antibiotici manifestata da molti batteri che causano malattie.
LAB TINKERING
3
La cellula eucariote animale
La cellula eucariote ha una struttura più complessa della cellula procariote e può essere animale o vegetale.
L’elemento che la contraddistingue è un corpuscolo sferico nel citoplasma, il nucleo, il “centro di controllo” di tutti i processi vitali della cellula. Nel citoplasma, oltre al nucleo, sono presenti numerosi organuli cellulari con forme e funzioni diverse. I più importanti sono i mitocondri, il reticolo endoplasmatico, i ribosomi, l’apparato di Golgi, i centrioli, i lisosomi e i vacuoli 3 .
3 Organizzazione della cellula eucariote animale. La membrana plasmatica separa e protegge la cellula, con tutto il suo contenuto, dall’ambiente circostante.
I flagelli sono sottilissimi filamenti che permettono alla cellula di spostarsi.
L’apparato di Golgi è formato da un insieme di tubuli e vescicole dove si accumulano le proteine.
Il reticolo endoplasmatico è un organulo costituito da numerose membrane, ripiegate a formare una serie di tubi e di sacche appiattite; trasporta sostanze all’interno del citoplasma.
I centrioli sono organuli di forma cilindrica; hanno un importante ruolo nella divisione cellulare.

I mitocondri sono organuli a forma di fagiolo dove avviene la respirazione cellulare, cioè la “combustione controllata” degli zuccheri necessaria per fornire l’energia alle cellule.

I ribosomi sono piccoli organuli che si trovano sia liberi nel citoplasma sia legati al reticolo endoplasmatico. Hanno il compito di costruire le proteine
I lisosomi sono piccole vescicole contenenti sostanze che distruggono le strutture cellulari danneggiate e non più utilizzabili.
Il nucleo è un organulo separato dal citoplasma dalla membrana nucleare
Il nucleo contiene uno o più nucleoli, piccoli corpi sferici in cui si svolgono importanti reazioni chimiche, e una massa granulosa, la cromatina
I vacuoli sono vescichette di deposito; contengono acqua e sostanze di riserva.
4 La cellula eucariote vegetale
La cellula vegetale ha di norma una forma più squadrata di quella animale 4 . Inoltre, si differenzia da quella animale perché, oltre che dalla membrana plasmatica, è delimitata da un rivestimento più esterno, la parete cellulare
La parete cellulare è formata da cellulosa, una sostanza che conferisce alla cellula una certa rigidità. Parete cellulare e membrana plasmatica delimitano e proteggono il citoplasma, all’interno del quale si trova il nucleo.
Esploriamo la cellula eucariote
SKILL BOOK
UNA CELLULA DA MANGIARE
I piccoli organuli allungati e verdi che si vedono all’interno del citoplasma sono i cloroplasti. Essi contengono la clorofilla, una sostanza verde in grado di “catturare” l’energia del Sole e avviare il processo di fotosintesi che permette alla pianta di fabbricarsi il proprio nutrimento. I cloroplasti sono presenti solo nelle cellule delle foglie e delle altre parti verdi delle piante; sono assenti in quelle che costituiscono le strutture che si sviluppano sotto terra come le radici, i bulbi e i tuberi. La parete cellulare è un involucro solido e rigido che delimita la cellula vegetale e la collega alle cellule vicine. La cellulosa, uno zucchero complesso di cui è costituita, permette alle piante di sollevarsi dal terreno.
La parete cellulare è un involucro solido e rigido che delimita la cellula vegetale e la collega alle cellule vicine.
Il vacuolo delle cellule vegetali adulte è voluminoso: può occupare fino al 90% del volume della cellula. Al suo interno si accumulano acqua e altre sostanze presenti nel citoplasma.
I cloroplasti sono organuli delimitati da una doppia membrana. Contengono delle vescicole nelle quali si accumula la clorofilla, la sostanza necessaria nel processo di fotosintesi.
FISSA I CONTENUTI ESSENZIALI
4 Organizzazione della cellula eucariote vegetale.
reticolo endoplasmatico
nucleo
mitocondrio
Completa le frasi con i termini corretti. mitocondri ribosomi membrana nucleare parete cellulare cloroplasti
1. I sono organuli che hanno il compito di costruire le proteine.
2. Il nucleo è separato dal citoplasma dalla
3. I sono organuli a forma di fagiolo dove avviene la respirazione cellulare.
4. La è un involucro solido e rigido che delimita la cellula vegetale.
5. I sono organuli delimitati da una doppia membrana e contengono la clorofilla.
VERSO LE COMPETENZE
Visitate il sito www.cellsalive.com
Esplorate la sezione che contiene i modelli interattivi della cellula animale e della cellula vegetale, e traducete in italiano i termini che compaiono sui disegni.
Dividete la classe in due gruppi e ciascuno realizzi un cartellone con i disegni della cellula animale e della cellula vegetale con la denominazione in italiano e in inglese degli organuli cellulari. Alla fine del lavoro, potete sfidarvi a chi completa per primo i puzzle interattivi dei modelli delle cellule!
lisosoma
apparato di Golgi
La riproduzione della cellula lezione 4
CARTA PENNA COMPUTER

Una riproduzione rapidissima
Guarda il video e scrivi le risposte sul quaderno.
1. Che cosa permette la riproduzione cellulare agli esseri viventi unicellulari? E a quelli pluricellulari?
2. Come si chiama la riproduzione propria dei batteri?
3. Rifletti: quale caratteristica rende più complessa la riproduzione di una cellula eucariote rispetto a quella di un batterio?
ORA FERMA L’IMMAGINE!
Che cosa rappresentano i disegni?
Scrivi una didascalia per ciascuna immagine.


1 Le cellule si riproducono
Quando una cellula ha raggiunto una determinata dimensione, è pronta per la riproduzione: si divide in due “cellule figlie”, ciascuna delle quali riceve gli stessi materiali della cellula di partenza, la “cellula madre”. Le cellule figlie si accresceranno e diventeranno identiche alla cellula madre e fra di loro; poi anch’esse si divideranno e comincerà un nuovo ciclo. Attraverso la riproduzione, gli organismi unicellulari si moltiplicano; gli organismi pluricellulari, invece, si accrescono in dimensione, dalla nascita fino all’età adulta, perché aumenta il numero delle cellule che formano il loro corpo 1
La riproduzione cellulare è necessaria, inoltre, per sostituire
le cellule danneggiate, invecchiate o comunque non più in grado di svolgere il loro compito, come le cellule della pelle che sono continuamente rimpiazzate da nuove cellule.

1
Anche le piante, come gli animali, crescono aumentando il numero di cellule dei propri tessuti.
CONTENUTI DIGITALI
2 La riproduzione della cellula procariote
Le cellule procariote si dividono per scissione binaria, un meccanismo di riproduzione molto semplice 2 . Poco prima che avvenga la scissione binaria, il DNA si duplica. Poi nella membrana plasmatica della cellula madre si forma una strozzatura, un anello simile al cordone di una borsa. A mano a mano che l’anello si stringe, il DNA e il citoplasma si distribuiscono in modo uguale nelle due parti della cellula. Infine, la cellula si divide in due metà identiche, le cellule figlie. I batteri, che sono organismi procarioti, si riproducono con questo meccanismo.
CELLULA MADRE
DNA membrana plasmatica
parete cellulare

La membrana plasmatica forma una strozzatura.
cellule figlie



2
3
CELLULE FIGLIE

Prima della scissione binaria il DNA si duplica, cioè crea una copia di se stesso.




La membrana plasmatica si riforma completamente.
La riproduzione della cellula eucariote
La cellula madre si divide in due cellule figlie, ognuna delle quali riceve una copia completa di DNA e la sua parte di citoplasma e organuli.
Le cellule eucariote si dividono con un processo più complesso rispetto alla scissione binaria: la mitosi. Prima che il citoplasma si divida, è necessario che il nucleo e il suo contenuto si duplichino, in modo che ognuna delle due cellule che si formano abbia un nucleo identico a quello della cellula di partenza.
La mitosi di una cellula è un processo rapido e continuo; tuttavia, per descriverla meglio, viene suddivisa in quattro momenti diversi, o fasi: profase, metafase, anafase e telofase 3 (a pagina seguente).
Con la formazione dei due nuclei la mitosi si conclude e ha inizio la citodieresi, durante la quale anche il citoplasma si divide e si formano due cellule figlie identiche e indipendenti. La citodieresi avviene in modo diverso nelle cellule animali e in quelle vegetali. Nelle cellule animali la membrana cellulare si strozza al centro, fino a che le due cellule figlie si separano.

Nelle cellule vegetali invece si forma un ispessimento, la piastra cellulare, dalla quale si forma la nuova parete cellulare che separerà le due cellule figlie 4 (a pagina seguente).
La scissione binaria.
3 Le fasi della mitosi.
Profase
Il DNA contenuto nel nucleo prende l’aspetto di bastoncini ben visibili al microscopio, i cromosomi. Ogni cromosoma fa una copia di se stesso per assicurare alle nuove cellule lo stesso numero di informazioni e non la metà. Nel citoplasma inizia a formarsi il fuso mitotico, una struttura costituita da lunghe fibre (microtubuli) che guiderà i movimenti dei cromosomi durante la mitosi.
Profase
I centrioli si spostano alle parti opposte del nucleo; la membrana nucleare si dissolve e tra i centrioli si tendono i microtubuli.
Metafase
Metafase
I cromosomi raddoppiati, ancorati alle fibre del fuso, vengono trascinati al centro della cellula.
Anafase
Anafase
I cromosomi raddoppiati, che nella metafase erano ancora congiunti in una ristretta zona, si separano completamente. Ciascuno dei due cromosomi migra a un polo della cellula, trascinato dalla contrazione della fibra del fuso alla quale è legato.
Telofase
Telofase Il fuso scompare; ai due poli opposti della cellula si riformano due nuovi nuclei.
nucleo

nucleolo




membrana nucleare
fuso mitotico in formazione



piano equatoriale









4 In questa fotografia al microscopio di una radice di cipolla, si possono osservare alcune fasi della mitosi.

cromosomi 5 La citodieresi.




centrioli
cromosoma
microtubuli
La mitosi
4
Il ciclo cellulare
Una volta formate, le due cellule figlie non si riproducono subito. Prima che inizi una nuova mitosi devono accrescersi fino a raggiungere le dimensioni della cellula madre e fabbricare nuovi materiali.
Nella cellula eucariote, la sequenza di eventi che si verifica tra una divisione cellulare e la successiva prende il nome di ciclo cellulare. Il ciclo cellulare è distinto in due momenti principali: l’interfase e la fase M 6 . L’interfase è la fase di preparazione della cellula alla fase M; comprende tre fasi denominate G1, S e G2. La fase M comprende la mitosi, cioè la divisione del nucleo, e la citodieresi, cioè la divisione del citoplasma. Il ciclo cellulare è comune a tutte le cellule, ma il tempo che trascorrono in ciascuna delle diverse fasi può variare da cellula a cellula.
FISSA I CONTENUTI
Nella fase G1 la cellula aumenta le proprie dimensioni e produce nuovi materiali.
CitodieresiTelofaseAnafaseMetafase
ESSENZIALI
Segna con una crocetta se vero (V) o falso (F).
1. Gli organismi procarioti si riproducono per scissione binaria.
2. La scissione binaria è un processo riproduttivo velocissimo.
3. Il DNA si duplica durante l’interfase.
4. L’anafase è il primo processo della mitosi.
5. I centrioli entrano in gioco nella formazione del fuso mitotico.
6. La telofase conclude la mitosi.
VERSO LE COMPETENZE STEM
Organizzate la classe in piccoli gruppi. Partendo dai disegni che illustrano la mitosi, ciascun gruppo realizza il modellino di una delle fasi usando materiali facilmente reperibili: per esempio carta, plastica ottenuta da bottiglie o da contenitori per alimenti, cannucce, pasta per modellare, ovatta. Al termine del lavoro la classe, sotto la guida dell’insegnante, compie le operazioni necessarie alla realizzazione di un filmato.
Nella fase S avviene la duplicazione del DNA.
si prepara alla mitosi.
Per prima cosa vengono scattate delle fotografie con lo smartphone o il tablet, che sono poi condivise in una cartella comune nella sequenza corretta del processo di mitosi.
Scegliete uno dei programmi gratuiti disponibili in rete per la realizzazione di filmati a partire da fotografie, per esempio Movie Maker oppure Movavi. Inserite la vostra sequenza di fotografie e realizzate il filmato della mitosi!
Nella fase G2 la cellula completa l’accrescimento e
Profase
Ciclo cellulare
Fase S
Fase G1
Fase G2
Interfase
Fase MMitosi
5 Il ciclo cellulare.
CON LA SINTESI
lezione 1 LE CARATTERISTICHE DEI VIVENTI
Tutti gli esseri viventi sono costituiti da cellule e sono caratterizzati da specifiche funzioni vitali: si nutrono, respirano ed eliminano rifiuti, si muovono, reagiscono agli stimoli, si adattano al proprio ambiente, crescono, si riproducono, muoiono.
Le piante sono organismi autotrofi perchè producono da soli le sostanze nutritive grazie alla fotosintesi. Gli animali, che ricavano le sostanze nutritive da altri viventi, sono organismi eterotrofi
La respirazione è il processo che permette agli organismi di trarre energia dagli alimenti.
L’escrezione è il processo di eliminazione delle sostanze di rifiuto.
Tutti gli esseri viventi rispondono agli stimoli esterni: gli animali si muovono per cercare ambienti favorevoli alla sopravvivenza, mentre le piante rispondono agli stimoli esterni, come la luce. Ogni organismo è capace di generare altri esseri viventi in tutto simili a se stesso. La riproduzione può essere asessuata, quando avviene con l’intervento di un solo organismo, o sessuata, quando intervengono un individuo femmina e un individuo maschio.
lezione 2 I VIVENTI SONO COSTITUITI DA CELLULE
La cellula è la più piccola unità dei viventi in grado di svolgere tutte le funzioni vitali.
I viventi costituiti da una sola cellula sono unicellulari: i batteri sono formati da una cellula procariote, cioè priva di nucleo; altri unicellulari sono costituiti da una cellula eucariote, cioè con un nucleo ben formato. Gli organismi costituiti da più cellule organizzate tra loro sono detti pluricellulari. Le cellule tra loro simili, che svolgono lo stesso compito, costituiscono un tessuto. I tessuti, a loro volta, sono organizzati in organi, poi in sistemi o apparati e infine in un organismo.
Per poter osservare le cellule occorre il microscopio, uno strumento capace di ingrandire le immagini di oggetti molto piccoli, dell’ordine del micrometro. Il microscopio ottico, che utilizza la luce, può ingrandire di centinaia di volte i preparati da osservare. Il microscopio elettronico, che utilizza gli elettroni, riesce a ingrandire un oggetto fino a 100000 volte.



lezione 3 LA STRUTTURA DELLA CELLULA
Le parti fondamentali della cellula sono la membrana plasmatica, il DNA e il citoplasma. La cellula procariote è delimitata dalla parete cellulare e dalla membrana; il DNA è immerso nel citoplasma, dove si trovano gli organuli che producono le proteine, i ribosomi. La cellula procariote di molti batteri si muove grazie a filamenti lunghi e sottili, i flagelli, o con strutture più corte, i pili
La cellula eucariote ha una struttura più complessa della cellula procariote e possiede un nucleo ben definito. Esistono due tipi di cellule eucariote: animale e vegetale. Nel citoplasma di entrambi i tipi sono presenti numerosi organuli: i mitocondri, il reticolo endoplasmatico, i ribosomi, l’apparato di Golgi, i centrioli, i lisosomi e i vacuoli. Le cellule vegetali possiedono, inoltre, una parete cellulare, che le delimita e le collega alle cellule vicine; i cloroplasti, che contengono la clorofilla, una sostanza in grado di avviare il processo di fotosintesi, e un grosso vacuolo che svolge funzione di sostegno e di accumulo di acqua ed altre sostanze. La parete cellulare è formata da cellulosa, uno zucchero che conferisce rigidità alla cellula vegetale.

lezione 4 LA RIPRODUZIONE DELLA CELLULA
Quando una cellula ha raggiunto una determinata dimensione, è pronta per la riproduzione: si divide in due cellule figlie, ciascuna delle quali riceve gli stessi materiali della cellula d’origine. La riproduzione permette agli organismi unicellulari di moltiplicarsi e agli organismi pluricellulari di accrescersi e sostituire le cellule danneggiate o invecchiate. Le cellule procariote si dividono per scissione binaria, un meccanismo di riproduzione molto semplice: il DNA si duplica, nella membrana plasmatica si forma una strozzatura e la cellula madre si divide in due cellule figlie. Le cellule eucariote si dividono con un processo detto mitosi. Prima della mitosi è necessario che il nucleo e il suo contenuto si duplichino per assicurare alle due cellule figlie un nucleo identico a quello della cellula madre. La mitosi si svolge in quattro fasi: profase, metafase, anafase e telofase e termina con la citodieresi, cioè la divisione del citoplasma e la separazione delle due cellule figlie. Tra una mitosi e quella successiva avviene una serie di eventi, chiamata ciclo cellulare, a sua volta distinto in due momenti principali: l’interfase e la fase M, o mitosi. Nell’interfase avviene la crescita della cellula, la duplicazione del DNA e la preparazione alla mitosi.

CON LA MAPPA
Adesso che hai ripassato i contenuti essenziali con la sintesi, prova a completare la mappa con le parole chiave suggerite e a trovare le definizioni corrispondenti.
animale - cellula - eucariote - nucleo - organismi pluricellulari - procariote - vegetale
L’UNITÀ BASE DI TUTTI I VIVENTI
e forma solo gli
organismi unicellulari
che si distingue in
ed è quella che forma gli
se è presente che può essere
se è assente

a. Organismi formati da apparati, organi e tessuti costituiti da cellule.
b. Organulo che controlla tutti i processi vitali della cellula.
c. Tipo di cellula eucariote delimitata dalla parete cellulare.
d. Cellula dotata di una struttura complessa.

lezione 1 LE CARATTERISTICHE DEI VIVENTI
1 Scegli la risposta errata.
I viventi:
a sono costituiti da cellule.
b reagiscono agli stimoli.
c non si riproducono.
d si adattano al proprio ambiente.
2 Indica quale funzione vitale si deve attribuire agli organismi rappresentati nelle fotografie.



3 Scegli la soluzione corretta.
Il processo che permette l’eliminazione dei rifiuti si chiama:
a escrezione.
b respirazione. c riproduzione. d nutrizione.
lezione 2 I VIVENTI SONO COSTITUITI DA CELLULE
4 Segna con una crocetta se vero (V) o falso (F).
a. Le cellule sono la più piccola unità dei viventi in grado di svolgere tutte le funzioni vitali.
b. I viventi costituiti da una sola cellula sono detti pluricellulari.
c. Il microscopio ottico permette di osservare i dettagli più piccoli delle cellule.
d. I tessuti sono costituiti da cellule diverse fra loro.
5 Disponi nella sequenza corretta i livelli di organizzazione dell’organismo a partire dalla cellula.
apparato o sistema - cellula - organismotessuto - organo
6 Assegna i termini corretti alle immagini.


lezione 3 LA STRUTTURA DELLA CELLULA
7 Completa il disegno della cellula eucariote inserendo i termini corretti.
8 Segna con una crocetta se vero (V) o falso (F).
a. I flagelli servono per il movimento delle cellule.
b. Il reticolo endoplasmatico si trova sia nella cellula animale sia in quella vegetale.
c. I cloroplasti sono organuli tipici della cellula animale.
d. I mitocondri producono l’energia necessaria alla cellula.
9 Scegli la soluzione corretta.
a. Quale componente cellulare si trova solo nella cellula vegetale?
1 Membrana cellulare.
2 Capsula.
3 Parete cellulare.
4 Centriolo.
b. Qual è il nome delle vescicole contenenti sostanze che distruggono le strutture cellulari danneggiate o non più utilizzabili?
1 Nucleoli
2 Mitocondri
3 Ribosomi
4 Lisosomi.
10 Abbina i termini con la definizione corretta.
1. Cloroplasti
2. Vacuolo
3. Mitocondri
4. Reticolo endoplasmatico
5. Nucleo
6. Ribosomi
a Producono proteine.
b Contiene il codice genetico.
c Attivano la fotosintesi.
d Vescicola di deposito.
e Hanno forma di fagiolo.
f È formato da numerose membrane ripiegate.
4 LA RIPRODUZIONE DELLA CELLULA
11 Sottolinea il termine corretto tra i due proposti.
a. La riproduzione della cellula procariote si chiama scissione binaria/mitosi.
b. Il fuso mitotico si allinea nel piano equatoriale durante la anafase/metafase.
c. La divisione cellulare avviene nella profase/ telofase.
d. La mitosi corrisponde alla fase M/fase S del ciclo cellulare.
e. Durante la profase i cromosomi si compattano e si duplicano/dividono
12 Segna con una crocetta se vero (V) o falso (F).
a. La citodieresi è il processo che inizia la mitosi.
b. Al termine della scissione binaria la membrana plasmatica forma una strozzatura.
c. Il DNA si duplica all’inizio della mitosi, ma non nella scissione binaria.
d. Durante l’interfase la cellula va incontro a un accrescimento importante.
e. La riproduzione cellulare ha come prodotto finale la produzione di proteine.
1.
3. 4. 5. 6.
lezione
INTERPRETARE E COMMENTARE UN MODELLO
1 Completa i disegni con i termini corretti.


2 Osserva i disegni qui sopra e rispondi alle domande.
a. Quale immagine rappresenta la cellula animale e quale la vegetale?
TRARRE INFORMAZIONI DA UN’IMMAGINE
3 Osserva le immagini e rispondi alle domande.




a. In quali fotografie sono rappresentati organismi autotrofi?
b. In quali fotografie sono rappresentati organismi eterotrofi?
c. In che modo si nutrono i funghi?
b. Quali organuli sono esclusivi della cellula vegetale?
d. Quale processo permette alle piante di essere autotrofe?
4 Risolvi.
In condizioni ottimali una cellula batterica può dividersi in 20 minuti. Calcola quanti batteri ci saranno dopo 1 ora partendo da una singola cellula.
METTERE IN ORDINE E SPIEGARE UN FENOMENO
5 Ordina le fasi della riproduzione della cellula eucariote. Poi abbina ogni termine alla sua definizione.
Anafase
Metafase
Profase
Telofase
Citodieresi
a. Processo di divisione del citoplasma.
b. Fase della mitosi durante la quale i cromosomi raddoppiati vengono trascinati al centro della cellula.
c. Fase della mitosi durante la quale i cromosomi raddoppiati si separano e migrano ai poli opposti.
d. Fase della mitosi in cui si riformano i due nuclei.
e. Fase della mitosi durante la quale i cromosomi si raddoppiano.
INTERPRETARE E TRARRE INFORMAZIONI DA UN TESTO
6 Leggi il brano.
DALLE CELLULE PROCARIOTE ALLE CELLULE EUCARIOTE
La Terra si formò circa 4,5 miliardi di anni fa: per milioni di anni le acque dei mari si arricchirono di molecole organiche formando quello che è chiamato “brodo primordiale”. È qui che, circa 3,8 miliardi di anni fa, si sarebbero formate le cellule degli organismi unicellulari più antichi, eterotrofi simili agli attuali batteri, capaci di vivere in assenza di ossigeno.
Nel tempo, il graduale esaurimento delle sostanze organiche favorì la diffusione di organismi autotrofi fotosintetici; l’aumento di ossigeno nell’atmosfera provocò la comparsa di organismi aerobi, capaci di utilizzare un gas come l’ossigeno per ricavare energia dalle molecole organiche. I protagonisti di questa prima fase della storia della vita furono, dunque, le cellule procariote
Come avvenne il passaggio alle cellule eucariote più complesse?
Negli anni ’70 del secolo scorso la biologa statunitense Lynn Margulis formulò la teoria dell’endosimbiosi sulla base delle osservazioni compiute su diversi tipi di batteri.
La teoria sostiene che circa 1,4 miliardi di anni fa batteri aerobi sarebbero stati ospitati da un batterio anaerobio: il batterio ospite forniva
protezione e sostanze nutritive al batterio aerobio che usava a vantaggio di entrambi l’ossigeno. Altre associazioni vantaggiose, ad esempio di batteri capaci di compiere la fotosintesi (i futuri cloroplasti) con batteri provvisti di flagello, determinarono la comparsa di cellule più grandi, con una complessa organizzazione interna e capaci di muoversi. In questo modo avrebbero avuto origine le cellule eucariote che oggi costituiscono animali, vegetali e funghi.
Rispondi alle domande e svolgi le attività proposte, da solo o in gruppo con i tuoi compagni.
a. Spiega il significato dei termini autotrofo, eterotrofo, aerobio e anaerobio.
b. Quale ipotesi hanno formulato gli scienziati riguardo alla comparsa delle prime cellule?
c. Come si alimentavano i primi organismi comparsi nelle acque marine circa 3,8 miliardi di anni fa?
d. Spiega le osservazioni compiute dalla scienziata che le hanno permesso di formulare la teoria dell’endosimbiosi.
DIGITAL SKILLS
L’origine della vita sulla Terra rimane ancora oggi oggetto di indagine da parte degli scienziati: ricerca informazioni sulle più recenti ipotesi su questo argomento.
Anafase: Metafase: Profase: Telofase: Citodieresi:


EUKARYOTIC
Like prokaryotic cells, all eukaryotic cells are surrounded by plasma membranes and contain ribosomes. However, eukaryotic cells are much more complex and contain a nucleus, a variety of cytoplasmic organelles, and a cytoskeleton. The largest and most prominent organelle of eukaryotic cells is the nucleus, with a diameter of approximately 5 µm. The nucleus contains the genetic information of the cell, which in eukaryotes is organised as linear DNA molecules.
Eukaryotic cells are generally much larger than prokaryotic cells, often having a cell volume at least a thousand times greater. In addition to a nucleus, eukaryotic cells contain a lot of organelles which have a distinct role in the metabolism of the cell. Two of these organelles, mitochondria and chloroplasts, play critical roles in energy metabolism. Mitochondria are responsible for generating energy through the breakdown of organic molecules, while chloroplasts are the sites of photosynthesis and are found only in plant and green algae cells.
COMPREHENSION EXERCISES
Read the text and answer the questions.
a. What structures are common both in prokaryotic and eukaryotic cells?
b. Which kind of cell is more complex, prokaryotic or eukaryotic?
c. Which is the largest organelle?
d. What do other organelles in eukaryotic cells do?
e. What role do mitochondria and chloroplasts play?



Rappresentazione di una cellula eucariote animale.
VIVENTI
degli organismi La classificazioneunità
lezione 1
Come si classificano i viventi
lezione 2
Dare un nome agli organismi

LEZIONI POWERPOINT in


BUONE NOTIZIE PER IL FUTURO
ORGANISMI STRAORDINARI PER LA MEDICINA DI DOMANI
La classificazione degli esseri viventi, introdotta da Linneo nel XVIII secolo e perfezionata nel corso del tempo, continua a essere uno strumento fondamentale non solo per comprendere meglio la varietà della vita sulla Terra, ma anche per scoprire nuove specie di organismi. I ricercatori concentrano sempre più l’attenzione sugli ecosistemi ad biodiversità, come le foreste pluviali, dove spesso vengono identificati nuovi vegetali con proprietà terapeutiche sorprendenti, come alcune specie di orchidee - Dendrobium longicornu, Dendrobium transparens, Rhynchostylis retusa, - che contengono sostanze in grado di fermare la proliferazione di molti tipi di tumori. Anche i mari sono ricchi di organismi in grado di offrire sostanze utili per la cura di molte malattie: alcune specie di alghe rosse contengono principi attivi, come l’omotaurina, che possono prevenire le malattie dell’invecchiamento cerebrale; mentre dai molluschi, come la lepre di mare, Dolabella auricularia, l’Elysia rufescens e molte altre specie di lumache di mare, si estraggono sostanza con proprietà antitumorali. La comunità scientifica stima che sul nostro pianeta resti ancora da scoprire circa l’80% delle specie viventi, la maggior parte delle quali abita negli ambienti marini, ancora largamente inesplorati.
Come si classificano i viventi lezione 1
CARTA PENNA COMPUTER
1 Una raccolta di fumetti, ordinati per genere.
Guarda il video e scrivi le risposte sul quaderno.

L’ornitorinco, un animale bizzarro
1. Qual è l’ambiente di vita dell’ornitorinco?
2. Quali funzioni svolgono la coda e le zampe palmate?
3. Perchè l’ornitorinco è classificato come mammifero?
4. Come si riproduce?
5. Quale funzione svolgono le ghiandole crurali?
6. Qual è l’areale di vita di questo animale?
7. Perché è stato molto difficile classificare l’ornitorinco?
1 Perché si classifica
Classificare è un’attività spontanea della nostra mente: senza quasi che ce ne accorgiamo, continuamente formiamo dei gruppi nei quali collochiamo gli oggetti che ci circondano con delle caratteristiche comuni, e assegniamo loro un nome. Osserviamo, per esempio, la disposizione ordinata dei prodotti sugli scaffali di un supermercato: sono classificati per categorie (detersivi, verdure, indumenti) in modo da rendere più facile la nostra spesa.

Classifichiamo anche quando collezioniamo qualcosa: per esempio, possiamo suddividere la collezione di fumetti a seconda del genere o dell’edizione 1
Per stabilire se un oggetto appartiene a un gruppo o a un altro è necessario individuare delle proprietà caratteristiche di un certo gruppo, in modo da stabilire dei criteri di classificazione
Gli organismi viventi sono assai più numerosi dei prodotti di un grande supermercato: finora sono stati identificati circa due milioni di tipi diversi di animali, piante, funghi, microrganismi, e i biologi ritengono che gli organismi ancora da scoprire siano molto più numerosi!
Questi dati dimostrano quanto sia indispensabile agli studiosi della natura un sistema di classificazione, una specie di “catalogo biologico” che permetta di identificare sia le specie conosciute sia i nuovi esemplari che via via vengono scoperti e di dare loro un nome ben preciso.
La tassonomia è la branca della biologia che si occupa di classificare gli esseri viventi e attribuire loro un nome.
In biologia, la classificazione consiste nel raggruppare gli esseri viventi in categorie secondo criteri oggettivi.

2 Criteri per classificare gli organismi
Nel Seicento le balene e i delfini venivano classificati come pesci a causa della loro forma molto simile a quella di un pesce e dell’ambiente in cui vivono. Gli scienziati di allora usavano ancora la classificazione introdotta, molti secoli prima, dal filosofo greco Aristotele, che si basava prevalentemente su criteri morfologici, relativi alla forma degli organismi.
Le somiglianze tra organismi basate sull’aspetto esteriore non sono, tuttavia, un corretto criterio di classificazione: se, infatti, si ricorre anche a criteri anatomici e fisiologici, relativi cioè alla struttura e alle funzioni degli organi interni, scopriamo che un delfino ha un maggior numero di caratteristiche comuni con un uomo anziché con uno squalo!
Infatti, il delfino respira con i polmoni, partorisce i piccoli e li allatta, ha organi simili a quelli dell’uomo e di tutti gli altri mammiferi. Lo squalo invece respira con le branchie, depone le uova, non allatta i piccoli e ha organi comuni ai pesci. Il delfino è un mammifero,

Il delfino introduce aria attraverso le narici situate sulla sommità del capo.
Lo squalo introduce l’acqua dagli spiracoli e la espelle dalle fessure branchiali dopo aver assorbito l’ossigeno.

2 Animali apparentemente simili ma in realtà molto diversi.

Oltre alle differenze riguardanti alcune funzioni vitali, ne esistono molte altre che confermano la classificazione del delfino come un mammifero e dello squalo come un pesce. Per esempio, l’arto anteriore del delfino ha una struttura molto diversa da quella della pinna di uno squalo ed è composta dalle stesse parti scheletriche del braccio di un uomo. L’arto anteriore del delfino e la pinna dei pesci sono organi analoghi
Gli organi analoghi si assomigliano perché svolgono la stessa funzione ma hanno struttura interna diversa.
Un caso emblematico riguarda un curioso animale, l’echidna: ha il corpo ricoperto di peli e aculei che la fanno assomigliare a un riccio, una testa molto piccola, un muso stretto e appuntito, non ha denti ma possiede una lingua lunghissima e zampe corte e con potenti artigli, che le conferiscono una grande abilità nello scavare 3 . Per classificarla è stato necessario usare i criteri fisiologici e stabilire così che l’echidna sebbene deponga le uova, è un mammifero: infatti allatta i piccoli e mantiene costante la temperatura del corpo.
3 L’echidna, come l’ornitorinco, è un mammifero che depone le uova.

3 Evoluzione e classificazione
La presenza di organi simili tra loro in animali apparentemente molto diversi, come l’essere umano e il delfino, può essere spiegata con la teoria dell’evoluzione, elaborata dal naturalista inglese Charles Darwin (1809-1882) nel XIX secolo. Secondo questa teoria, tutti gli organismi si modificano nel tempo, cioè evolvono, per adattarsi all’ambiente in cui vivono. Le somiglianze e le differenze tra i diversi gruppi di viventi sono il risultato dei diversi adattamenti a queste variazioni ambientali.

Un adattamento è una struttura, un processo fisiologico o un comportamento che rende gli organismi adatti a sopravvivere e a riprodursi rispetto agli altri membri della stessa specie
Di generazione in generazione, i diversi gruppi di organismi possono cambiare moltissimo, talvolta perdendo ogni somiglianza tra di loro; è questo il meccanismo che ha determinato la grande varietà di forme viventi che oggi conosciamo.
Tuttavia, numerose indagini hanno dimostrato che spesso organismi che appaiono molto diversi tra loro hanno invece in comune il “piano costruttivo” del loro corpo. Consideriamo per esempio l’arto anteriore dell’iguana e del martin pescatore: sono molto diversi tra loro nella forma e nella funzione, tuttavia sono formati dalle stesse parti scheletriche. In biologia si dice che l’arto dell’iguana e l’ala del martin pescatore, così come l’arto anteriore del delfino e il braccio di un uomo, sono organi omologhi 4 .

SCIENZA
Gli organi omologhi svolgono funzioni diverse ma hanno la stessa struttura interna.
4 La zampa dell’iguana serve a camminare, l’ala del martin pescatore invece a volare, ma la loro struttura interna è molto simile.
Nessun animale è in grado di sopravvivere nello spazio
Nello spazio le condizioni ambientali sono estreme, temperature vicine allo zero assoluto e gravità molto bassa sono in grado di disgregare qualsiasi essere vivente. O forse no. Il tardigrado, Milnesium tardigradum, chiamato anche “orso d’acqua”, è un minuscolo animale, lungo pochi millimetri, che vive in tutti mari, anche nel gelido Oceano Antartico. Ha 8 zampe munite di artigli e può sopravvivere senza cibo per qualche decennio. Nel corso di un esperimento dell’Agenzia Spaziale Europea alcuni tardigradi sono stati posti all’esterno di una capsula spaziale: i minuscoli animali sono sopravvissuti per circa 12 giorni al freddo siderale, sottoposti al continuo bombardamento delle radiazioni ad alta energia. È proprio questo “superstite dello spazio” che ha ispirato i disegnatori di Glordon, l’amico alieno del protagonista del film di animazione Elio.

Un esempio di organi omologhi sono gli arti anteriori dei vertebrati 5 . Pur essendo simili nella struttura, si sono differenziati nel tempo per compiere funzioni diverse: il salto nelle rane, il nuoto nelle balene, il volo negli uccelli, la presa degli oggetti nell’uomo. La loro forte somiglianza testimonia che hanno avuto un antenato comune, un vertebrato: pertanto tutti questi animali sono classificati come vertebrati. Classificare gli organismi in questo modo significa usare criteri evolutivi. Oltre ai criteri evolutivi, morfologici, anatomici e fisiologici, oggi i biologi utilizzano anche altri criteri per classificare correttamente gli organismi: criteri ecologici, legati all’ambiente di vita, criteri etologici, legati al comportamento, e criteri biochimici, legati alle caratteristiche della molecola del DNA.




FISSA I CONTENUTI
ESSENZIALI
Completa le frasi con i termini corretti. criteri tassonomia ecologici analoghi omologhi
1. La è la branca della biologia che classifica gli organismi e attribuisce loro un nome.
2. Per classificare è necessario stabilire dei di classificazione.
3. Gli organi svolgono la stessa funzione ma hanno struttura interna diversa.
4. Gli organismi che possiedono organi hanno un antenato in comune.
VERSO LE COMPETENZE
Individua il criterio (fisiologico, anatomico, morfologico, ecologico, etologico, biochimico) utilizzato per ognuna delle classificazioni.
1. La trota è un pesce che vive solo in ambienti acquatici ricchi di ossigeno. criterio
2. La composizione del DNA di un organismo permette di sapere a che specie appartiene. criterio
3. Nelle prime fasi di vita la rana ha molte caratteristiche dei pesci. criterio
4. Il canto di un uccello permette di sapere a che specie appartiene. criterio
uomo
gatto
balena pipistrello
uccello
lucertola
rana
5 Arti con la stessa struttura ma con funzioni diverse.
Dare un nome agli organismi lezione 2
CARTA PENNA COMPUTER

Carlo Linneo
Guarda il video e scrivi le risposte sul quaderno.
1. Quali sono i domini in cui sono suddivisi i viventi?
2. Quali sono i regni in cui è suddiviso il dominio degli eucarioti?
3. Quali sono le principali caratteristiche degli organismi che appartengono ai diversi regni dei viventi?
ORA FERMA L’IMMAGINE!
Metti in pausa il video nel seguente punto.
4. Quali caratteristiche degli Archeobatteri hanno condotto i biologi a ipotizzare l’esistenza di un unico progenitore comune a tutti i viventi?

1 La classificazione di Linneo
Un sistema di classificazione degli esseri viventi è stato introdotto per la prima volta nel XVIII secolo dal naturalista svedese Karl von Linné (in italiano Carlo Linneo; 17071778). Le caratteristiche che Linneo prende in considerazione per classificare i viventi sono l’aspetto esteriore del corpo e la sua struttura interna. Sulla base di queste caratteristiche egli identifica cinque raggruppamenti, definiti categorie sistematiche (o tassonomiche), all’interno dei quali colloca ogni organismo. Linneo ordina le categorie sistematiche in una successione, dalla più ristretta alla più ampia: la categoria fondamentale è la specie, che raggruppa organismi tra loro simili, e le categorie più ampie sono i due regni, animale e vegetale. Le categorie intermedie sono il genere, l’ordine e la classe. La specie costituisce ancora oggi la categoria fondamentale della classificazione.
La specie riunisce organismi con caratteristiche simili e che, accoppiandosi tra loro, generano individui simili e fecondi, cioè capaci a loro volta di generare dei figli.
2 La classificazione moderna
La suddivisione in due regni (animali e vegetale) introdotta da Linneo è stata mantenuta fino al secolo scorso. In seguito, lo sviluppo della ricerca scientifica e l’invenzione di microscopi sempre più potenti hanno permesso di scoprire gli organismi unicellulari che, per le loro dimensioni e le loro caratteristiche, non possono essere classificati in nessu-
Tre domini
no dei due regni ideati da Linneo. I funghi, poi, assomigliano per l’aspetto alle piante ma, a differenza di queste, non sono autotrofi: in quale regno allora vanno collocati? Per rispondere a queste nuove esigenze di classificazione, nel 1969 il biologo americano Robert Whittaker (1920-1980) ha introdotto tre nuovi regni: monere, protisti e funghi 1 . Per identificarli, ha utilizzato alcuni semplici criteri:
• il numero di cellule che formano un organismo (unicellulari o pluricellulari);
• la presenza o meno nella cellula di un nucleo distinto (procarioti ed eucarioti);
• il modo di nutrirsi (autotrofi ed eterotrofi).


Ricerche effettuate negli anni successivi hanno portato alla scoperta di particolari tipi di batteri, i batteri estremofili, formati da cellule con caratteristiche uniche e particolari che li rendono adatti a vivere in condizioni ambientali estreme, come le acque termali calde o le acque acide e, forse, persino su altri corpi celesti 2
La scoperta di questi batteri è alla base della divisione degli esseri viventi in tre grandi raggruppamenti:
• il dominio degli archeobatteri, che comprende i batteri estremofili;
• il dominio dei batteri, che comprende i batteri veri e propri, formati da un’unica cellula procariote;
• il dominio degli eucarioti, che comprende tutti gli organismi, unicellulari e pluricellulari, formati da cellule eucariote.
Nel dominio degli eucarioti sono compresi quattro regni: protisti , funghi , piante e animali 3
1 I batteri appartengono al regno delle monere (a); l’euglena è un protista (b); il porcino (Boletus edulis) appartiene al regno dei funghi (c).

2 L’archeobatterio Staphylothermus marinus vive nelle acque a temperature altissime, comprese tra 65 e 85 ˚C.

3 Domini e regni dei viventi.
TUTTI GLI ORGANISMI VIVENTI
cellule procariote (senza nucleo)
cellule eucariote (con nucleo)
sono suddivisi in tre DOMINI
4 La classificazione della tigre.
Specie
Le categorie sistematiche odierne, ordinate dalla più ristretta alla più ampia, sono: specie, genere, famiglia, ordine, classe, phylum, regno e dominio 4 .
La specie è la categoria fondamentale perché raggruppa organismi con caratteristiche simili, in grado di accoppiarsi tra loro e di generare figli a loro volta fecondi. Il nome della tigre è Panthera tigris.
Famiglia
Generi simili con un progenitore comune costituiscono una famiglia. Alla famiglia dei felini appartengono il leone e la tigre, ma anche il gatto domestico.
Genere
Il genere comprende le specie che si somigliano per alcuni caratteri e che discendono da un antenato comune. Leone e tigre appartengono allo stesso genere, Panthera
Ordine
Famiglie simili appartengono allo stesso ordine. La tigre e il leone appartengono all’ordine dei carnivori, insieme ai cani e agli orsi.

Classe
Gli ordini simili tra loro fanno parte di una classe: la tigre e il leone sono dei mammiferi, come tutti gli organismi che partoriscono e allattano i piccoli. I nomi delle classi sono spesso quelli con i quali indichiamo gli organismi nel linguaggio di tutti i giorni: sono classi ad esempio gli insetti, i rettili, gli uccelli, le conifere.
Regno
I phyla sono collocati in categorie sistematiche più ampie, i regni: protisti, funghi, piante e animali.
Dominio Il dominio raggruppa organismi sulla base delle caratteristiche del loro DNA. Due domini comprendono i batteri, l’altro tutti gli organismi formati da cellule eucariote.
Phylum
Le classi sono inserite, a loro volta, nelle categorie sistematiche dei phyla (phylum, al singolare). Ad esempio, tutti gli organismi che hanno il corpo suddiviso in segmenti e gli arti articolati appartengono al phylum degli artropodi, mentre il phylum dei cordati, al quale appartiene anche la specie umana, comprende tutti gli organismi che possiedono una struttura di sostegno interna.
3 La nomenclatura binomia
Linneo viene ricordato non solo per il suo rivoluzionario sistema di classificazione, ma anche per aver introdotto nella tassonomia la nomenclatura binomia, un modo di denominare gli organismi utilizzando due nomi latini. Il latino era da secoli la lingua con la quale comunicavano gli studiosi, le persone colte, gli scienziati, e quindi era la più adeguata per dare agli organismi un nome universalmente comprensibile. Ancora oggi la nomenclatura binomia in latino è la denominazione usata dagli scienziati di tutto il mondo: elimina, infatti, i problemi legati alla traduzione da una lingua all’altra e impedisce che si verifichino confusioni nella comunicazione scientifica tra ricercatori di paesi diversi.
Il primo dei nomi latini utilizzati dalla nomenclatura binomia si riferisce al genere di appartenenza, il secondo nome in latino indica la specie
5 Il gatto domestico (a), Felis catus, ha una coda lunga e affusolata e non teme l’uomo; il gatto selvatico (b), Felis silvestris ha una coda folta e tozza, vive nei boschi ed è più robusto e schivo.

Il nome del genere si scrive sempre con l’iniziale maiuscola, quello della specie con l’iniziale minuscola 5 . Per esempio il nome della tigre secon do la nomenclatura binomia è Panthera tigris. Una convenzione interna zionale stabilisce che il nome della specie venga scelto dallo scopritore, che quindi può attribuirgli il nome che preferisce, anche il proprio. È il caso del Chlamydosaurus kingii 6 , un rettile conosciuto come drago frangiato (o “lucertola con il collare”) che vive in Australia.Il termine che ne definisce la specie è stato dato in onore del capitano Philip Gidley King, un esploratore e governatore dell’Australia.
FISSA I CONTENUTI ESSENZIALI
Abbina i termini con la definizione corretta.
1 Specie
2 Dominio
3 Batteri
4 Protisti
a Regno degli organismi unicellulari procarioti.


b Riunisce organismi con caratteristiche simili che, accoppiandosi, generano individui simili e fecondi.
c Regno degli organismi unicellulari eucarioti.
d Categoria più ampia nella classificazione dei viventi.
1: 2: 3: 4:
VERSO LE COMPETENZE
Osserva il disegno della pagina precedente che mostra la classificazione della tigre. Scegli le soluzioni corrette. Il leone: appartiene alla stessa specie della tigre. appartiene al genere Panthera. ha in comune con la tigre tutte le categorie tassonomiche superiori alla classe. ha un maggior numero di caratteristiche in comune con l’orso piuttosto che con il gatto domestico.
CON LA SINTESI
lezione 1 COME SI CLASSIFICANO I VIVENTI
Classificare la realtà è un’attività spontanea della mente. Grazie a specifici criteri di classificazione suddividiamo in gruppi tutti gli oggetti che hanno delle caratteristiche in comune. La prima classificazione degli organismi risale al filosofo Aristotele, che utilizzava soprattutto criteri morfologici basati sulle forme esterne degli esseri viventi. Per classificare correttamente non basta individuare le somiglianze tra organismi basate sull’aspetto del corpo, ma servono anche criteri anatomici e criteri fisiologici, che si riferiscono alla struttura e alle funzioni degli organi interni.
La teoria dell’evoluzione proposta dal naturalista Charles Darwin nel XIX secolo ha introdotto l’idea che gli esseri viventi si modificano nel tempo, cioè evolvono per adattarsi all’ambiente in cui vivono: quindi le somiglianze e le differenze dei corpi degli organismi sono il risultato di questo adattamento. Utilizzando i criteri anatomici e fisiologici, è stato possibile individuare gli organi omologhi, cioè organi che appartengono ad animali diversi e che svolgono funzioni differenti, ma che presentano la stessa struttura interna. Gli organismi che possiedono organi omologhi sono legati da una parentela, cioè hanno avuto un antenato comune: questo criterio di classificazione è un criterio evolutivo.
Oggi i biologi utilizzano anche altri criteri per classificare gli organismi: criteri ecologici, legati all’ambiente di vita, criteri etologici, legati al comportamento, e criteri biochimici, legati alle caratteristiche della molecola del DNA.




balena pipistrello
uccello
lucertola

lezione 2 DARE UN NOME AGLI ORGANISMI
Nel 1700 il naturalista Carlo Linneo ha introdotto una classificazione dei viventi basata su criteri morfologici, anatomici e fisiologici. In base a questi criteri Linneo ha individuato 5 categorie sistematiche (o tassonomiche).
La categoria fondamentale era la specie che raggruppa organismi simili, mentre la categoria più ampia era il regno. Linneo è stato il primo a utilizzare la nomenclatura binomia secondo cui ogni organismo è individuato da due nomi latini: il primo si riferisce solo al genere di appartenenza mentre entrambi i nomi insieme indicano la specie.
Con il progredire delle scoperte scientifiche sono state introdotte nuove categorie sistematiche. Grazie alle scoperte sui batteri, è stato necessario suddividere gli organismi in 3 domini: archeobatteri, batteri e eucarioti. Il dominio degli eucarioti comprende a sua volta 4 regni: il regno dei protisti, il regno dei funghi, il regno vegetale e il regno animale.
Le categorie sistematiche della classificazione moderna, ordinate dalla più ristretta alla più ampia, sono: specie, genere, famiglia, ordine, classe, phylum, regno e dominio.
cellule procariote (senza nucleo)
eucariote (con nucleo)
cellule
sono suddivisi in tre DOMINI
CON LA MAPPA
Adesso che hai ripassato i contenuti essenziali con la sintesi, prova a completare la mappa con le parole chiave suggerite e a trovare le definizioni corrispondenti.
criteri - Linneo - morfologici - nomenclatura binomia - organi omologhi - specie
1. LA CLASSIFICAZIONE DEGLI ORGANISMI
raggruppa i viventi in è stata proposta dal naturalista
delle quali la più importante è la
2. categorie sistematiche
secondo dei
che possono essere
5. quando individuano la presenza di 9.
a. Raggruppamenti di organismi usati nella classificazione.
b. Criteri di classificazione basati sull’origine comune di un organo.
che ha introdotto la per dare un nome agli organismi
c. Criteri di classificazione che si basano sul funzionamento degli organi interni.
d. Organi con stessa struttura interna ma funzione diversa.
6. anatomici
8. evolutivi
7. fisiologici
10.
Carlo Linneo

lezione 1 COME SI CLASSIFICANO I VIVENTI
1 Scegli la soluzione errata.
La tassonomia:
a classifica gli esseri viventi e i non viventi.
b classifica gli esseri viventi.
c attribuisce un nome agli organismi.
d usa criteri soggettivi per classificare.
2 Indica come avviene la nascita della prole negli organismi rappresentati nelle fotografie.

a
b

3 Scegli la soluzione corretta.
Organi che svolgono funzioni diverse, ma hanno la stessa struttura interna sono detti:
a analoghi.
b fisiologici.
c omologhi.
d anatomici.
4 Completa le frasi con i termini corretti.
a. Un rende gli organismi capaci di sopravvivere e riprodursi in un certo ambiente meglio di altri membri della stessa specie.
b. L’arto anteriore dell’otaria e l’ala dell’aquila sono molto diversi tra loro nella forma e per la loro , tuttavia sono formati dalle stesse parti scheletriche.
5 Abbina i termini con la definizione corretta.
1. Criteri morfologici
2. Criteri anatomici
3. Criteri fisiologici
4. Criteri evolutivi
5. Criteri ecologici
a Si basano sul numero di organi omologhi.
b Sono relativi alla struttura degli organi interni.
c Sono legati all’ambiente di vita.
d Sono relativi alle funzioni degli organi interni.
e Sono basati sulla forma degli organismi.
1. 2. 3. 4. 5.
6 Sottolinea il termine corretto tra i due proposti.
a. Il delfino respira attraverso le narici/ branchie
b. I criteri etologici si basano sulla fisiologia/ sul comportamento degli organismi.
c. I criteri biochimici/evolutivi sono legati alle caratteristiche della molecola del DNA.
7 Osserva il disegno e inserisci il numero corrispondente alla funzione che svolge l’arto rappresentato.
1. camminata e presa
2. nuoto
3. volo
4. salto
5. presa




lezione 2 DARE UN NOME AGLI ORGANISMI
8 Segna con una crocetta se vero (V) o falso (F).
a. La specie raggruppa gli organismi in grado di generare figli fertili.
b. La categoria tassonomica più ampia è il dominio.
c. Gli organismi procarioti sono tutti raggruppati in un phylum unico.
d. Il nome in latino della specie si scrive in maiuscolo stampatello.
9 Scegli la soluzione errata.
I metodi di classificazione moderni si basano sui seguenti criteri:
a numero di cellule che formano un organismo.
b presenza o meno nella cellula di un nucleo distinto.
c modo di nutrirsi degli organismi. d forma e funzione degli organi.
10 Scegli la soluzione corretta.
La classificazione attuale ha sostituito con il regno dei protisti il regno:
a degli archeobatteri.
b delle monere.
c dei funghi.
d delle piante.
11 Colloca nel dominio corretto gli organismi rappresentati.


12 Sottolinea il termine corretto tra i due proposti.
a. Il nome del genere si scrive sempre con l’iniziale maiuscola/minuscola.
b. Secondo la nomenclatura binomia il termine tigris nell’organismo Panthera tigris indica la specie/famiglia
c. I termini Rhododendron ferrugineum e Rhododendron hirsutum indicano due ordini/specie differenti.
d. Il termine “funghi” appartiene alla categoria della classe/del regno.
INDIVIDUARE CARATTERISTICHE E SPIEGARE
1 Osserva gli oggetti, suddividili in due gruppi e scrivi il criterio che hai usato per classificarli.







Gruppo A: Gruppo B:
INTERPRETARE E COMMENTARE UN MODELLO
2 Completa il disegno con i termini corretti.

specie
TRARRE INFORMAZIONI DA UN’IMMAGINE
3 Osserva le immagini e rispondi alle domande. a b


a. Indica se gli organi rappresentati nelle fotografie sono analoghi oppure omologhi. Motiva la tua risposta.
b. Come si definisce il processo che è all’origine della formazione di questi organi?
INTERPRETARE E TRARRE INFORMAZIONI DA UN TESTO
5 Leggi il brano.
LA RICCHEZZA DELLA VITA
4 Osserva le immagini e rispondi alle domande.


a d b c


a. In quali fotografie sono rappresentati organismi appartenenti al dominio degli eucarioti?
b. In quale fotografia sono rappresentati organismi appartenenti al dominio dei batteri?
La biodiversità, cioè la varietà degli esseri viventi che popolano la Terra, si misura a vari livelli: geni, specie, popolazioni ed ecosistemi. Miliardi di miliardi di organismi, dai più piccoli batteri alle piante, agli animali e agli ecosistemi tutti legati fra loro, tutti indispensabili. Anche noi esseri umani facciamo parte della biodiversità e, come ogni vivente, sfruttiamo quanto ci offre: cibo, acqua, energia e risorse per la vita quotidiana. Batteri, farfalle, balene e foreste tropicali, insetti e grandi carnivori, papaveri e orchidee sono solo alcuni dei componenti della biodiversità della Terra, l’immensa varietà delle forme viventi che rende il nostro pianeta unico. Gli ambienti particolarmente ricchi di biodiversità non sono molti: le barriere coralline, le foreste tropicali e gli estuari dei fiumi ospitano circa la metà degli esseri viventi del pianeta, anche se ricoprono solo il 6% della superficie terrestre. Grazie alla biodiversità è garantita la vita sulla Terra. L’uomo deve evitare di estinguere specie viventi, ha il dovere di preservare l’ambiente e le risorse della Terra per le generazioni future.
(Tratto da www.wwf.it)
Rispondi alle domande e svolgi le attività proposte, da solo o in gruppo con i tuoi compagni.
a. Che cos’è la biodiversità?
b. Perché la biodiversità è importante per la vita?
c. Quali sono gli ambienti più ricchi di biodiversità?
d. Qual è il dovere dell’uomo nei confronti della biodiversità?
Intelligenza Artificiale IA
Con l’aiuto dell’insegnante realizza un prompt, cioè una domanda da sottoporre a un chatbot di intelligenza artificiale, per chiedergli di illustrarti in maniera semplice ma completa i target dell’Obiettivo 15 dell’Agenda 2030. Insieme alla classe crea dei gruppi di lavoro per presentare con cartelloni o presentazioni digitali i quattro target di questo obiettivo.


CLASSIFICATION
OF LIVING THINGS
All living organisms are classified into groups based on very basic, shared characteristics. Organisms within each group are then further divided into smaller groups. These smaller groups are based on more detailed similarities within each larger group. This grouping system makes it easier for scientists to study certain groups of organisms. Characteristics such as appearance, reproduction, mobility, and functionality are just a few ways in which living organisms are grouped together. These specialized groups are collectively called the classification of living things. The classification of living things includes 7 levels: kingdom, phylum, class, order, family, genus, and species. The most basic classification of living things is kingdom. Currently there are five kingdoms.
• The phylum is the next level following kingdom in the classification of living things.
• Classes are a way to further divide organisms of a phylum
• Organisms in each class are further broken down into orders.
• Orders are divided into families.
• Genus is a way to describe the generic name for an organism.
• Species are as specific as you can get. It is the lowest and most strict level of classification of living things.
lossario
APPEARANCE aspetto
COMPREHENSION
EXERCISES
Answer the following questions.
a. Does this grouping system make it easier for scientists to study certain groups of organisms?
b. Can you name some of the characteristics in which living organisms are grouped together?
c. Can you name the classification levels of living things?



LA CELLULA: MODELLO
DI COOPERAZIONE E UTILIZZO DEGLI
SPAZI

Pensa a un sistema in cui ogni parte ha un compito ben preciso e coordinato con le altre parti, un sistema che funziona in modo cooperativo per raggiungere un solo scopo: l’equilibrio dinamico del sistema stesso. La cellula ne è un esempio perfetto: ognuno degli organuli ha una funzione ben precisa e tutti insieme lavorano per la sopravvivenza e il benessere della cellula stessa. Ma non è tutto qui. Per funzionare a dovere la cellula ha bisogno di ampie superfici e lunghezze inimmaginabili: il DNA di una cellula umana è lungo due metri e la superficie della membrana interna ai mitocondri può arrivare fino a 1 m2. Il tutto racchiuso in uno spazio di 30 micron! Il fenomeno per cui grandezze così diverse possono convivere e funzionare insieme dentro lo spazio piccolissimo di una cellula si spiega con l’effetto scala.
PREREQUISITI
Conoscere le caratteristiche delle cellule.
Riconoscere i principali organuli delle cellule.
Saper descrivere il funzionamento degli organuli cellulari.
RISULTATI ATTESI
Conoscenza della struttura e del funzionamento dei vari organuli.
Comprensione di come la cooperazione sia alla base del funzionamento delle cellule.
Comprensione dei principi matematici alla base dell’effetto scala.
Capacità di riconoscere l’effetto scala nell’arte.
RACCORDI interdisciplinari
Proponiamo alcuni approfondimenti che possono essere affrontati nel percorso interdisciplinare, ma la mappa suggerisce altri argomenti che possono essere sviluppati per integrare lo stesso percorso.
ITALIANO: la ripetizione strutturale nella poesia
SCIENZE: effetto scala e cooperazione degli organuli
MATEMATICA: le unità di misura
ARTE E LETTERATURA: moduli ripetitivi in pittura
TECNOLOGIA: Strumenti che modificano la percezione del reale
EFFETTO SCALA E COOPERAZIONE DEGLI ORGANULI
MODULI RIPETITIVI NEI DIPINTI
LE UNITÀ DI MISURA
LA MAGIA DELLA RIPETIZIONE
LESSICALE E STRUTTURALE
NELLA POESIA
STRUMENTI CHE MODIFICANO LA PERCEZIONE DEL REALE
SCIENZE
Effetto scala e cooperazione degli organuli

Lo studio degli organuli cellulari ha mostrato come le strutture interne si ripetano con piccole variazioni utili al loro funzionamento. Le membrane cellulari, per esempio, sono formate da un doppio strato di molecole di fosfolipidi e altre sostanze, secondo un modulo ripetitivo chiamato “mosaico fluido”. Le membrane interne dei mitocondri e del reticolo endoplasmatico sviluppano superfici enormi in spazi ridotti grazie all’effetto scala, visibile anche nel nucleo, dove i filamenti di DNA possono raggiungere due metri di lunghezza. Questo effetto dimostra come la natura sfrutti lo spazio in modo intelligente: anche se tutto è piccolissimo, ogni parte è organizzata e proporzionata alla sua funzione. Gli organuli collaborano come reparti di una fabbrica: i mitocondri producono energia, i ribosomi costruiscono proteine che sono poi raccolte e modificate dal reticolo endoplasmatico. Così, il funzionamento coordinato tra le parti garantisce il corretto funzionamento della cellula.
DOMANDE GUIDA
a. In che modo la ripetizione delle strutture aiuta gli organuli cellulari a funzionare meglio?
b. Come fa l’effetto scala a permettere che superfici molto grandi, come quelle dei mitocondri o del DNA, stiano dentro spazi così piccoli?
c. Cosa ci insegna l’effetto scala sul modo in cui la natura organizza lo spazio e le funzioni all’interno della cellula?
d. In che modo la collaborazione tra gli organuli rende la cellula un sistema efficiente e vitale?
DIGITAL SKILLS
PER APPROFONDIRE
Ricerca in rete informazioni sul modello a mosaico fluido delle membrane cellulari.
Intelligenza Artificiale IA
Con l’aiuto dell’insegnante chiedi a un chatbot di intelligenza artificiale di fornirti una descrizione della cellula eucariote paragonandola a una città o a una fabbrica.
ITALIANO
La magia della ripetizione lessicale e strutturale nella poesia
La ripetizione è una componente importante della creatività umana: la troviamo in natura, ma anche nella musica, nella pittura e nella poesia. Ripetere non vuol dire rifare la stessa cosa, ma darle più forza, ritmo e significato. In arte molti pittori usano motivi o forme ricorrenti per creare armonia e riconoscibilità, come una firma personale. Anche nella poesia la ripetizione è fondamentale: può riguardare le parole, i suoni oppure la struttura dei versi. Un esempio è il sonetto, composto da 14 versi di undici sillabe ciascuno (chiamati endecasillabi) e diviso in due quartine e due terzine. Le rime seguono schemi precisi: possono essere alternate (ABAB), incrociate (ABBA) o più libere nelle terzine (come CDC DCD o CDE CDE), creando ritmo e musicalità. Questa regolarità aiuta il lettore a entrare in sintonia con il testo, come nella musica tribale, dove i tamburi ripetono lo stesso ritmo variando la velocità e producendo un effetto ipnotico. Forse queste ripetizioni somigliano a quelle presenti nelle strutture cellulari, come se anche il nostro pensiero rifletta il ritmo profondo della vita stessa.
DOMANDE GUIDA

a. Perché la ripetizione è così importante nell’arte e nella poesia?
b. In che modo la ripetizione può rendere un messaggio più forte o più emozionante?
c. Ti è mai capitato di ascoltare una canzone o leggere una poesia dove le parole ripetute ti hanno colpito? Perché?
DIGITAL SKILLS
PER APPROFONDIRE
Ricerca in rete informazioni su artisti che hanno introdotto la ripetizione nelle loro opere d’arte e seleziona le immagini dei quadri che ti colpiscono di più.
Lo studio dei viventi VIVENTI
Quante sono le specie viventi che popolano il pianeta?
Attualmente si conoscono solo 1,8 milioni di specie, considerando i microrganismi, le specie animali e le specie vegetali, ma si ipotizza che la biodiversità della Terra possa raggiungere i 100 milioni di specie!
Tutti coloro che operano nei settori della biologia - dalla microbiologia, alla botanica, alla zoologia - sono al lavoro in tutte le aree del pianeta, in particolare negli ambienti più ricchi di biodiversità come le foreste pluviali, i mari tropicali e gli ambienti marini, alla ricerca di nuove specie: lo scopo di questa ricerca non è solo studiare e catalogare viventi rimasti fino ad ora sconosciuti, ma soprattutto comprendere in che modo gli organismi riescano ad adattarsi alle più diverse condizioni ambientali, anche a quelle più estreme e sfavorevoli alla vita.
2



Ilmicrorganismi mondo dei
3 e delle piante I regni dei funghi unità 4


gli invertebrati Il regno degli animali: unità 5 i vertebrati Il regno degli animali: unità 6
FABIO MOLOGNI, ricercatore universitario
Dopo la laurea in Scienze della Natura con indirizzo botanico, Fabio si è trasferito in Nuova Zelanda, dove ha iniziato lo studio della flora delle piccole isole che compongono l’arcipelago.
Oggi vive in Canada, dove è ricercatore presso l’Università della Columbia Britannica: studia le specie che si sono adattate a vivere in ambienti diversi da quelli d’origine e analizza gli effetti sugli ecosistemi.


ricercatrice universitaria


Dopo il diploma al liceo linguistico, Sarah si è laureata in Scienze Naturali con una interessante tesi sul polpo come indicatore ecologico. In seguito ha intrapreso ricerche sulle macroalghe e sulle microalghe invasive nelle acque della Sardegna. Per anni si è occupata di ecologia marina e vegetali marini. Attualmente conduce un progetto finalizzato a estrarre da alcune alghe invasive del Mediterraneo molecole utilizzabili per produrre medicinali.
LISA
MARIE TALIA, consulente di sostenibilità

Lisa Marie lavora in Olanda in una società che si occupa di sostenibilità ambientale e di analisi del rischio derivante dal cambiamento climatico. Le sue competenze in Ingegneria matematica le permettono di capire a fondo i modelli realizzati per le previsioni del cambiamento climatico. Il suo lavoro consiste nel valutare l’impatto economico che eventi climatici straordinari hanno sulle attività produttive.
Alexander Fleming
3 VIVENTI
Ilmicrorganismi mondo dei unità
lezione 1
I virus
lezione 2
I domini dei batteri
lezione 3
Il regno dei protisti
I virus, parassiti per obbligo VISUAL


LEZIONI POWERPOINT in


BUONE NOTIZIE PER IL FUTURO
Mattoni viventi contro inquinamento
Molte sostanze prodotte dall’uomo si accumulano nell’ambiente senza degradarsi, causando gravi danni alla salute umana e agli ecosistemi. È il caso dei PFAS, composti a base di fluoro usati in numerose applicazioni industriali, dai rivestimenti antiaderenti alle schiume antincendio. Estremamente resistenti, contaminano acqua e suolo e per anni si è pensato che fosse impossibile distruggerli. Una recente scoperta delle Università di Vicenza e Padova ha però identificato batteri del suolo – come Micrococcus, , Pseudoxanthomonas e Achromobacter –capaci di degradare i PFAS con grande efficienza. Questi microrganismi potrebbero essere impiegati per la bonifica biologica dei terreni contaminati, direttamente sul posto, offrendo una speranza concreta per la salute del pianeta.
Anche nel settore delle costruzioni arrivano innovazioni “viventi”. All’Eth di Zurigo, un gruppo di ricerca ha sviluppato biomattoni realizzati con cianobatteri, funghi e microalghe. Questi microrganismi, attivi all’interno di una struttura in gel stampabile, assorbono anidride carbonica dall’atmosfera grazie alla fotosintesi e la trasformano in biomassa e in carbonati solidi. Questo processo, chiamato “doppia cattura del carbonio”, consente non solo di ridurre l’inquinamento, ma anche di rendere il materiale più stabile e duraturo. Due soluzioni diverse, ma con un filo conduttore comune: usare organismi viventi per riparare l’ambiente, ridurre gli impatti dell’attività umana e immaginare un futuro più sostenibile.


Batteri luminosi e dove trovarli
I virus lezione 1
Guarda il video e scrivi le risposte sul quaderno.
CARTA PENNA COMPUTER
1. A quando risale l’identificazione dei primi virus? Perché prima di allora non si era riusciti a osservarli?
2. Che cosa significa patogeno?
3. Perché per curare una malattia virale è inutile somministrare un antibiotico?

Le malattie virali
Metti in pausa il video nei seguenti punti.

4. Quale virus è rappresentato nella figura 1?
5. Descrivi il fenomeno rappresentato nella figura 2.
6. Quale relazione lega la distruzione degli habitat con la diffusione delle malattie virali?


1
Al confine dei viventi
I virus si comportano come dei viventi ma in realtà sono delle strutture biologiche che gli scienziati non collocano in nessuna delle categorie di classificazione dei viventi.
I virus sono delle strutture biologiche con un’organizzazione ancora più semplice di quella della cellula procariote.


I virus non sono cellule: non hanno né membrana cellulare, né nucleo, né organuli cellulari. Essi sono costituiti solo da materiale genetico (DNA o RNA) racchiuso in un involucro fatto di proteine, il capside. All’esterno del capside molti virus possiedono un altro involucro, formato da lipidi e altre molecole 1
I virus sono estremamente piccoli: le loro dimensioni variano tra i 20 e i 200 nanometri (il nanometro è la millesima parte del micrometro ed è equivalente a 10 –9 m). Per questo è possibile osservarli solo con il microscopio elettronico.
ORA FERMA L’IMMAGINE!
1 Struttura dei virus.
2 I virus sono parassiti obbligati
I virus non sono in grado di svolgere le funzioni vitali che caratterizzano tutti i viventi: non crescono, non rispondono agli stimoli, non si nutrono e non sono in grado di produrre energia. L’unica cosa che sanno fare è riprodursi, ma per farlo devono usare le strutture delle cellule che invadono.
Questa condizione rende i virus dei parassiti obbligati, sia delle cellule procariote sia di quelle eucariote.
I batteriofagi sono virus specializzati nell’invadere la cellula procariote che forma i batteri 2
I patogeni sono virus specializzati nell’invadere le cellule eucariote di piante, funghi e animali 3 .
“Virus” è una parola latina che significa “veleno”, perché quando un virus attacca una cellula vi inietta il suo contenuto provocandone la morte.

2 Batteriofagi che iniettano il materiale genetico in un batterio.
I virus patogeni, responsabili di molte malattie che colpisco no anche gli esseri umani, sono specializzati nell’attacca re solo un particolare tipo di tessuto: per esempio, il virus che provoca l’epatite invade solo le cellule del fegato, mentre quello del raffreddore attacca solo le cellule dell’apparato respiratorio.
I virus, non essendo cellule, non sono sensibili agli antibiotici (che agiscono invece sui batteri).
Sono invece attaccati dagli anticorpi, sostanze ad azione specifica prodotte dal sistema immunitario dell’organismo infettato per difendersi 4 .
4 Il metodo più efficace per combattere le malattie virali è la prevenzione, che viene realizzata attraverso le vaccinazioni.

3 Il virus del mosaico del tabacco colpisce molti vegetali. Blocca la fotosintesi e provoca la formazione di macchie gialle o verdi sulle foglie delle piante.

5 Il ciclo riproduttivo di un batteriofago.
3 La riproduzione dei virus
Quando vengono a contatto con una cellula viva, sia essa procariote o eucariote, i virus iniettano il proprio materiale genetico al suo interno, lasciando all’esterno il capside. La strategia di invasione della cellula cambia a seconda che il virus contenga DNA o RNA.
• Se il virus contiene DNA, il materiale genetico iniettato nella cellula si duplica e viene tradotto in RNA. In seguito, i ribosomi della cellula utilizzano l’RNA per fabbricare (in biologia si dice più precisamente “sintetizzare”) le proteine indispensabili per costruire i capsidi che avvolgeranno il DNA di nuovi virus. Bastano 20 minuti perché da un virus ne nascano altri 200. In poco tempo la cellula è piena di virus che escono dalla sua parete, distruggendola. I nuovi virus sono pronti a invadere altre cellule, riprendendo il loro ciclo riproduttivo 5
• Se invece il virus contiene RNA, avviene il processo inverso: l’RNA virale viene copiato in DNA, che si unisce a quello della cellula infettata. In questo modo la cellula ospite produce le sue proteine insieme a quelle del virus.
2. Dopo aver perforato la membrana, il virus inietta il proprio DNA all’interno della cellula batterica.

1. Un virus batteriofago aderisce a un batterio mediante particolari fibre simili a zampe di ragno.


3. Il batterio comincia a produrre il DNA e le proteine del virus.

4. Il DNA e il capside si assemblano formando nuovi virus.


5. La cellula batterica si rompe e i batteriofagi vengono liberati.
Il ciclo riproduttivo dei batteriofagi
4 HIV, il virus che danneggia il sistema immunitario
Il virus HIV 6 colpisce il sistema immunitario umano, il complesso di organi e cellule che ha la funzione di difendere il corpo dalle sostanze estranee e dagli attacchi degli agenti patogeni. La malattia che provoca è l’AIDS. Nelle persone colpite dall’HIV il sistema immunitario è indebolito e mal funzionante: non riesce ad attaccare e distruggere i microrganismi patogeni, né a produrre nuovi tipi di anticorpi. Per questi motivi si possono scatenare le cosiddette malattie opportunistiche: si tratta spesso di malattie rare, come alcune forme di tumore della pelle, che prima dell’avvento dell’AIDS erano quasi sconosciute. Il virus HIV viene generalmente trasmesso quando il sangue di una persona infetta entra nella circolazione sanguigna di un’altra persona. In circa novanta giorni l’organismo reagisce alla penetrazione del virus producendo anticorpi specifici, riconoscibili attraverso una semplice analisi del sangue: la persona è divenuta sieropositiva. Ma non tutte le persone sieropositive sono destinate a sviluppare l’AIDS: ci si ammala soltanto in assenza di cure adeguate.
Con una diagnosi tempestiva e l’assunzione costante di farmaci antiretrovirali, si può restare portatori del virus con una speranza di vita normale. Da quando sono stati studiati i primi casi (1981), la malattia si è diffusa rapidamente in tutto il mondo. Il virus dell’HIV non è un bersaglio facile. Interessa 36,9 milioni di persone in tutto il mondo, dei quali 1,8 milioni sono bambini. Ogni anno, quasi un milione di persone muore perché non sa di aver contratto il virus HIV o perché non ha accesso a medicinali adeguati. Nel 2017 ci sono state quasi 2 milioni di nuove diagnosi.
FISSA I CONTENUTI
ESSENZIALI
Segna con una crocetta se vero (V) o falso (F).
1. Il termine virus significa infezione.
2. I virus possono contenere sia DNA sia RNA.
3. L’involucro esterno dei virus è chiamato capside.
4. I virus sono parassiti obbligati solo degli organismi procarioti.
5. Il raffreddore è una malattia virale.
F V
F V
F V
F V
F V
Prepara una mappa concettuale sull’azione del virus HIV sull’organismo umano. Puoi usare le seguenti parole chiave: HIV, AIDS, malattie opportunistiche, sieropositivo.

6 Rappresentazione del virus HIV.
Perché il simbolo della lotta contro l’AIDS
è un nastrino rosso?
Il nastrino rosso, in inglese Red Ribbon, simboleggia la solidarietà nei confronti di tutte le persone sieropositive e dei malati di AIDS.
Fu ideato nel 1991 da un gruppo di artisti di New York per sensibilizzare l’opinione pubblica sulle problematiche legate a una malattia virale fino ad allora sconosciuta.
Fu scelto il rosso perché è il colore dell’amore e della tolleranza, ma è anche il colore del sangue che veicola il virus. La sua caratteristica forma a “cappio” fu scelta perché facile da realizzare con un singolo pezzo di nastro e può essere appuntato ai vestiti.

Il Red Ribbon è diventato il simbolo della giornata mondiale per la lotta all’AIDS, istituita dall’ONU per non dimenticare una delle epidemie più gravi della storia.
I domini dei batteri lezione 2
LAB STEM
UNA COLTURA DI BATTERI
Non li vediamo ma sono dappertutto: nell’aria, nell’acqua, nel suolo, sopra e dentro il nostro corpo! Possono essere prelevati dall’ambiente per essere “coltivati” in laboratorio: è necessario un terreno di coltura con le sostanze nutritive adatte per moltiplicarsi. Realizza questo esperimento e prepara anche tu un terreno di coltura per i batteri.
■ REALIZZA L’ESPERIMENTO
PROCEDIMENTO
MATERIALI
• una scatoletta di plastica trasparente
• agar agar (o gelatina per dolci e zucchero)


1. Lava molto bene la scatoletta di plastica.
2. Prepara il terreno di coltura con l’agar-agar o con la gelatina per dolci mischiata con lo zucchero.
3. Riempi per metà la scatoletta con il terreno di coltura. Attendi finché la gelatina si rapprende. Con le mani sporche premi il tuo polpastrello sul terreno di coltura (in alternativa, puoi versare sul terreno di coltura qualche goccia dell’acqua di un vaso di fiori o del sottovaso di una pianta).
4. Metti il tuo preparato in un luogo buio e tiepido e attendi.
5. Dopo qualche ora si formano patine colorate sul terreno di coltura. Sono i batteri presenti sui tuoi polpastrelli.
■ OSSERVA E RISPONDI
1. Perché hai pulito bene la scatoletta prima dell’esperimento?
2. Avresti ottenuto lo stesso risultato se, anziché l’acqua dei fiori, avessi usato acqua distillata?
3. Le patine che si sono formate sono di colore uguale?
4. Scrivi la relazione dell’esperimento.
1
Il dominio degli archeobatteri
I primi abitanti della Terra furono organismi formati da un’unica cellula procariote, lo stesso tipo di cellula che forma i batteri attuali. Negli ultimi decenni si sono moltiplicate le scoperte di batteri capaci di vivere nelle acque termali calde a quasi 100 °C, nelle porosità delle rocce, negli abissi degli oceani, nelle acque sature di sali, nel petrolio e anche nei ghiacci dei Poli.
CONTENUTI DIGITALI
Quelli che vivono a grandi profondità consumano poca energia e riescono a sopravvivere per milioni di anni.
I batteri adatti a vivere in condizioni ambientali estreme appartengono al dominio degli archeobatteri.
Gli archeobatteri sono organismi unicellulari formati da una cellula con caratteristiche differenti rispetto agli altri batteri: per esempio, la parete cellulare ha una composizione diversa da quella dei batteri, e anche le molecole di RNA e DNA che contengono sono differenti. Le modalità con le quali questi microrganismi costruiscono le molecole indispensabili per la loro sopravvivenza sono molteplici: esistono archeobatteri capaci di ricavare energia dalla trasformazione dell’anidride carbonica in metano; altri sfruttano reazioni chimiche con sostanze contenenti ferro o zolfo; altri ancora utilizzano come fonte di energia la luce.
Proprio per la loro capacità di sopravvivere in condizioni ambientali estreme, gli archeobatteri sono definiti estremofili 1 .


Le acque delle saline sono l’ambiente ideale per l’Halobacterium salinarum.
Nella solfatara di Pozzuoli, vicino a Napoli, vive l’Acidimethylosilex fumarolicum.
Recentemente sono stati trovati archeobatteri in frammenti di meteoriti caduti sulla Terra circa 4,5 miliardi di anni fa, al momento della formazione del nostro pianeta.
Secondo gli scienziati questi ritrovamenti dimostrano che gli archeobatteri sono in grado di sopravvivere in uno stato di quiescenza (cioè di riduzione delle funzioni vitali) su qualsiasi corpo freddo del Sistema solare e di sopportare le temperature prossime allo zero assoluto dello spazio interplanetario; tuttavia, possono diventare attivi solo in presenza di acqua allo stato liquido.
2 Il dominio degli eubatteri
Il dominio degli eubatteri comprende organismi procarioti e unicellulari, che comunemente chiamiamo batteri. I batteri sono adattati a vivere negli ambienti più diversi e per questo sono gli organismi più diffusi sulla Terra. La membrana plasmatica è rivestita da una parete e, a volte, da un ulteriore involucro gelatinoso chiamato capsula. Il materiale genetico è formato da un unico filamento di DNA attorcigliato. Molti batteri possiedono dei filamenti allungati, i flagelli e i pili 2 , piccole appendici che utilizzano per muoversi.

Archeobatteri in vetrina

Nelle profondità degli oceani vivono archeobatteri che sopportano pressioni elevate e temperature fino a 140 °C: per esempio il Pyrococcus furiosus, che vive nelle acque bollenti in prossimità dei vulcani.
2 Struttura di un batterio.
1 Batteri estremofili.
flagello DNA
parete pili
La classificazione dei batteri in base alla forma.

Lo Streptococcus pneumoniae è un batterio di forma sferica responsabile della polmonite.

I batteri prendono nomi differenti a seconda della forma della loro cellula: i cocchi hanno forma sferica 3 a , i bacilli hanno forma di bastoncello 3 b , i vibrioni hanno forma incurvata simile a una virgola 3 c , gli spirilli hanno forma a spirale o a elica 3 d .


L’Escherichia coli è classificato tra i bacilli.
I batteri si riproducono per scissione binaria, generando due cellule figlie con il materiale genetico identico a quello della cellula madre. In particolari condizioni, però, i batteri possono scambiarsi tratti del materiale genetico in un processo chiamato coniugazione batterica: attraverso un “ponte”, il pilo di coniugazione, frammenti di materiale genetico passano da un batterio “donatore” a un batterio “ricevente”. Grazie a questo processo il batterio ricevente modifica il proprio patrimonio genetico e assume caratteristiche nuove che trasmette a tutti i suoi discendenti.
Un altro criterio per classificare i batteri si basa sul loro modo di produrre energia:
Chi ha scoperto gli antibiotici?
SCIENZA
Oggi esistono un gran numero di antibiotici per curare le infezioni causate da diversi ceppi batterici. Tuttavia, il capostipite di tutti gli antibiotici è la penicillina. Fu il medico e scienziato scozzese Alexander Fleming (1881-1955) a compiere questa straordinaria scoperta: nel 1928 osservò per caso che una muffa, cresciuta accidentalmente in una delle sue piastre di coltura, aveva distrutto i batteri presenti intorno ad essa. Fleming intuì immediatamente che quella muffa poteva essere trasformata in un potente farmaco contro le infezioni batteriche. Per questa scoperta, Fleming ricevette il Premio Nobel per la Medicina nel 1945.
• i batteri aerobi vivono in presenza di ossigeno e lo utilizzano per compiere la respirazione cellulare;
• i batteri anaerobi si sviluppano in assenza di ossigeno e per produrre energia sfruttano il processo di fermentazione;
• i batteri anaerobi facoltativi sono in grado di sopravvivere sia in presenza sia in assenza di ossigeno, e sfruttano il processo di respirazione cellulare o di fermentazione secondo le condizioni ambientali del momento.
Quando le condizioni ambientali diventano avverse, i batteri si trasformano in endospore, cioè si costruiscono uno spesso involucro all’interno del quale rallentano drasticamente le loro funzioni vitali. L’endospora può resistere anche per alcuni anni. Una volta tornate favorevoli le condizioni ambientali, le endospore si aprono e i batteri riattivano le loro funzioni vitali.
Vibrio vulnificus è un vibrione.
Helicobacter pylori è uno spirillo che può vivere nello stomaco umano.
3
Come si nutrono gli eubatteri
Gli eubatteri hanno modalità nutritive differenti:
• i batteri azotofissatori vivono nelle radici delle piante leguminose dove formano dei rigonfiamenti chiamati noduli radicali 4 a . Questi batteri assorbono l’azoto dell’aria e lo “fissano” in composti azotati che cedono alla pianta;
• i batteri decompositori trasformano i rifiuti degli organismi e i resti di animali e vegetali in sostanze più semplici 4 b . Queste poi restano nel terreno e diventano disponibili per le piante;
• i batteri parassiti vivono a spese di un altro organismo, danneggiandolo 4 c . Sono batteri patogeni perché possono provocare malattie;
• i batteri fotosintetici, chiamati anche cianobatteri, sono autotrofi, cioè fabbricano da sé le sostanze nutritive di cui hanno bisogno attraverso la fotosintesi 4 d . Il nome “cianobatteri” si riferisce alla loro particolare colorazione, dovuta a una sostanza che li rende in prevalenza azzurri, anche se esistono cianobatteri violetti e persino rossi. Probabilmente furono i primi organismi fotosintetici comparsi sulla Terra: oggi vivono in tutti gli ambienti acquatici, specialmente nelle acque dolci, dove si riuniscono in colonie di milioni di individui, ma anche nei suoli caldi e ricchi di umidità.

Noduli radicali di batteri azotofissatori attorno alle radici di una leguminosa.

I batteri del genere Pseudomonas sono decompositori.
FISSA I CONTENUTI
ESSENZIALI
Segna con una crocetta se vero (V) o falso (F).

I bacilli del genere Salmonella sono parassiti degli animali.

4 Le diverse modalità nutritive dei batteri.

I cianobatteri del genere Nostoc sono autotrofi.
1. Gli archeobatteri sono in grado di vivere in condizioni ambientali estreme.
2. I batteri di forma sferica sono chiamati spirilli.
3. Le endospore sono una forma di sopravvivenza dei batteri.
4. I batteri anaerobi necessitano dell’ossigeno per vivere.
Il XIX secolo ha visto lo sviluppo di due branche importanti della medicina: l’igiene e la profilassi antibiotica. Dividetevi in gruppi e svolgete ricerche su queste tematiche. Realizzate una presentazione della vostra ricerca immaginando di intervistare i ricercatori e gli scienziati che hanno maggiormente contribuito all’evoluzione di questi due settori della medicina.
Il regno dei protisti lezione 3
CARTA PENNA COMPUTER

La ricerca di Hasler
Guarda il video e scrivi le risposte sul quaderno.

Dai batteri alla cellula eucariote
1. Che cos’è l’endosimbiosi?
2. Come si chiama la scienziata che ha proposto questa teoria?
3. Quali organuli sono stati indicati per primi a favore di questa teoria?
4. Perché le cellule eucariote rappresentano un aumento di complessità nelle forme di vita e un esempio di collaborazione?
1 Il dominio degli eucarioti
Tutti gli organismi, unicellulari e pluricellulari, formati da cellule eucariote, fanno parte del dominio degli eucarioti
1
Un dominio con quattro regni.

Regno dei protisti: eucarioti unicellulari e pluricellulari, autotrofi o eterotrofi.
Questo dominio è diviso a sua volta nei regni dei protisti, dei funghi, delle piante e degli animali. Che cosa hanno in comune tutti questi organismi? L’elemento unificante è la cellula eucariote, cioè una cellula dotata di nucleo e con una complessa struttura interna 1 .

Regno dei funghi: eucarioti eterotrofi, si nutrono per assorbimento; sono pluricellulari, con tessuti poco o per nulla differenziati.
2 I protisti

Regno delle piante: eucarioti pluricellulari con tessuti differenziati e capacità di compiere la fotosintesi.

Regno degli animali: eucarioti eterotrofi, si nutrono per ingestione; sono pluricellulari, con tessuti differenziati.
Il regno dei protisti comprende una straordinaria varietà di organismi diversi tra loro per forme, dimensioni, modi di nutrirsi e di muoversi. Ciò che li accomuna è possedere un’organizzazione strutturale molto primitiva.
Ai protisti appartengono organismi unicellulari (i protozoi, i protofiti, i funghi mucillaginosi e le muffe d’acqua) e organismi pluricellulari, le alghe Esistono protisti che conducono vita libera, protisti parassiti di altri organismi, protisti a riproduzione asessuata e protisti a riproduzione sessuata.
3 I protozoi sono protisti eterotrofi
“Protozoo” deriva da un termine greco e significa “primo animale”: questi microrganismi infatti sono eterotrofi e come gli animali ricavano energia da particelle di cibo o da altre cellule che inglobano nel loro citoplasma.
Il criterio usato per classificare i protozoi si basa sul loro modo di muoversi. Si distinguono così quattro gruppi di protozoi: i flagellati 2 a , i sarcodici 2 b , gli sporozoi 2 c e i ciliati 2 d

2 Esempi di protozoi.


a b c d

I flagellati, come il Trypanosoma brucei, possiedono uno o più flagelli con cui si spostano nuotando.
I sarcodici, come l’Amoeba proteus, si muovono mediante prolungamenti del citoplasma chiamati pseudopodi.
Gli sporozoi, come il Toxoplasma gondii, sono incapaci di muoversi e vivono come parassiti di molti animali.
I protozoi sono una componente importantissima dello zooplancton, quel complesso di piccoli organismi eterotrofi che si lasciano trasportare dall’acqua e che rappresentano, dal punto di vista ecologico, il secondo anello delle catene alimentari acquatiche.
4 I protofiti sono protisti autotrofi
I protofiti sono organismi unicellulari autotrofi fotosintetici, chiamati anche alghe unicellulari Vivono isolati oppure in colonie, sia in mare sia nelle acque dolci, dove costituiscono gran parte del fitoplancton, il primo anello delle catene alimentari acquatiche. Appartengono a questo gruppo:
• le euglene 3 a , caratterizzate da due flagelli; in condizioni di carenza di luce l’euglena può diventare eterotrofa e inglobare piccoli organismi o frammenti di sostanze organiche in decomposizione;
• le diatomee 3 b , dotate di una parete impregnata di silice costituita da due valve che si incastrano come una scatola e il suo coperchio;
• i dinoflagellati 3 c , con due flagelli che permettono loro di avanzare nell’acqua ruotando vorticosamente. Molti dinoflagellati sono luminescenti, cioè producono luce grazie a particolari reazioni chimiche che avvengono nella loro cellula.

I ciliati, come il Paramecium caudatum, si muovono grazie al battito coordinato di numerose ciglia.

a b c

3 Esempi di protofiti.
4 La Fuligo septica è un fungo mucillaginoso.

5 Ogni colonia di alga Volvox è una sfera cava formata da numerosissime cellule.
5 Protisti eterotrofi decompositori
Nel vasto regno dei protisti trovano posto anche unicellulari saprofiti, cioè che si nutrono decomponendo le sostanze organiche. Le muffe d’acqua vivono in ambienti d’acqua dolce dove decompongono i resti di piante e animali. I funghi mucillaginosi amano gli ambienti umidi e ricchi di materia organica in decomposizione. Formano strutture dall’aspetto ramificato che presentano spesso colori molto accesi 4
6 Le alghe sono pluricellulari autotrofi
Le alghe sono organismi pluricellulari fotosintetici molto semplici: le loro cellule, a differenza delle piante, non sono organizzate a formare un tessuto specializzato a svolgere una funzione, ma si susseguono come una serie di tasselli identici. Per questo le alghe sono organismi coloniali 5 .
Una colonia è un gruppo di cellule che, pur vivendo insieme, mantengono la loro individualità.

Una colonia non è un vero e proprio organismo pluricellulare perché ogni cellula, una volta staccata dalla colonia, è ancora in grado di condurre vita autonoma e di svolgere tutte le funzioni vitali. Oltre a non possedere tessuti specializzati, le alghe non hanno vere e proprie radici, né un fusto e nemmeno delle vere foglie. Il corpo delle alghe pluricellulari è a tallo, cioè privo di tessuti specializzati, e può raggiungere dimensioni notevoli senza bisogno di strutture di sostegno, per ché è l’acqua stessa che fornisce il supporto necessario. Le alghe sono suddivise in tre gruppi in base al tipo di molecola (pig mento) che utilizzano per compiere la fotosintesi: le tengono clorofilla, mentre le altri pigmenti che permettono loro di vivere anche nel le acque profonde, dove la quantità di luce solare che riesce a penetrare è molto scarsa.
Le alghe sono cibo per pesci! O no?
SCIENZA
No, anche noi umani le utilizziamo in cucina, in moltissimi piatti. Molte ricette della cucina orientale, come quella cinese e giapponese, utilizzano le alghe nella preparazione di zuppe, creme, contorni, sushi e dolci. Le alghe sono ricche di amminoacidi essenziali, minerali e vitamine. Poiché sono ricche di coloranti naturali, le alghe sono utilizzate per la decorazione in pasticceria, ad esempio il giallo dei gelati è dato dall’alga spirulina, ricca di sostanze nutritive e di proprietà stimolanti ed energetiche. Un’altra alga, l’agar agar, ha proprietà gelificanti e addensanti: senza agar agar non potremmo mangiare la maggior parte dei gelati prodotti dall’industria dolciaria!

FISSA I CONTENUTI ESSENZIALI
Abbina i termini con la definizione corretta.
1 Protozoi
2 Euglene
3 Flagellati
4 Muffe d’acqua
5 Alghe pluricellulari
a Organismi decompositori.
b Protisti che possiedono uno o più flagelli.
c Sono una componente dello zooplancton.
d Organismi coloniali dal corpo a tallo.
e Protisti che compiono la fotosintesi.
1: 2: 3: 4: 5:

VERSO LE COMPETENZE
Osserva l’immagine che rappresenta la distribuzione delle alghe alle diverse profondità.






Rispondi alle domande.


• Che cosa hanno in comune le cellule che formano un’alga e quelle che formano le piante?

• Quali sono le principali differenze tra un’alga e una pianta?
• Quale fattore limitante dell’ambiente marino influisce sulla distribuzione dei diversi tipi di alghe?
Ricerca in rete:
• informazioni sulle alghe di cui compare il nome nello schema;
• informazioni sui diversi utilizzi delle alghe, dall’alimentazione, alla cosmetica, alla produzione di farmaci.
alga verde
alga rossa
40 m
100 m
alga bruna
VISUAL I virus, parassiti per obbligo

I virus sono germi patogeni che, una volta entrati nell’organismo, iniziano a moltiplicarsi e a danneggiare le cellule sane, provocando malattie infettive più o meno serie.
BATTERI INFLUENZALI
I virus sono i più piccoli agenti patogeni, parassiti non cellulari che si riproducono solo all’interno di cellule vive. I batteriofagi colpiscono i batteri, mentre altri virus attaccano cellule animali e vegetali. Non rispondono agli antibiotici, ma vengono contrastati dagli anticorpi. La prevenzione più efficace resta la vaccinazione
Il virus che provoca l’influenza è un adenovirus che ha una forma poliedrica.
I BATTERI “CATTIVI”
I batteri patogeni rappresentano solo una piccola percentuale di tutti i batteri, circa il 3%. Malattie come la polmonite, il colera e la tubercolosi, ma anche molte forme di dissenteria sono provocate da batteri. Le infezioni batteriche si curano somministrando gli antibiotici
Vibrio cholerae, il vibrione che provoca il colera.
FUNGHI CHE CRESCONO NEI TESSUTI
Alcuni funghi microscopici possono superare le difese dell’organismo e causare micosi, colpendo pelle, capelli, unghie e, talvolta, organi interni come i polmoni. La prevenzione si basa sull’igiene: lavare gli indumenti ed evitare ambienti caldo-umidi. Le micosi si curano con prodotti antimicotici applicati sulla zona infetta.
La Candida albicans è un fungo che compone la naturale flora batterica dell’organismo umano. In condizioni di squilibrio dell’organismo può cominciare a proliferare in maniera eccessiva diventando patogena.
Candida albicans responsabile della candidosi.
PROTOZOI PERICOLOSI
I protozoi sono organismi unicellulari eucarioti, alcuni dei quali vivono come parassiti e trasmettono malattie gravi come la malaria e la malattia del sonno, diffuse in molte aree africane. Anche in questo caso, la prevenzione è fondamentale: proteggersi con zanzariere è uno dei modi più efficaci per evitare il contagio e salvare vite.
Trypanosoma brucei responsabile della malattia del sonno.

CON LA SINTESI
lezione 1 I VIRUS
Virus è una parola latina che vuol dire “veleno” perché quando un virus attacca una cellula ne provoca la morte.
I virus non sono organismi viventi, ma strutture biologiche estremamente piccole e semplici: non si nutrono e non respirano e per riprodursi invadono un’altra cellula, usano le sue strutture e ne provocano la morte.
I virus sono costituiti soltanto da una molecola di acido nucleico (DNA o RNA) racchiusa in un involucro di proteine, il capside
I virus sono parassiti obbligati e possono attaccare sia le cellule procariote sia quelle eucariote.
I batteriofagi sono virus specializzati a invadere la cellula procariote che forma i batteri.
I virus patogeni sono specializzati a invadere le cellule eucariote di funghi, piante e animali. I virus patogeni sono responsabili di molte malattie che colpiscono anche gli esseri umani. Per difendersi dai virus il sistema immunitario degli organismi produce gli anticorpi. La terapia più efficace contro i virus è la vaccinazione
lezione 2 I DOMINI DEI BATTERI
I batteri sono gli organismi più diffusi sulla Terra perché riescono a vivere in quasi tutti gli ambienti. Il dominio degli archeobatteri comprende organismi unicellulari che hanno caratteristiche particolari che li rendono capaci di sopravvivere in condizioni ambientali molto difficili, per esempio con temperature molto basse o molto alte, in acque molto salate o con elevate concentrazioni di zolfo.
Il dominio degli eubatteri comprende organismi procarioti unicellulari che sono chiamati batteri. La cellula dei batteri è protetta dalla parete e da un involucro esterno, la capsula, e al suo interno è presente un filamento di DNA chiuso ad anello. Molti batteri per muoversi utilizzano dei filamenti allungati, i flagelli, e spesso sono presenti anche numerose piccole appendici, i pili.


Quando l’ambiente diventa sfavorevole, molti batteri si trasformano in endospore, riducendo al minimo le funzioni vitali.
Una volta tornate le condizioni ambientali favorevoli, le endospore si aprono e i batteri riattivano le proprie funzioni vitali.
I batteri possono essere classificati in base alla loro forma in: cocchi, bacilli, vibrioni e spirilli.
Possono essere classificati in base a come producono energia in: batteri aerobi, che vivono solo in presenza di ossigeno; batteri anaerobi, che si sviluppano in assenza di ossigeno; batteri anaerobi facoltativi, che possono sopravvivere sia in presenza di ossigeno sia in sua assenza, secondo le condizioni ambientali del momento.
Un’altra classificazione può essere fatta in base a come si nutrono. Si classificano in: azotofissatori, che fissano l’azoto dell’aria in composti azotati; decompositori, che trasformano i rifiuti organici in sostanze semplici; parassiti, che vivono a spese di un altro organismo; fotosintetici, come i cianobatteri che sono autotrofi.
lezione 3 IL REGNO DEI PROTISTI
La cellula eucariote è l’unità di base di tutti gli organismi che appartengono al dominio degli eucarioti, che comprende i regni dei protisti, dei funghi, delle piante e degli animali. Il regno dei protisti comprende i protozoi, i protofiti, i funghi mucillaginosi, le muffe d’acqua e le alghe. I protozoi sono gli antenati degli animali, sono eterotrofi e sono classificati in base al modo di muoversi in flagellati, sarcodici, sporozoi e ciliati. I protofiti sono gli antenati delle piante, sono autotrofi e vivono in mare o nelle acque dolci. Le euglene, le diatomee e i dinoflagellati sono protofiti. Le muffe d’acqua e i funghi mucillaginosi sono protisti decompositori che si nutrono di sostanza organica. Le alghe sono organismi fotosintetici che vivono in colonie in cui ogni cellula è indipendente dalle altre e svolge da sola tutte le funzioni vitali. Le alghe sono classificate in tre gruppi in base al colore del pigmento che utilizzano per compiere la fotosintesi: le alghe verdi contengono clorofilla, le alghe brune e le alghe rosse possiedono altri tipi di pigmenti che permettono loro di compiere la fotosintesi anche nelle profondità marine dove arriva poca luce.


CON LA MAPPA
Adesso che hai ripassato i contenuti essenziali con la sintesi, prova a completare la mappa con le parole chiave suggerite e a trovare le definizioni corrispondenti.
archeobatteri - cocchi - eubatteri - parassiti obbligati - procarioti - protisti - virus
1. I MICRORGANISMI

che sono
delle cellule che invadono
4. organismi
possono essere come i che costituiscono un
che possono vivere in ambienti dalle condizioni estreme
classificati in base alla forma in

a. Eubatteri a forma di elica o di spirale.
b. Microrganismi formati da una cellula complessa dotata di nucleo.
c. Sono stati primi abitanti del Pianeta.
d. Vivono solo sfruttando le strutture della cellula che invadono.
13. regno
che comprende molti e diversi organismi
eucarioti 8.
9. bacilli 5.
10. spirilli 11. vibrioni
2.
3. organismi

lezione 1 I VIRUS
1 Segna con una crocetta se vero (V) o falso (F).
a. I virus sono organismi viventi a tutti gli effetti.
b. L’involucro dei virus si chiama capside.
c. Le infezioni virali si combattono grazie agli anticorpi prodotti dal sistema immunitario.
d. I virus sono avvolti da un involucro esterno proteico.
e. Un virus a DNA può riprodursi in 20 minuti replicando se stesso 200 volte.
f. I virus batteriofagi iniettano il proprio codice genetico nei batteri.
2 Scegli la soluzione corretta.
a. La dimensione dei virus è:
1 superiore a 200 nanometri.
2 inferiore ai 20 nanometri.
3 compresa tra 20 e 200 nanometri.
4 compresa tra 20 e 200 micron.
b. I virus patogeni invadono:
1 tutti i tipi di cellule eucariote.
2 le cellule procariote.
3 le cellule batteriche.
4 solo le cellule animali.
c. Il modo più efficace per combattere le malattie virali è:
1 farsi contagiare dai virus.
2 farsi vaccinare.
3 non farsi vaccinare.
4 assumere antibiotici.
d. Il virus dell’HIV:
1 è un sinonimo di AIDS.
2 viene trasmesso per via aerea.
3 scatena malattie opportunistiche.
4 non può essere combattuto con alcun tipo di farmaco.
3 Assegna le frasi alle immagini corrette.


1. I virus patogeni sono virus specializzati nell’invadere le cellule eucariote di piante, funghi e animali.
2. I batteriofagi sono virus specializzati nell’invadere la cellula procariote che forma i batteri.
lezione 2 I DOMINI DEI BATTERI
4 Abbina i termini con la definizione corretta.
1. Archeobatteri
2. Eubatteri
3. Capsula
4. Batteri aerobi
5. Coniugazione batterica
a Scambio di materiale genetico da un batterio “donatore” a uno “ricevente”.
b Sono adatti a vivere in ambienti con condizioni estreme.
c Involucro gelatinoso che ricopre i batteri.
d Organismi procarioti unicellulari chiamati comunemente batteri.
e Vivono solo in presenza di ossigeno.
1. 2. 3. 4. 5.
5 Sottolinea il termine corretto tra i due proposti.
a. Il dominio degli eubatteri comprende organismi procarioti/eucarioti e unicellulari.
b. Molti batteri possiedono piccole appendici dette flagelli/pili.
c. I batteri aerobi/anaerobi sfruttano il processo di fermentazione per produrre energia.
6 Segna con una crocetta se vero (V) o falso (F).
a. Gli eubatteri sono detti anche estremofili.
b. Gli archeobatteri sono stati probabilmente la prima forma di vita sul nostro pianeta.
c. I batteri si riproducono per scissione binaria.
d. Le endospore rappresentano una risposta di sopravvivenza a condizioni ambientali sfavorevoli.
7 Scegli la soluzione corretta.
a. Gli eubatteri sono organismi:
1 eucarioti unicellulari.
2 eucarioti pluricellulari.
3 procarioti unicellulari.
4 procarioti pluricellulari.
b. Negli eubatteri è un organo deputato al movimento:
1 la capsula.
2 la parete cellulare.
3 il DNA.
4 il flagello.
c. Quale dei seguenti gruppi di batteri non si riferisce alla loro capacità di produrre energia?
1 Batteri fotosintetici.
2 Batteri aerobi.
3 Batteri anaerobi.
4 Batteri anaerobi facoltativi.
lezione 3 IL REGNO DEI PROTISTI
8 Sottolinea il termine corretto tra i due proposti.
a. I protisti antenati degli animali sono i protofiti/protozoi.
b. I protofiti sono autotrofi/eteretrofi
c. I saprofiti sono organismi autotrofi/ decompositori.
d. Le alghe sono organismi unicellulari/coloniali
9 Completa le frasi con i termini corretti.
a. Tutti gli organismi, unicellulari e pluricellulari, formati da cellule eucariote, fanno parte del dominio degli .
b. Le euglene sono caratterizzate da due flagelli.
c. Molti sono luminescenti.
d. Le muffe d’acqua vivono in ambienti d’acqua dolce dove i resti di piante e animali.
e. Le alghe sono organismi pluricellulari molto semplici.
10 Indica a quale regno appartengono gli organismi rappresentati nelle fotografie.




11 Scegli la soluzione corretta.
a. Il termine “protofita” in greco significa:
1 primo animale.
2 primo vegetale.
3 primo decompositore.
4 primo batterio.
b. I sarcodici:
1 si muovono grazie ai flagelli.
2 nuotano grazie al movimento delle ciglia.
3 utilizzano gli pseudopodi per spostarsi.
4 non sono in grado di spostarsi.
INTERPRETARE E COMMENTARE UN MODELLO
1 Osserva il disegno e inserisci accanto a ogni termine il numero corrispondente.
a. Fibre
b. Capside
c. Acido nucleico
d. Coda

METTERE IN ORDINE E SPIEGARE UN FENOMENO
2 Metti nella sequenza corretta le fasi del ciclo riproduttivo del batteriofago.





Rispondi alle domande.
a. In che modo il virus si ancora alla membrana del batterio?
b. In quale fase il virus inietta il materiale genetico all’interno della cellula batterica?
c. Che cosa accade all’interno del batterio dopo l’iniezione del DNA virale?
d. Quando la cellula batterica si rompe? Che cosa accade dopo?
INDIVIDUARE CARATTERISTICHE E SPIEGARE
3 Osserva le immagini.

a. Scrivi una didascalia che spieghi le relazioni tra le due fotografie.
b. A quale gruppo di microrganismi appartiene quello rappresentato nella fotografia?
4 Il fenomeno rappresentato nella fotografia è la formazione di un’endospora.

Rispondi alle domande.
a. In quale situazione i batteri formano le endospore?
b. Per quanto tempo possono sopravvivere in questa condizione?
5 Scrivi le definizioni dei tre tipi di batteri e rispondi alle domande.
Batteri anaerobi
Batteri aerobi
Batteri anaerobi facoltativi
Rispondi alle domande.
a. Quale criterio è usato per classificare questi batteri?
b. Quale processo è sfruttato dai batteri quando l’ossigeno scarseggia?
RIFLETTERE E SPIEGARE
6 Rispondi alle domande.
a. Perché i virus sono parassiti obbligati?
b. Perché i batteri sono gli organismi più diffusi sulla Terra?
INTERPRETARE E TRARRE INFORMAZIONI DA UN TESTO
7 Leggi il brano.
BATTERI MANGIA PLASTICA
È stato scoperto un batterio in grado di degradare completamente il PET, il polietilene tereftalato, la plastica usata per produrre tonnellate di bottiglie e contenitori. Il batterio Ideonella sakaiensis è stato presentato sulle pagine della rivista Science da parte di un gruppo di ricercatori di Kyoto, guidati da Shosuke Yoshida, che lo ha scovato in mezzo ad alcuni rifiuti di bottiglie pronte per il riciclaggio. Grazie a tecniche di biochimica e di genetica, i ricercatori sono riusciti a scoprire che il batterio riesce a mangiarsi la plastica grazie a una speciale coppia di enzimi, delle sostanze in grado di attaccare i polimeri costituenti il PET e di ridurli in molecole a base di carbonio di cui il batterio si ciba. Un altro batterio, Pseudomonas putida, sarebbe in grado di digerire i solventi organici che spesso sono i responsabili delle contaminazioni ambientali, fornendo risposte concrete anche ad alcuni problemi legati all’inquinamento ambientale, plastiche comprese. Di fatto, il batterio Pseudomonas putida è utilizzato per una grande varietà di scopi, ma soprattutto per la produzione di poliidrossialcanoati (Pha), un gruppo di polimeri con i quali si possono produrre sostanze termoplastiche, che possono essere facilmente riciclate, o gomme biodegradabili.
c. Qual è la differenza tra alghe verdi, alghe rosse e alghe brune? Come si distribuiscono nelle acque dolci e salate?
d. Quale sistema del corpo umano è attaccato dal virus HIV?
(Tratto e adattato da treccani.it e greenplanner.it) Rispondi alle domande e svolgi le attività proposte, da solo o in gruppo con i tuoi compagni.
a. Quali sono i batteri descritti nell’articolo?
b. Perché sono così importanti nella lotta all’inquinamento da plastica?
c. Come agiscono i due batteri?
d. Quali caratteristiche hanno in comune le termoplastiche e le gomme biodegradabili?
DIGITAL SKILLS
e. Quando una persona diventa sieropositiva?
Svolgi ricerche in rete sull’obiettivo 12 dell’Agenda 2030 con particolare attenzione ai traguardi 12.4 e 12.5.

THE IMPORTANCE OF PROTISTS FOR THE ENVIRONMENT
Protists are a diverse collection of organisms. While exceptions exist, they are primarily microscopic and unicellular. The cells of protists are highly organized with a nucleus and specialized cellular machinery called organelles. Protists play an important role in the environment. Nearly 50 percent of photosynthesis on Earth is carried out by algae. Protists act as decomposers and help in recycling nutrients through ecosystems. In addition, protists in various aquatic environments, including the open water, waterworks and sewage disposal systems feed upon, and control bacterial populations. «If you took all the protists out of the world, the ecosystem would collapse really quickly», said a biologist.
Euglena spirogyra is a species of algae. It feeds by photosynthesis in the light, but uses its flagellum to move about in search of food in the dark.


Foraminifera typically produce a shell, commonly made of calcium carbonate.
lossario
ECOSYSTEM ecosistema
WATERWORKS acquedotto
SEWAGE DISPOSAL SYSTEMS
sistema di smaltimento delle acque reflue
CALCIUM CARBONATE carbonato di calcio

Amoeba are common in both salt and freshwater as well as soil, moss and leaf litter.
COMPREHENSION EXERCISES
Answer the following questions.
a. Why are protists so important for the environment?
Trentepohlia
aurea is a species of terrestrial green alga. It grows on rocks, old walls and the trunks and branches of trees.

b. Can protists help limit water pollution?
c. Could life on Earth survive without protists?



VIVENTI
e delle piante I regni dei funghi unità
lezione 1
Il regno dei funghi
lezione 2
Il regno delle piante

lezione 3
La deforestazione
La radice e il fusto
lezione 4
La foglia
lezione 5 LEZIONI
Fiori, frutti e semi




BUONE NOTIZIE PER IL FUTURO
Le piante, alleate contro il riscaldamento globale
Il riscaldamento globale è la conseguenza dell’aumento continuo delle emissioni di gas serra nell’atmosfera.
Da decenni il mondo scientifico esorta istituzioni e popolazione ad agire per ridurre le cause del loro incremento. Come sarebbe bello avere a nostra disposizione una tecnologia potente ed efficace, in grado di risolvere questo gravissimo problema! Stefano Mancuso, uno degli scienziati più famosi nel mondo per la sua attività di ricerca sulle piante, afferma che questa tecnologia è già a nostra disposizione: sono le piante.
Si tratta di una tecnologia basata sulla vita, in quanto le piante, per la loro capacità di assorbire anidride carbonica per il processo di fotosintesi, sono la soluzione concreta al problema del riscaldamento globale e del cambiamento che ne deriva.
Lo scienziato è uno dei sostenitori più convinti della necessità di piantare mille miliardi di alberi entro il 2030. Sembrerebbe una cifra enorme, ma, se si pensa che negli ultimi due secoli sono stati abbattuti duemila miliardi di alberi, ripiantarne un miliardo non sembra una cosa impossibile!
SCIENCE REEL


Piante velenose: quando l’apparenza inganna
Il regno dei funghi lezione 1
LAB STEM
UNA COLTIVAZIONE DI MUFFE
Una muffa verdastra, che si sviluppa con facilità sulla superficie dei frutti, è all’origine della produzione di una famosa sostanza antibatterica, la penicillina. Prova anche tu a coltivare la più famosa delle muffe, il Penicillum notatum.
■ REALIZZA L’ESPERIMENTO
MATERIALI
• due arance
• batuffoli di cotone idrofilo
• due limoni
• due sacchetti di plastica trasparenti microforati
• una ciotola
• un microscopio ottico







PROCEDIMENTO
1. Strofina le arance e i limoni sul pavimento della stanza e mettili nella ciotola, lasciandoli esposti all’aria per un giorno.
2. In ognuno dei due sacchetti metti un’arancia e un limone, insieme a un batuffolo di cotone idrofilo imbevuto d’acqua.
3. Richiudi accuratamente i sacchetti.
4. Metti un sacchetto in frigorifero e l’altro in un luogo caldo e buio per circa due settimane. Durante questo periodo esegui osservazioni giornaliere sulla frutta, senza aprire i sacchetti.
■ OSSERVA E RISPONDI
1. Quali differenze noti confrontando i frutti conservati in frigorifero e quelli esposti all’aria?
2. Preleva una piccola quantità di muffa dalla superficie dei frutti e osservala al microscopio. Realizza un disegno di quello che vedi.
3. Come hanno fatto le muffe ad arrivare sulla superficie della frutta?
4. Perché i sacchetti devono essere microforati?
5. Che ruolo ha la temperatura ambientale nello sviluppo delle muffe?
6. Scrivi la relazione dell’esperimento.
Né piante né animali
Il regno dei funghi comprende organismi molto diversi tra loro per aspetto e dimensione. Appartengono allo stesso regno i funghi pluricellulari, come quelli dalla tipica struttura a cappello o come le muffe che si formano sulla superficie del formaggio e sulla buccia della frutta, e i funghi unicellulari, come il lievito che viene aggiunto all’impasto del pane per farne aumentare il volume.
Per quanto diversi tra loro, i funghi hanno però in comune il modo di nutrirsi. Sono tutti organismi eterotrofi, come gli animali, perché le loro cellule non contengono la clorofilla, perciò non sono in grado di produrre sostanze nutritive attraverso la fotosintesi, ma le devono assorbire da altri organismi. I funghi, però, presentano anche delle caratteristiche che li rendono simili alle piante: non si muovono, perché sono ancorati al substrato di cui si nutrono, e possiedono dei filamenti, simili a radici, con i quali assorbono le sostanze nutritive e l’acqua.
Non potendo essere classificati né come animali né come piante, è stato necessario creare una categoria tassonomica a parte che li comprendesse tutti: il regno dei funghi.
In base al loro modo di procurarsi le sostanze nutritive, i funghi sono divisi in tre gruppi: i funghi saprofiti, i funghi parassiti e i funghi simbionti I funghi saprofiti ricavano le sostanze nutritive dalla decomposizione di resti vegetali o animali. Per esempio, i funghi a mensola che si sviluppano sugli alberi caduti decompongono le sostanze che formano il tronco 1 a I funghi simbionti vivono in stretta associazione con una determinata specie di organismi ed entrambi ne traggono reciproco vantaggio. La grande maggioranza dei funghi vive in stretta relazione con gli alberi: ricavano dal terreno i sali minerali utili alla pianta e ricevono in cambio gli zuccheri prodotti dalla pianta con la fotosintesi 1 b . La scienza ha osservato che le foreste più rigogliose sono quelle più ricche di funghi. I funghi parassiti si nutrono esclusivamente del materiale contenuto nelle cellule di altri organismi vivi. Per esempio, i funghi chiamati “chiodini” sono parassiti di alcune piante 1 c
2 I funghi a cappello
I funghi che tutti conosciamo, quelli che crescono nei boschi e nei prati, sui ceppi degli alberi, sulle foglie morte o sui resti di vegetali e animali, sono funghi simbionti. Le cellule dei funghi, come quelle delle alghe, non sono differenziate e non formano dei tessuti; sono disposte l’una dopo l’altra a formare dei sottili filamenti, le ife. In genere questi funghi sono costituiti da una parte sotterranea, il micelio, formato da un groviglio di ife, che è l’organo che provvede ad assorbire le sostanze nutritive. La parte che spunta dal terreno è il corpo fruttifero, che svolge la funzione di organo riproduttore, a sua volta formato da un gambo e da un cappello. Sotto il cappello, in strutture a forma di lamelle o di sottili tubuli, maturano le spore. Quando una spora cade in un luogo favorevole, germina, cioè dà origine a un nuovo micelio, da cui si sviluppa un nuovo corpo fruttifero 2





ife che formano il micelio

1 Come si nutrono i funghi.




La struttura di un fungo a cappello.
spore
cappello
3 Ife e sporangi di una muffa cresciuta sulla buccia di un limone.
3 Le muffe e i lieviti

Le muffe sono funghi pluricellulari parassiti, di dimensioni microscopiche. Quando si sviluppano sulla superficie del pane o sulla buccia di un agrume, le muffe hanno un aspetto polveroso; se invece le osserviamo al microscopio appaiono formate da catenelle di cellule tenute insieme, le ife. All’estremità le ife terminano con lo sporangio, una formazione tondeggiante nella quale si sviluppano le spore, proprio come nel corpo fruttifero dei funghi a cappello 3 . Alcune specie di muffe sono parassite di piante e di animali e spesso provocano malattie indicate con il termine di micosi Esistono però anche muffe utili: alcune sono sfruttate per migliorare le caratteristiche di alcuni cibi, per esempio di formaggi come il gorgonzola o il camembert. Dalle muffe, infine, è stato ricavato il primo antibiotico, la penicillina; oggi invece gli antibiotici sono sintetizzati in laboratorio.
sono funghi unicellulari che traggono energia dalle sostanze organiche, soprattutto zuccheri, attraverso il processo di fermentazione. Negli ambienti dove la quantità di ossigeno è ridotta, i lieviti trasformano gli zuccheri in alcol e anidride carbonica. Per questa loro proprietà i lieviti vengono utilizzati nella produzione di bevande alcoliche, come il vino e la birra, e nella panificazione, dove la fermentazione dell’amido contenuto nella farina di grano fa lievitare, cioè gonfiare, la pasta e la rende più soffice e digeribile.
4 I licheni

sono una simbiosi fra un’alga, cioè un organismo autotrofo, e un fungo, cioè un organismo eterotrofo, che vivono insieme scambiandosi sostanze nutritive. Si tratta di organismi pionieri, capaci di colonizzare ambienti in cui le condizioni di vita sono particolarmente difficili, come le rocce, i muri, le cortecce degli alberi 4 . L’alga, poiché svolge la fotosintesi, produce gli zuccheri di cui si nutre anche il fungo; da parte sua il fungo rifornisce l’alga di acqua e sali minerali che assorbe dalla superficie su cui poggia.
La classificazione dei funghi
I funghi sono suddivisi in tre gruppi in base al tipo di riproduzione e al corpo frut-
Gli zigomiceti comprendono organismi formati da un’unica ifa che contiene numerosi nuclei cellulari. Normalmente si riproducono asessualmente attraverso le spore prodotte negli sporangi. Tuttavia, in condizioni ambientali avverse possono riprodursi sessualmente. In questi casi le ife che contengono le spore sessuate si allungano le une verso le altre fino a unirsi e a formare una nuova cellula. Comprendono alcune muffe, come la muffa del pane. ascomiceti possiedono particolari strutture a forma di sacco, gli aschi, all’interno delle quali sono prodotte le spore. Gli ascomiceti si possono riprodurre anche per semplice divisione cellulare e per gemmazione. Appartengono agli ascomiceti i lieviti, i tartufi e molte delle muffe colorate che ricoprono i cibi in decomposizione o attaccano i raccolti di frutta.
• Il gruppo dei basidiomiceti comprende gli organismi che vengono denominati “funghi” anche nel linguaggio comune: i funghi commestibili, i funghi velenosi, le vesce dal caratteristico corpo globoso e i funghi a mensola 5 . Nei basidiomiceti le spore sono prodotte all’interno dei basidi, sacche a forma di clava che si trovano nella parte inferiore del cappello.
5 Il porcino (a) è un basidiomicete commestibile; l’Amanita phalloides (b) invece è un basidiomicete velenoso.


FISSA I CONTENUTI ESSENZIALI
Abbina i termini con la definizione corretta.
1 Saprofiti
2 Micelio
3 Lieviti
4 Licheni
5 Ascomiceti
6 Zigomiceti
È vero che i tartufi fanno ammalare gli alberi?
I tartufi sono funghi ascomiceti del genere Tubor; vivono attaccati alle radici degli alberi per assorbire le sostanze organiche che fabbricano le piante. L’aspetto tondeggiante e l’adesione ai filamenti radicali li fa assomigliare a escrescenze dall’aspetto poco invitante.
SCIENZA CHE
I tartufi, invece, non sono una malattia della pianta: la stretta coesione tra albero e tartufo è una forma di simbiosi che prende il nome di micorrize. Questa simbiosi non produce danni all’albero, ma anzi migliora le capacità di assorbimento dei nutrienti da parte delle radici, rende la pianta più resistente alla siccità e la protegge dall’attacco di funghi patogeni e vermi.

a Funghi unicellulari che attivano il processo della fermentazione.
b Simbiosi fra un fungo e un’alga.
c Funghi dotati di particolari strutture a sacco all’interno delle quali sono prodotte le spore.
d Funghi che ricavano le sostanze nutritive dalla decomposizione di resti organici.
e Organo del fungo che provvede ad assorbire le sostanze nutritive.
f Comprendono organismi formati da un’unica ifa che contiene numerosi nuclei cellulari.
1: 2: 3: 4: 5: 6:
VERSO LE COMPETENZE
Ricerca in rete il significato della parola fermentazione e individua quali organismi, oltre i lieviti, la attuano. Si tratta solo di organismi unicellulari o anche di organismi pluricellulari? In quali processi utili all’uomo vengono utilizzati? Si tratta solo di processi in campo alimentare o anche in campo industriale?
Il regno delle piante lezione 2
CARTA PENNA COMPUTER

Esplora l’oggetto interattivo e scrivi le risposte sul quaderno.

L’evoluzione delle piante
1. Quali organismi sono i progenitori delle piante attualmente presenti sul nostro pianeta?
2. In che cosa si differenziano le cellule dei funghi rispetto a quelle delle piante?
3. Che cosa significa “organismi con il corpo a tallo”? E “organismi con il corpo a cormo”? Fai un esempio per ciascun gruppo.
4. Quali gruppi di piante non dipendono dall’ambiente acquatico per la loro riproduzione? Quali adattamenti hanno evoluto?
1 Le piante e le loro caratteristiche
1 Le piante usano l’energia del Sole per produrre glucosio.

L’erba dei prati, gli alberi di una foresta, le siepi, gli alberi da frutto, il muschio del sottobosco sono tutti delle piante: ciò che accumuna questi organismi è la fotosintesi, il processo chimico che avviene nelle foglie e nelle loro parti verdi. Utilizzando la luce del Sole come fonte di energia, e sostanze semplici, cioè l’acqua, i sali minerali e l’anidride carbonica gassosa, le cellule autotrofe delle piante producono lo zucchero glucosio e altre sostanze nutritive necessarie alla loro sopravvivenza 1 Il processo è di fondamentale importanza per tutte le forme di vita sulla Terra. Le piante, infatti, sono i produttori alla base di tutte le catene alimentari, perché costituiscono la fonte primaria di cibo per tutti gli animali, esseri umani compresi. Inoltre, come sostanza di rifiuto del processo di fotosintesi, le piante producono ossigeno, il gas fondamentale per la respirazione dei viventi e delle piante stesse.
Le piante sono organismi pluricellulari formati da cellule eucariote e autotrofe.
2 Piante con il corpo a tallo
Il lento passaggio che portò i vegetali acquatici ad adattarsi a vivere sulla terraferma è iniziato circa 500 milioni di anni fa. L’ambiente terrestre offriva notevoli opportunità per i primi organismi autotrofi: non esistevano altre forme di vita con le quali entrare in competizione, l’atmosfera era ricca di anidride carbonica e la luce molto più intensa di
La ricerca di Hasler
CONTENUTI DIGITALI
quella filtrata dalle acque. C'erano, però, molti nuovi problemi da risolvere: l'aria non forniva alcun sostegno agli organismi e favoriva la perdita di acqua per evaporazione. Le prime piante che cercarono di adattarsi a queste difficili condizioni ambientali furono le briofite
Le briofìte sono piante di piccole dimensioni, nelle quali si può distinguere una parte basale che si ancora al substrato, il rizoide, e una parte apicale fornita di numerose espansioni verdi. Il corpo è ancora a tallo, perché non sono presenti veri e propri tessuti.
Le briofite sono piante terrestri molto primitive, di piccole dimensioni e con corpo a tallo.
Il phylum delle briofite è suddiviso in due classi: i muschi e le epatiche
I muschi ricoprono i terreni nelle zone fresche e ombreggiate e le epatiche vivono in ambienti umidi 2 . Sebbene rappresentino il primo tentativo delle piante di rendersi indipendenti dall’ambiente acquatico, le briofite dipendono ancora dall’acqua per riprodursi 3
3 Il ciclo vitale del muschio.
cap sula spore
1. Sulle piante femminili si sviluppa lo sporofito che sorregge una capsula piena di spore.
2 Le epatiche possiedono espansioni simili a foglie.

2. Quando cadono sul terreno umido, le spore germinano e originano nuove piantine.

5. Dall’unione dei gameti si forma uno zigote, che darà origine a un nuovo sporofito.
sporofito


gametofiti


3 Piante con il corpo a cormo

Le piante con tessuti specializzati per il trasporto dei liquidi sono dette piante vascolari, o tracheofite. rizoide
3. Le piantine di muschio, dette gametofiti, producono i gameti maschili e i gameti femminili in strutture particolari situate all’apice delle piante.
4. I gameti maschili raggiungono i gameti femminili.
Le briofite furono le prime piante a conquistare le terre emerse, ma riuscirono a occupare solo spazi ristretti vicini all’acqua. Per conquistare il resto degli ambienti terrestri, le piante hanno dovuto mettere in atto altre strategie, specialmente per trattenere l’acqua e farla arrivare a tutte le parti del corpo in modo più efficiente. A tale scopo, le cellule delle piante si sono via via specializzate, formando diversi tipi di tessuti per il sostegno, il rivestimento e il trasporto dei liquidi. In particolare, nelle piante terrestri si sono sviluppati i tessuti per il trasporto, chiamati tessuti vascolari.

Che cosa succede se…
4 Classificazione generale delle piante.

Le pteridofite.
Le tracheofite possiedono un corpo a cormo, cioè dotato di organi specializzati: le radici, per l’ancoraggio e l’assorbimento, il fusto, per il sostegno e il trasporto dei fluidi, le foglie, per la fotosintesi. Comprendono il phylum delle pteridofite e il phylum delle spermatofite, divise a loro volta in gimnosperme e angiosperme 4
BRIOFITE TRACHEOFITE

SPERMATOFITE

ANGIOSPERME
4 Le pteridofite, le prime piante vascolari
Le pteridofite furono le prime piante di una certa dimensione che riuscirono a conqui stare le terre emerse grazie ai vasi conduttori di cui sono dotate. Hanno un fusto sotterraneo dal quale si sviluppano radici e foglie; sono piante primitive, perché dipendono ancora dall’acqua per la riproduzione, che avviene mediante spore 5 . Sono pteridofite le felci, i licopodi e gli equiseti. Le felci vivono negli ambienti umidi e ombrosi. Le loro foglie, chiamate fronde, sono ampie e finemente suddivise 6 a . I licopodi possiedono foglie piccole, a forma di squame e disposte a spirale attorno al fusto 6 b . Gli equiseti, o “code di cavallo”, hanno foglie sottili disposte a raggiera ai nodi del fusto 6 c
5 Il ciclo vitale della felce.

4. Dalla fusione dei gameti si forma uno zigote che darà origine a una nuova piantina (lo sporofito).

gamete femminile
3. Il protallo è il gametofito e produce i gameti maschili e i gameti femminili.

1. Lo sporofito produce, sulla pagina inferiore delle foglie, dei corpuscoli tondi di colore giallo, i sori, all’interno dei quali maturano le spore.

sporofito




spore sori
gameti maschili

protallo

gametofito
2. Le spore, germinando, originano una laminetta verde a forma di cuore, il protallo
5 Le spermatofite, le piante con semi
Le spermatofite hanno la caratteristica di riprodursi attraverso i seme è formato da un rivestimento rigido che protegge l’embrione della nuo va piantina, insieme a una riserva di sostanze nutritive indispensabili per la sua sopravvivenza.
La particolare struttura del seme ha permesso alle spermatofite di diven tare le piante più adatte alla vita sulla terraferma e di resistere alle condi zioni ambientali più difficili, per esempio l’assenza di acqua.
Le spermatofite si dividono in due gruppi: le gimnosperme e le angiosperme

• Il termine gimnosperma significa “pianta a semi nudi”: queste piante, infatti, non possiedono frutti che proteggono i semi, ma delle strutture legnose, chiamate pigne o coni, simili a fiori primitivi. Le squame che costituiscono i coni sostengono i semi senza racchiuderli al loro interno. Le gimnosperme più diffuse sono le conifere, come gli abeti, i pini, i larici e i cipressi.
• Il termine angiosperma significa “pianta con semi racchiusi”. Le angiosperme, infatti, producono semi racchiusi all’interno del frutto. Il seme ha origine dall’ovulo fecondato che si sviluppa nell’ovario, all’interno della struttura adibita alla riproduzione, il fiore Tutte le angiosperme sono piante con fiori; comprendono non solo i vegetali con i fiori appariscenti, ma anche la maggior parte dei grandi alberi, tutte le piante da frutto, le verdure, le piante erbacee 7
Le angiosperme sono le piante più diffuse (oltre 250 000 specie) e sono presenti in quasi tutti gli ambienti della Terra.
FISSA I CONTENUTI ESSENZIALI
Segna con una crocetta se vero (V) o falso (F).
1. Il corpo a tallo è formato da tessuti specializzati.
2. Le briofite sono piante vascolari molto semplici.
3. Le pteridofite sono piante con fiori.
7 Angiosperme, piante di successo.

4. Le angiosperme sono piante di piccole dimensioni che vivono in ambienti molto umidi.
5. Le gimnosperme si riproducono grazie a strutture legnose detti coni o pigne.
6. Le pteridofite sono piante vascolari.
7. Le felci sono angiosperme.
VERSO LE COMPETENZE
Indica a quale phylum appartengono le piante rappresentate nelle immagini.




SKILL BOOK
ESTETICA DELLA NATURA
CHE COS’È LA SEQUENZA DI FIBONACCI?
VISUAL La deforestazione

La deforestazione è uno dei più gravi problemi ambientali della nostra epoca: il taglio massiccio di alberi, a un ritmo più veloce rispetto al tempo necessario perché le piante possano ricrescere, altera e, nei casi più gravi, distrugge, gli habitat delle piante e degli animali che vivono in quell’ecosistema.
In passato la deforestazione, o diboscamento, è stata praticata per diversi motivi: ottenere legna da ardere o legname da costruzione, ricavare cellulosa, che è la materia prima con cui si produce la carta, creare nuovi terreni da destinare alle colture.
Oggi la deforestazione è praticata principalmente nei paesi in via di sviluppo, per rispondere alle richieste dei mercati dei paesi più ricchi come Europa e Stati Uniti, dove sono molto apprezzati i legni pregiati e alcuni prodotti agricoli come tè, caffè e cacao, coltivati nell’America del Sud, in Africa e in Asia. Questi prodotti rappresentano per le popolazioni locali un’importante fonte di reddito e per questo motivo, nelle aree a clima tropicale, le foreste spesso vengono bruciate: la cenere infatti è un buon fertilizzante per il suolo, ma l’effetto è solo temporaneo e dopo pochi anni il terreno viene abbandonato 1 .
LE CONSEGUENZE DELLA DEFORESTAZIONE
A che cosa ci porterà tutto questo?
Le foreste hanno un ruolo biologico importantissimo per la vita sulla Terra: la composizione dell’aria e il clima dell’intero pianeta dipendono dalla loro salute. Modificare e ridurre la superficie coperta dalle foreste vuol dire creare uno squilibrio che coinvolge tutto il pianeta! Attraverso la fotosintesi le piante producono ossigeno e assorbono anidride carbonica, mantenendo l’equilibrio atmosferico tra questi due gas. Ogni albero produce in media 25 litri di ossigeno al giorno e que sto spiega perché la foresta pluviale è spesso chiamata il “ mondo”.
Anche il ciclo dell’acqua è controllato dalle foreste: attraverso la traspira



CAUSE DI IERI... E DI OGGI

zione, le piante immettono vapore acqueo, che condensa e forma le nuvole dalle quali si originano le precipitazioni

. Il taglio indiscriminato delle foreste distrugge questa “fabbrica delle nuvole” provocando cambiamenti nel clima e aumentando la concentrazione di anidride car-
La mancanza di copertura forestale lascia il suolo senza protezione e lo rende poco compatto; così, quando le piogge sono particolarmente intense, possono avvenire alluvioni, frane e smottamenti.

3 Logo FSC.
Durante la COP26 che si è tenuta nel 2022, è stata firmata dai rappresentanti di 110 paesi la Dichiarazione dei Leader di Glasgow sulle Foreste e l’Uso del Suolo. I paesi firmatari del documento si sono impegnati a fermare la deforestazione entro il 2030. Nella dichiarazione si legge: “Proteggere la nostra foresta non è solo una linea d’azione per affrontare il cambiamento climatico, ma anche per un futuro più prospero”. Per questi motivi i leader si sono impegnati a rafforzare i loro sforzi per conservare le foreste e per accelerare gli interventi di ripristino di tutti gli ecosistemi terrestri, oltre che a facilitare le politiche di sviluppo economico e di commercio sostenibili, a livello internazionale e nazionale. La dichiarazione ha, inoltre, lo scopo di attuare politiche e programmi agricoli per ridurre la fame e favorire l’ambiente. Anche noi, ciascuno nella propria vita quotidiana, possiamo contribuire al raggiungimento di questi obiettivi, peraltro già presenti nel goal 13 dell’Agenda 2030.
Scegliamo prodotti con la certificazione FSC, Forest Stewardship Council 3 , che garantisce la provenienza di cellulosa da foreste e piantagioni autorizzate e controllate. Preferiamo i prodotti in carta riciclata, in modo da consumare meno carta ed aiutare le foreste a crescere. Ma soprattutto raccontiamo a chi ci è vicino quello che abbiamo imparato sulle foreste. Si ama e si protegge più facilmente ciò che si conosce!

AFFRONTIAMO IL PROBLEMA TUTTI INSIEME
2 Le foreste influenzano il clima.
MATERIALI
• forbici
• bottiglie di plastica
• coloranti alimentari di diversi colori
• fiori con petali bianchi




3
La radice e il fusto
LAB STEM
FIORI CHE CAMBIANO COLORE
Acqua e sali minerali sono indispensabili per la vita delle piante. Dal suolo, questi composti devono percorrere le radici e il fusto, e raggiungere le foglie, che sono i “laboratori chimici” della pianta dove viene prodotto il nutrimento. Come riesce l’acqua a compiere il lungo percorso dalle radici alle foglie? Con questa semplice esperienza potrai renderti conto del passaggio di fluidi attraverso il corpo di una pianta vascolare.
■ REALIZZA L’ESPERIMENTO
PROCEDIMENTO
1. Usa le forbici per tagliare la parte alta delle bottiglie di plastica, in modo da ottenere dei contenitori.
2. Riempi d’acqua i contenitori e versa in ciascuno qualche goccia dei diversi coloranti.


3. Con le forbici, taglia in diagonale i gambi dei fiori.
4. Disponi qualche fiore in ogni bottiglia e lascia che assorbano l’acqua per almeno 12 ore.
■ OSSERVA E RISPONDI
1. Come appaiono i petali dei fiori dopo 12 ore?
2. Che cosa è accaduto all’interno dei gambi dei fiori?
3. Come pensi che avvenga la risalita dei fluidi all’interno del fusto?
4. Scrivi la relazione dell’esperimento.
1
La radice
In una pianta le strutture di sostegno sono due: la radice e il fusto. Le radici svolgono molteplici funzioni:
• fissano la pianta al suolo, impedendo che il vento, la pioggia o il suo stesso peso la abbattano;
• assorbono dal terreno l’acqua e i sali minerali che costituiscono la linfa grezza;
• in alcune piante accumulano delle sostanze di riserva, in particolare l’amido; sono radici di questo tipo le carote, le rape e i ravanelli.
CONTENUTI DIGITALI
La radice è l’organo che àncora la pianta al terreno, assorbe acqua e sali minerali indispensabili per la fotosintesi, accumula sostanze di riserva.
L’insieme di tutte le radici di una pianta forma il suo sistema radicale che può essere a fittone, fascicolato o avventizio I sistemi radicali a fittone, come quello della cipolla, sono formati da una parte centrale grossa e robusta dalla quale si sviluppano piccole radici laterali 1 a . I sistemi radicali fascicolati, come quello della pianta del mais, sono formati da fasci di radici più o meno della stessa lunghezza 1 b . I sistemi radicali avventizi, come quelli dell’edera e di tutti i rampicanti che si accrescono attaccandosi ai muri e ad altre piante, si sviluppano alla base del fusto e lungo i rami 1 c .
Nella maggior parte delle piante le radici si sviluppano sotto terra, ma esistono anche radici che emergono dal terreno per sostenere meglio il fusto.


2 Le parti della radice

1 Sistemi radicali a confronto.
Nella radice è possibile distinguere tre parti che svolgono diverse funzioni: l’apice radicale, la zona di assorbimento e la zona di accrescimento 2
linfa grezza
linfa elaborata
pelo radicale


L’apice radicale è la parte finale, formata da cellule che si riproducono di continuo permettendo alla radice di penetrare nel terreno. È rivestito dalla cuffia, un cappuccio di cellule che produce sostanze lubrificanti e favorisce la penetrazione delle radici nel terreno.



apice radicale
Le mangrovie sono alberi tropicali?
Diversamente da quello che spesso si sente dire, le mangrovie non sono piante, ma formazioni vegetali di piante diverse che crescono lungo le coste basse e sabbiose dei mari tropicali, nelle lagune salmastre e negli estuari costieri. Le mangrovie formano ecosistemi estremamente importanti e ricchi di biodiversità. Il fitto intreccio delle radici delle mangrovie, che emerge ed è sommerso ad ogni cambio di marea, offre riparo a numerosi animali acquatici e costituisce un habitat protettivo dove i pesci giovani possono crescere e svilupparsi al sicuro prima di diventare adulti. Le mangrovie hanno anche un’altra proprietà importante: possono trattenere una quantità di anidride carbonica per ettaro dieci volte superiore rispetto alle foreste terrestri.
SCIENZA


zona di assorbimento
zona di accrescimento
cellule della cuffia

2 La struttura della radice.
La zona di assorbimento è ricca di sottili prolungamenti, i peli radicali, che assorbono acqua e sali minerali. Queste sostanze costituiscono la linfa grezza e vengono convogliate verso il cilindro centrale dove si trovano i vasi conduttori.
La zona di accrescimento è formata da cellule generate nell’apice radicale che si sviluppano in lunghezza, facendo accrescere le radici.
DEBATE ALBERI IN CITTÀ

3 Rappresentazione di una sezione trasversale di radice.
Se sezioniamo una radice, possiamo osservare i diversi tipi di tessuti che la formano 3 All’esterno si trova l’epidermide, il tessuto di rivestimento dal quale si sviluppano i peli radicali; sotto l’epidermide c’è la corteccia, formata da diversi strati di cellule nelle quali si accumulano le sostanze di riserva. Nella parte più interna si trova il cilindro centrale formato dai vasi conduttori: i vasi legnosi e i vasi cribrosi.
• I vasi legnosi hanno il compito di trasportare l’acqua e i sali minerali, cioè la linfa grezza o linfa ascendente, dalle radici alle foglie. Essi sono formati da cellule morte, di forma cilindrica e vuote all’interno, disposte le une sopra le altre in modo da formare dei tubicini, di diametro inferiore al millimetro, che collegano le radici alle foglie.
• I vasi cribrosi trasportano le sostanze nutritive prodotte dalle foglie, cioè la linfa elaborata o linfa discendente, dall’alto verso il basso. Essi hanno un diametro che va dai 20 agli 80 µm; sono formati da cellule vive, disposte le une sopra le altre, che comunicano tra loro attraverso una parete bucherellata. È attraverso i forellini di questo “colino”, che la linfa elaborata scende nelle diverse parti della pianta, sino alle radici.
3 Il fusto
Il fusto ha la funzione di sorreggere il carico dei rami e delle foglie; inoltre trasporta la linfa grezza dalle radici alle foglie e la linfa elaborata dalle foglie alle diverse parti della pianta. I fusti possono essere pieni, come quelli degli alberi, cavi, come quelli del bambù e del grano, erbacei, cioè verdi e flessibili come gli steli e i gambi delle piante erbacee, legnosi, come quelli robusti ma privi di clorofilla verde che formano gli arbusti. Il fusto è composto da un asse principale, a forma di cono, che termina con la gemma apicale: è formata da cellule destinate a differenziarsi in tessuti adulti, che permettono la crescita del fusto in altezza. Il fusto presenta numerose altre zone di crescita in corrispondenza delle gemme laterali, da cui hanno origine nuovi rami, e delle gemme ascellari, da cui si sviluppano le foglie e i fiori 4 SKILL BOOK
pelo radicale
epidermide

corteccia

vasi legnosi


Le parti del fusto.
apicale

ascellare








vasi cribrosi
gemma
gemma
ramo laterale
fusto
radici
In alcuni casi, il fusto si modifica e funziona da organo di riserva, diventando bulbo oppure tubero.
Se sezioniamo trasversalmente il fusto di un albero possiamo distinguere diversi strati sovrapposti 5
La corteccia protegge il fusto dagli sbalzi di temperatura e dai parassiti. È formata dal sughero, un tessuto costituito da cellule morte e piene d’aria. L’epiderma è lo strato più esterno, formato da cellule impermeabili. Nei fusti legnosi è ispessito e costituisce la corteccia.
5 Gli strati del fusto.
Il cilindro centrale è composto verso l’esterno dai vasi cribrosi e da cellule fibrose che costituiscono il libro, e verso l’interno dai vasi legnosi e da fibre di sostegno che formano il legno

Il cambio divide il legno dal libro. Le cellule del cambio, dividendosi, producono nuovi vasi legnosi verso l’interno e nuovi vasi cribrosi verso l’esterno, determinando l’accrescimento in larghezza del fusto.
FISSA I CONTENUTI ESSENZIALI
Abbina i termini con la definizione corretta.
1 Radici
2 Peli radicali
3 Vasi legnosi
4 Fusto
5 Bulbo
Il midollo è formato da un tessuto che immagazzina le sostanze di riserva.
a Ha la funzione di sorreggere il carico dei rami e delle foglie.
b Hanno il compito di trasportare la linfa grezza.
c Ancorano la pianta al suolo.
d Fusto trasformato in organo di riserva.
e Sottili prolungamenti nella zona di assorbimento.
1: 2: 3: 4: 5:
midollo
legno
cambio
libro
corteccia
La foglia lezione 4
CARTA PENNA COMPUTER

Guarda il video e scrivi le risposte sul quaderno.

A ogni albero la sua foglia
1. Quali sono i criteri di classificazione delle foglie?
2. Elenca tutte le forme che possono avere le foglie.
3. Pensa alle piante che conosci: che forma hanno le foglie?
4. Che cosa pensi che siano le nervature della foglia?
5. Ritieni possa esistere una relazione fra nervatura e forma della foglia?
6. Elenca i tipi di margini che possono avere le foglie.

nervature
Come è fatta la foglia
picciolo a b
lamina fogliare

La maggior parte delle foglie è piatta e sottile, in modo da poter esporre meglio alla luce del Sole i cloroplasti, gli organuli cellulari che compiono il processo di fotosintesi.
foglie sono gli organi della pianta in cui avvengono la fotosintesi, la traspirazione e la respirazione.
Osservando una foglia si può notare che essa è costituita da diversi elementi 1 a :
picciolo, un sottile cilindro che la sorregge e la inserisce nel ramo; al suo interno passano i vasi legnosi e i vasi cribrosi che provengono dal fusto. Alcune foglie sono prive di picciolo e si inseriscono direttamente sul fusto; lamina fogliare, una superficie ampia e sottile; si distinguono due facce, la pagina superiore (di colore verde intenso) e la pagina inferiore (di colore più chiaro); nervature , un insieme di sottili canali che percorrono tutta la foglia; sono le ramificazioni dei vasi legnosi e dei vasi cribrosi del fusto. A seconda dell’ambiente di vita, le piante hanno sviluppato particolari adattamenti che si possono osservare anche nella struttura delle loro foglie.
Per esempio, la pianta acquatica Victoria amazonica possiede foglie enormi che possono raggiungere i 3 m di diametro. La pagina inferiore è ricoperta di spine che difendono la pianta dai pesci, mentre la fitta e robusta rete di nervature consente di accumulare aria e mantenere a galla le grandi foglie 1 b
La ricerca di Hasler
Se esaminiamo al microscopio la sezione di una lamina fogliare possiamo individuare diversi strati di cellule: l’epidermide superiore, il tessuto a palizzata, il tessuto lacunoso e l’epidermide inferiore 2
L’epidermide superiore riveste e protegge la foglia. L’ampia superficie favorisce il processo di fotosintesi, ma aumenta la perdita di acqua per evaporazione. Per questa ragione l’epidermide è coperta a sua volta da una cuticola cerosa che la rende impermeabile.
cellula di guardia
nervatura
xilema floema

L’epidermide inferiore è provvista di piccole aperture, gli stomi, attraverso i quali passano l’anidride carbonica, l’ossigeno e il vapore acqueo. Gli stomi si possono aprire o chiudere secondo le condizioni atmosferiche e le necessità della pianta, regolando così gli scambi gassosi tra la foglia e l’ambiente esterno.
2
La fotosintesi
epidermide inferiore
2 Dentro la foglia.
epidermide superiore
cuticola stoma
tessuto a palizzata
tessuto lacunoso cuticola
cellula di guardia stoma
La parte interna della foglia è costituita da due strati di tessuti: il tessuto a palizzata, a contatto con la pagina superiore, è formato da cellule allungate e ricche di cloroplasti; il tessuto lacunoso, a contatto con la pagina inferiore, è costituito da cellule di forma irregolare e con spazi vuoti in cui circola l’aria.

La foglia funziona come un “laboratorio” nel quale viene pro dotto il nutrimento della pianta, utilizzando come energia la luce del Sole, e come materie prime l’acqua e l’anidride car bonica. La pianta assorbe l’acqua del terreno grazie alle ra dici e introduce l’anidride carbonica dell’aria attraverso gli stomi 3 .
La fotosintesi è l’insieme delle reazioni che portano l’anidride carbonica e l’acqua a combinarsi tra loro per formare molecole di glucosio e ossigeno.
3 La fotosintesi.
ossigeno










luce
anidride carbonica
linfa elaborata
acqua e sali minerali
linfa grezza
4 Cloroplasti al microscopio nelle cellule vegetali.

5 Schema della reazione della fotosintesi.
Questo processo avviene nei cloroplasti, che sono ricchi di clorofilla, un pigmento verde che cattura l’energia del Sole, indispensabile per dare l’avvio alla reazione 4 La fotosintesi si compone di diverse reazioni chimiche che sono raggruppate in due fasi:
• la prima è chiamata fase luminosa perché richiede la presenza della luce solare;
• la seconda è chiamata fase oscura perché può svolgersi anche senza la luce.
Durante la fase luminosa la pianta cattura l’energia luminosa del Sole grazie alla clorofilla e la utilizza per scindere le molecole di acqua in idrogeno e ossigeno. L’ossigeno esce dalla foglia e si libera nell’atmosfera.
Durante la fase oscura l’idrogeno si combina con l’anidride carbonica per formare glucosio, una sostanza che è la base del nutrimento della piante 5 . Il glucosio entra a far parte della linfa elaborata ed è trasportato a tutte le cellule della pianta.
Il glucosio è formato da 6 atomi di carbonio, 12 atomi di idrogeno e 6 atomi di ossigeno; la sua formula è C6H12O6. Per formare una molecola di glucosio sono necessarie 6 molecole di acqua (H2O) e 6 di anidride carbonica (CO2).

La fotosintesi
6 Schema della reazione della respirazione.
3
Fotosintesi e respirazione, due processi tra loro dipendenti
Le piante, come tutti gli organismi viventi, respirano perché hanno bisogno di energia per il funzionamento delle proprie cellule.
La respirazione è il processo opposto a quello della fotosintesi: mentre la fotosintesi richiede energia per attivarsi, la respirazione è un processo che libera energia 6
La respirazione è l’insieme delle reazioni che portano il glucosio a combinarsi con l’ossigeno, formando acqua e anidride carbonica e liberando energia.
SKILL BOOK
LAB STEAM
LA STAMPA SOLARE
La respirazione avviene in tutte le cellule vive della pianta (in quelle delle foglie, del fusto e delle radici), perché tutte le cellule hanno bisogno di energia per compiere le loro funzioni, riprodursi e accrescersi. Nelle foglie gli scambi dei gas coinvolti nella respirazione avvengono attraverso gli stomi; nelle radici e nei fusti attraverso le lenticelle, piccole aperture presenti sull’epidermide di questi due organi. Durante le ore di luce, i processi di fotosintesi e di respirazione avvengono contemporaneamente nella cellula, anche se prevale la fotosintesi; durante la notte invece prevale la respirazione.
4 La traspirazione
Le piante assorbono dal terreno grandi quantità d’acqua ma solo l’1-2% viene utilizzata nella fotosintesi: il resto è in eccesso e viene eliminato nell’aria, sotto forma di vapore acqueo, attraverso gli stomi delle foglie, il fusto e le radici. Questo processo, detto traspirazione, può variare d’intensità a seconda delle condizioni ambientali. Gli stomi si aprono e si chiudono grazie alle cellule che li delimitano, le cellule di guardia. Quando la temperatura aumenta, le cellule di guardia si riempiono d’acqua e lo stoma si apre per aumentare la traspirazione. È quello che avviene nei climi caldo-umidi, dove le foreste traspirano giornalmente enormi quantità d’acqua sotto forma di vapore. Quando, invece, l’aria è secca, le cellule di guardia sono povere d’acqua, si afflosciano e chiudono gli stomi, impedendo la traspirazione e permettendo alla pianta di trattenere l’acqua all’interno della foglia 7
FISSA I CONTENUTI ESSENZIALI
Segna con una crocetta se è vero (V) o falso (F).
1. All’interno del picciolo si trovano solo vasi legnosi.
2. La cuticola rende la foglia impermeabile.
3. Gli stomi si trovano sull’epidermide superiore.
4. La fotosintesi produce glucosio e libera ossigeno.
5. Le cellule di guardia regolano l’apertura e la chiusura degli stomi.
VERSO LE COMPETENZE STEM
Esegui l’esperimento.
Materiali
• due piante da appartamento o da orto
• due sacchetti di plastica trasparente e due elastici
Esecuzione
1. Ricopri ogni pianta con un sacchetto di plastica trasparente.
2. Avvolgi bene tutte le foglie e usa l’elastico per chiudere il sacchetto nella parte inferiore.
3. Dopo qualche ora controlla che cosa è successo.
Osserva e rispondi.
4. Che cosa osservi sulla superficie interna dei sacchetti?
5. Quale processo è avvenuto nelle foglie delle piante?
7 La regolazione








6. Pensi che la temperatura dell’ambiente abbia qualche relazione con il fenomeno che osservi?
7. Noti qualche differenza nei processi avvenuti nelle due piante?
cellule di guardia
stoma chiuso stoma aperto
degli stomi.
SKILL BOOK
SCIENZE & MAT
Fiori, frutti e semi lezione 5
Guarda il video e scrivi le risposte sul quaderno.
CARTA PENNA COMPUTER

Tecniche di riproduzione
1 Polloni di tiglio.

2 Riproduzione vegetativa della fragola.
1. Che cos’è la riproduzione vegetativa?
2. Quali tecniche sono state sviluppate per far riprodurre alcune piante in modo efficiente?
3. Quale tecnica utilizzeresti per far riprodurre un geranio e avere di anno in anno un balcone sempre più fiorito?
Metti in pausa il video nei seguenti punti.

4. Indica per ciascuna pianta la tecnica usata per la riproduzione.


1 La riproduzione delle piante
Le piante possono riprodursi in due diversi modi: per riproduzione asessuata e per riproduzione sessuata.
• Nella riproduzione asessuata, detta anche riproduzione vegetativa, nuove piante si originano da alcune parti della “pianta madre”.
• Nella riproduzione sessuata avviene la fusione di due gameti, le cellule specializzate per la riproduzione; i gameti sono prodotti nel fiore.
Molte piante sono in grado di riprodursi in entrambi i modi: il tiglio, per esempio, è una pianta con fiori che produce semi dai quali si sviluppano nuove piante, ma i nuovi germogli che spuntano ai piedi dell’albero in primavera, i polloni, si generano direttamente dal fusto e dalle radici per riproduzione vegetativa 1
2 La riproduzione vegetativa
Nella riproduzione vegetativa, cellule non specializzate per la riproduzione si dividono ripetutamente, dando origine a una nuova pianta identica a quella di partenza.
I nuovi organismi possono originarsi da parti diverse della pianta. La fragola, per esempio, produce rami lunghi e sottili, gli stoloni, che nascono alla base del fusto; da ciascuno dei nodi dello stolone si sviluppano radici e gemme, che danno origine a nuove piantine che in seguito si staccano dalla pianta madre 2
stolone
ORA FERMA L’IMMAGINE!
Alcune specie di piante possiedono un rizoma, un fusto sotterraneo nel quale accumu lano sostanze di riserva per sopravvivere durante la stagione invernale; i rizomi più gonfi e carnosi prendono il nome di tuberi.
Dai rizomi e dai tuberi, come quelli della patata e del topinambur, si sviluppano nuove pianticelle che crescono utilizzando le sostanze immagazzinate, soprattut to amido. Lo stesso avviene per i bulbi, che sono grosse gemme sotterranee rico perte da foglie molto spesse, nelle quali la pianta accumula sostanze nutritive.
L’aglio e la cipolla sono esempi di bulbi commestibili.
3
Il fiore
Il fiore è la struttura della pianta specializzata per la riproduzione sessuata. Contiene gli stami, gli organi riproduttivi maschili che producono il polline, e i pistilli, gli organi riproduttivi femminili che producono gli ovuli. I fiori unisessuali, come quelli del salice, hanno solo stami (fiori maschili) oppure solo pistilli (fiori femminili); i fiori ermafroditi, come quelli del castagno, invece possiedono sia stami sia pistilli 3 . In natura esistono fiori di ogni forma, colore e dimensione; piccoli e poco appariscenti oppure grandi e profumati. Tuttavia, malgrado queste diversità, la struttura di base del fiore si ripete sempre uguale 4 .
4 Le parti del fiore.
La corolla, protetta dal calice, è formata da foglie colorate che costituiscono i petali

3 Fiori ermafroditi del castagno.
petali antera
Il pistillo è l’organo riproduttore femminile. È costituito dall’ovario che contiene gli ovuli, dallo stilo che sporge verso l’alto e dallo stimma che accoglie i granuli di polline. Ogni ovulo contiene un gamete femminile.

ovario con ovuli
Il peduncolo è il gambo verde che collega il fiore alla pianta. Il peduncolo si allarga alla sommità formando il ricettacolo, dove si inseriscono le varie parti del fiore.


LAB TINKERING
UN ORTO VERTICALE
SKILL BOOK
Gli stami formano l’organo riproduttore maschile. Sono lunghi filamenti al cui apice si trova un sacchettino, l’antera, che contiene i granuli di polline; all’interno del polline si trovano i gameti maschili
Il calice è composto dai sepali, foglioline verdi che racchiudono il fiore quando è in boccio e lo proteggono.

stame
sepali
filamento
stimma
peduncolo
stilo

b a

5 Impollinazione anemofila ed entomofila.
6 La fecondazione.
stimma
granulo di polline

ESTETICA DELLA NATURA
ALLA SCOPERTA
DEI FRATTALI!
L’impollinazione e la fecondazione
La prima tappa del processo di riproduzione sessuata è l’impollinazione
impollinazione è il trasporto del polline dall’antera allo stimma di un fiore della stessa specie.
Questo trasporto può avvenire a opera del vento (impollinazione anemofila), dell’acqua ), degli insetti (impollinazione entomofila) o di altri animali (im). Le piante a impollinazione anemofila possiedono fiori poco appariscenti e producono granuli di polline piccoli e numerosi 5 a Le piante a impollinazione entomofila possiedono fiori colorati e spesso profumati. Possiedono un liquido zuccherino, il nettare, per attirare gli insetti. L’animale si sporca il corpo di polline e in seguito lo trasporta su altri fiori della stessa specie, impollinandoli 5 b
Giunto allo stimma, il granulo di polline emette il tubetto pollinico, che penetra nello stilo fino a raggiungere un ovulo e a fondersi con esso: è avvenuta la fecondazione 6
La fecondazione è la fusione del gamete maschile con il gamete femminile.
Da questa fusione si forma una cellula, lo zigote, che inizia a dividersi per mitosi dando origine all’embrione. Poco dopo i sepali e i petali seccano e si staccano, mentre le pareti dell’ovario si ispessiscono e s’ingrossano trasformandosi in frutto. All’interno del frutto sono racchiusi e protetti i semi che contengono l’embrione.
Il seme è la struttura protettiva che contiene l’embrione della pianta.
In genere i semi sono piuttosto secchi perché durante la loro maturazione si disidratano, cioè perdono acqua. Sono avvolti esternamente da un involucro sottile, protettivo, chiamato tegumento; al loro interno si trova l’embrione, costituito dalle strutture in miniatura che formeranno l’individuo adulto: i cotiledoni, che contengono le sostanze nutritive che alimenteranno l’embrione, un fusticino e una radichetta 7 . Protetti all’interno dei semi, gli embrioni possono interrompere il loro sviluppo anche per lunghissimi periodi, in modo da affrontare e superare condizioni ambientali avverse. I semi possono contenere un solo cotiledone oppure due: questa caratteristica permette di distinguere le monofusticino
tubetto pollinico

zigote


7 Le parti del seme.


radichetta
cotiledone
SKILL BOOK
cotiledoni dalle dicotiledoni. Sono monocotiledoni le piante erbacee, i cereali e molte piante ornamentali, come i gigli e le orchidee; le dicotiledoni invece comprendono la maggior parte delle piante con i fiori.
5 La disseminazione e la germinazione
I frutti permettono la disseminazione, cioè la diffusione dei semi lontano dalla “pianta madre”.
La disseminazione può avvenire grazie al vento, all’acqua e agli animali: lo scopo è che le nuove piantine si possano sviluppare senza entrare in competizione con la pianta madre per la luce, l’acqua e i sali minerali.
Quando i semi trovano le condizioni adatte di temperatura e umidità, inizia la fase della germinazione
Il tegumento che riveste il seme si lacera e da esso fuoriesce una radichetta principale, che si allunga nel terreno alla ricerca di acqua e sali minerali.
Il fusticino spunta dal terreno e si sviluppano le prime foglie.
Con la germinazione dall’embrione si sviluppa una nuova pianta.
Sono arrivati gli alieni nel mio giardino?
Non sono alieni, ma organi di un vegetale! Si tratta dell’ovario di un fiore, il Nelumbo nucifera, più noto come fior di loto: è una pianta acquatica della famiglia delle Nelumbonaceae, originaria dell’Asia, dell’Australia e del Sud America e ormai diffusa anche in Europa. Il suo frutto inizialmente è bluastro, proprio come un piccolo alieno, poi cambia gradualmente di colore e diventa prima verde e poi rosa tenue a maturazione completa Quelli che sembrano degli occhietti in realtà sono frutti di forma ovoidale, le nucule, lunghe circa 2 cm, che contengono al loro interno i semi maturi, che sono pure commestibili. Le radici si estendono nel terreno del fondale, mentre i piccioli delle foglie possono raggiungere i 2 m di lunghezza, consentendo alla pianta di crescere in acque anche di quella profondità.
FISSA I CONTENUTI ESSENZIALI
Sottolinea il termine corretto tra i due proposti.


SCIENZA CHE
1. La riproduzione vegetativa è un tipo di riproduzione asessuata/sessuata
2. Il pistillo è l’organo riproduttivo maschile/femminile.
3. Il calice è composto dai sepali/petali
4. I semi sono avvolti da un involucro protettivo detto embrione/tegumento.
5. La disseminazione avviene tramite i frutti/le radici
VISUAL frutti falsi Frutti veri e

Si fa presto a dire frutti, ma di frutti ce ne sono di tanti tipi!I frutti veri sono quelli che si formano grazie allo sviluppo dell’ovario,mentre i frutti falsi derivano dall’ingrossamento anche del ricettacolo del fiore.
FRUTTI VERI secchi
I FRUTTI VERI SECCHI hanno una polpa piuttosto dura e oleosa e sono meno appetitosi per gli animali; per questo le piante che li producono hanno escogitato altri sistemi di disseminazione.
BACCELLO
ACHENIO
GHIANDA
CARIOSSIDE
SILIQUA
SAMARA
NOCE
fagioli, piselli
tarassaco, girasole
quercia
grano, mais, riso
carruba
olmo, acero



nocciolo, castagno




FRUTTI VERI carnosi
I FRUTTI VERI CARNOSI sono in genere dolci e succulenti, fatti apposta per essere un alimento prelibato per gli animali che, mangiandoli, digerendoli e disperdendo i semi con le feci, favoriscono la disseminazione.
BACCA
uva, pomodoro
DRUPA

albicocca, ciliegia, pesca



PEPONIDE
melone, anguria

FRUTTI FALSI
Sembra strano, ma mele, pere e fichi, che normalmente compaiono sulle nostre tavole, non sono veri frutti! Ad esempio nella mela e nella pera il vero frutto è il torsolo; nel fico i veri frutti sono i semini; nella fragola i veri frutti sono i semini gialli sulla superficie.
POMO
pera, mela
SICONIO AGGREGATI DI FRUTTI
sicomoro, fico



mora e lampone sono aggregati di drupe, la fragola è un aggregato di acheni



CON LA SINTESI
lezione 1 IL REGNO DEI FUNGHI
I funghi sono organismi eterotrofi, unicellulari e pluricellulari e si classificano in base alle modalità con cui si nutrono.
I funghi saprofiti ricavano sostanze nutritive dalla decomposizione di resti vegetali; i funghi parassiti, si nutrono del materiale contenuto in altre cellule; i funghi simbionti vivono in associazione con altri organismi.
I funghi a cappello sono formati da cellule non differenziate tenute insieme da sottili filamenti, le ife, che penetrano nel terreno formando il micelio, l’organo che assorbe le sostanze nutritive.
La parte che spunta dal terreno è il corpo fruttifero formato da un gambo e da un cappello, l’organo riproduttore dove maturano le spore.
Le muffe sono funghi pluricellulari parassiti dalle dimensioni microscopiche. I lieviti sono funghi unicellulari che vivono grazie alla fermentazione; sono usati nella lievitazione del pane e nella produzione di vino e birra.
lezione 2 IL REGNO DELLE PIANTE
Le piante sono organismi pluricellulari autotrofi. Le prime piante che si sono adattate a vivere sulla terraferma sono state le briofite. Sono briofite i muschi e le epatiche, che hanno il corpo a tallo, cioè privo di tessuti specializzati, e vivono in ambienti umidi. Le piante vascolari, o tracheofite, possiedono un corpo a cormo, con tessuti e organi specializzati: le radici per l’assorbimento, il fusto per il sostegno e per il trasporto dei liquidi e le foglie per la fotosintesi. Le tracheofite comprendono le pteridofite e le spermatofite, che sono divise in gimnosperme e angiosperme. Le gimnosperme proteggono i semi all’interno delle pigne. Le angiosperme, le piante con fiori, proteggono i semi all’interno del frutto.
lezione 3 LA RADICE E IL FUSTO


La radice è l’organo che ancora la pianta al terreno e assorbe acqua e sali minerali indispensabili per la fotosintesi. Nella radice si distinguono l’apice radicale, dove le cellule si riproducono continuamente, la zona di accrescimento, che fa allungare le radici, e la zona di assorbimento ricca di peli radicali. La radice è formata dal tessuto di rivestimento, l’epidermide, dalla corteccia e dal cilindro centrale, dove si trovano

i vasi conduttori che trasportano la linfa grezza, dalle radici alle foglie, e la linfa elaborata, dalle foglie alle radici. Il fusto sorregge i rami e le foglie e contiene i vasi di trasporto. I fusti possono essere pieni, come quelli degli alberi, cavi, come quelli del bambù, erbacei, come gli steli dell’erba, legnosi, come quelli degli arbusti. In alcuni casi il fusto si modifica e funziona da organo di riserva, diventando bulbo o tubero.
lezione 4 LA FOGLIA

La foglia è costituita dal picciolo, che la sorregge e la inserisce nel ramo, e dalla lamina fogliare, che è attraversata dalle nervature, le ramificazioni dei vasi conduttori che provengono dal fusto. Nelle foglie avvengono i processi di fotosintesi, traspirazione e respirazione. La fotosintesi è l’insieme delle reazioni che trasformano l’anidride carbonica e l’acqua in molecole di glucosio e ossigeno. Questo processo avviene nei cloroplasti che contengono la clorofilla, il pigmento verde che cattura l’energia del Sole e attiva la reazione. Il glucosio prodotto entra a far parte della linfa elaborata e l’ossigeno esce dalla foglia attraverso gli stomi. La respirazione, che avviene in tutte le cellule della pianta, trasforma il glucosio e l’ossigeno in acqua e anidride carbonica e libera energia. La traspirazione è il processo con cui le piante eliminano l’acqua non utilizzata per la fotosintesi sotto forma di vapore acqueo.
lezione 5 FIORI, FRUTTI E SEMI
Le piante possono riprodursi per riproduzione vegetativa, o asessuata, quando le nuove piantine si originano dai fusti o dalle radici della pianta madre, o per riproduzione sessuata, quando le nuove piantine si originano dalla fusione di due gameti. Il fiore è la struttura specializzata per la riproduzione sessuata: contiene gli organi riproduttori maschili, gli stami, che producono il polline, e gli organi riproduttori femminili, i pistilli, che producono gli ovuli. Quando il polline raggiunge gli ovuli avviene la fecondazione e il fiore si trasforma in un frutto che contiene i semi. Il seme è la struttura protettiva che contiene l’embrione della nuova pianta. Quando le condizioni ambientali sono adatte inizia la germinazione del seme.


CON LA MAPPA
Adesso che hai ripassato i contenuti essenziali con la sintesi, prova a completare la mappa con le parole chiave suggerite e a trovare le definizioni corrispondenti.
epatiche - fiore - foglie - gameti - radice - tallo - vegetativa
possono avere il corpo a si possono riprodurre per
4. tessuti specializzati quando non possiedono quando possiedono organi specializzati come




a. Svolge la funzione di sostegno della pianta.
b. È composto da petali, sepali, peduncolo, stami e pistilli.
10. riproduzione
11. riproduzione sessuata
che prevede la fusione di
12. maschili e femminili
contenuti in strutture all’interno del




c. Dà origine a nuove piantine a partire da cellule specializzate per la riproduzione.
d. Sono piante dotate di tessuti vascolari.
3. cormo
5. muschi
8. fusto
2.
1. LE PIANTE
FISSA I CONTENUTI ESSENZIALI
lezione
1 IL REGNO DEI FUNGHI
1 Segna con una crocetta se vero (V) o falso (F).
a. Il regno dei funghi comprende organismi unicellulari e pluricellulari.
b. I licheni sono un’associazione tra un fungo e un alga.
c. Le ife sono formate da cellule disposte una dopo l’altra in sottili filamenti.
d. Le muffe sono funghi unicellulari parassiti.
e. Al gruppo dei basidiomiceti appartengono i funghi commestibili.
2 Scegli la soluzione corretta.
a. I funghi parassiti:
1 sono unicellulari.
2 vivono in stretta relazione simbiotica con gli alberi.
3 si nutrono esclusivamente del materiale contenuto in cellule di altri organismi vivi.
4 sono una simbiosi tra un fungo e un’alga.
b. I funghi a cappello si riproducono tramite:
1 le spore.
2 i fiori.
3 il micelio.
4 le ife.
3 Osserva il disegno e inserisci accanto a ogni termine il numero corrispondente.



Ife Spore

4 Completa le frasi con i termini corretti.
a. Le ife delle muffe terminano con una struttura detta , nella quale si sviluppano le spore.
b. Nel gruppo dei basidiomiceti le spore sono prodotte all’interno dei
lezione 2 IL REGNO DELLE PIANTE
5 Abbina i termini con la definizione corretta.
1. Corpo a tallo
2. Corpo a cormo
3. Briofite
4. Pteridofite
a Piante di piccole dimensioni che vivono in ambienti molto umidi.
b Piante vascolari molto semplici.
c Corpo delle piante privo di tessuti specializzati.
d Corpo delle piante dotato di organi specializzati.
1. 2. 3. 4.
6 Sottolinea il termine corretto tra i due proposti.
a. Il corpo a tallo è tipico delle briofite/angiosperme.

b. I licopodi appartengono al phylum delle pteridofite/spermatofite.
c. Le gimnosperme si riproducono tramite spore/fiori.
7 Completa le frasi con i termini corretti.

Micelio


a. Le furono le prime piante di una certa dimensione che riuscirono a conquistare le emerse grazie ai di cui sono dotate.
b. Tutte le sono piante con fiori; comprendono non solo i vegetali con i fiori appariscenti, ma anche la maggior parte dei grandi , tutte le piante da frutto, le verdure, le piante


Gambo
Cappello
Corpo fruttifero
lezione 3 LA RADICE E IL FUSTO
8 Segna con una crocetta se vero (V) o falso (F).
a. La pianta assorbe acqua dal terreno grazie alle radici.
b. Le piante rampicanti hanno sistemi radicali a fittone.
c. L’apice radicale è rivestito da una struttura detta cuffia.
d. I vasi cribrosi trasportano la linfa grezza.
e. I fusti delle piante possono essere cavi.
9 Scegli la soluzione corretta.
a. Quale delle seguenti funzioni non è svolta dalle radici?
1 Fissano la pianta al suolo, impedendo che il vento, la pioggia o il suo stesso peso la abbattano.
2 Assorbono dal terreno l’acqua e i sali minerali che costituiscono la linfa grezza.
3 Possono accumulare sostanze di riserva come l’amido.
4 Trasportano la linfa elaborata.
b. L’insieme di tutte la radici di una pianta forma:
1 il pollone.
2 il sistema radicale.
3 l’apice radicale.
4 la zona di assorbimento.
lezione
4 LA FOGLIA
10 Osserva il disegno e inserisci il numero corrispondente alle molecole coinvolte nella reazione.
11 Segna con una crocetta se vero (V) o falso (F).
a. Nelle foglie avviene solo la reazione di fotosintesi.
b. La lamina fogliare presenta la pagina superiore e la pagina inferiore.
c. Gli stomi sono posizionati nella pagina superiore.
d. Le cellule di guardia aprono e chiudono gli stomi.
e. Il tessuto lacunoso è ricco di cloroplasti.
f. Le nervature della foglia sono le ramificazioni dei vasi cribrosi e legnosi.
lezione 5 FIORI, FRUTTI E SEMI
12 Abbina i termini con la definizione corretta.
1. Riproduzione vegetativa
2. Polline
3. Frutto
4. Seme
5. Cotiledoni
a È prodotto dagli organi riproduttori maschili.
b Contengono le sostanze nutritive che alimentano l’embrione.
c Tipo di riproduzione asessuata.
d Organo derivato dalle pareti dell’ovario.
e Struttura protettiva che contiene l’embrione della pianta.
1. 2. 3. 4. 5.
13 Scegli la soluzione corretta.
a. L’impollinazione per mezzo del vento è detta impollinazione: 1 entomofila. 2 idrofila. 3 anemofila. 4 zoofila.
1. Anidride carbonica 2. Glucosio
3. Acqua 4. Ossigeno
b. La diffusione dei semi lontano dalla pianta si chiama: 1 disseminazione. 2 fecondazione. 3 impollinazione. 4 germinazione.
INTERPRETARE E COMMENTARE UN MODELLO
1 Attribuisci il titolo alle immagini che mostrano diversi tipi di funghi.



Rispondi alle domande.
a. Come ricavano le sostanze nutritive i funghi del gruppo a?
RIFLETTERE E SPIEGARE
2 Osserva l’immagine e rispondi alle domande.
a. Il corpo della pianta di carota è a tallo o a cormo?

b. A quale gruppo di piante appartiene la carota?
c. La carota è un ortaggio: quale parte delle piante è commestibile?
d. Descrivi le caratteristiche della parte della pianta rappresentata nella fotografia.
3 Elenca quali vantaggi hanno avuto le piante nella conquista della terraferma:
a.
b.
c.
4 Osserva l’immagine e rispondi alle domande.
a. Che cosa passa nei vasi cribrosi? Da dove proviene?

b. Come ricavano le sostanze nutritive i funghi del gruppo b? Perché sono considerati benefici per gli alberi?
b. Che cosa passa nei vasi legnosi? Da dove proviene?
c. Quali sono le differenze tra corteccia e epidermide?
c. Spiega che cosa sono le ife.

zigomorfa simmetria)
5 I disegni mostrano i gradi di simmetria che possono presentare i fiori in base alla loro corolla. Ricerca in rete la foto dei fiori indicati in tabella. Completa la tabella inserendo il tipo di corolla di ciascun fiore.




corolla attinomorfa (2 o più piani di simmetria)
olla attinomorfa (2 o più piani di simmetria)
corolla asimmetrica (nessun piano di simmetria)

zigomorfa piano di simmetria)
corolla attinomorfa (2 o più piani di simmetria)


INTERPRETARE E TRARRE INFORMAZIONI DA UN TESTO
6 Leggi il brano.
FRUTTI VERI E FRUTTI FALSI



Si fa presto a dire frutti, ma di frutti ce ne sono di tanti tipi! I frutti veri sono quelli che si formano grazie allo sviluppo dell’ovario, mentre i frutti falsi derivano dall’ingrossamento anche di altri organi del fiore.
corolla zigomorfa (un solo piano di simmetria)
corolla asimmetrica (nessun piano di simmetria)
I frutti vengono classificati in: frutti veri carnosi, frutti veri secchi, frutti falsi.

I frutti veri carnosi sono in genere dolci e succulenti, fatti apposta per essere un alimento prelibato per gli animali che, mangiandoli, digerendoli e disperdendo i semi con le feci, favoriscono la disseminazione. Sono frutti di questo tipo l’uva, la pesca e il melone.
olla zigomorfa (un solo piano di simmetria)


I frutti veri secchi hanno una polpa piuttosto dura e oleosa e sono meno appetitosi per gli animali; per questo le piante che li producono hanno escogitato altri sistemi di disseminazione, per esempio il vento. Sono frutti di questo tipo il grano, il fagiolo e il nocciolo.
corolla asimmetrica (nessun piano di simmetria)
corolla zigomorfa (un solo piano di simmetria)
corolla zigomorfa (un solo piano di simmetria)

fiore piani di simmetria tipo di corolla
Lilium candidum 3 + 3 piani
Helleborus niger 5 piani
Dictamnus albus 0 piani
Eruca vesicaria 2 + 2 piani
Anemone nemorosa 6 piani
Viola calcarata 1 piano
Delphinium pictum 0 piani
Ophrys 1 piano
corolla asimmetrica (nessun piano di simmetria)
corolla asimmetrica (nessun piano di simmetria)
Sembra strano, ma mele, pere e fichi, che normalmente compaiono sulle nostre tavole, non sono veri frutti! Ad esempio nella mela e nella pera il vero frutto è il torsolo; nel fico i veri frutti sono i semini; nella fragola i veri frutti sono i semini gialli sulla superficie.
(Tratto e adattato da wwf.it) Rispondi alle domande e svolgi le attività proposte, da solo o in gruppo con i tuoi compagni.
corolla asimmetrica (nessun piano di simmetria)
a. Come si formano i frutti veri secchi? Che cosa li distingue da quelli veri carnosi?
b. A quale categoria di frutti appartengono quelli che consumiamo più frequentemente?
c. Quali parti della fragola e del fico sono i veri frutti?
Con l’aiuto dell’insegnante inserisci questo prompt in un chatbot di intelligenza artificiale: “Descrivimi in ordine casuale alcuni frutti con le loro caratteristiche, in modo che io possa provare a inserirli nelle categorie frutti veri e frutti falsi usate per la loro classificazione”. Chiedi al chatbot di controllare le tue risposte per confrontarle con quelle dei tuoi compagni.

THE QUALITIES OF
MUSHROOMS
Engineers, medical researchers, and designers are utilizing the natural abilities of various fungi for antibiotics, building materials, water filtration, toxic waste cleanup, textiles, and other purposes. Researchers keep discovering surprising ways fungi boost human health. A recent study showing that two common antioxidants in some mushrooms have the potential to help ward off diseases that come with aging, such as heart disease and Alzheimer’s. Some species are famous for their hallucinogenic properties. Others not only are appreciated by chefs but also show therapeutic value. Perhaps in the future, superfoods won’t be just plants but also fungi.
lossario
BOST HUMAN HEALT
migliorare la salute umana
ANTIOXIDANTS antiossidanti WARD OFF allontanare
COMPREHENSION EXERCISES
Answer the following questions.
a. Why are fungi so important?
b. For which diseases can fungi be used?
c. Complete the picture with the following words. cap ● fruiting body ● hyphae ● mycelium ● stem




VIVENTI
gli invertebrati Il regno degli animali: unità
lezione 1
SOSTEGNO, MOVIMENTO, RISPOSTA AGLI STIMOLI
lezione 2
NUTRIZIONE, RESPIRAZIONE, CIRCOLAZIONE E RIPRODUZIONE
lezione 3
Poriferi e cnidari
lezione 4
Vermi e molluschi
lezione 5
Artropodi ed echinodermi




BUONE NOTIZIE PER IL FUTURO
Agricoltura non convenzionale
La “transizione ecologica” interessa anche l’agricoltura. Il modello convenzionale di agricoltura prevede l’uso di macchine agricole e l’impiego di fertilizzanti, diserbanti e antiparassitari prodotti nei laboratori chimici con lo scopo di coltivare velocemente grandi quantità di piante destinate all’alimentazione umana o animale. Questo tipo di agricoltura altera in maniera grave gli ecosistemi naturali, rendendo i suoli sempre meno fertili e produttivi. In alternativa a questo modo di coltivare, oggi si stanno affermando pratiche agricoltura biologica e l’agricoltura integrata, che pongono al centro la salute dell’ambiente. Queste pratiche agricole prevedono l’utilizzo di insetti utili, come coccinelle, vespe e formiche, per contrastare i parassiti in modo naturale, riducendo l’uso di pesticidi e salvaguardando gli insetti impollinatori. Inoltre, alcune tecniche innovative prevedono di lasciare nei campi le piante infestanti, piante ritenute fino a poco tempo fa inutili e persino dannose per le piante coltivate, e che, invece, si è scoperto contribuire alla conservazione della biodiversità e al miglioramento della fertilità del terreno.
SOSTEGNO, MOVIMENTO, RISPOSTA AGLI STIMOLI lezione 1
CARTA PENNA COMPUTER

L’evoluzione degli animali
Guarda il video e scrivi le risposte sul quaderno.
1. Quali sono le caratteristiche tipiche degli animali?
2. Quali sono i due grandi gruppi in cui sono suddivisi gli animali?
3. In quale ambiente sono comparsi i primi animali?
4. Per quale motivo si sono sviluppati gli organi di senso, il sistema nervoso e gli organi di movimento?
1
ORA FERMA L’IMMAGINE!
Metti in pausa il video nel seguente punto.
5. Scrivi un breve testo che descriva la figura e spieghi il significato dei termini riportati nel disegno.

Che cos’è un animale
Il regno degli animali comprende organismi formati da numerose cellule eucariote. A differenza degli organismi coloniali, le cellule degli animali sono specializzate a compiere diverse funzioni e sono organizzate in tessuti e organi. Grazie a questa specializzazione, nel corso dell’evoluzione il corpo degli animali si è adattato alle più diverse condizioni ambientali, prima nell’acqua e in seguito sulle terre emerse.

Gli animali sono organismi pluricellulari eucarioti; sono tutti eterotrofi e per questa ragione dipendono dagli organismi autotrofi.
Gli animali sono suddivisi in due grandi gruppi: gli invertebrati, ovvero tutti gli animali senza colonna vertebrale, e i vertebrati, che hanno una colonna vertebrale.
2 La simmetria
Un’importante conseguenza degli adattamenti degli animali ai diversi ambienti è stata, insieme all’aumento della complessità della struttura corporea, la comparsa di una simmetria: le diverse parti del corpo sono disposte in modo simmetrico rispetto a un asse.
Negli animali più semplici, come le spugne, le parti del corpo sono disposte in maniera casuale; di conseguenza questi ani-
mali non hanno alcuna simmetria. Tutti gli altri animali marini che vivono ancorati a una superficie o che si muovono poco presentano invece una simmetria raggiata, che permette loro di controllare l’ambiente a 360° e di difendersi o attaccare in ogni direzione.
Negli animali a simmetria raggiata esistono numerosi piani passanti per il centro del corpo, che lo dividono in due metà simmetriche, e non è possibile distinguere un’estremità anteriore e un’estremità posteriore 1
Per gli animali che devono muoversi in una direzione precisa per procurarsi il cibo, è necessario che il corpo presenti un’estremità anteriore, il capo, e un’estremità posteriore, la coda. Il capo è la prima parte del corpo che viene a contatto con l’ambiente quando l’animale si muove, e quindi è qui che si localizza la maggior parte degli organi di senso e il cervello, l’organo che coordina il sistema nervoso. Un’organizzazione di questo tipo si chiama simmetria bilaterale. Negli animali a simmetria bilaterale esiste un solo piano, passante per il capo e per la coda, che divide il corpo in due metà simmetriche 2
3 Il celoma
In generale, il corpo degli animali può essere descritto come un tubo, il canale digerente, collocato all’interno di un altro tubo, la parete esterna Nei vermi, tra il tubo interno e il tubo esterno non c’è nessuna cavità: tutti gli organi formano una massa compatta. Negli animali più complessi, per esempio nei lombrichi, è presente invece una cavità tra la parete esterna del corpo e il tubo interno, chiamata celoma: nel celoma gli organi interni, sostenuti e mantenuti nella loro posizione da particolari tessuti, possono funzionare indipendentemente gli uni dagli altri e in maniera più efficace 3
4 Movimento e strutture di sostegno
La forma, la struttura e le funzioni del corpo degli animali sono direttamente legate al loro modo di muoversi e alimentarsi.
La locomozione è la capacità degli animali di muoversi
Il movimento è reso possibile dai muscoli, che formano il sistema muscolare, e dallo scheletro, un sostegno che può essere esterno o interno all’organismo. Tutti gli animali hanno la necessità di possedere un sostegno del corpo, in particolare se vivono sulla terraferma, dove la spinta esercitata dall’aria per sostenere il corpo è molto minore rispetto a quella dell’acqua.
1 L’anemone di mare, che vive ancorato al fondo marino, presenta simmetria raggiata.

2 L’aragosta, che si muove sul fondo marino, presenta simmetria bilaterale.

3 Sezione di un lombrico in cui si vedono il celoma e alcuni organi interni. celoma per cercare cibo, sfuggire ai predatori, esplorare l’ambiente.
Gli invertebrati sono privi di scheletro interno; tuttavia, nei lombrichi è presente l’idroscheletro, un sistema idraulico interno composto da anelli pieni di liquido del celoma che sostiene l’animale.

4 La conchiglia delle cozze è formata da due pezzi chiamati valve.
L’idroscheletro permette anche il movimento grazie all’azione della muscolatura sul liquido: in questo modo l’animale regola il diametro e la lunghezza del corpo riuscendo ad avanzare tra le asperità del suolo o a strisciare sui fondali marini.
Un sostegno rigido, però, è molto più efficiente per muoversi, specialmente su superfici accidentate: può essere esterno, come la conchiglia dei molluschi 4 , o come l’esoscheletro che protegge gli insetti e i crostacei. La conchiglia è un’ottima protezione meccanica per l’organismo e lo preserva dalla disidratazione; tuttavia è piuttosto pesante e non offre vantaggi per il movimento. L’esoscheletro, al contrario, è leggero e robusto, ma non può accrescersi mentre l’animale aumenta di dimensioni e, pertanto, deve essere sostituito attraverso la muta

Ricci di mare e stelle marine possiedono un dermascheletro superficiale calcareo 5 , costituito da carbonato di calcio, che si trova sotto l’epidermide e che quindi non può essere considerato un esoscheletro. Nei ricci di mare il dermascheletro forma una vera e propria corazza. I vertebrati possiedono un endoscheletro capace di crescere insieme all’animale, senza costituire un limite per le dimensioni del suo corpo; per questa ragione gli animali più grandi che vivono sulla Terra sono vertebrati.
6 Il cavallo è sostenuto da uno scheletro

L’endoscheletro, oltre a sostenere il corpo, protegge gli organi interni più delicati: per esem pio, le ossa della scatola cranica racchiudono il cer vello, le costole proteggono il cuore e i polmoni 6 .

5 Stella marina.
5 Sensibilità e coordinamento
Gli animali percepiscono segnali dall’ambiente in cui vivono e avvertono anche stimoli provenienti dal loro corpo. Questi stimoli sono raccolti da particolari cellule, i recettori, che in molti animali sono riunite in appositi organi di senso. Altre cellule specializzate, i neuroni, elaborano gli stimoli e inviano una risposta adeguata agli organi interessati.
La sensibilità è la capacità degli animali di avvertire gli stimoli esterni e interni. Il coordinamento delle reazioni appropriate è affidato a una rete di neuroni o a un vero e proprio sistema nervoso.
Per esempio, le meduse hanno una rete di neuroni diffusa in tutto il corpo che funziona in modo semplice: uno stimolo esercitato in un punto qualsiasi dell’animale si diffonde in tutte le direzioni. Negli altri animali i neuroni si riuniscono in piccoli gruppi, i gangli, facilitando il passaggio delle informazioni da una cellula nervosa all’altra. Nei vertebrati il sistema nervoso è costituito dall’encefalo, formato dal cervello e dal cervelletto, e dal midollo spinale 7 .
rete nervosa
IDRA (cnidari)
cordoni nervosi encefalo macchia oculare
PLANARIA (platelminti)
catena gangliare ventrale gangli encefalo
INSETTO (artropodi)
CALAMARO (molluschi) gangli encefalo
FISSA I CONTENUTI ESSENZIALI
Segna con una crocetta se è vero (V) o falso (F).
1. Esistono animali unicellulari.
2. Gli animali si muovono grazie ai muscoli e allo scheletro.
3. Tutti gli animali acquatici hanno simmetria bilaterale.
4. Il celoma è una cavità tra il tubo digerente e la parete esterna.
5. La conchiglia dei molluschi è un tipo di dermascheletro.
VERSO LE COMPETENZE
Commenta la frase.
7 Sistemi nervosi di alcuni animali a confronto.
catena gangliare ventrale gangli
SANGUISUGA (anellidi) encefalo
encefalo
midollo spinale gangli nervosi
SALAMANDRA (vertebrati)
catena gangliare ventrale gangli encefalo
Gli animali acquatici fissi sul fondale o dotati di pochi movimenti propri sono avvantaggiati dalla simmetria raggiata.
Ti trovi d’accordo? Motiva la tua risposta.
lezione 2
NUTRIZIONE, RESPIRAZIONE, CIRCOLAZIONE E RIPRODUZIONE
CARTA PENNA COMPUTER

Gli adattamenti all’ambiente subaereo
Guarda il video e scrivi le risposte sul quaderno.
1. Quali sono stati i primi organismi a vivere in ambiente subaereo?
2. Quali sono i principali adattamenti che hanno attuato gli animali per poter vivere fuori dall’acqua?
3. Quali adattamenti specifici dei vertebrati hanno permesso loro di raggiungere ragguardevoli dimensioni?
1
Metti in pausa il video nei seguenti punti.


4. Dai un titolo alle immagini e scrivi sul quaderno una didascalia per ciascuna foto (max due righe).
Nutrizione e digestione
Con la nutrizione gli animali assumono il cibo. In base al loro tipo di nutrizione, gli animali possono essere:
• erbivori, se si nutrono esclusivamente di vegetali;
• carnivori, se si nutrono di altri animali;
• onnivori, se si nutrono sia di vegetali sia di animali;
• filtratori, se assorbono l’acqua e se trattengono le sostanze organiche presenti in essa 1

1 La balena è un animale filtratore.
Negli invertebrati acquatici molto primitivi, come le spugne, ogni singola cellula ingerisce frammenti di cibo e li digerisce autonomamente. Nelle meduse è presente la bocca, una cavità da cui entra il cibo che viene digerito dai succhi prodotti dalle cellule che rivestono internamente l’animale. I vermi e gli altri invertebrati possiedono un apparato digerente più o meno complesso, costituito essenzialmente da un lungo tubo digerente dotato di due aperture: la bocca e l’ano. Nei vertebrati sono presenti anche vari organi specializzati.
La digestione è l’insieme dei processi che riducono il cibo in sostanze semplici che possono essere assorbite dalle cellule del corpo.
Possedere un tubo digerente con due aperture è vantaggioso: consente all’animale di dedicare più tempo alla nutrizione, perché può contemporaneamente introdurre cibo
ORA FERMA L’IMMAGINE!
ed eliminare le sostanze di rifiuto. Nel corso dell’evoluzione il tubo digerente si è sempre più specializzato: si sono sviluppati organi per la cattura e la triturazione del cibo, ghiandole per aiutare la digestione e l’assorbimento dei nutrienti.
In funzione del tipo di alimentazione si sono modificate la lunghezza e la struttura del tubo digerente. Per esempio, gli erbivori ruminanti come le mucche o le pecore, masticano più volte il cibo per ricavare il maggior numero possibile di sostanze nutritive; per questa ragione hanno un intestino molto lungo e con diverse espansioni dove conservare temporaneamente il cibo prima di una nuova masticazione 2
2 Respirazione
Gli animali hanno una vita molto attiva che richiede grandi quantità di energia, che essi ricavano dalle sostanze semplici prodotte dalla digestione. Perché questo processo possa avvenire è necessario
Con la respirazione esterna volti nella respirazione cellulare: assumono ossigeno dall’aria o dall’acqua ed eliminano anidride carbonica e acqua sotto forma di vapore.
Con la respirazione cellulare precisamente nei mitocondri, gli zuccheri si combinano con l’ossigeno liberando ener gia, anidride carbonica e acqua.
La respirazione è il processo che, grazie all’ossigeno, permette all’organismo di ricavare energia dal cibo digerito.
Negli animali più semplici, come spugne, meduse e vermi piatti, l’ossigeno e l’anidride carbonica diffondono da una cellula all’altra per tutto il corpo.
Anche in alcuni gruppi di animali complessi lo scambio di gas con l’ambiente esterno avviene direttamente attra verso la superficie del corpo, come nel caso degli anfibi
Negli animali più grandi e complessi, invece, esistono delle struttu re specifiche per la respirazione: le
2 Le pecore hanno una digestione molto lunga.

3 La rana riesce ad assorbire ossigeno anche attraverso la pelle, molto sottile e priva di rivestimento.

Negli insetti terrestri la respirazione avviene attraverso le trachee, sottili tubi che si aprono all’esterno attraverso piccoli fori (gli stigmi). Le trachee arrivano in pros simità di tutte le cellule, rifornendole di ossigeno.
Le branchie, presenti negli animali acquatici, sono costituite da una serie di filamenti attra versati da numerosi vasi sanguigni che traspor tano ossigeno e anidride carbonica. Quando l’acqua bagna le branchie, l’ossigeno in essa di sciolto passa nel sangue che circola nei fila menti branchiali, mentre l’anidride carbonica passa dal sangue all’acqua, dove si scioglie
Tutti gli animali terrestri respirano con i polmo ni, organi interni dotati di un’ampia superficie respiratoria, bagnata da capillari sanguigni, in cui possono avvenire rapidamente gli scambi gassosi tra l’ambiente e le cellule.












Il flusso dell’acqua nelle branchie.
ACQUA IN ENTRATA
ACQUA IN USCITA
branchia
3
Circolazione ed escrezione
L’ossigeno e i prodotti della digestione devono essere assorbiti e portati a tutte le cellule; a loro volta le cellule devono poter eliminare le sostanze di scarto, in particolare l’anidride carbonica prodotta dalla respirazione cellulare.
La circolazione è il processo che trasporta l’ossigeno e le sostanze nutritive a tutte le cellule del corpo e allontana le sostanze di scarto che esse producono.
Se l’animale è costituito da poche cellule, o è molto piccolo, il trasporto di sostanze in tutto il corpo avviene per diffusione da una cellula all’altra. Quando il numero di cellule apparato circolatorio: le sostanze sono disciolte in un liquido (il sangue o l’emolinfa) che scorre in una serie di tubi, i
5 Gli apparati circolatori degli animali.
Tra gli invertebrati, gli insetti possiedono un vero e proprio apparato circolatorio aperto, costituito da un tubo e da vasi; il liquido che scorre nei vasi prende il nome di spinge l’emolinfa nei vasi che si aprono nelle cavità del corpo e negli spazi tra gli organi. Da qui l’emolinfa ritorna al cuore.




I vertebrati possiedono un apparato circolatorio chiuso formato da un cuore e da due tipi di vasi (le vene e le arterie) che formano un circuito chiuso al cui interno scorre il sangue. Il cuore spinge il sangue nelle arterie che si diramano in tutto il corpo fino alle cellule. Da qui il sangue si raccoglie nelle vene e ritorna al cuore.













arterie vene cuore


L’escrezione è il processo che convoglia i prodotti di rifiuto all’esterno del corpo.
Negli animali più semplici, i prodotti di rifiuto sono eliminati attraverso la superficie corporea. Negli animali più complessi, sono presenti organi specializzati che costituiscono l’apparato escretore. Il funzionamento dei diversi apparati escretori è quello di riuscire a espellere le sostanze di rifiuto trattenendo nell’organismo l’acqua e i sali minerali che servono.
4 Riproduzione
Gli animali, quando raggiungono la maturità, sono in grado di riprodursi.
Con la riproduzione gli animali generano individui simili a se stessi.
La riproduzione può essere asessuata, quando da un solo organismo hanno origine organismi identici al genitore, oppure sessuata, quando un organismo ha origine dall’unione di due cellule riproduttive, i gameti, generate da un individuo maschio e da un individuo femmina.
La riproduzione per gemmazione e quella per rigenerazione sono due tipi di riproduzione asessuata presenti tra gli invertebrati. Gli animali più complessi, che si riproducono sessualmente, possiedono organi specializzati per la riproduzione, le gonadi: la femmina possiede le ovaie, che producono cellule uovo, i maschi hanno i testicoli, che producono spermatozoi. Perché avvenga la fecondazione occorre che i gameti (cioè le cellule uovo e gli spermatozoi) si incontrino e si uniscano.
• Nella fecondazione esterna, l’unione tra i gameti avviene nell’ambiente esterno, in particolare nell’acqua 6 a
• Nella fecondazione interna, l’unione avviene all’interno del corpo della femmina 6 b


FISSA I CONTENUTI ESSENZIALI
Abbina i termini alla definizione corretta.
1 Trachee
2 Gemmazione
3 Apparato escretore
4 Tubo digerente
1: 2: 3: 4:
a Riproduzione asessuata tipica degli invertebrati.
b Organi respiratori degli insetti.
6 I pesci si riproducono con la fecondazione esterna, le libellule con la fecondazione interna.
c Sistema di organi che provvede all’eliminazione delle sostanze di rifiuto. d È dotato di bocca e ano.
VERSO LE COMPETENZE
Metti a confronto gli apparati circolatori degli animali. Prepara una tabella che riassuma le principali somiglianze e differenze.
Poriferi e CNIDARI lezione 3
Guarda il video e scrivi le risposte sul quaderno.
CARTA PENNA COMPUTER

Le caratteristiche degli invertebrati
1. Perché alcuni invertebrati acquatici riescono a raggiungere dimensioni notevoli mentre gli attuali invertebrati terrestri no?
2. Come riescono a proteggersi dall’ambiente esterno?
3. Quali strategie adottano per avere un’elevata capacità riproduttiva?
4. In che cosa consiste il processo di metamorfosi?
ORA FERMA L’IMMAGINE!
Metti in pausa il video nei seguenti punti.

5. Attribuisci a ciascuna foto la caratteristica dei vertebrati che rappresenta e spiega perché costituisce un vantaggio per questi animali (max due righe).


1
Gli invertebrati
Oltre il 90% degli animali appartiene al gruppo degli invertebrati
Gli invertebrati sono animali che non hanno la colonna vertebrale.
Sono invertebrati i poriferi, i celenterati, i platelminti, i nematodi, gli anellidi, i molluschi, gli artropodi e gli echinodermi.
2
Poriferi
Poriferi è il nome del phylum a cui appartengono le spugne. Sono animali acquatici molto primitivi, con il corpo a forma di sacco perforato da moltissimi pori (da cui il nome del gruppo). Nella parte superiore hanno un’apertura di dimensioni maggiori, l’osculo 1 L’acqua entra nella spugna dai pori e fuoriesce dall’osculo.
Le spugne sono organismi pluricellulari, ma presentano ancora caratteristiche tipiche degli organismi coloniali: infatti le loro cellule riescono a vivere anche quando sono staccate dal resto del corpo.
I poriferi sono per la maggior parte marini e si trovano a tutte le profondità, dalla zona litorale a quella abissale. Inoltre sono animali sessili, cioè vivono ancorati a una roccia o ad altri oggetti del fondale, perciò non sono in grado di muoversi. Il continuo passaggio dell’acqua attraverso il corpo poroso della spugna è indispensabile per la sopravvivenza dell’animale: l’acqua trasporta i microrganismi di cui la spugna
1 Come è fatta una spugna.
La superficie esterna è rivestita da cellule appiattite.
La cavità interna è chiamata spongocele ed è tappezzata da cellule flagellate, i coanociti. Muovendo i loro flagelli, i coanociti spingono l’acqua verso l’osculo favorendo l’ingresso di altra acqua attraverso i pori.
flusso d’acqua
coanociti pori spicole


Tra la superficie esterna e la cavità interna è posto uno strato gelatinoso, la mesoglea, dove si trovano le cellule ameboidi che svolgono diverse funzioni: digeriscono le sostanze nutritive e le distribuiscono a tutto l’organismo, possono produrre gameti e secernono le spicole. Le spicole sono strutture rigide simili a spine che servono a sostenere l’organismo. Possono essere calcaree, silicee o cornee (come quelle delle spugne “da bagno”).
si nutre, permette la respirazione perché contiene ossigeno e consente l’eliminazione delle sostanze di rifiuto; inoltre, facilita la riproduzione, perché il flusso di acqua in uscita porta con sé le cellule uovo e gli spermatozoi. I poriferi non possiedono un sistema nervoso e la loro sensibilità si limita a quella delle singole cellule di cui sono costituiti.
La riproduzione delle spugne è prevalentemente asessuata e può avvenire per gemmazione o per frammentazione.
• Nella riproduzione per gemmazione, sul corpo della spugna si forma un piccolo gruppo di cellule, la gemma, che in seguito si stacca e si sviluppa in modo autonomo.
• Nella riproduzione per frammentazione, da qualsiasi frammento dell’organismo, anche molto piccolo, si riforma un nuovo individuo identico al genitore.
3 Cnidari o celenterati
Meduse, polipi, coralli, idra e anemoni di mare sono animali acquatici, prevalentemente marini, che appartengono al phylum degli cnidari 2 . Sono anche chiamati celenterati poiché il corpo è dotato di una cavità interna, il celenteron
Si può fare qualcosa per salvare le barriere coralline?
Approfondire la conoscenza dell’ambiente di vita dei coralli e del loro ciclo vitale può essere il primo passo per sensibilizzare i cittadini e invitarli a sostenere le iniziative di conservazione promosse in varie parti del mondo per fermare la progressiva scomparsa delle barriere coralline. Già oggi gli scienziati utilizzano delle tecniche per trapiantare milioni di larve di corallo nei fondali oceanici dove la barriera appare danneggiata. Questa tecnica è stata applicata con successo dai ricercatori dalla Southern Cross University nella Grande Barriera australiana, dove il corallo è riuscito a rigenerarsi.
2 Le meduse sono cnidari.


3
Organizzazione del corpo di polipo e medusa.
I celenterati mostrano due diverse forme di organizzazione del corpo 3 :
• il polipo è a forma di imbuto, vive fissato al fondale marino o a una roccia, con l’apertura verso l’alto;
• la medusa ha forma a ombrello ed è libera di spostarsi con lenti movimenti o di farsi trasportare dalla corrente.
tentacolo
bocca

piede


piede
ectoderma
mesoglea



celenteron
endoderma


tentacolo

mesoglea ectoderma
celenteron
endoderma
ectoderm
mesoglea
celenteron
endoderma
In entrambe le forme è presente il celenteron, che è dotato di una bocca ed è circondato da tentacoli.
Il livello di organizzazione corporea di questi animali è più ordinato e complesso di quello dei poriferi: il corpo dei celenterati presenta simmetria raggiata e veri e propri tessuti, tra cui una primitiva rete di cellule nervose che coordina le attività dell’organismo, e un tessuto che permette al corpo di contrarsi.
A partire dai celenterati si sono evoluti recettori in grado di percepire stimoli interni ed esterni, e nelle meduse sono addirittura presenti organi sensibili alla radiazione luminosa.
Lo strato esterno dell’animale, chiamato ectoderma, è formato da un tessuto di rivestimento che protegge il corpo dell’animale. Lo strato interno, detto endoderma, ricopre il celenteron ed è formato da cellule con il compito di digerire le prede catturate con i tentacoli.
Tra l’ectoderma e l’endoderma si trova uno strato gelatinoso, la mesoglea, privo di cellule o contenente cellule provenienti dai due strati adiacenti.
I tentacoli sono provvisti di particolari cellule, gli cnidoblasti, che servono all’animale per la difesa e per paralizzare le prede. Ogni cnidoblasto è munito di un filamento acuminato, pieno di una sostanza urticante simile a quella prodotta dalle ortiche. Non appena un animale (preda o predatore) sfiora lo cnidoblasto, il filamento viene estroflesso come una molla e inietta il liquido urticante nel malcapitato.
bocca
bocca
polipo
medusa
Alcuni celenterati presentano una sola delle due forme per tutta la vita (o polipo o medusa), mentre per altri, polipi e meduse sono due fasi successive del ciclo vitale. I celenterati si riproducono sia per via sessuata sia per via asessuata. Nel ciclo vitale di una medusa si alternano una fase sessuata e una fase asessuata 4
5. Quando la colonia è matura, il polipo più in alto si stacca, si “gira” e diventa una medusa libera che si riproduce sessualmente con un’altra medusa, cominciando un nuovo ciclo.


4. Il polipo si divide per gemmazione e dà origine a una colonia di polipi impilati l’uno sull’altro.


4 Il ciclo vitale della medusa.


1. Due meduse producono i gameti: le cellule uovo e gli spermatozoi.
2. Con la fecondazione ha origine una piccola larva cigliata.
FISSA I CONTENUTI ESSENZIALI
Completa le frasi con i termini corretti.



3. La larva si fissa sul fondale e cresce in un individuo sessile a forma di polipo.
1. Il corpo dei celenterati presenta simmetria e veri e propri tessuti, tra cui una primitiva rete di cellule nervose.
2. Nella riproduzione per , da qualsiasi frammento dell’organismo si riforma un nuovo individuo identico al genitore.
3. Le spugne sono organismi pluricellulari, ma presentano ancora caratteristiche tipiche degli organismi .
4. La medusa ha forma a ombrello mentre il ha forma a imbuto.
VERSO LE COMPETENZE
Osserva il disegno.
1. Che cosa rappresenta?
2. Che cosa succede nel piede?
3. Che cosa può avere generato questa situazione?

vermi e molluschi lezione 4
Guarda il video e scrivi le risposte sul quaderno.
CARTA PENNA COMPUTER

Molluschi in vetrina
1. Che cosa contraddistingue i nudibranchi dagli altri molluschi?
2. Perché alcune specie di bivalvi, come per esempio la tridacna gigante, riescono a raggiungere ragguardevoli dimensioni?
3. Quale strategia ha evoluto il nautilo per riuscire a nuotare agilmente nonostante l’ingombrante conchiglia?
4. Quali sono le caratteristiche dei cefalopodi?
1 I platelminti
Metti in pausa il video nel seguente punto.

5. Quale particolare adattamento ha evoluto questo mollusco?
I platelminti sono detti anche “vermi piatti” per la forma appiattita del loro corpo. Possono essere acquatici o terrestri, condurre vita libera o essere parassiti di altri animali.
Il phylum dei platelminti comprende vermi con il corpo piatto e allungato, con una simmetria bilaterale.

planaria.
Nei platelminti i tessuti svolgono funzioni ben precise e sono organizzati in veri e propri organi. Tuttavia i platelminti hanno ancora un apparato digerente con una sola apertura, attraverso cui aspirano i microrganismi di cui si nutrono ed espellono le sostanze di rifiuto. La respirazione non richiede organi specializzati perché gli scambi gassosi tra l’animale e l’ambiente avvengono attraverso l’intera superficie del corpo: per questo si parla di respirazione cutanea. Il sistema nervoso, molto primitivo, è costituito da un ammasso di cellule nervose (gangli) che si concentrano nella regione del capo, dove si trovano anche organi di senso molto semplici.
I platelminti si riproducono sessualmente e sono in genere ermafroditi, cioè ogni individuo possiede sia gli organi riproduttivi maschili sia quelli femminili. La riproduzione può anche essere asessuata, grazie alla spiccata capacità di rigenerazione: il corpo di alcuni platelminti può frammentarsi in più parti, ciascuna delle quali è in grado di riprodurre la porzione mancante. Un platelminta molto comune è la planaria, che vive nelle acque dolci e fredde di stagni e torrenti 1 . Esistono anche platelminti parassiti, per esempio la tenia, conosciuta come “verme solitario” che può infettare anche l’uomo.
ORA FERMA L’IMMAGINE!
2 I nematodi
I nematodi, chiamati anche “vermi cilindrici”, hanno un corpo lungo e sottile rivestito da una cuticola resistente ed elastica. Alcuni conducono vita libera nelle acque o nel terreno (in una manciata di terra se ne possono trovare più di 100 000), ma la maggior parte di essi sono parassiti di piante e animali.
Il phylum dei nematodi comprende vermi con il corpo cilindrico provvisto di due aperture distinte, una bocca e un ano, poste alle estremità opposte del corpo.
I nematodi possiedono organi più evoluti rispetto ai platelminti: hanno dei muscoli e l’apparato digerente è costituito da un tubo con una bocca, per introdurre il cibo, e un ano per eliminare le sostanze non digerite. La respirazione avviene attraverso la superficie del corpo. I nematodi si riproducono sessualmente e presentano un dimorfismo sessuale, cioè una netta differenza tra maschi e femmine.
3 Gli anellidi
Il nome anellidi deriva dal latino e significa “piccolo anello”: la caratteristica principale degli anellidi, infatti, è la suddivisione del corpo in una serie di segmenti (gli “anelli”) che si ripetono sempre uguali con l’eccezione del primo e dell’ultimo. Tali segmenti sono chiamati metàmeri
Appartengono a questo phylum il lombrico, animali acquatici come i policheti 2 e parassiti come la sanguisuga che si nutrono del sangue di altri animali.
Il phylum degli anellidi comprende vermi con celoma e con il corpo diviso in metàmeri.

2 Lo Spirobranchus giganteu, una specie di polichete, possiede branchie colorate che si avvolgono a spirale tanto da farlo assomigliare a un albero di natale.
3 Come è fatto un lombrico.
Il corpo è rivestito da una cuticola, resistente ed elastica, provvista di setole nella parte inferiore. Il corpo è suddiviso in metameri.
Ogni metamero presenta la stessa struttura e contiene gli stessi organi: due gangli, due organi escretori, muscoli e vasi sanguigni 3 . Nelle specie terrestri lo scambio di gas avviene per diffusione attraverso la superficie del corpo; le specie acquatiche invece respirano con le branchie
Gli anellidi si riproducono sessualmente; alcuni sono ermafroditi.
L’apparato circolatorio è di tipo chiuso. Piccoli cuori pompano il sangue in una rete di minuscoli vasi.
Il sistema nervoso è formato da una catena di gangli e da un cordone nervoso che percorre tutto il corpo dell’animale.
L’apparato escretore è costituito da piccoli fori presenti in ciascun metamero, attraverso cui i prodotti di rifiuto sono riversati all’esterno.
4 I molluschi

ESTETICA DELLA NATURA
LA SEZIONE AUREA
SKILL BOOK
4 Come è fatta una chiocciola.
Il capo è provvisto di bocca e di organi di senso.
Il piede è un organo muscolare e permette il movimento dell’animale.
L’apparato digerente, provvisto di bocca e ano, attraversa tutto il corpo.
I molluschi sono animali dal corpo “molle” (da cui il loro nome) spesso protetto da una conchiglia. Comprendono specie dall’aspetto assai diverso, come le chiocciole, le lumache, le vongole, le seppie e il polpo.
Il phylum dei molluschi comprende animali invertebrati con il corpo molle, dotati di celoma e privi di metameri.
Il corpo dei molluschi è suddiviso in due parti: il capo e il tronco, in cui si trovano il piede, il sacco dei visceri e il mantello 4


Il sacco dei visceri contiene gli organi degli apparati circolatorio, digerente, escretore e riproduttore.
La conchiglia, formata da carbonato di calcio, protegge e sostiene il corpo.
Il mantello riveste il sacco viscerale, estendendosi ai lati e posteriormente come una piega cutanea. Produce la conchiglia.
setole
cordone nervoso metameri cuori
tubo digerente
bocca
ano
I molluschi sono prevalentemente marini; alcune specie vivono in acqua dolce, altre sulla terraferma. Le specie acquatiche respirano per mezzo delle branchie, le specie terrestri invece con un polmone rudimentale. I molluschi si riproducono sessualmente; alcune specie hanno sessi separati, altre sono ermafrodite. I molluschi sono suddivisi in tre classi principali: gasteropodi, bivalvi e cefalopodi 5


I gasteropodi hanno la conchiglia formata da un unico pezzo, ma in alcune specie può mancare. Il piede è ben sviluppato ed è adatto a strisciare. La bocca è provvista della radula, una lamina munita di dentelli con la quale i gasteropodi raschiano i vegetali. Appartengono a questa classe le chiocciole di terra, di mare e le lumache.
I cefalopodi sono generalmente privi di conchiglia o ne possiedono una molto ridotta e interna (“osso di seppia”). Il piede si è spostato vicino al capo ed è suddiviso in tentacoli, disposti intorno alla bocca, che l’animale usa per catturare le prede. I cefalopodi si muovono espellendo l’acqua da un tubo muscoloso, il sifone. Comprendono seppie, calamari e polpi.
Polpo e polipo sono lo stesso animale?
Assolutamente no! I polpi appartengono al phylum dei molluschi, sono dotati di otto tentacoli con i quali nuotano in ogni direzione e possiedono un’intelligenza straordinaria. I polipi, invece, sono minuscoli celenterati che vivono ancorati a un substrato.
Alcuni polipi sono solitari, come l’anemone di mare, altri vivono in enormi colonie uno vicino all’altro, costruendosi uno scheletro di carbonato di calcio: le barriere coralline sono gli esempi più spettacolari dell’attività dei polipi corallini.
FISSA I CONTENUTI ESSENZIALI
Segna con una crocetta se vero (V) o falso (F).
1. La tenia è un verme parassita che appartiene al gruppo dei nematodi.
2. La chiocciola è un gasteropode.
3. Il lombrico appartiene al phyum degli anellidi.
4. I nematodi si riproducono asessualmente.
5 Le principali classi dei molluschi.

I bivalvi hanno la conchiglia formata da due pezzi, le valve, che azionano grazie a potenti muscoli. Vivono ancorati agli scogli o ad altre superfici. Si procurano il cibo filtrando l’acqua in cui sono immersi. Sono bivalvi le vongole, le cozze e le ostriche.
SCIENZA
artropodi ed echinodermi lezione 5
CARTA PENNA COMPUTER

Sfoglia la galleria di immagini e scrivi le risposte sul quaderno.

1. Perché gli artropodi hanno avuto un così grande successo evolutivo?
2. Qual è l’insetto più forte? Che cosa è in grado di fare?
3. Dove puoi incontrare un Archispirostreptus giga? Quali dimensioni può raggiungere?
4. Prova a descrivere l’habitat di Munidopsis polimorfa basandoti sulle sue peculiari caratteristiche.
1
Un gruppo di successo
Il gruppo animale più numeroso sulla Terra è quello degli artropodi : si conoscono oltre un milione di specie, ma si pensa che sulla Terra ve ne siano molte di più! L’enorme diffusione è possibile grazie soprattutto allo scheletro esterno, l’esoscheletro, che ricopre tutto il corpo. L’esoscheletro ha numerose funzioni:
• protegge gli organi interni;
• sostiene la muscolatura;
• permette l’inserimento di numerose e diverse appendici;
• isola il corpo dall’ambiente esterno;
• riduce la disidratazione, cioè le perdite di acqua per evaporazione.
1

L’esoscheletro è composto da chitina, una sostanza dura ma molto flessibile. Negli artropodi marini, che devono sopportare pressioni molto forti, l’esoscheletro è impregnato di sali di calcio, che lo rendono più rigido e duro come le piastre di una corazza 1 L’esoscheletro non può svilupparsi insieme all’organismo; per questo motivo gli artropodi sono costretti ad abbandonarlo periodicamente e a costruirne uno nuovo, adatto alle nuove dimensioni, attraverso un processo chiamato muta. ll nuovo esoscheletro è inizialmente molle, ma ben presto si indurisce a contatto
L’esoscheletro è formato da segmenti che si articolano fra loro per permettere all’animale di muoversi con facilità su qualsiasi superficie. In corrispondenza delle articolazioni la chitina è più sottile e si possono inserire delle coppie di appendici articolate con diverse funzioni: permettere all’animale di muoversi, difender-
La ricerca di Hasler
Artropodi da record
CONTENUTI DIGITALI
Un esoscheletro duro come una corazza.
si, afferrare il cibo e percepire gli stimoli esterni. Per esempio le formiche sono dotate di zampe articolate e utilizzano le antenne per percepire gli odori. È questa caratteristica che dà il nome al phylum: artropode significa, infatti, “animale dotato di arti articolati”.
Il phylum degli artropodi comprende animali dotati di esoscheletro e appendici articolate.
Gli artropodi sono divisi in quattro classi: miriapodi, aracnidi, crostacei e insetti
2
Le caratteristiche generali degli artropodi
Gli artropodi comprendono animali molto differenti tra loro, come i millepiedi, gli insetti, i ragni e i granchi, ma tutti hanno alcune caratteristiche in comune.
Il corpo degli artropodi è suddiviso in metameri. Il loro numero è inferiore a quello degli anellidi perché alcuni metameri si sono fusi; inoltre si sono modificati per formare strutture specializzate. Negli insetti il corpo è suddiviso in tre parti: il capo, il torace e l’addome 3 . Negli artropodi più primitivi, come ragni e crostacei, sono fusi anche il capo e il torace, così i segmenti sono solo due: il cefalotorace e l’addome Il capo protegge il sistema nervoso che è piuttosto sviluppato: è formato da un primitivo cervello collegato a un cordone nervoso ventrale e agli organi di senso.
Gli occhi sono gli organi di senso più evoluti: possono essere occhi semplici, come nei ragni, oppure occhi composti come quelli degli insetti. Gli occhi composti sono formati da migliaia di piccoli occhi semplici riuniti insieme. Ogni occhio “registra” solo una piccola porzione dello spazio e il cervello poi unisce tutte le immagini parziali in un’unica immagine d’insieme 4 .
3 Le parti del corpo di un insetto.
CHI è IL GRANCHIO DELLE PALLINE?
Si tratta della Scopimera globosa, o granchio gorgogliatore, un piccolo crostaceo grande poco più di un pollice, che trascorre la vita nascosto in cunicoli scavati sotto la sabbia, lungo la linea di costa. Quando la marea si ritira, emerge per setacciare la sabbia alla ricerca di minuscoli organismi di cui si nutre. Ogni volta che il granchietto trova qualcosa da mangiare, forma una pallina di sabbia e la sposta, così da non passare due volte nello stesso punto.


4 Gli occhi composti degli insetti.
capo torace addome

Un insetto sotto la lente
5
Come è fatta una cavalletta.
ano
Gli artropodi acquatici respirano per mezzo delle branchie, mentre quelli terrestri possiedono le trachee, che si aprono all’esterno attraverso piccoli fori dell’esoscheletro, gli stigmi. Alcuni artropodi terrestri, come i ragni, respirano mediante particolari polmoni, i polmoni a libro, che funzionano come delle branchie interne.
Tutti gli artropodi hanno un apparato digerente formato da un tubo che percorre l’intero corpo dell’animale e che ha due aperture, la bocca e l’ano 5 . L’apparato circolatorio è aperto: una serie di piccoli cuori contrattili, situati nella parte dorsale del corpo, spinge un liquido simile al sangue, l’emolinfa, in una cavità chiamata emocele, dove l’emolinfa bagna direttamente gli organi interni.
L’eliminazione delle sostanze di rifiuto è affidata a un primitivo apparato escretore, formato da minuscoli tubuli che si aprono all’esterno.
Nella maggior parte degli artropodi i sessi sono separati e la fecondazione avviene all’interno del corpo della femmina. In alcune specie nascono animali simili ai genitori, in altre si originano delle larve che subiscono la metamorfosi, cioè successive trasformazioni che le fanno diventare insetti adulti 6 .
cuori dorsali intestino
stomaco
antenne

cordone nervoso ventrale
esofago
6 La metamorfosi della farfalla.
zampe articolate
occhi composti
bocca


Dall’uovo esce la larva o bruco. I bruchi divorano grandi quantità di cibo e compiono la muta diverse volte per accrescersi.
Al termine della metamorfosi l’adulto fuoriesce dal bozzolo e comincia la sua nuova vita.
A un certo punto il bruco si avvolge in un bozzolo protettivo e diventa pupa. La pupa non si muove e non mangia, ma si trasforma progressivamente nell’individuo adulto.
3 Gli echinodermi
Il termine echinoderma significa “pelle spinosa” ed è attribuito ad animali acquatici molto particolari, come stelle marine, ricci di mare e oloturie. Il loro corpo è ricoperto da un dermascheletro, un insieme di piastre calcaree incluse nello spessore della pelle.
Il phylum degli echinodermi comprende animali con il corpo dotato di dermascheletro.
Nel dermascheletro sono inseriti aculei e spine 7 . Inoltre, il dermascheletro è costellato da piccoli fori da cui escono dei tubicini, i pedicelli ambulacrali, con i quali gli animali si spostano e afferrano le prede. Gli echinodermi non hanno un vero apparato circolatorio e nemmeno un apparato escretore. Anche il loro sistema nervoso e gli organi di senso sono scarsamente sviluppati. L’apparato digerente inizia con la bocca, che si trova sulla faccia ventrale dell’animale (cioè la faccia che poggia sul fondale marino) ed è munita di un apparato masticatore; termina con l’ano che si trova sulla faccia opposta 8
Gli echinodermi si riproducono sessualmente. Dall’unione di un ovulo con uno spermatozoo si origina una larva che presenta caratteristiche diverse rispetto all’animale adulto: ha simmetria bilaterale e possiede una corda, ovvero un cordoncino di cartilagine che sostiene il corpo e permette all’animale di muoversi più facilmente. Queste caratteristiche scompaiono nell’animale adulto: infatti stelle marine, ricci e oloturie presentano una simmetria raggiata e non possiedono nessuna struttura di sostegno interna all’organismo.
La comparsa della corda nelle larve degli echinodermi è la prova che questo phylum ha preceduto il phylum al quale appartengono tutti gli animali vertebrati, compresa la specie umana.
ano
7 I ricci di mare hanno spine particolarmente vistose.

8 Come è fatta una stella marina.

FISSA I CONTENUTI ESSENZIALI
Abbina i termini alla definizione corretta.
1 Chitina
2 Cefalotorace
3 Stigmi
4 Metamorfosi
5 Pedicelli ambulacrali
pedicelli ambulacrali
a Metamero tipico degli artropodi primitivi in cui il capo e il torace sono fusi insieme.
b Serie di trasformazioni che portano alla trasformazione da una larva a un insetto adulto.
c Sostanza dura ed elastica che compone l’esoscheletro.
d Appendici mobili che permettono il movimento degli echinodermi.
e Piccoli fori che permettono la respirazione negli artropodi terrestri.
1: 2: 3: 4: 5:
braccia
VISUAL

degli artropodi Le classi
Il phylum degli artropodi comprende quattro classi: i miriapodi, gli aracnidi, i crostacei e gli insetti.
I MIRIAPODI
I miriapodi hanno il corpo allunga to, suddiviso in numerosi metameri, ognuno dei quali è provvisto di uno o due paia di zampe. Sono tutti ter restri: vivono sotto la corteccia degli alberi o sotto i sassi, in luoghi piut tosto umidi.
Comprendono i centopiedi e i mil lepiedi.


GLI ARACNIDI
Il corpo degli aracnidi è formato dal cefalotorace, che comprende il capo e il torace fusi insieme, e dall’addome. Sul cefalotorace si trovano sei paia di appendici articolate: le prime due sono in relazione con la bocca e sono i cheliceri, che servono per la cattura del cibo perché consentono di iniettare nella preda un veleno che la paralizza; le altre due sono i pedipalpi, organi del tatto e dell’odorato. Le altre quattro paia di appendici sono le zampe e servono per la locomozione. A questa classe appartengono ragni, zecche, acari e scorpioni.

I CROSTACEI
I crostacei sono protetti da un esoscheletro duro, il formato da chitina e carbonato di calcio; hanno il corpo suddi viso in cefalotorace e addome. Il capo è provvisto di due paia di antenne, sensibili alle vibrazioni sonore, e di un paio di occhi, a volte peduncolati.
Il cefalotorace ha in genere cinque paia di zampe, di cui il primo termina con un paio di grosse pinze, le chele, che servono per afferrare il cibo e per la difesa. Alcuni segmenti dell’addome portano appendici articolate, che l’animale usa per nuotare e durante la riproduzione.
GLI INSETTI

I crostacei sono prevalentemente marini; i più noti sono quelli commestibili, come l’aragosta, l’astice, il gamberetto e il granchio.

Costituiscono la più vasta classe di artropodi e il gruppo più ricco di animali oggi esistente sulla Terra. Il capo è munito di occhi composti, di un paio di an tenne e di un apparato boccale che assume varie forme, secondo il tipo di alimenta zione delle diverse specie. Il torace ha tre paia di zampe e, in alcune spe cie, uno o due paia di ali. L’addo me è spesso dotato di appendici che servono per la riproduzione. In genere lo sviluppo degli insetti avviene mediante la metamorfosi
Gli insetti includono diversi ordini, tra cui quello dei lepi dotteri, dei ditteri, dei coleotteri e quello degli ortotteri.


Le farfalla è un lepidottero; la coccinella un coleottero.

CON LA SINTESI
lezione 1 SOSTEGNO, MOVIMENTO, RISPOSTA
AGLI STIMOLI
Gli animali sono organismi eucarioti pluricellulari eterotrofi e comprendono gli invertebrati e i vertebrati. Una conseguenza degli adattamenti degli animali ai diversi ambienti è stata la comparsa di una disposizione simmetrica delle diverse parti rispetto a un asse. Gli animali marini che vivono ancorati a una superficie hanno simmetria raggiata, gli animali che si muovono hanno simmetria bilaterale. Il corpo degli animali può essere descritto come un tubo, il canale digerente, collocato all’interno della parete esterna. Negli animali più complessi è presente il celoma, una cavità tra la parete esterna del corpo e il tubo interno, dove si trovano gli organi interni. Il movimento degli animali è reso possibile dal sistema muscolare e dallo scheletro, che può essere esterno (esoscheletro), tipico degli invertebrati, o interno (endoscheletro), il sostegno dei vertebrati. I segnali che provengono dall’ambiente e gli stimoli interni al corpo sono raccolti da particolari cellule, i recettori, che in molti animali sono riunite in appositi organi di senso. Altre cellule specializzate, i neuroni, elaborano gli stimoli e inviano una risposta adeguata agli organi interessati.
lezione 2 NUTRIZIONE, RESPIRAZIONE, CIRCOLAZIONE
E RIPRODUZIONE
Gli animali, che assumono il cibo con la nutrizione, possono essere erbivori, carnivori, onnivori o filtratori e possiedono organi per la digestione. Con la respirazione esterna gli organismi immettono ossigeno nell’organismo ed eliminano anidride carbonica; con la respirazione interna le cellule producono energia. Negli animali più semplici, ossigeno e anidride carbonica si diffondono da una cellula all’altra; negli anfibi avviene anche attraverso la superficie del corpo; gli animali acquatici respirano con le branchie, quelli terrestri con le trachee e i polmoni. L’apparato circolatorio trasporta l’ossigeno e i prodotti della digestione a tutte le cellule del corpo. Le sostanze di rifiuto sono eliminate attraverso l’apparato escretore. Gli animali, quando raggiungono la maturità, sono in grado di riprodursi. La riproduzione può essere asessuata o sessuata



lezione 3 PORIFERI E CNIDARI
Il phylum dei poriferi comprende le spugne, animali acquatici sessili con il corpo a forma di sacco. L’acqua, che trasporta ossigeno e microrganismi, entra dai pori ed esce attraverso un’apertura più grande, l’osculo. La riproduzione è asessuata e può avvenire per gemmazione o per frammentazione. Il phylum degli cnidari comprende meduse e coralli. I celenterati hanno due diverse forme del corpo: il polipo, a forma di imbuto, che vive fisso al fondale, e la medusa, a forma di ombrello, che è libera di muoversi. Il corpo dei celenterati è formato da un tessuto esterno, l’ectoderma, da una cavità interna, il celenteron, che contiene le cellule per la digestione, e da un tessuto interno, l’endoderma. La riproduzione dei celenterati avviene sia per via sessuata sia per via asessuata

lezione 4 VERMI E MOLLUSCHI
I platelminti sono i vermi con il corpo piatto e allungato: hanno simmetria bilaterale e un apparato digerente con una sola apertura. I nematodi sono i vermi cilindrici, per lo più parassiti, con il corpo rivestito da una cuticola elastica. Hanno un apparato digerente con due aperture: la bocca da cui entra il cibo e l’ano per eliminare le sostanze di rifiuto. Gli anellidi sono vermi, terrestri e acquatici, con il corpo diviso in segmenti a forma di anelli, i metameri, che si ripetono lungo tutto il corpo e contengono gli stessi organi. I molluschi sono animali dal corpo molle, spesso protetto da una conchiglia. I molluschi acquatici respirano con le branchie, quelli terrestri con polmoni primitivi. I molluschi sono suddivisi in gasteropodi, come le chiocciole, bivalvi, come le vongole e cefalopodi, come le seppie.
lezione 5 ARTROPODI ED ECHINODERMI
Il phylum degli artropodi comprende miriapodi, aracnidi, crostacei e insetti. Il corpo degli artropodi è protetto da un esoscheletro di chitina, che non cresce con l’organismo ma è periodicamente sostituito con la muta. Nell’esoscheletro si inseriscono le appendici articolate, che permettono il movimento. Gli echinodermi sono animali acquatici con il corpo coperto da piastre calcaree che formano il dermascheletro, dove sono inseriti aculei e spine. Il movimento avviene attraverso i pedicelli ambulacrali. La riproduzione è sessuata; la larva ha una simmetria bilaterale e una corda che sostiene il corpo. Queste caratteristiche scompaiono nell’adulto.


CON LA MAPPA
Adesso che hai ripassato i contenuti essenziali con la sintesi, prova a completare la mappa con le parole chiave suggerite e a trovare le definizioni corrispondenti.
conchiglia - dermascheletro - insetti - meduse - poriferi - vermi
1. GLI INVERTEBRATI
3. celenterati
4. sono suddivisi in
5. molluschi
6. artropodi
7. echinodermi
a cui appartengono le 8.

a cui appartengono gli 9.
sono animali dotati di una come
10. struttura di sostegno esterna 12. esoscheletro 13.
a. Phylum che comprende gli animali con corpo molle.
b. Phylum che comprende gli animali dotati di appendici articolate.
c. Phylum che comprende stelle marine e ricci di mare.

d. Phylum che comprende animali con caratteristiche di organismi coloniali.
11.
2.
FISSA I CONTENUTI ESSENZIALI
lezione 1 SOSTEGNO, MOVIMENTO, RISPOSTA AGLI STIMOLI
1 Segna con una crocetta se vero (V) o falso (F).
a. Gli animali sono organismi eterotrofi.
b. La locomozione è legata all’apparato escretore.
c. L’idroscheletro è tipico dei molluschi.
d. Un animale senza capo e coda ha simmetria raggiata.
e. I lombrichi possiedono il celoma.
2 Scegli la soluzione corretta.
a. Gli animali sono:
1 unicellulari.
2 procarioti.
3 autotrofi.
4 eterotrofi.
b. La conchiglia è un esempio di:
1 idroscheletro.
2 esoscheletro.
3 endoscheletro.
4 dermascheletro.
c. Il movimento degli animali è reso possibile:
1 dal sistema muscolare e scheletrico.
2 dal celoma.
3 dal sistema nervoso.
4 dall’apparato circolatorio.
lezione 2 NUTRIZIONE, RESPIRAZIONE, CIRCOLAZIONE E RIPRODUZIONE
3 Sottolinea il termine corretto tra i due proposti.
a. Nella riproduzione un solo organismo ne hanno origine altri identici al genitore.

b. I gameti sono gli organi tipici della riproduzione asessuata/

c. La gemmazione è un tipo di riproduzione degli invertebrati/dei vertebrati
d. Le ovaie sono gli organi che fanno parte delle gonadi dei maschi/delle femmine

4 Abbina i termini con l’apparato corretto.
1. Bocca
2. Trachee
3. Vene
4. Superficie corporea
5. Gonadi
a Apparato riproduttore b Apparato escretore
c Apparato circolatorio
d Apparato digerente
e Apparato respiratorio
1. 2. 3. 4. 5.
5 Completa il brano con i termini corretti.
I vertebrati possiedono un apparato formato da un
e da due tipi di vasi (le vene e le ) che formano un circuito al cui interno scorre il .
lezione 3 PORIFERI E CNIDARI
6 Segna con una crocetta se vero (V) o falso (F).
a. Il nome comune dei poriferi è coralli.
b. Attraverso l’osculo l’acqua entra nella spugna.
c. I poriferi sono organismi sessili.
d. Il celenteron è la cavità interna del corpo dei celenterati.
e. Nei celenterati esiste una primitiva rete di cellule nervose.
7 Osserva il disegno e inserisci accanto a ogni termine il numero corrispondente.

lezione 4 VERMI E MOLLUSCHI
8 Scegli la soluzione corretta.
a. La definizione di vermi piatti è tipica del phylum dei:
1 platelminti.
2 nematodi.
3 anellidi.
4 molluschi.
b. I nematodi:
1 respirano con le branchie.
2 sono ermafroditi.
3 presentano dimorfismo sessuale.
4 hanno i metameri.
c. I policheti appartengono al phylum:
1 dei platelminti.
2 dei nematodi.
3 degli anellidi.
4 dei molluschi.
9 Segna con una crocetta se vero (V) o falso (F).
a. Tutti i molluschi sono protetti da una conchiglia esterna.
b. I bivalvi sono molluschi.
c. La bocca dei gasteropodi è provvista di radula.
d. I molluschi acquatici hanno le branchie.
e. Le seppie si riproducono asessualmente.
10 Osserva il disegno e inserisci accanto a ogni termine il numero corrispondente.


11 Sottolinea le parole sbagliate presenti nel brano.
Negli artropodi marini, che devono sopportare pressioni molto deboli, l’endoscheletro è impregnato di sali di calcio che lo rendono più elastico e duro come le piastre di una corazza.
12 Osserva il disegno e inserisci accanto a ogni termine il numero corrispondente.

Cuori dorsali
Intestino Antenne
Bocca
Occhi composti Zampe articolate
13 Abbina i termini con la definizione corretta.
1. Cefalotorace
2. Occhi composti
3. Corda
4. Pedicelli ambulacrali
5. Dermascheletro
a Cordoncino di cartilagine che sostiene il corpo.
b Insieme di piastre calcaree incluse nello spessore della pelle.
c Tubicini con i quali gli echinodermi si spostano e afferrano le prede.
d Parte del corpo degli artropodi primitivi.
e Organi visivi degli insetti.
LEGGERE UN GRAFICO IN MODO CRITICO
1 Osserva il grafico e rispondi alle domande.


RICAVARE INFORMAZIONI DALLE IMMAGINI
RICERCARE INFORMAZIONI IN RETE
4 Scrivi in corrispondenza di ciascuna foto di quale insetto si tratta.






a. Che cosa rappresenta il grafico?




b. Qual è il phylum di animali più numeroso?
c. Sai calcolare all’incirca la percentuale totale degli invertebrati?
d. Sai spiegare le ragioni di questa distribuzione degli animali?



RIFLETTERE E SPIEGARE
2 Spiega la frase seguente.
Gli animali acquatici che vivono ancorati ai fondali sono avvantaggiati dalla simmetria raggiata.
INDIVIDUARE CARATTERISTICHE E SPIEGARE
3 Spiega la differenza tra esoscheletro e dermascheletro.
Abbina il disegno di ogni apparato boccale con la foto dell’insetto al quale appartiene.


1. 2. 3.
Rispondi alle domande.

a. Quale apparato è più adatto a triturare frammenti di vegetali?
b. Quale apparato è adatto a succhiare il nettare?
c. Quale apparato è adatto a pungere e succhiare?
INTERPRETARE E COMMENTARE UN MODELLO
5 Come si definisce la circolazione? a b c 1 2 3





Confronta i modelli dell’apparato circolatorio aperto e di quello chiuso e descrivili.





INTERPRETARE E TRARRE INFORMAZIONI DA UN TESTO
8 Leggi il brano. GIORNATA MONDIALE DELLE API
RICAVARE INFORMAZIONI DALLE IMMAGINI
7 Osserva il disegno che rappresenta il corpo di una spugna e rispondi alle domande.
a. In che direzione si muove il flusso dell’acqua nell’animale?

Il 20 dicembre 2017, l’Assemblea generale delle Nazioni Unite ha dichiarato il 20 maggio di ogni anno la Giornata mondiale delle api, perché sempre più impollinatori in tutto il mondo sono sull’orlo dell’estinzione. Le cause sono molteplici e concatenate: distruzione, degradazione e frammentazione degli habitat, inquinamento (in particolare da pesticidi), cambiamenti climatici e diffusione di specie aliene invasive, parassiti e patogeni. Lo scopo della risoluzione è portare all’attenzione l’importanza delle api e in generale di tutti gli impollinatori per la sicurezza alimentare, la sussistenza di centinaia di milioni di persone e per il funzionamento degli ecosistemi e la conservazione degli habitat. Gli impollinatori sono animali che, visitando i fiori alla ricerca di nettare e polline, s’imbrattano di polline. Visitando i fiori di altre piante, trasferiscono il polline sullo stigma. Attraverso lo stigma il polline giunge poi a fecondare l’ovario, permettendo così la riproduzione della pianta.
Circa il 70% delle colture agrarie mondiali beneficia dell’impollinazione animale. In Europa la produzione di circa l’80% delle coltivazioni dipende dall’attività degli insetti impollinatori.
(Tratto e adattato dal sito ISPRA ambiente)
Rispondi alle domande e svolgi le attività proposte, da solo o in gruppo con i tuoi compagni.
b. Che cosa sono i coanociti?

c. Quale funzione svolgono?
d. Che cosa sono le spicole?
e. Quali cellule producono le spicole?
Come avviene l’impollinazione?
Per quali ragioni le api e tutti gli impollinatori sono importanti per l’ambiente?
c. Quali fenomeni stanno mettendo a rischio la loro sopravvivenza?
d. Quale percentuale di colture agrarie è connessa con l’attività degli impollinatori?
DIGITAL SKILLS
Ricerca in rete in quali modi è possibile salvare le api dall’estinzione. Prepara una presentazione digitale sull’argomento oppure costruisci un’animazione in coding con Scratch o altri programmi.

MOLLUSCS
Molluscs are invertebrates. They have a soft body that is often protected by a hard shell. Snails, slugs, clams, cuttlefish and octopuses are all molluscs. Some species live in fresh water and others on land, but most molluscs live in the sea. Water molluscs breathe through gills while land molluscs have a simple lung They reproduce sexually.
■ The classes of molluscs
There are three main classes of molluscs: gastropods, cephalopods and bivalves
GASTROPODS
This class includes snails and slugs, living both on the earth and in water. They have a large ventral foot that they use to crawl. They also have a radula, a type of tongue with built-in teeth. It helps them to scrape plants. Some gastropods do not have a shell, or they have a very small one. Some of them have very beautiful shells that have a spiral or cone shape.


CEPHALOPODS
This class includes cuttlefish, squids and octopuses. They have strong tentacles and a mouth with a hard beak. They swim using their tentacles or by blowing out water from a muscular tube callaed a siphon. They also use their tentacles to pick up food and put it in their mouth. They do not usually have a shell but sometimes they have a very delicate bone inside their body.


BIVALVES
This class includes clams, mussels, and oysters. Their shell is divided into two parts called valves. Many bivalves must attach to rocks or other surfaces to live. Some live on the sandy seabed. Their foot is shaped like a scythe and they make small jumps if they want to move. They eat by filtering the water in their habitat.


COMPREHENSION EXERCISES
Read the information about molluscs and tick the characteristics for each class in the table below.
CLASS FOOT ventral scythe tentacles
Gastropods
Bivalves
Cephalopods
CLASS MOVEMENT swim crawl small jumps
Gastropods
Bivalves
Cephalopods
CLASS NUTRITION
scrape plants block their food filter water
Gastropods
Bivalves
Cephalopods



GILLS branchie LUNG polmone
lossario
octopus
squid
snail slug
clams
oyster
unità
i vertebrati Il regno degli animali: 6 VIVENTI
lezione 1
I pesci
lezione 2
Gli anfibi e i rettili
lezione 3
Gli uccelli
lezione 4
I mammiferi
VISUAL


Gli ordini dei mammiferi placentati
LEZIONI POWERPOINT in


BUONE NOTIZIE PER IL FUTURO
PESCA SOSTENIBILE PER MARI PIu ` RICCHI DI VITA
Per soddisfare la crescente domanda del mercato, la pesca è diventata un’attività intensiva e spesso indiscriminata, proprio come l’agricoltura. La tecnica della pesca a strascico, che prevede l’uso di una grande rete trainata lungo il fondale marino, cattura indiscriminatamente pesci, coralli, tartarughe, delfini e altre specie non commestibili, provocando danni gravi e talvolta irreversibili agli ecosistemi marini. La pesca nasce per invertire questa tendenza: significa prelevare dal mare solo ciò che serve, con metodi selettivi e attrezzi a basso impatto ambientale, rispettando l’ecosistema, proteggendo la biodiversità e lasciando in mare abbastanza esemplari da permettere alle specie di riprodursi. Tra i sistemi più rispettosi dell’ambiente piccola pesca costiera, che utilizza strumenti tradizionali e selettivi come i palangari (lenze con ami distanziati), le nasse e trappole (gabbie che catturano solo alcune specie), pesca a circuizione, che impiega reti disposte in cerchio attorno ai banchi di pesci, senza danneggiare i fondali. L’acquacoltura, praticata in impianti controllati, può affiancare la pesca sostenibile, fornendo pesce nutriente senza impoverire i mari. Anche i consumatori possono fare la loro parte: leggere attentamente l’etichetta e informarsi sull’origine del prodotto è un gesto semplice ma importante per proteggere la biodiversità marina.
I pesci lezione 1
Esplora l’oggetto interattivo e scrivi le risposte sul quaderno.
CARTA PENNA COMPUTER

Il Parco Nazionale
Arcipelago
Toscano
1. Quali sono le caratteristiche del parco?
2. Quali sono le caratteristiche delle specie vegetali che vi crescono?
3. Quali sono i vertebrati che vivono sulle isole?
4. Quali tipi di organismi marini sono descritti nelle immagini?
5. Che cos’è un endemismo? Perché è importante tutelare le specie endemiche?
1 La posizione della corda dorsale negli urocordati, nei cefalocordati e nei vertebrati.
tubo neurale corda

tubo neurale corda

CEFALOCORDATO

1 I cordati
ORA FERMA L’IMMAGINE!
Dai un titolo e scrivi una didascalia per ogni immagine.






VERTEBRATO



Tutti gli animali che ci sono più familiari appartengono al phylum dei cordati: cani, gatti, pesci, lucertole, rane e piccioni, ma anche gli esseri umani, hanno tutti in comune un’importante caratteristica anatomica, quella di possedere una struttura di sostegno, la corda dorsale. Grazie alla corda dorsale, i cordati hanno potuto compiere uno straordinario balzo evolutivo, riuscendo a occupare i più diversi tipi di ambienti.
Il phylum dei cordati comprende animali dotati, almeno in una fase della loro vita, di una corda dorsale per sostenere il corpo.
Tutti i cordati hanno simmetria bilaterale e possiedono un tubo neurale, cioè un cordone cavo di tessuto nervoso, posto sopra la corda dorsale, che si dilata nella testa per formare il cervello. Corda dorsale e tubo neurale si estendono dorsalmente, mentre gli organi dell’apparato circolatorio, respiratorio e digerente sono posti nella zona ventrale. Nei cordati si distinguono tre raggruppamenti: urocordati, cefalocordati e vertebrati 1 Gli urocordati sono i cordati più primitivi; la corda dorsale, che è presente solo nelle larve, è limitata alla coda. Sono organismi marini, come l’ascidia, un animale molto semplice che conduce vita libera allo stadio larvale e da adulto si fissa al fondo perdendo sia la coda sia la corda dorsale.
Nei cefalocordati la corda dorsale si estende per tutta la lunghezza del corpo e rimane per tutta la vita. Il cefalocordato più studiato è l’anfiosso, un animale con il corpo simile a quello di un pesce ma che vive affondato nel fango e nella sabbia.
2 Le caratteristiche dei vertebrati
I vertebrati formano il gruppo più numeroso e diversificato dei cordati. La corda dor sale, che si estende dalla coda fino al cervello, è presente solo nell’embrione: nell’adulto è sostituita dalla colonna vertebrale formata da ossa articolate tra loro, le vertebre. I vertebrati si dividono in cinque classi: pesci, anfibi, rettili, uccelli e mammiferi
I vertebrati sono animali molto diversi tra loro, ma tutti con una caratteristica comune: possiedono la colonna vertebrale.
Vediamo quali sono le altre loro caratteristiche generali.
• La colonna vertebrale è l’asse portante dell’endoscheletro, una struttura scheletrica interna in grado di sostenere il corpo e facilitarne i movimenti. Lo scheletro è formato da due tipi di tessuto: il tessuto osseo, rigido, e il tessuto cartilagineo, meno rigido ma più flessibile.
• Il corpo ha simmetria bilaterale

2 La pelle dei vertebrati. Un anfiosso


• La superficie del corpo è protetta dalla pelle, un organo formato da un tessuto di rivestimento piuttosto sottile che avvolge tutto il corpo dell’animale. Per aumentare la protezione esterna, sulla pelle vi sono diversi tipi di formazioni: scaglie nei pesci 2 a , squame nei rettili 2 b , penne negli uccelli 2 c e peli nei mammiferi 2 d . La pelle degli anfibi invece non ha strutture protettive: per questo si dice che è nuda.
• Il sistema circolatorio è chiuso e il cuore provvede a spingere il sangue in tutto il corpo.
• I vertebrati acquatici respirano l’ossigeno disciolto nell’acqua attraverso le branchie 3 ,quelli terrestri respirano attraverso i polmoni.
• I pesci, gli anfibi e i rettili regolano la temperatura corporea con quella dell’ambiente: questi vertebrati sono definiti eterotermi o a “sangue freddo”. Gli uccelli e i mammiferi invece sono in grado di mantenere costante la temperatura del loro corpo indipendentemente dalle condizioni ambientali: sono detti omeotermi, o a “sangue caldo”.
• La riproduzione è sessuata e i sessi sono separati; la fecondazione può essere interna o esterna secondo l’ambiente.
In base alle modalità di sviluppo dell’embrione, i vertebrati vengono distinti in tre gruppi: ovipari, ovovivipari e vivipari. Negli animali ovipari la femmina depone numerose uova protette dal guscio e l’embrione si sviluppa grazie alle sostanze nutritive contenute nell’uovo. Sono ovipari i pesci, gli anfibi, i rettili, gli uccelli e alcuni mammiferi (l’echidna e l’ornitorinco).

3 Come sono fatte le branchie. a


4 Come è fatto un pesce.
Negli animali ovovivipari l’uovo fecondato rimane nel corpo della femmina; al termine dello sviluppo embrionale, la femmina depone l’uovo e alla schiusa esce il piccolo completamente formato. Appartengono a questo gruppo le vipere.
Negli animali vivipari l’embrione si sviluppa nel corpo della femmina, che lo nutre attraverso la placenta. Terminato lo sviluppo dell’embrione, la femmina partorisce il piccolo. La maggior parte dei mammiferi è vivipara.
3 I pesci
I pesci sono animali eterotermi esclusivamente acquatici 4 .
L’apparato digerente è composto dalla bocca munita di denti, dall’esofago, dallo stomaco e dall’intestino che termina con l’ano. branchie
La respirazione avviene attraverso le branchie poste ai lati del capo.








cuore


Il sistema scheletrico è formato dal cranio e dalla colonna vertebrale, chiamata lisca

Anatomia di un pesce osseo

Anatomia di un pesce cartilagineo
cuore con 2 cavità branchie tessuti















L’apparato circolatorio è di tipo chiuso e semplice: il sangue rimane sempre all’interno dei vasi sanguigni e passa una sola volta per il cuore, che è diviso in due cavità (un atrio e un ventricolo).
Sono divisi in due sottoclassi: i pesci cartilaginei, che hanno lo scheletro formato da cartilagine, e i pesci ossei, che hanno lo scheletro di tessuto osseo
Gli organi di senso più sviluppati sono la linea laterale e le narici. La linea laterale, ben visibile sui fianchi dei pesci ossei, è costituita da una serie di pori che comunicano con un canale interno. In questo canale sono presenti delle cellule nervose capaci di rilevare i cambiamenti di pressione dell’acqua circostante. Grazie alla linea laterale i pesci si accorgono dell’avvicinarsi di una preda o della presenza di un ostacolo. Le narici, dove ha sede l’olfatto, permettono ai pesci di percepire l’odore del cibo.
I pesci possiedono diversi adattamenti per vivere e muoversi nell’acqua:
• il corpo ha forma idrodinamica, cioè affusolata, adatta a ridurre la resistenza dell’acqua; esternamente è rivestito di scaglie, piccole placche sovrapposte come le tegole di un tetto, che favoriscono lo scorrimento dell’acqua sul corpo;
• si muovono grazie a organi specializzati, le pinne, che si distinguono in pari e impari: pari sono le due coppie poste sul petto e sul ventre, impari sono la pinna anale, la pinna dorsale e la pinna caudale 5 .
• la pelle è viscida, perché ricoperta da muco secreto da particolari ghiandole che riduce l’attrito con l’acqua.
pinna dorsale
pinna caudale

pinna anale
linea laterale
pinna pettorale
pinna ventrale
Nei pesci la fecondazione è esterna: le uova sono fecondate dagli spermatozoi sparsi che il maschio libera all’esterno del corpo della femmina. La maggior parte dei pesci è ovipara e le uova sono avvolte in un involucro gelatinoso 6 . Esistono tuttavia alcune specie di squali e torpedini che sono vivipare. Squali, razze e torpedini sono pesci cartilaginei: hanno la bocca ventrale, la pinna caudale divisa in due parti disuguali e le scaglie sono dentellate per favorire il movimento nell’acqua.
Durante la respirazione, l’acqua entra attraverso gli spiracoli, particolari aperture poste vicino agli occhi, e fuoriesce dalle fessure branchiali, che si aprono direttamente all’esterno.
Salmoni, trote e gran parte dei pesci marini sono pesci ossei: la bocca è terminale e la pinna caudale è divisa in due parti uguali. Inoltre, i pesci ossei possiedono la vescica natatoria, una sacca piena di gas che permette ai pesci di regolare il galleggiamento: riempiendola di gas, il pesce si sposta verso la superficie; svuotandola, scende verso il fondo.
Durante la respirazione, l’acqua entra dalla bocca ed esce dalle fessure branchiali, che sono coperte da una specie di coperchio, l’opercolo, che i pesci cartilaginei non hanno.
FISSA I CONTENUTI ESSENZIALI
Segna con una crocetta se vero (V) o falso (F).
1. La principale caratteristica dei cordati è la presenza della corda dorsale.
2. I cordati più antichi sono gli urocordati.
3. Tutti i vertebrati hanno simmetria raggiata.
4. La maggior parte dei pesci respira attraverso i polmoni.
5. Tutti i pesci possiedono la vescica natatoria.
VERSO LE COMPETENZE
Spiega il significato dei termini evidenziati nel brano.
6 Il gattuccio è una specie di squalo che depone le uova e le àncora ai rami delle gorgonie.

«Nei pesci la fecondazione è esterna: le uova sono fecondate dagli spermatozoi sparsi che il maschio libera all’esterno del corpo della femmina. La maggior parte dei pesci è ovipara e le uova sono avvolte in un involucro gelatinoso. Alcuni pesci, come gli squali e le torpedini, sono vivipari».
5 Pinne con diverse funzioni.
Gli anfibi e i rettili lezione 2
CARTA PENNA COMPUTER

La ricerca di Hasler


1 Il ciclo vitale della rana.
1. La femmina depone nell’acqua molte uova microscopiche protette da un involucro gelatinoso.
Esplora la galleria di immagini e scrivi le risposte sul quaderno.

Pesci fuor d’acqua
1. Spiega perché è stato dato il titolo “Pesci fuor d’acqua”.
2. Quali soluzioni hanno adottato gli animali descritti per poter respirare anche fuori dall’acqua?
3. Quali sono le caratteristiche del pesce di terra? Che cosa lo differenzia dal saltatore del fango?
4. Quali pesci hanno sviluppato polmoni primitivi?
5. Perché alcuni pesci possono spiegare in che modo gli anfibi discendono dai pesci?
1 Gli anfibi
Rane, rospi, tritoni e salamandre appartengono alla classe degli anfibi. Questo termine, che significa “doppia vita”, specifica che il ciclo vitale degli anfibi attraversa due diverse fasi: la prima in acqua, la seconda sulla terraferma 1 . Le uova vengono deposte e fecondate nell’acqua, dove i giovani anfibi vivono fino a quando diventano adulti. Solo allora escono dall’acqua per vivere sulla terraferma, ma restano sempre in zone umide, in prossimità di fiumi, laghi e stagni.
2. Alla schiusa delle uova, fuoriescono piccole larve simili a pesci, i girini.

4. I girini subiscono una lunga metamorfosi: la coda si accorcia, si modifica la forma del corpo, si sviluppano le zampe e i polmoni
3. I girini vivono per tre mesi nell’acqua, respirando con le branchie, nuotando per mezzo dei movimenti della coda e cibandosi di alghe e di piccoli crostacei.
Gli anfibi si riproducono sessualmente e sono ovipari; depongono nell’acqua una grande quantità di uova che vengono fecondate all’esterno del corpo della femmina. Sono animali eterotermi. D’inverno, quando le temperature si abbassano, molte specie di anfibi scavano buche nel terreno, vicino ai corsi d’acqua, e lì si riparano entrando in uno stato di ibernazione, durante il quale le funzioni vitali sono ridotte al minimo. Il corpo degli anfibi è rivestito da una pelle sottile e nuda, cioè priva di formazioni cornee protettive, ma tenuta costantemente viscida dal muco prodotto dalle ghiandole. La respirazione è sia polmonare sia cutanea. Il muco della pelle, infatti, trattiene l’acqua dalla quale gli animali ricavano l’ossigeno 2 .
polmoni
polmoni
colonna vertebrale
cuore
cuore

stomaco

intestino
stomaco
intestino
polmone
colonna vertebrale



2 Come è fatto un anfibio.

polmone
gonade rene vescica


gonade rene

vescica
Gli anfibi possiedono quattro zampe; quelle posteriori hanno dita palmate, cioè unite tra loro da membrane di pelle che facilitano il nuoto.







cuore con 3 cavit




tessuti

cuore con 3 cavità a b c



tessuti



Gli anfibi sono classificati in tre ordini: gli anuri (senza coda), che comprendono le rane, le raganelle e i rospi 3 a ; gli urodeli (con coda), che comprendono le salamandre e i tritoni 3 b ; gli apodi (senza le zampe), che comprendono le cecilie 3 c

Gli anfibi hanno il cuore diviso in tre cavità: due atri e un ventricolo. La circolazione sanguigna è doppia (il sangue passa due volte nel cuore) e incompleta (il sangue ossigenato proveniente dai polmoni e quello ricco di anidride carbonica proveniente dal resto del corpo si mescolano tra loro nel ventricolo).
3 Gli ordini degli anfibi.

4 Come è fatto un rettile.
cer vello
2 I rettili
I rettili sono stati i primi vertebrati terrestri a svincolarsi completamente dall’acqua grazie ad alcune caratteristiche che li rendono particolarmente adatti a vivere sulla terraferma 4 .
polmoni
cer vello
colonna vertebrale gonade stomaco
rene


rene cuore polmone
colonna vertebrale intestino fegato gonade stomaco



La respirazione avviene attraverso i polmoni. La circolazione del sangue è doppia e, nella maggior parte delle specie, incompleta. Il cuore presenta tre cavità (due atri e un ventricolo) in cui il sangue ricco di ossigeno si mescola con quello carico di anidride carbonica. Solo nei coccodrilli il cuore ha due ventricoli e la circolazione è completa.
5 L’uovo dei rettili.
polmoni






cuore con 3 cavità









cuore con 3 cavità


tessuti




La pelle è protetta, a seconda delle specie, da squame cornee, da placche o dal carapace, un guscio osseo. Tutte queste strutture impediscono un’eccessiva perdita di acqua (disidratazione) e proteggono l’animale quando si muove sulle superfici ruvide, come la sabbia e le rocce.
La locomozione di molti rettili, come coccodrilli, lucertole e tartarughe, è resa possibile da due paia di zampe, che permettono agli animali di muoversi anche sui terreni più difficili: sono piuttosto corte, inserite ai lati del corpo e con le dita rivolte verso l’esterno. Altri rettili, come i serpenti, non possiedono zampe ma si muovono strisciando sul terreno.
albume
tuorlo sacco amniotico embrione allantoide guscio camera d’aria
In tutti i rettili la fecondazione è interna e questo costituisce un vantaggio per la vita terrestre in quanto l’uovo fecondato rimane protetto all’interno del corpo materno.
Le uova sono deposte direttamente a terra perché possiedono un guscio membranoso, resistente e flessibile, che impedisce loro di essiccarsi ma che lascia passare l’aria necessaria alla respirazione dell’embrione. Generalmente i rettili non covano e le uova si schiudono al calore del Sole. Le uova dei rettili contengono il tuorlo, composto da una grande quantità di sostanze nutritive necessarie allo sviluppo dell’embrione. Sono, inoltre, uova amniotiche perché al loro interno si forma una specie di sacco, il sacco amniotico, ripieno di liquido, dove l’embrione si accresce nutrendosi delle sostanze nutritive del tuorlo. Le sostanze di rifiuto sono raccolte in un altro sacco, l’allantoide, ed eliminate 5
Fu proprio grazie alle caratteristiche delle loro uova che i rettili del Mesozoico, tra cui i famosi dinosauri, poterono diventare i dominatori indiscussi della Terra per oltre 100 milioni di anni.
Anche i rettili, come gli anfibi, sono eterotermi; si nascondono nella sabbia o sotto i sassi quando fa molto caldo e vanno in ibernazione durante l’inverno.
La classe dei rettili è divisa in tre ordini:
• i cheloni sono rettili protetti da un guscio osseo, il il quale ritirano la testa e gli arti in caso di pericolo; comprendono le testuggini (terrestri) e le tartarughe (acquatiche)

• gli squamati sono rettili con il corpo coperto da squame; comprendono le lucerto le, i ramarri e i serpenti 6 b
• i loricati, parola che significa “armatura”, hanno il corpo coperto da placche cornee che formano una specie di corazza: comprendono i coccodrilli e gli alligatori
È vero che il coccodrillo piange quando divora la sua preda?
L’espressione “piangere lacrime di coccodrillo” si usa per descrivere l’atteggiamento di una persona che finge di provare dispiacere per un’azione commessa. In realtà i coccodrilli non piangono per questa ragione, ma a causa di un fenomeno fisiologico. Quando masticano la preda e sforzano la mascella, comprimono le ghiandole lacrimali vicino agli occhi, stimolando la produzione di lacrime che non hanno nulla a che fare con un sentimento di tristezza o di pentimento per l’atto predatorio.

SCIENZA

FISSA I CONTENUTI ESSENZIALI
Completa le frasi con i termini corretti.
1. Rane, rospi, tritoni e salamandre appartengono alla classe degli . 2. Il termine “anfibio” significa “doppia ”, perché il ciclo vitale degli anfibi attraversa due diverse fasi: la prima in acqua, la seconda sulla terraferma.
3. Gli anfibi sono : le uova sono deposte nell’acqua, dove vengono fecondate.
4. Le uova dei rettili sono deposte direttamente a terra perché possiedono un , resistente e flessibile, che impedisce loro di essiccarsi.
6 Gli ordini dei rettili. b a
Gli uccelli lezione 3
Guarda il video e scrivi le risposte sul quaderno.
CARTA PENNA COMPUTER

Dai dinosauri agli uccelli
1. Quale straordinario fossile è stato ritrovato nel 1861 nei pressi di Solnhofen, in Germania?
2. Archaeopteryx era in grado di volare attivamente?
Da che cosa lo si può dedurre?
3. Quale processo ha favorito la comparsa degli uccelli?
4. Perché si ritiene che gli uccelli discendano dai dinosauri?
ORA FERMA L’IMMAGINE!
Metti in pausa il video nei seguenti punti.


5. Scrivi un breve testo che metta a confronto le caratteristiche dell’Archaeopteryx e del pappagallo.
1 Gli uccelli, vertebrati adatti al volo
Gli uccelli si distinguono da tutti gli altri vertebrati per la loro capacità di volare, grazie alla quale hanno potuto occupare nuovi ambienti di vita.
1
Strategie per il volo.
Lo scheletro è molto leggero, formato da ossa robuste, ma cave all’interno e piene d’aria.
Il cranio piccolo, con la bocca munita di becco, contribuisce alla forma aerodinamica del corpo.
I movimenti delle ali sono resi possibili da muscoli molto robusti, inseriti su una cresta ossea che sporge dallo sterno, la carena
La struttura corporea aerodinamica, adatta a fendere l’aria, rende gli uccelli partico larmente adatti al volo 1


ala penne remiganti
carena muscoli per il volo
penne timoniere

I sacchi aerei diramazioni dei polmoni, si insinuano nelle ossa cave e alleggeriscono ulteriormente il corpo.

Gli arti anteriori sono trasformati in la loro superficie è resa più ampia dalla presenza delle penne. Le grandi penne delle ali sono chiamate remiganti perché battono l’aria durante il volo come i remi di una barca. Le penne timoniere che ricoprono la coda servono a dare la direzione.
Per mantenere caldo il corpo, occorre anche limitare la quantità di calore che viene disperso: a questo provvedono le piume, morbide e flessibili, che ricoprono il corpo funzionando da isolante termico.
Anche le penne contribuiscono a ridurre la dispersione del calore ma hanno una funzione preminente nel volo. Le penne sono costituite da una parte infissa nella cute, il calamo, da una parte esterna formata dal rachide, che è la continuazione del calamo, e dal vessillo, che si diparte ai due lati del rachide 2
Il vessillo è a sua volta formato da filamenti via via più sottili, chiamati barbe e barbule. Le barbule si dipartono ai lati delle barbe e in molte specie presentano, nel tratto terminale, dei piccoli uncini con i quali si agganciano tra di loro rendendo il vessillo più compatto e le penne più aerodinamiche.
Per volare gli uccelli hanno bisogno di una grande quantità di energia: per questa ragione il sistema respiratorio e quello circolatorio devono essere molto efficienti 3
3
Come è fatto un uccello.
esofago
ingluvie
fegato

pancreas
intestino cloaca ventriglio


polmoni
2 Le parti della penna.



cuore con 4 cavità
tessuti
La circolazione del sangue è doppia e completa; il cuore è suddiviso in due atri e due ventricoli e il sangue vi transita due volte. In questo modo il sangue ricco di ossigeno che arriva dai polmoni non si mescola mai con quello carico di anidride carbonica che proviene da tutti i tessuti del corpo.
È vero che gli uccelli cantano soprattutto al mattino?
Dagli studi fatti sul canto degli uccelli emerge che prediligono il mattino per dare prova della loro forma fisica. Gli uccelli diurni, infatti, si nutrono durante il giorno e, di conseguenza, al mattino sono più deboli. Cantare all’alba è quindi una tecnica utilizzata dai maschi per dimostrare alle femmine di essere sani e pieni di energia già dal mattino.


vessillo
rachide
calamo
4 Cova di un uovo e nutrimento dei piccoli in due specie di uccelli.


Gli uccelli respirano con i polmoni, ma la loro capacità respiratoria è potenziata dai sacchi aerei dentro i quali si accumula dell’aria aggiuntiva.
L’elevata quantità di calore prodotto dal metabolismo viene conservata dall’organismo. Gli uccelli, infatti, sono animali omeotermi, o a “sangue caldo”: la temperatura del loro corpo si mantiene costante su valori compresi tra 40 e 43 °C, indipendentemente dalle condizioni ambientali.
Per afferrare e introdurre il cibo gli uccelli usano il becco, che ha una forma e dimensioni particolarmente adatte al tipo di alimentazione. L’apparato digerente degli uccelli presenta degli aspetti particolari. Il becco è privo di denti e, pertanto, il cibo non può essere triturato e sminuzzato in bocca; a ciò provvedono due strutture dell’apparato digerente, l’ingluvie e il ventriglio. L’ingluvie, o gozzo, è un’ampia dilatazione dell’esofago, dove il cibo viene immagazzinato e inumidito dai succhi gastrici.
Dall’ingluvie il cibo passa nello stomaco e nel ventriglio, un sacco muscolare che contiene dei piccoli sassi inghiottiti dall’uccello. Quando le sue pareti si contraggono, i sassi schiacciano il cibo che passa successivamente nell’intestino.
L’intestino termina con la cloaca, un’apertura in comune con gli apparati escretore e riproduttore.
Gli uccelli sono ovipari e l’uovo è amniotico, come quello dei rettili. Dopo la fecondazione, che è interna, la femmina depone le uova in un nido e le cova con il calore del corpo: infatti gli embrioni, che sono a “sangue caldo”, morirebbero se la temperatura scendesse eccessivamente 4 .
La costruzione di un nido e la cova fanno parte delle cure parentali tipiche degli uccelli. Nella maggior parte dei casi questi animali si prendono cura dei loro piccoli anche dopo la nascita: li sfamano, li proteggono, insegnano loro il volo e tutti quei comportamenti indispensabili per la sopravvivenza 5
La comunicazione con i propri simili è possibile grazie al canto, una caratteristica tipica degli uccelli. L’emissione dei suoni avviene grazie alla siringe, un organo che si trova all’estremità inferiore della trachea e che funziona come la cassa di risonanza di uno strumento musicale.
5 Un esemplare femmina di cigno con i suoi piccoli.

FISSA I CONTENUTI ESSENZIALI
Abbina i termini con la definizione corretta.
1 Piume
2 Amniotico
3 Sacchi aerei
4 Remiganti
5 Ingluvie
a Ampia dilatazione dell’esofago dove il cibo immagazzinato è inumidito dai succhi gastrici.
b Grandi penne delle ali che battono l’aria durante il volo.
c Diramazioni dei polmoni che si trovano nelle ossa cave.
d Contribuiscono alla termoregolazione.
e Uovo dotato di un sacco interno dove si sviluppa l’embrione.
1: 2: 3: 4: 5:
VERSO LE COMPETENZE
Le immagini rappresentano il becco di un’aquila, di un’anatra e di un colibrì. Analizza la loro forma, descrivila e prova ad attribuire a ognuno di questi uccelli il tipo di alimento di cui si nutre tra quelli sotto rappresentati.






1: 2: 3:
CARTA PENNA COMPUTER

Gli arti dei mammiferi
I mammiferi
Esplora l’oggetto interattivo e scrivi le risposte sul quaderno.
1. Quali sono le caratteristiche degli arti dei mammiferi? Hanno tutti lo stesso numero di dita?
2. Perché all’interno della classe dei mammiferi si osservano arti dall’aspetto così diverso?
3. Quali tra i mammiferi terrestri hanno gli arti meglio adattati alla corsa?
4. Perché gli arti anteriori dei cetacei assomigliano nell’aspetto alle pinne pettorali dei pesci?
5. Quali sono gli unici mammiferi capaci di volo attivo? Come si sono adattati i loro arti anteriori?
6. Quali mammiferi hanno un arto simile alla nostra mano?
1
ORA FERMA L’IMMAGINE!
Scrivi un breve testo a commento dell’immagine e spiega il significato di “pollice opponibile”.


Perché si chiamano mammiferi
sono una classe di vertebrati diffusi in quasi tutti gli ambienti della Terra, in prevalenza terrestri; i pipistrelli hanno conquistato l’ambiente aereo; le balene, i delfini e altri, quel-
La principale caratteristica dei mammiferi è la presenza ghiandole mammarie, che nelle femmine producono , una soluzione ricca di zuccheri, grassi e proteine, con cui vengono nutriti i cuccioli. Il termine mammifero significa proprio “portatori di mammelle”. Oltre ad allattarli, i mammiferi dedicano molto più tempo degli altri animali alla cura, alla protezione e all’educazione dei piccoli. In questo modo i genitori trasmettono alla prole conoscenze e abilità necessarie per la loro sopravvivenza 1 .

Specie a rischio di estinzione
1 La cura dei cuccioli.
2 Le caratteristiche dei mammiferi
I mammiferi sono animali omeotermi: la loro temperatura corporea si mantiene costante intorno ai 36-40 °C.
In base al loro ambiente di vita, la pelle dei mammiferi presenta caratteristiche differenti. Gli orsi sono coperti da peli che formano una vera e propria pelliccia che funziona da isolante termico e permette loro di adattarsi anche ai climi più rigidi 2 a ; rinoceronti ed elefanti hanno la pelle coperta da peli radi o da peluria 2 b ; nell’istrice, nel riccio e nell’echidna i peli sono trasformati in aculei e sono uno strumento di difesa 2 c ; delfini e balene sono completamente privi di peli per meglio adattarsi alla vita nell’acqua 2 d
La pelle è anche ricca di ghiandole sudoripare che producono il sudore, una soluzione acquosa: quando la temperatura esterna è elevata, il sudore evapora disperdendo il calore del corpo all’esterno.
Lo scheletro comprende il tronco, quattro arti e il capo, costituito da un cranio che protegge un cervello piuttosto voluminoso.
Ma i cani e i gatti non sudano?
La sudorazione è un meccanismo utilizzato da diversi animali per abbassare la temperatura corporea in ambienti caldi o durante l’attività fisica. Come noi sudano, per esempio, i cavalli, ma anche cani e gatti che, tuttavia, possiedono poche ghiandole sudoripare poste nel naso e sotto i cuscinetti planari delle zampe. Per ovviare al problema, quando fa caldo, cani e gatti ansimano, cioè respirano a bocca aperta per disperdere il calore in eccesso accumulato dal corpo; anche la dilatazione dei vasi sanguigni a livello delle orecchie e del muso contribuisce ad abbassare la temperatura corporea.
Il sistema nervoso è molto sviluppato, superiore per capacità a quello di qualsiasi altro vertebrato: lo strato superficiale del cervello, la cor teccia cerebrale, presenta dei ripiegamenti, detti circonvoluzioni, che sono la sede del ragionamento e dell’apprendimento.
SCIENZA CHE

Gli arti sono molto diversificati, secondo le abitudini di vita e l’ambiente in cui gli animali vivono; sono dotati di 4-5 dita, a volte trasformate in zoccolo o provviste di artigli.


2 Il rivestimento dei mammiferi.


3 L’apparato digerente dei ruminanti.
Mucche, pecore, giraffe, cervi brucano una grande quantità di erba, che ingoiano senza masticarla. Il cibo si accumula nel rumine, una specie di sacca dello stomaco; passa poi nel reticolo, dove viene ridotto a una massa pastosa. Quando l’approvvigionamento è sufficiente, gli erbivori richiamano l’erba alla bocca e la triturano con i denti molari. Successivamente ingoiano nuovamente il cibo, che passa in altre due sacche, l’omaso e l’abomaso, dove viene completamente digerito.

esofago
4 Appena nati gli agnelli sono in grado di reggersi sulle zampe e di alimentarsi.

omaso


reticolo
intestino

L’apparato digerente è formato da esofago, stomaco e intestino; nei mammiferi erbivori ruminanti lo stomaco è diviso in quattro sacche per digerire la cellulosa 3 Il tipo di dentatura dei mammiferi è in relazione con il tipo di dieta. A differenza degli altri vertebrati che hanno denti tutti uguali, i mammiferi possiedono quattro tipi di denti: gli incisivi, per spezzare i cibi più duri, i canini, per incidere e strappare, i premolari e i molari per triturare il cibo.
La circolazione sanguigna è doppia e completa; il cuore è diviso in quattro cavità (due atri e due ventricoli) come negli uccelli.
La respirazione avviene attraverso i polmoni. La funzione respiratoria è migliorata dall’azione di un muscolo, il diaframma, che alzandosi e abbassandosi facilita l’ingresso dell’aria nei polmoni e la successiva espulsione. Il diaframma divide in due parti la cavità del corpo: nella cavità toracica sono contenuti il cuore e i polmoni, mentre nella cavità addominale sono collocati gli altri organi.
Quasi tutti i mammiferi sono vivipari, cioè partoriscono piccoli già formati. La fecondazione è interna: la femmina produce una cellula uovo molto piccola che, una volta fecondata, si annida in un particolare organo, l’utero
All’interno dell’utero l’embrione si sviluppa e cresce; esso è nutrito direttamente dal sangue materno attraverso una membrana che lo circonda, la placenta. Dopo la gestazione, che ha una durata di tempo diversa nelle differenti specie, la madre partorisce il piccolo a un livello di sviluppo molto avanzato 4
3 I mammiferi si dividono in tre gruppi
I mammiferi si dividono in tre sottoclassi:
• i monotremi sono i mammiferi più primitivi. Sono ovipari, ma allattano i piccoli. Il latte fuoriesce dallo sbocco delle ghiandole mammarie e cola lungo un ciuffo di peli, che i cuccioli leccano. Non hanno denti e possiedono un becco corneo. Gli unici rappresentanti dei monotremi vivono in Australia e sono l’ornitorinco 5 a e l’echidna;
rumine
abomaso
bocca
• i marsupiali sono vivipari, ma la gravidanza è molto breve, cosicché i piccoli nascono immaturi e proseguono lo sviluppo nel marsupio, una tasca sulla pancia della madre. Comprendono animali come il canguro 5 b e il koala;
• i placentati comprendono la maggior parte dei mammiferi. Sono tutti vivipari e l’embrione completa il suo sviluppo nell’utero della madre, avvolto dalla placenta, come il cavallo 5 c .


b c

FISSA I CONTENUTI ESSENZIALI
Segna con una crocetta se vero (V) o falso (F).
5 Le sottoclassi dei mammiferi.
COMPITO DI REALTÀ
4 OTTOBRE: GIORNATA
MONDIALE DEGLI ANIMALI
1. La pelle dei mammiferi ha una copertura differente in funzione dell’ambiente di vita.
2. L’omaso è un organo tipico dei carnivori.
3. La circolazione sanguigna dei mammiferi è doppia e completa.
4. I monotremi sono ovipari.
VERSO LE COMPETENZE
Forma e dimensioni dei denti dei mammiferi forniscono informazioni sul modo di nutrirsi degli animali. Osserva le foto dei tre mammiferi e attribuisci a ciascun animale la sua dentatura.

Il castoro si nutre di piante legnose e con i suoi denti può abbattere alberi. La sua dentatura corrisponde alla lettera


Il leone è un predatore in cima alla catena alimentare della savana. La sua dentatura corrisponde alla lettera


Il cervo si nutre di erbe, foglie e germogli.
La sua dentatura corrisponde alla lettera

SKILL BOOK
VISUAL mammiferi placentati Gli ordini dei

I mammiferi sono raggruppati in numerosi ordini a seconda del tipo di alimentazione, della dentatura e delle caratteristiche degli arti.

CHIROTTERI
Sono in grado di volare grazie alla presenza di una membrana di pelle (il patagio) sugli arti anteriori. Sono predatori notturni ed emettono ultrasuoni per localizzare le prede. Comprendono i pipistrelli.
INSETTIVORI
Sono i placentati più primitivi. Si nutrono di insetti e altri piccoli invertebrati. Comprendono animali come la talpa, il toporagno e i ricci.


LAGOMORFI
Hanno denti incisivi molto robusti e lunghi a crescita continua. Il labbro superiore è diviso in due. Il pelo cambia colore a seconda della stagione invernale o estiva. Comprendono il coniglio e le lepri.

SDENTATI
RODITORI
Hanno denti incisivi robusti, ma non hanno i canini. Il loro corpo è ricoperto da pelo (come il topo, lo scoiattolo o i castori) oppure da aculei (come l’istrice).

Hanno una dentatura ridotta. Sono ricoperti da una corazza (come l’armadillo) oppure da peli (come il formichiere).

ARTIODATTILI
Hanno zampe con quattro dita e camminano appoggiando al suolo la punta del terzo e del quarto dito, trasformati in zoccolo. Comprendono la mucca, la pecora, il cammello, la giraffa, la gazzella e l’ippopotamo.
CARNIVORI
Hanno denti canini grossi e appuntiti con cui lacerano la carne, ma incisivi poco sviluppati. Sono carnivori il cane, il gatto, la tigre, il leone; alcuni sono adattati al nuoto, come il tricheco e la foca.
PERISSODATTILI
Camminano poggiando al suolo la punta delle dita (che sono tre) trasformate in zoccolo. Comprendono il cavallo, l’asino, la zebra, il tapiro e il rinoceronte.

PRIMATI
Sono i mammiferi più evoluti, con un cervello molto sviluppato. Hanno arti prensili, alcuni con il pollice opponibile. Sono primati le scimmie e l’uomo.
PROBOSCIDATI
Hanno una lunga proboscide, formata dal labbro superiore e dal naso. Gli incisivi superiori sono trasformati in zanne. Comprendono solo gli elefanti.


CETACEI
Sono mammiferi adattati al nuoto: hanno forma idrodinamica e arti anteriori trasformati in pinne. Alcuni hanno i fanoni, denti sottili e fitti con i quali filtrano l’acqua per trattenere i piccoli organismi di cui si cibano. Comprendono la balena, il capodoglio, l’orca e il delfino.



CON LA SINTESI
lezione 1 I PESCI
I cordati sono gli animali dotati di una struttura di sostegno del corpo, la corda. Tutti i cordati hanno simmetria bilaterale e possiedono il tubo neurale, cioè un cordone di tessuto nervoso che nella testa si dilata a formare il cervello. I cordati si dividono in urocordati, come le ascidie, cefalocordati, come l’anfiosso, e vertebrati. I vertebrati possiedono la colonna vertebrale, la struttura scheletrica interna al corpo che sostiene l’organismo e permette i movimenti. Lo scheletro dei vertebrati è formato dal tessuto osseo rigido e dal tessuto cartilagineo, meno rigido ma più flessibile. La superficie del corpo è protetta dalla pelle e da strutture protettive che si differenziano nei diversi vertebrati. I pesci sono animali esclusivamente acquatici. Sono classificati in pesci cartilaginei, come gli squali, e pesci ossei, come le trote. I pesci si muovono grazie alle pinne; il loro corpo ha una forma idrodinamica e la loro superficie è coperta di scaglie che favoriscono lo scorrimento dell’acqua. I pesci ossei possiedono l’organo della linea laterale, che permette loro di orientarsi e catturare le prede. La respirazione avviene attraverso le branchie. La maggior parte dei pesci è ovipara ma esistono alcune specie di squali e torpedini che sono vivipare

lezione 2 GLI ANFIBI E I RETTILI
Il termine anfibio significa “dalla doppia vita”: gli anfibi, infatti, nascono e vivono la prima parte della loro vita nell’acqua ma, da adulti, possono vivere anche sulla terraferma. In acqua respirano con le branchie e da adulti attraverso i polmoni e la pelle. Gli anfibi sono classificati in tre ordini: gli anuri, come rane e rospi, che non hanno la coda; gli urodeli, come le salamandre e i tritoni, che hanno la coda; gli apodi, come le cecilie, che non hanno gli arti. I rettili sono animali terrestri che respirano attraverso i polmoni. Le uova dei rettili sono protette all’esterno da un guscio membranoso; all’interno è presente il tuorlo, ricco di sostanze nutritive per l’embrione, e il sacco amniotico, una struttura ripiena di liquido che protegge l’embrione. Anfibi e rettili hanno la circolazione del sangue doppia e incompleta. I rettili sono suddivisi in tre ordini: i cheloni, come le tartarughe, che possiedono un guscio osseo esterno; gli squamati, come le lucertole, che hanno il corpo coperto da squame; i loricati, come i coccodrilli, che sono ricoperti da placche ossee.


lezione 3 GLI UCCELLI
Gli uccelli sono i vertebrati specializzati nel volo. Lo scheletro è formato da ossa cave e gli arti anteriori sono trasformati in ali ricoperte da penne. I movimenti delle ali sono possibili grazie a muscoli robusti che si inseriscono sulla carena. Gli uccelli respirano con i polmoni e hanno la circolazione del sangue doppia e completa; mantengono costante la temperatura del corpo grazie alle penne e alle piume. Il becco non ha denti e ha forma e dimensione che dipendono dal tipo di alimentazione; l’apparato digerente è formato dall’ingluvie, in cui si accumula il cibo, e dal ventriglio, un sacco muscolare che contiene dei piccoli sassi che servono a triturare il cibo. Il canto avviene grazie alla siringe, un organo che si trova all’estremità inferiore della trachea. Gli uccelli sono ovipari: la femmina depone le uova in un nido e accudisce i piccoli anche dopo la nascita.
lezione 4 I MAMMIFERI
I mammiferi sono animali che allattano: le femmine possiedono le ghiandole mammarie che producono il latte con cui vengono alimentati i piccoli. I mammiferi sono animali omeotermi, cioè la loro temperatura corporea resta costante tra 36-40 °C: se la temperatura è elevata, le ghiandole sudoripare producono il sudore che disperde il calore. I mammiferi possiedono arti diversificati in base all’ambiente e alle loro abitudini di vita.
Nel capo si trova il cranio, una struttura ossea che protegge il cervello.
L’apparato digerente è formato da esofago, stomaco e intestino; nei mammiferi erbivori ruminanti lo stomaco è diviso in quattro sacche. A differenza degli altri vertebrati, i mammiferi possiedono quattro tipi di denti: gli incisivi, i canini, i premolari e i molari. La circolazione sanguigna è doppia e completa; il cuore è diviso in quattro cavità. I mammiferi monotremi, come l’ornitorinco e l’echidna, depongono le uova all’interno delle quali si sviluppa l’embrione; i marsupiali, come il koala e il canguro, sono vivipari ma i piccoli completano lo sviluppo nel marsupio della madre; i placentati, che sono la maggior parte dei mammiferi, partoriscono piccoli già formati perché completano il loro sviluppo nell’utero della madre protetti dalla placenta


CON LA MAPPA
Adesso che hai ripassato i contenuti essenziali con la sintesi, prova a completare la mappa con le parole chiave suggerite e a trovare le definizioni corrispondenti.
anfibi - cordati - mammiferi - omeotermi - pesci - piume - uccelli
se mantengono costante la temperatura del corpo
appartengono al
se non sono in grado di regolare la temperatura del corpo
come

come


hanno
a. Ricoprono la pelle dei pesci.
b. Serie di trasformazioni che portano alla nascita di un adulto da un girino.
c. Hanno permesso ai rettili di conquistare la terraferma.
d. Comprende gli animali dotati di una struttura di sostegno.
e. Secernono il latte per la nutrizione dei cuccioli.
possono essere
1. I VERTEBRATI
che depongono
7. rettili
12. uova amniotiche
3. eterotermi
dotati di
14. ghiandole mammarie
9.
4.
2. phylum dei
che
la pelle ricoperta di
10. scaglie 5.
che subiscono una
11. metamorfosi
6.
dotati di
13. penne e
FISSA I CONTENUTI
lezione 1 I PESCI
1 Segna con una crocetta se vero (V) o falso (F).
a. Tutti i pesci appartengono al phylum dei mammiferi.
b. Tutti i cordati hanno simmetria raggiata e possiedono un tubo neurale.
c. Gli urocordati sono i cordati più primitivi.
d. Nei cefalocordati la corda dorsale si estende per tutta la lunghezza del corpo e rimane per tutta la vita.
2 Scegli la soluzione corretta.
a. Nei vertebrati lo scheletro è formato da due tipi di tessuti:
1 osseo e cartilagineo.
2 cartilagineo e muscolare.
3 osseo e connettivo.
4 osseo e nervoso.
b. Nei vertebrati la superficie del corpo è protetta:
1 dal sangue.
2 dallo scheletro.
3 dalla cartilagine.
4 dalla pelle.
c. L’apparato circolatorio dei pesci è di tipo:
1 chiuso doppio.
2 chiuso semplice.
3 aperto semplice.
4 aperto doppio.
3 Completa le frasi con i termini corretti.
a. I vertebrati acquatici usano le per respirare l’ossigeno disciolto nell’acqua.
b. Pesci, anfibi e rettili sono definiti perché non sono in grado di regolare la temperatura corporea.
c. I pesci ossei possiedono la ben visibile sui fianchi.
d. Nella respirazione dei pesci cartilaginei, l’acqua entra dagli ed esce dalle fessure branchiali.

lezione 2 GLI ANFIBI E I RETTILI
4 Abbina i termini con la definizione corretta.
1. Anuri
2. Metamorfosi
3. Girini
4. Involucro gelatinoso
5. Ibernazione
a Copertura a protezione delle uova degli anfibi.
b Serie di trasformazioni che portano un girino alla vita adulta.
c Stato durante il quale le funzioni vitali sono ridotte al minimo.
d Piccole larve simili a pesci.
e Ordine degli anfibi a cui appartengono rane e rospi.
1. 2. 3. 4. 5.
5 Sottolinea il termine corretto tra i due proposti.
a. Nei rettili la pelle è protetta da squame ossee/cornee, da placche o dal carapace.
b. La fecondazione dei rettili è esterna/interna
c. Le uova dei rettili sono deposte direttamente a terra perché possiedono un guscio membranoso/gelatinoso che le protegge dal disseccamento.
6 Scegli la soluzione corretta.
a. Le testuggini e le tartarughe appartengono all’ordine:
1 dei cheloni.
2 degli squamati.
3 dei loricati.
4 degli anfibi.
b. La circolazione sanguigna dei rettili è:
1 singola.
2 doppia incompleta.
3 doppia completa.
4 semplice e aperta.
7 Osserva il disegno e inserisci accanto a ogni elemento indicato il numero corrispondente.


1. Colonna vertebrale
2. Cervello
3. Cuore
4. Polmone
5. Intestino
lezione 3 GLI UCCELLI
8 Segna con una crocetta se vero (V) o falso (F).
a. Le ossa degli uccelli sono cave e piene d’aria.
b. Negli uccelli gli arti anteriori sono diventati ali.
c. Per afferrare e introdurre il cibo gli uccelli usano il becco.
d. L’ingluvie è un’ampia dilatazione dello stomaco.
e. La costruzione di un nido e la cova fanno parte delle cure parentali tipiche degli uccelli.
9 Osserva il disegno e inserisci accanto a ogni elemento indicato il numero corrispondente.
1. Penne remiganti
2. Penne timoniere
3. Carena
4. Muscoli per il volo
5. Ala



lezione 4 I MAMMIFERI
10 Scegli la soluzione corretta.
a. La principale caratteristica del corpo dei mammiferi è la presenza di:
1 zampe.
2 polmoni.
3 ghiandole mammarie.
4 piume.
b. I mammiferi sono omeotermi perché sono in grado di regolare:
1 la temperatura corporea.
2 la circolazione sanguigna.
3 il battito cardiaco.
4 la struttura scheletrica.
11 Abbina i termini con la definizione corretta.
1. Latte
2. Ghiandole sudoripare
3. Monotremi
4. Marsupiali
5. Placentati
a Producono il sudore.
b Crescono i piccoli alimentandoli in una sacca ventrale.
c Soluzione ricca di zuccheri, grassi e proteine, con cui sono nutriti i cuccioli.
d Il loro embrione completa lo sviluppo nell’utero della madre.
e Mammiferi più antichi attualmente viventi.
1. 2. 3. 4. 5.
12 Sottolinea le parole sbagliate presenti nel brano.
La circolazione sanguigna dei mammiferi è doppia e incompleta; il cuore è diviso in tre cavità come negli uccelli. La respirazione avviene attraverso i sacchi aerei; la funzione respiratoria è migliorata dall’azione di un muscolo, il bicipite, che alzandosi e abbassandosi facilita l’ingresso dell’aria nel corpo.
TRARRE INFORMAZIONI DA
1 Osserva i disegni e rispondi alle domande.
tubo neurale corda

tubo neurale corda
ambientale, dalle reti fantasma, dall’attività di navigazione con navi tecnologicamente avanzate, ma totalmente inadatte a rispettare la vita acquatica.






UROCORDATO
CEFALOCORDATO
VERTEBRATO
a. Qual è la principale differenza tra un urocordato e un cefalocordato?
b. Descrivi la composizione e la struttura della corda dorsale e del tubo neurale.
Il prezioso e delicato ecosistema marino del Mediterraneo vanta la presenza di alcuni dei più amati mammiferi marini: i delfini costieri tursiopi (Tursiops truncatus). Con il progetto “Il Golfo dei Delfini”, gli operatori turistici impegnati nell’attività di dolphin watching vengono inseriti in un network e coinvolti in corsi formativi per lo sviluppo di un turismo naturalistico a basso impatto.
A garanzia del loro impegno, in collaborazione con Friend of the Sea, è rilasciata agli operatori turistici la certificazione di dolphin watching sostenibile che assicura al turista un avvistamento responsabile.
Il risultato è un’offerta turistica educativa, che pone le basi per la creazione di nuove attività ricreative e la destagionalizzazione della domanda turistica.
(Tratto e adattato dal sito di Worldrise)
Rispondi alle domande e svolgi le attività proposte, da solo o in gruppo con i tuoi compagni.
1. Come sono classificati i delfini?
2. Quali sono le principali minacce alla loro sopravvivenza?
3. In che cosa consiste l’attività di dolphin watching?
INTERPRETARE E TRARRE INFORMAZIONI DA UN TESTO
2 Leggi il brano.
IL GOLFO DEI DELFINI
Creare e promuovere nuove forme di sviluppo economico e sociale, basate sulla valorizzazione delle risorse naturali del territorio, in associazione con ricerca scientifica e formazione pratico-professionale è uno dei numerosi obiettivi che si pone l’associazione Worldrise, impegnata da sempre nella conservazione della risorsa marina. I mammiferi marini sono minacciati dalle attività umane a partire dal degrado
4. Che cosa significa, secondo te, “avvistamento responsabile”?
5. Che cos’è la certificazione dolphin watching sostenibile?
6. Perché il turismo ecosostenibile rappresenta una risorsa per il futuro?
DIGITAL SKILLS
Ricerca in rete il sito di Worldrise e quelli di altri enti impegnati nella difesa dell’ambiente nel Mediterraneo. Prepara un’infografica o un altro prodotto digitale che illustri le attività dei soggetti individuati e i loro progetti.
Una seppia gioca a nascondino
26 gennaio 1832, Isole di Capo Verde
Ciao di nuovo! Eccomi qui, in questa splendida località nell’Oceano Atlantico, l’arcipelago di Capo Verde. Sono dieci le isole vulcaniche che formano questo arcipelago. Il signor Darwin sta studiando le creature marine nella zona vicino a Praia, la città principale dell’isola di Santiago. Ci sono un sacco di pesci e di molluschi nel mare limpido e azzurro, e lui mi insegna tutti i loro nomi. Ho imparato a riconoscere l’Aplysia: se la tocchi con un bastone, spruzza intorno a sé un liquido rosso per nascondersi. E se il liquido ti colpisce, irrita la pelle.



Darwin
L’Oceano Atlantico circonda le isole di Capo Verde. L’acqua è molto chiara ed è facile osservare gli organismi marini e i loro comportamenti. C’è un tipo di mollusco molto interessante, l’Aplysia, un gasteropode marino simile a una grossa lumaca priva di guscio. È lunga circa 12 cm ed è di colore giallo con delle strisce viola. Nuota con eleganza tra le alghe che crescono sul fondale marino in acque poco profonde. Quando tocco l’acqua, la lumaca si spaventa e spruzza un po’ di liquido per difendersi. L’acqua diventa tutta rossa! Il liquido è irritante e può bruciare la pelle. È possibile osservare facilmente anche le seppie, molluschi cefalopodi muniti di tentacoli. Le seppie possono muoversi rapidamente nell’acqua limpida e, quando mi vedono, vanno a nascondersi nelle crepe tra le rocce. Per mimetizzarsi tra i fondali marini, le seppie cambiano rapidamente il colore della pelle, dal grigio al giallo brillante, al rosso o al marrone, proprio come i camaleonti, che sono rettili terrestri. Per nascondersi, possono spruzzare nell’acqua un inchiostro marrone scuro. Una seppia mi vede e velocemente si nasconde in un buco, poi spruzza acqua nella mia direzione. Forse vuole giocare a nascondino con me? Credo proprio di sì! Le seppie sono animali vivaci, intelligenti e divertenti.
ORA RACCONTA TU!
a. Che cosa fa Sims quando accompagna Darwin nelle sue uscite?
b. Che tipo di operazione compie Darwin quando riconosce un animale e gli dà il nome scientifico?
c. Descrivi con le tue parole il tipo di rapporto che Darwin instaura con gli animali che osserva.

d. Sims racconta che la mano gli brucia un po’: prova a immaginare che cosa gli può essere accaduto e descrivi la scena dell’incontro tra l’Aplysia e il ragazzo.
DIGITAL SKILLS
Utilizza Google Map per localizzare l’arcipelago di Capo Verde. Elenca i nomi delle isole dell’arcipelago, individua quella in cui si trova la capitale Praia e cerca una descrizione dei monumenti e dei quartieri più caratteristici della città.
Intelligenza Artificiale IA
Con l'aiuto dell’insegnante utilizza un chatbot di intelligenza artificiale per avere informazioni sui molluschi marini descritti da Darwin e indicazioni di siti dove trovare delle fotografie. Ora che possiedi queste informazioni, prova a creare delle schede descrittive di tutte le classi dei molluschi.
UN MODULO MATEMATICO PER LEGGERE LA NATURA

Immagina un modello matematico che metta insieme numeri e forme geometriche e che si può ripetere all’infinito: questa ripetizione è così interessante da poter riprodurre le forme più complesse della natura, come il margine delle foglie, il reticolo idrografico dei fiumi, la forma delle coste, dei cristalli, dei minerali, dei coralli e molto altro ancora. Questo modello esiste e si chiama frattale, una figura fatta di parti che si ripetono, sempre simili tra loro, anche se diventano più piccole o più grandi.
PREREQUISITI
Conoscere i livelli di organizzazione degli organismi unicellulari e pluricellulari.
Conoscere i criteri di classificazione degli organismi.
Saper descrivere le categorie sistematiche con cui sono classificati i viventi.
RISULTATI ATTESI
Comprensione del legame fra matematica e forme naturali.
Comprensione della sequenza di Fibonacci. Conoscenza della sezione aurea.
Capacità di riconoscere le forme che possono essere riprodotte con i frattali.
RACCORDI interdisciplinari
Proponiamo alcuni approfondimenti che possono essere affrontati nel percorso interdisciplinare, ma la mappa suggerisce altri argomenti che possono essere sviluppati per integrare lo stesso percorso.
SCIENZE: forme e strutture vegetali e animali legate alla sequenza di Fibonacci.
MATEMATICA: i principi di base dei frattali.
ARTE: piramidi egizie e templi greci.
GEOGRAFIA: frattali e forme del paesaggio: reticoli idrografici, forma delle coste e delle foci a delta. TECNOLOGIA
CAVOLI, MOLLUSCHI, SEZIONE AUREA
LA SEZIONE AUREA
CHE COS’È LA SEQUENZA DI FIBONACCI?
I RETICOLI IDROGRAFICI, LA FORMA DELLE COSTE, LA FORMA DELLE FOCI A DELTA
LA SEZIONE AUREA NEL PENTAGONO REGOLARE
MATEMATICA
Che cos’è la sequenza di Fibonacci?
SCIENZE
Cavoli, molluschi e sezione aurea
Il cavolo romano, il Nautilus e molti altri viventi, o parti di essi, mostrano forme che si ripetono con regolarità e proporzione, seguendo schemi geometrici che la natura utilizza per far crescere in modo efficiente gli organismi. Consideriamo, per esempio, il cavolo romanesco, un’infiorescenza che si sviluppa secondo una struttura a spirale: ogni cimetta è una copia in miniatura dell’intero cavolo. Questa ripetizione a scale diverse di una struttura è una caratteristica tipica di particolari figure geometriche chiamate frattali. Osservando il cavolo ancora più attentamente, possiamo notare spirali con andamento in senso orario e antiorario, una disposizione che segue la sequenza di Fibonacci, un modello matematico ricorrente in molte forme naturali.

Immagina di avere una fila di numeri che inizia così: 1, 1, 2, 3, 5, 8, 13, 21, 34, 55… Ti accorgi di qualcosa? Ogni numero, a partire dal terzo, è la somma dei due numeri precedenti: 1 + 1 = 2, 1 + 2 = 3, 2 + 3 = 5, 3 + 5 = 8 e così via. Questa è la sequenza di Fibonacci, chiamata così in onore di Leonardo Fibonacci, un matematico italiano vissuto circa 800 anni fa. La sequenza può essere descritta con una semplice regola: F(1) = 1, F(2) = 1 e, per ogni numero successivo, F(n) = F(n−1) + F(n−2). È come un domino di numeri che cresce sommando sempre gli ultimi due. La cosa più affascinante è che la sequenza di Fibonacci non appartiene solo alla matematica, ma si trova ovunque in natura. Molti fiori hanno un numero di petali che corrisponde a un numero di Fibonacci, come 3, 5, 8 o 13. Nelle pigne e nei girasoli, i semi o le scaglie si dispongono in spirali che seguono la stessa sequenza. Anche le conchiglie, come quella del Nautilus, crescono formando una spirale aurea, legata proprio ai numeri di Fibonacci. Perfino le foglie sui rami spesso si dispongono seguendo la sequenza di Fibonacci, in modo da ricevere più luce possibile.
DOMANDE GUIDA
a. Che cosa ti colpisce della regola con cui si forma la sequenza di Fibonacci?
b. Perché secondo te questa sequenza è considerata così speciale nella matematica e nella natura?
c. In che modo la regola “ogni numero è la somma dei due precedenti” può ricordare un ciclo o una crescita naturale?
d. Se potessi osservare da vicino un oggetto naturale, come proveresti a scoprire se segue la sequenza di Fibonacci?
LAB
STEM
a. Osserva diversi fiori (margherite, gigli, rose, girasoli) e conta i petali. Segna su un quaderno se il numero dei petali è un numero della sequenza (1, 2, 3, 5, 8, 13, 21…). Quali fiori rispettano la sequenza?
b. Prendi una pigna o una conchiglia e osserva le spirali: prova a contare quante vanno in una direzione e quante nell’altra. I numeri che ottieni appartengono alla sequenza di Fibonacci.
Anche la conchiglia del Nautilus, un mollusco cefalopode che vive nelle profondità degli oceani, mostra una crescita basata sullo stesso principio. La sua conchiglia è formata da camere disposte lungo una spirale logaritmica: man mano che l’animale cresce, aggiunge nuove camere mantenendo la stessa forma complessiva, ma su una scala più grande. Questo tipo di spirale, chiamata anche spirale aurea, è un esempio naturale di equilibrio tra estetica e funzionalità, poiché consente al mollusco di crescere senza modificare la sua struttura interna.
DOMANDE
GUIDA

a. In che modo le sue cimette dell’infiorescenza assomigliano al cavolo intero?
b. Secondo te perché il cavolo romanesco cresce seguendo una forma a spirale e ripetuta? Che vantaggi può offrire alla pianta questo tipo di crescita?
c. Osserva la conchiglia del Nautilus: la sua forma si sviluppa secondo una spirale aurea. Che cosa sono i numeri riportati all’interno del disegno?
Intelligenza Artificiale IA
Chiedi a un chatbot di intelligenza artificiale di fornirti una spiegazione con parole semplici di “spirale logaritmica”, “spirale aurea”.
La conservazione della natura VIVENTI
“Relazione” è la parola chiave della vita sulla Terra. Non solo gli organismi sono legati da relazioni, ma l’intera biosfera non può vivere senza continui scambi di materia ed energia con le altre sfere geochimiche. Coloro che studiano biologia sono convinti che la collaborazione tra organismi, e non solo la competizione, abbia permesso alla vita di affermarsi ed evolvere sulla Terra: gli organismi che cooperano con individui della loro specie o di specie differenti hanno maggiori possibilità di sopravvivere e di affrontare i cambiamenti dell’ambiente.
È questo l’oggetto di studio dell’ecologia, una scienza giovane, nata nella seconda metà dell’Ottocento, ma che oggi ha assunto un ruolo fondamentale nella ricerca di soluzioni per la conservazione degli ambienti naturali, messi in pericolo dagli interventi umani.
In natura le relazioni tra gli organismi si costruiscono attraverso i comportamenti e la comunicazione, nelle sue diverse forme, studiati dall’etologia. Fino a qualche anno fa l’etologia riguardava solo il mondo animale, ma oggi, grazie agli studi condotti da Stefano Mancuso, scienziato di fama mondiale, è nata l’etologia vegetale che studia le modalità di comunicazione tra le piante e le relazioni che stabiliscono tra di loro er sopravvivere e proteggere il loro ambiente.
3



L’ecologia unità 7 L’etologia unità 8


SARA CASTELLAZZI, zookeeper


Per realizzare la sua tesi e conseguire la laurea in Scienza naturali, Sara ha svolto un tirocinio in un parco faunistico, studiando una colonia di fenicotteri rosa. È stata un’esperienza positiva, tanto che oggi lavora come zookeeper nello stesso parco. Si occupa di preparare i pasti e di curare la pulizia dell’habitat di diverse specie di primati, come lemuri, bertucce e grandi babbuini; questo le permette di osservare da vicino il comportamento degli animali, di capire le loro necessità ed eventuali problemi di salute.
NOEMI ROTA, dottorandainEcologiadelpaesaggio


Noemi si è laureata prima in Biologia e poi in Scienze ambientali. Oggi si occupa di Ecologia del paesaggio e di servizi ecosistemici. Il suo lavoro consiste nella raccolta di dati ecologici su campo e nella realizzazione di analisi di laboratorio e di analisi eseguite dai satelliti, per valutare i benefici forniti dagli ecosistemi e prendere decisioni consapevoli per la gestione e la tutela degli ecosistemi stessi.
FABIO DEOTTO, scrittoreedivulgatore

Due passioni accompagnano Fabio da sempre: la Biologia e la letteratura. Dopo la laurea in Biotecnologie Molecolari, si è dedicato alla scrittura, senza mai perdere interesse per le scienze. Nel 2021 ha pubblicato L’altro mondo. La vita in un pianeta che cambia, un reportage in cui esplora i luoghi nel mondo dove la crisi climatica sta già cambiando il modo di vivere. Oggi lavora come giornalista scientifico e culturale per diverse riviste e quotidiani.
Ivan Pavlov
PARLA LA SCIENZA
L’ecologia unità
lezione 1
DALL’aMBIENTE ALL’eCOSISTEMA
lezione 2
COME FUNZIONA UN ’ECOSISTEMA
EDUCAZIONE CIVICA
Che cosa sono i rifiuti
lezione 3
LE RELAZIONI TRA GLI ORGANISMI
I licheni: sentinelle ambientali VISUAL

lezione 4
I BIOMI TERRESTRI
lezione 5
I BIOMI ACQUATICI
lezione EDUCAZIONE CIVICA 6
IL CAMBIAMENTO CLIMATICO
E GLI EFFETTI SULLA BIOSFERA

LEZIONI POWERPOINT in


BUONE NOTIZIE PER IL FUTURO
Non basta conservare gli ecosistemi, BISOGNA RIGENERARLI
Nel luglio 2023 il Parlamento europeo ha approvato una legge storica per la tutela della natura: la Nature Restoration Law, la legge per il ripristino degli ecosistemi. Il suo obiettivo è fermare la distruzione degli ambienti naturali, sia terrestri sia acquatici, e contrastare la perdita di biodiversità causata dalle attività umane e dal cambiamento climatico. “Ripristinare” significa aiutare gli ecosistemi danneggiati a rigenerarsi, rafforzando le loro funzioni e rendendoli più resilienti La legge punta a riportare in buono stato almeno il 20% delle aree naturali dell’Unione Europea entro il 2030, e tutti gli ecosistemi degradati entro il 2050. Gli interventi interesseranno ambienti come foreste, zone umide, praterie, fiumi, mari, ma anche città e terreni agricoli, insieme alle specie che li abitano. Come si può raggiungere questo ambizioso obiettivo? Ad esempio, riducendo fortemente l’uso dei pesticidi in agricoltura, piantando più alberi nelle città per aumentare le aree ombreggiate, proteggendo gli insetti impollinatori e rimuovendo le barriere artificiali inutili che bloccano i fiumi, per favorire il naturale scorrere dell’acqua e prevenire gravi alluvioni.
SCIENCE REEL


Ecologia: quando la diversità è importante per sopravvivere
DALL’aMBIENTE ALL’ ECOSISTEMA lezione 1
CARTA PENNA COMPUTER

La nascita dell’ecologia
Esplora l’oggetto interattivo e scrivi le risposte sul quaderno.
1. In che modo le grandi esplorazioni hanno contribuito alla conoscenza dell’ambiente e della natura in genere?
2. Quando è nata l’ecologia? Che cosa significa il termine “ecologia”?
3. Chi ha introdotto il termine “ecosistema”?
4. Perché sono importanti gli studi realizzati dalla scienziata R.L. Carson?
Come fa questo insetto a trovare l’acqua nel deserto?
SCIENZA

Questo insetto è il coleottero delle nebbie, che vive nel deserto della Namibia, una delle regioni più aride della terra. Eppure ha un sistema infallibile per trovare l’acqua necessaria per sopravvivere, la cattura letteralmente. Nelle prime ore del mattino il coleottero si posiziona sulla parte alta delle dune e raccoglie l’umidità della nebbia. L’insetto non fa troppa fatica: le goccioline d’acqua condensano sull’estremità dell’addome, si aggregano e rotolano nella bocca grazie ai piccoli dossi sulle ali esterne. Questa tecnica di cattura dell’acqua, chiamata fog catching, ha ispirato soluzioni innovative e sostenibili per recuperare l’acqua per le popolazioni che vivono nelle regioni aride.
Metti in pausa il video nei seguenti punti.

5. Dai un titolo a ogni immagine e scrivi una didascalia di commento.


1 L’ecologia
Basta dire eco prima di una parola o usare il termine ecologia per indicare che stiamo parlando dell’ambiente e di tutto quello che si può fare per conservarlo e proteggerlo.
Ma che cos’è l’ ecologia ? Cerchiamo di capirlo con qualche esempio. La vita di qualsiasi organismo si svolge in un luogo ben definito: per una carpa è il lago dove vive, per un insetto è il frutto in cui ha scavato un cunicolo, per un albero è il terreno dove affonda le radici, per un batterio è l’organismo che ha infettato. Questo luogo e l’insieme dei fattori che influiscono sulla sua vita sono l’ ambiente dell’organismo, dal quale egli trae l’energia necessaria per crescere, muoversi, riprodursi e compiere le altre funzioni vitali.
L’ecologia è la scienza che studia le relazioni che si instaurano tra gli organismi e l’ambiente nel quale vivono.
CHE
ORA FERMA L’IMMAGINE!
2 Fattori abiotici e biotici di un ambiente naturale
Ogni ambiente possiede un insieme di caratteristiche che possono essere raggruppate in due categorie: i fattori abiotici e i fattori biotici
I fattori abiotici comprendono tutti gli elementi non viventi dell’ambiente.
• I fattori abiotici di tipo fisico sono l’acqua, la luce, la temperatura, l’umidità e la pressione dell’aria. Insieme ai fattori che caratterizzano il clima di un luogo, come l’alternarsi delle stagioni e dei periodi secchi e umidi, le temperature minime e massime, la lunghezza del dì e della notte, condizionano la vita degli organismi. L’acqua è una sostanza di fondamentale importanza per la vita ed è un fattore abiotico di cui non tutti gli organismi hanno bisogno allo stesso modo 1
La luce è indispensabile per i vegetali: infatti, grazie a essa possono compiere la reazione di fotosintesi e fabbricarsi le sostanze nutritive. Gli animali, invece, sono meno dipendenti dalla luce.
• I fattori abiotici di tipo chimico riguardano la composizione del suolo, dell’aria, dell’acqua. La composizione e lo spessore del suolo, per esempio, condizionano la vita dei vegetali, degli animali erbivori che di essi si cibano e degli animali che vivono sottoterra scavando gallerie.
1 La vita negli ambienti poveri di acqua.
Gli organismi xerofili, come il dromedario e il cactus, si sono adattati a vivere nei deserti e riescono a sopravvivere anche con minime quantità di acqua.

Nei climi aridi le foglie possono trasformarsi in spine e ricoprirsi di una cuticola impermeabile per ridurre l’evaporazione.

I fattori biotici comprendono tutti gli organismi che vivono in un ambiente e l’insieme delle relazioni che li lega.
Gli organismi della stessa specie hanno bisogno gli uni degli altri: molte specie vivono in gruppo e traggono vantaggio dall’aggregazione, ma esistono anche specie che conducono vita solitaria 2 .
In ogni ambiente la sopravvivenza degli organismi dipende anche dalle relazioni che si stabiliscono tra specie diverse. Un esempio sono le catene alimentari: i vegetali, che vivono grazie alle componenti abiotiche dell’ambiente sono cibo per gli erbivori che, a loro volta, permettono la sopravvivenza dei carnivori.

2 Il bradipo conduce vita solitaria e si sposta solo per trovare un partner per la riproduzione.

3 La trota è un pesce che può vivere solo in acqua di torrente, ben ossigenata e fresca.


4 Le piante dei climi caldi e umidi hanno foglie sottili e ampie per aumentare la traspirazione.
3
Fattori limitanti
A seconda che gli ambienti siano acquatici o terrestri, alcuni fattori sono più importanti di altri per la vita degli organismi e, per questa ragione, sono chiamati fattori limitanti
I fattori limitanti sono fattori che rallentano o impediscono la sopravvivenza degli organismi.
Negli ambienti acquatici i fattori limitanti sono la luce, la concentrazione di ossigeno, la salinità e la quantità di sostanze nutritive disciolte. Per esempio, la luce che penetra nell’acqua si riduce con la profondità: per questo motivo la maggior parte dei vegetali acquatici vive entro i primi 50 m di profondità. Anche l’ossigeno non è uniformemente distribuito nell’acqua: le acque fredde e mosse e le acque dolci superficiali sono quelle più ossigenate 3 .
Negli ambienti terrestri sono fattori limitanti la temperatura, la disponibilità di acqua e la composizione chimica del suolo.
La temperatura svolge un ruolo determinante: le sostanze di cui sono costituiti gli esseri viventi sopportano temperature comprese tra 0 °C (la temperatura di congelamento dell’acqua) e 40-50 °C.
L’acqua contenuta in un organismo tende a mantenersi costante nella quantità, ma al suo interno si rinnova continuamente. Gli animali assumono acqua dagli alimenti e bevendo, e al tempo stesso la restituiscono all’ambiente attraverso la respirazione, la traspirazione e l’escrezione.
Le piante hanno diverse strategie per recuperare l’acqua e conservarla: per esempio, le piante terrestri hanno radici molto lunghe e ramificate per aumentare la superficie di assorbimento, e anche la forma e le dimensioni delle foglie dipendono dalla disponibilità di acqua nell’ambiente 4
4 L’ecosistema e la sua organizzazione
L’ambiente possiede tutte le caratteristiche di un sistema perché è costituito da elementi diversi che si influenzano reciprocamente. Per questo prende il nome di ecosistema.

L’ecosistema è l’insieme costituito dagli organismi viventi e dall’ambiente fisico in cui vivono e con il quale interagiscono.
L’insieme di tutti gli ecosistemi costituisce la biosfera, ovvero la parte della Terra in cui esistono forme di vita.
In ogni ecosistema si possono individuare spazi in cui esistono le condizioni ambientali adatte alla vita di una particolare specie; questo spazio si chiama habitat.
L’habitat è il particolare tipo di ambiente in cui vive ciascun organismo.
Nel proprio habitat ciascun organismo utilizza particolari risorse per vivere e riprodursi, e stabilisce determinate relazioni con gli altri organismi che vi abitano. In ecologia si dice che ogni specie ha una propria nicchia ecologica
Piante che amano il sale
La nicchia ecologica è la posizione che una specie assume nel proprio habitat e il modo in cui sfrutta le risorse dell’ambiente.
In ecologia il termine ha un significato molto ampio perché comprende le scelte alimentari, i comportamenti, i predatori e tutti i fattori fisici, come temperatura e umidità, che condizionano la vita di un organismo. Per questa ragione organismi di due specie diverse non possono occupare la stessa nicchia ecologica: nascerebbe una competizione che porterebbe una delle due specie a scomparire, migrare o adattarsi a una nicchia ecologica leggermente diversa.
Gli organismi di una stessa specie che vivono nello stesso luogo formano una popolazione
Per esempio, costituiscono una popolazione l’insieme delle piante di trifoglio che crescono in un prato, così come i conigli selvatici che si cibano del trifoglio e delle erbe di quello stesso prato. Lo stesso habitat è popolato da tante specie che, per vivere insieme, devono cibarsi di alimenti diversi e avere comportamenti differenti per quanto riguarda la riproduzione, gli spostamenti e la costruzione dei rifugi.
L’insieme delle popolazioni di specie diverse che convivono nello stesso habitat forma una comunità di organismi.
Le comunità costituiscono la componente biotica degli ecosistemi 5 .



FISSA I CONTENUTI

ESSENZIALI
Segna con una crocetta se è vero (V) o falso (F).

5 Dall’organismo alla biosfera.

1. L’ecologia è la scienza che studia le relazioni che si instaurano tra gli organismi e il loro ambiente.
2. La concentrazione di ossigeno è un fattore limitante in ambiente acquatico.
3. La nicchia ecologica è l’insieme degli organismi viventi e dell’ambiente fisico in cui vivono.
4. Gli organismi di una stessa specie che vivono nello stesso luogo formano una comunità.
La nicchia del lombrico
SKILL BOOK
BIOSFERA IN BOTTIGLIA
LAB TINKERING
Come funziona un ecosistema lezione 2
CARTA PENNA COMPUTER

La ricerca di Hasler
Esplora l’oggetto interattivo e scrivi le risposte sul quaderno.
CONTENUTI DIGITALI
1 Il “laboratorio” foglia.
energia dalla luce del Sole

Il ciclo dell’azoto
1. In quale sfera geochimica è più abbondante l’azoto?
2. Quali importanti molecole che formano i viventi contengono azoto?
3. Grazie a quali organismi l’azoto gassoso può entrare a far parte dei viventi?
4. Quali organismi ospitano i batteri azotofissatori? Quali vantaggi traggono da questa convivenza?
5. Che tipo di organismi sono gli animali e i funghi relativamente al loro modo di nutrirsi?
6. Che cos’è la denitrificazione?
1 Gli organismi produttori
I cloroplasti catturano
1

l’energia solare

5

2
L’acqua entra nella foglia.

Lo zucchero (glucosio) lascia la foglia.
3
COMPITO DI REALTÀ
UNA VISITA AL PARCO
L’ossigeno esce dagli stomi. 4
Le principali relazioni che si stabiliscono tra gli organismi di un ecosistema sono di tipo alimentare: gli animali mangiano i vegetali oppure altri animali che, a loro volta, hanno mangiato dei vegetali. Alla base dell’alimentazione di tutti gli organismi ci sono quindi i vegetali. Grazie all’energia solare, essi sono in grado di trasformare le sostanze inorganiche (acqua, anidride carbonica e sali minerali) in sostanze organiche (zuccheri, proteine e lipidi) mediante il processo della fotosintesi 1 I vegetali, che sono capaci di “produrre” autonomamente le sostanze nutritive, sono chiamati autotrofi. Rientrano in questa categoria le piante e altri organismi fotosintetici come le alghe. Le sostanze organiche prodotte attraverso la fotosintesi sono utilizzate dagli autotrofi per costruire le proprie strutture, per crescere e per riprodursi.
L’anidride carbonica entra nella foglia dagli stomi.
Gli organismi autotrofi che producono sostanze organiche a partire da sostanze inorganiche costituiscono gli organismi produttori
2 Gli organismi consumatori e decompositori
Gli organismi autotrofi costituiscono il cibo per gli animali e per altri organismi eterotrofi che sono in grado di utilizzare soltanto sostanze organiche già sintetizzate.
Gli organismi eterotrofi che si nutrono delle sostanze organiche già fabbricate da altri organismi costituiscono gli organismi consumatori.
I consumatori che si cibano direttamente di produttori sono gli erbivori, mentre quelli che si nutrono di altri consumatori sono i carnivori
Gli erbivori sono consumatori di primo ordine (o primari); i carnivori che si nutrono di erbivori sono consumatori di secondo ordine (o secondari); i carnivori che si nutrono di altri carnivori sono consumatori di terzo o quarto ordine (terziari o quaternari).
Quando gli organismi muoiono, i loro resti possono diventare cibo per altri animali, i saprofagi: alcuni, come gli avvoltoi, si nutrono direttamente dei cadaveri; altri, come alcuni insetti o i lombrichi, si cibano dei residui degli organismi morti.
La demolizione della materia organica viene completata da particolari organismi eterotrofi che vivono nel suolo, chiamati decompositori, come i batteri e i funghi
Saprofagi e decompositori contribuiscono a ritrasformare le sostanze organiche in sostanze inorganiche, che tornano a essere nuovamente a disposizione dei vegetali.
Se in un ambiente mancasse anche solo una di queste tre categorie di organismi, non potrebbero vivere nemmeno le altre due. Infatti, se sparissero improvvisamente i vegetali, gli erbivori morirebbero di fame per mancanza di cibo e, per lo stesso motivo, morirebbero presto anche i carnivori e i decompositori. Possiamo quindi dire che nessuna specie può vivere da sola e che ogni specie è condizionata e dipende da altre specie.
3 Catene e reti alimentari
Produttori, consumatori e decompositori sono legati tra loro da rapporti di tipo alimentare, che si possono rappresentare con le catene alimentari. Ogni specie corrisponde a un anello della catena alimentare e la posizione in cui si trova questo anello è chiamata livello trofico. La catena alimentare è in realtà una semplificazione: la maggior parte degli animali, infatti, si nutre di specie diverse e, contemporaneamente, è preda di diversi consumatori e quindi entra a far parte di più catene alimentari.
Una catena alimentare è una sequenza di organismi che si nutrono gli uni degli altri. L’intreccio di diverse catene alimentari costituisce una rete alimentare.
La rete alimentare è una rappresentazione più realistica della complessità di un ecosistema. Il primo anello è rappresentato dai produttori. Alla fine di una catena o di una rete alimentare c’è sempre un predatore, cioè un consumatore di quarto ordine che nel suo ambiente non viene cacciato da nessuno 2

2 Una catena alimentare (a) e una rete alimentare (b). Le frecce significano “è mangiato da”.
Consumatori quaternari
Consumatori terziari
Consumatori secondari
Consumatori primari
Produttori primari


















Decompositori

libellula
rapace
volpe
ratto
lepre
cincia
serpente
erba
rana
coccinella
afide
farfalla
cavalletta
bacche
b
La catena alimentare marina
3 Piramide dell’energia.






4 Piramide della biomassa.
(kg) Esempi di organismi





5 La piramide dei numeri.
Esempi di organismi Livello trofico






Numero di individui
4
Le piramidi di un ecosistema
Un ecosistema ha bisogno di un continuo apporto di energia. In una catena alimentare i produttori, con la fotosintesi, assorbono l’energia solare per produrre materia vivente ma spendono una parte di essa per svolgere le proprie funzioni vitali, restituendola all’ambiente sotto forma di calore. Pertanto, solo una frazione dell’energia accumulata è disponibile per i consumatori primari che, a loro volta, richiedono energia per il movimento e per le altre funzioni vitali, e la disperdono come calore. Di conseguenza, la quota di energia resa disponibile ai consumatori secondari è molto inferiore a quella acquisita dalle piante. Nei passaggi attraverso i vari livelli di una catena alimentare, l’energia diminuisce progressivamente e deve essere rimpiazzata da nuova energia proveniente dal Sole. Per rappresentare l’energia che passa da un livello all’altro si utilizza un grafico a piramide, la piramide dell’energia 3 .
La quantità di energia che passa da un livello trofico a quello successivo è solo il 10% di quella contenuta nella materia organica del livello precedente. La materia, invece, percorre dei cicli all’interno della biosfera: gli atomi utilizzati per produrre sostanze organiche sono sempre gli stessi perché sono riciclati passando dai produttori ai consumatori fino ai decompositori. Per rappresentare la quantità di materia organica disponibile nei successivi livelli trofici di una catena alimentare si usa un altro grafico a piramide, la piramide della biomassa 4 . Il rettangolo alla base, che rappresenta la biomassa dei produttori dell’ecosistema, è sempre più esteso dei rettangoli superiori, che rappresentano la biomassa dei consumatori, perché nel passaggio da un livello all’altro la diminuzione di biomassa corrisponde alla riduzione dell’energia.
Un’altra piramide utilizzata è la piramide dei numeri. Anche in questa rappresentazione dell’ecosistema si usano rettangoli la cui area è proporzionale al numero di organismi di ciascun livello trofico 5
5 I cicli della materia
consumatori terziari consumatori secondari consumatori primari produttori
Il ciclo dell’acqua, cioè la circolazione dell’acqua attraverso il sistema Terra, svolge un ruolo fondamentale perché fa da collegamento tra riserve di sostanze organiche e inorganiche permettendo, grazie all’energia solare, la circolazione di elementi e composti. L’acqua evapora dalla superficie dei corsi d’acqua e passa come vapore nell’atmosfera, dove condensa nelle goccioline che formano le nubi. L’acqua torna poi sulla superficie terrestre sotto forma di precipitazioni 6 .

Il ciclo del carbonio
Il ciclo del carbonio è un esempio di ciclo biogeochimico, perché interessa sia l’ambiente sia i viventi: il carbonio, infatti, è l’elemento base dei composti organici. Nell’atmosfera è presente come anidride carbonica (o diossido di carbonio, CO2), un gas che i produttori utilizzano nella fotosintesi per produrre glucosio e altre sostanze organiche. Attraverso la catena alimentare queste sostanze passano dai produttori ai consumatori e diventano il combustibile nel processo di respirazione, che rilascia nell’aria anidride carbonica. Anche il carbonio che rimane a far parte degli organismi viene rilasciato sotto forma di CO2, ma solo alla loro morte, grazie alla demolizione delle molecole organiche compiuta dai decompositori. Il ciclo dell’azoto è un altro ciclo biogeochimico. L’azoto è presente in grandi quantità nell’atmosfera, ma entra nel ciclo dei viventi solo grazie ai cianobatteri e ai batteri azotofissatori presenti nel suolo e nelle radici di alcune piante, le leguminose.
L’azoto “fissato” e incorporato dalle piante è distri buito agli animali attraverso la catena alimentare: torna alla materia inorganica solo alla morte degli organismi, grazie all’azione dei batteri nitrificanti del suolo, che trasformano i resti organici in com posti azotati. Infine, l’azoto ritorna all’atmosfera attraverso i batteri denitrificanti, che convertono le sostanze azotate in azoto gassoso.
Il fosforo è un elemento indispensabile per la vita perché entra a far parte della molecola di DNA ma è contenuto principalmente in alcune rocce della crosta terrestre.


6 Il ciclo dell’acqua.




















evaporazione
evapotraspirazione


condensazione grandine pioggia pioggia neve








Il ciclo del fosforo.
e uccelli






















fosforo nelle rocce

disciolto nelle acque

Il ciclo del fosforo inizia con il rilascio di fosforo provocato dalla disgregazione di queste rocce; in seguito, entra nel ciclo dei viventi grazie ai vegetali marini e quindi risale la catena alimentare. Alla morte degli organismi particolari batteri restituiscono il fosforo al terreno 7 .
FISSA I CONTENUTI ESSENZIALI
Completa le frasi con i termini corretti.
1. L’intreccio di diverse catene alimentari costituisce una alimentare.
2. L’azione dei presenti nel suolo trasforma i resti organici in composti azotati.
3. Per rappresentare l’energia che passa da un livello trofico all’altro si utilizza un grafico detto dell’energia.
4. Gli organismi che si nutrono delle sostanze organiche già fabbricate da altri, sono organismi consumatori.
falde acquifere
scorrimentosuperficiale
evaporazione
pesci
marini
fosforo
vegetali marini
7
EDUCAZIONE CIVICA
Che cosa sono i rifiuti
Una risposta potrebbe essere: “I rifiuti sono tutto ciò che non ci serve più o che ha esaurito la sua funzione!”. Questa però è una risposta che potrebbe dare solo un essere umano, perché in natura i rifiuti non esistono. Tutti i residui animali e vegetali subiscono una trasformazione e le sostanze ritornano a disposizione degli organismi attraverso i cicli della materia.
1
Prendiamo esempio dalla natura
1 Le tre frecce rappresentano le tre fasi del riciclo. Quando trovi questo simbolo su un prodotto vuol dire che il materiale di cui è fatto è riciclabile.

2 Cereali “alla spina” in un supermercato.
Il verbo “riciclare” è composto dal prefisso ri- che indica “di nuovo” e dalla parola greca kyklos, “giro”. Letteralmente, quindi, questo termine vuol dire “mettere di nuovo in circolazione”; nell’ambito dei rifiuti, riciclare significa riutilizzare materiali di scarto per nuovi scopi. Sull’esempio delle strategie naturali così efficienti, anche i rifiuti e gli scarti delle nostre attività, quando sono raccolti e trasformati correttamente, non solo possono essere riciclati, ma anche riutilizzati.
Ognuno di noi ogni giorno produce circa 1,5 kg di scarti che rappresentano il punto di partenza della raccolta differenziata. Grazie a una corretta separazione dei materiali negli appositi contenitori, i rifiuti possono essere inviati agli impianti specifici dove sono trasformati in nuovi prodotti.
Nel processo di corretta gestione dei rifiuti ha un ruolo fondamentale la strategia delle 3 R: ridurre, riutilizzare, riciclare 1
Secondo questa strategia i rifiuti, prima di diventare veri scarti, sono considerati delle risorse perché possono ancora essere utilizzati, sebbene con funzioni diverse rispetto al loro scopo originario; oppure è possibile recuperare il materiale di cui il rifiuto è fatto per creare un nuovo oggetto. Solo quando non possiamo più né riutilizzarli né riciclarli, i rifiuti diventano dei veri scarti. Da queste considerazioni è chiaro che la raccolta differenziata coinvolge direttamente il cittadino nella creazione di un’economia circolare, un modello di sistema economico che prende spunto dalla natura, dove nulla viene buttato ma tutto è trasformato e riutilizzato in un nuovo ciclo.

2 Disimballiamoci
Delle 3, R la prima è la più importante: RIDURRE Circa il 60% dei prodotti che acquistiamo è costituito da imballaggi che servono per il trasporto del prodotto e la sua conservazione, oppure servono a informare il consumatore sulle caratteristiche del prodotto o ad attirarne l’attenzione con la forma e il colore. Si tratta, quindi, di imballaggi superflui che potrebbero essere facilmente evitati. Cerchiamo dunque di ridurre il più possibile la nostra produzione domestica di rifiuti facendo scelte consapevoli, per esempio privilegiando imballaggi di cartone o di vetro al posto della plastica, comprando prodotti sfusi ed evitando di acquistare prodotti usa e getta 2
3
Stop alle discariche abusive
Fino a pochi anni fa tutto quello che buttavamo era portato nelle discariche e accumulato in grandi buche scavate nel suolo, spesso senza alcun sistema di impermeabilizzazione né barriere di protezione.
Discariche di questo tipo hanno avuto per anni un forte impatto ambientale, perché la decomposizione delle sostanze contenute nei rifiuti rilasciava nel terreno composti inquinanti che danneggiavano l’acqua e il suolo e liberavano nell’aria metano e anidride carbonica, due gas a effetto serra. Oggi le discariche autorizzate raccolgono solo rifiuti precedentemente selezionati. Inoltre, sono costruite in modo da ridurre al minimo l’impatto ambientale: hanno il fondo impermeabilizzato, così da raccogliere il percolato, cioè l’insieme dei liquidi prodotti dalla decomposizione dei rifiuti, e sono attraversate da tubazioni dove sono convogliati i gas, in particolare il metano, che sono poi utilizzati negli impianti adiacenti per produrre energia.
Purtroppo è ancora troppo frequente il fenomeno delle discariche abusive, luoghi in cui vengono abbandonati rifiuti di qualsiasi tipo 3
4 L’arte dai rifiuti

3 Una discarica abusiva.
I rifiuti possono anche ispirare idee creative. Molti artisti contemporanei utilizzano plastica, metallo e cartone per realizzare le loro opere d’arte. Questi artisti comunicano la loro creatività attraverso nuove forme, ma hanno anche l’obiettivo di sensibilizzare la gente al problema dell’eccessiva produzione di rifiuti.
Bordalo, artista portoghese, crea le sue opere unendo la tecnica classica della street art con l’uso di materiali riciclati per creare particolari murales e sculture 4 .

4 L’artista Arthur Bordalo ha realizzato questa scultura utilizzando solo rifiuti di plastica.
SKILL BOOK
LAB STEM
PERCHÉ L’OLIO NON VA VERSATO NEL LAVANDINO?
Le relazioni tra gli organismi lezione 3
CARTA PENNA COMPUTER

Armi da predatori, trucchi da prede
Strategie di caccia.


Guarda il video e scrivi le risposte sul quaderno.
1. Quali sono le caratteristiche dei predatori?
2. Qual è la dimensione dei predatori rispetto alle prede?
3. Quali caratteristiche fisiche hanno sviluppato i predatori per sopraffare le prede?
4. Quali tecniche hanno sviluppato le prede per sfuggire ai predatori?
1
Metti in pausa il video nei seguenti punti.


5. Scrivi un breve testo che metta a confronto le tecniche di predazione dell’aquila e quelle della medusa.
Gli organismi non hanno solo rapporti alimentari
Ogni comunità è formata da popolazioni di organismi produttori, consumatori e decompositori che possono instaurare tra loro vari tipi di rapporti, non solo alimentari. Individui di specie diverse possono essere legati da relazioni che, in alcuni casi, producono un vantaggio reciproco, in altri un vantaggio oppure un danno per uno solo dei due. I predatori, per esempio, sono organismi che catturano, uccidono e divorano altri organismi che sono le loro prede. In generale, i predatori sono più grandi delle prede, come nel caso di un gatto e un topo; oppure, quando sono di taglia minore, cacciano in branchi, come fanno i leoni 1
La predazione è un tipo di relazione alimentare in cui un predatore cattura e si nutre di una preda.
In questo tipo di relazione sono sempre i predatori a ricavare vantaggio, mentre le prede sono danneggiate. Anche i predatori, tuttavia, esercitano un’azione molto importante negli ecosistemi, perché controllano l’eccessivo sviluppo delle popolazioni delle prede.
Il rapporto di simbiosi si crea quando due o più individui di specie diverse si aiutano reciprocamente, oppure quando una sola delle due specie trae dei vantaggi.
ORA FERMA L’IMMAGINE!
CONTENUTI DIGITALI
Il termine simbiosi è usato per indicare una relazione stretta e permanente tra individui di specie diverse. In natura esistono diversi tipi di simbiosi: il parassitismo, il commensalismo e il mutualismo.
• Il parassitismo è una simbiosi tra due specie diverse nella quale una ricava vantaggio e l’altra è danneggiata. Le specie parassite sono numerose e sono generalmente più piccole delle loro prede, gli ospiti, dalle quali ricavano il nutrimento senza possibilmente determinarne la morte. Un esempio è la zecca 2 a . Gli ectoparassiti sono forniti di ventose o uncini con i quali si attaccano sulla superficie dell’ospite per succhiargli il sangue. Gli endoparassiti vivono negli organi interni del loro ospite. La tenia, chiamata anche verme solitario, è un endoparassita che vive all’interno dell’intestino dei mammiferi, esseri umani compresi 2 b
2 Parassiti esterni e interni.


• Il commensalismo è una relazione in cui una specie trae vantaggio da un’altra senza danneggiarla. Un esempio di commensalismo si osserva tra gli uccelli che seguono le mandrie di erbivori nella savana poiché si cibano dei parassiti che questi erbivori hanno sul corpo 3 .
• Il mutualismo è una simbiosi tra due specie diverse, nella quale entrambe ricavano beneficio.
Che cosa vuol dire l’espressione “Avere delle remore”?
L’espressione deriva dal comportamento della remora, un pesce dotato di un potente organo-ventosa sul dorso con il quale si attacca ad altri pesci o allo scafo delle imbarcazioni per farsi trasportare. Questo comportamento, se praticato contemporaneamente da più individui, può creare difficoltà di movimento al pesce ospite. In tal senso, “avere delle remore” indica avere un impedimento a fare qualcosa. Nonostante l’abitudine a “rubare” passaggi, la remora non è un parassita anzi, è un cacciatore attivo, ma può anche instaurare relazioni di commensalismo con gli squali, cibandosi dei resti che sfuggono dalla loro bocca.
La bufaga beccorosso è una specie di uccello africano che si nutre di zecche e altri parassiti presenti sul pelo di grandi mammiferi come i bufali.


4 Tipi di mutualismo.
In natura esistono rapporti mutualistici facoltativi, quando le due specie possono vivere e riprodursi anche autonomamente, e rapporti mutualistici di tipo obbligatorio, che si verificano nel caso in cui le due specie (o una delle due) non possano vivere senza l’altra 4
Il cibo degli erbivori ruminanti come le mucche è ricco di cellulosa, un polisaccaride impossibile da digerire senza la collaborazione di certi microrganismi. I batteri che si trovano nel rumine, infatti, degradano la cellulosa ottenendo sostanze nutritive per loro e liberandone altre che sono assimilabili dall’animale ruminante. La relazione che si instaura tra ruminanti e batteri è un mutualismo obbligato.




Gli afidi sono minuscoli insetti che si nutrono della linfa di numerose piante e producono una sostanza zuccherina che viene utilizzata dalle formiche come fonte di nutrimento. Le formiche, d’altra parte, difendono gli afidi dai predatori, proteggendoli dai pericoli e assicurandone la sopravvivenza. Le formiche hanno stretto con gli afidi una forma di mutualismo facoltativo.
2
Il mimetismo
La sopravvivenza di una specie all’interno di una comunità è spesso legata alla sua capacità di mimetizzarsi: un organismo si confonde con un elemento dell’ambiente o con una parte di un altro organismo in modo da sfuggire ai predatori o, al contrario, in modo da non essere visto dalle prede che si avvicinano a lui.
Esistono diversi tipi di mimetismo, ma il più conosciuto è il mimetismo criptico, attraverso il quale un organismo assume una colorazione, una forma oppure un comportamento per rendersi invisibile alla preda o al predatore. Per esempio, i polpi e i camaleonti hanno la straordinaria capacità di cambiare velocemente colore per non essere avvistati dalle potenziali prede 5 . Molti organismi che producono veleni o sono potenzialmente pericolosi per gli altri ricorrono a un altro tipo di mimetismo, chiamato mimetismo mülleriano. Questi animali presentano colorazioni di avvertimento molto marcate, come le strisce
gialle e nere di vespe e calabroni o le colorazioni vivacissime di alcune rane tropicali, come la Dendrobates leucomelas che, se attaccata, produce una sostanza tossica 6 . Un eventuale predatore che abbia assaggiato per la prima volta una preda disgustosa o tossica o che lo ha punto, impara velocemente a non catturarne altre della stessa specie, in particolare se il loro riconoscimento è favorito da colorazioni appariscenti. In natura esistono anche organismi che, pur non essendo pericolosi, sfruttano le potenzialità del mimetismo mülleriano per non essere predati. Si tratta del mimetismo batesiano, un camuffamento di inganno in cui individui innocui assumono le colorazioni o l’aspetto di organismi pericolosi. Per difendersi dai predatori, l’innocuo serpente del latte 7 a imita la vistosa colorazione del velenoso serpente corallo 7 b

FISSA I CONTENUTI ESSENZIALI
6 Esemplare di Dendrobates leucomelas.


Abbina i termini con la definizione corretta.
1 Predazione
2 Commensalismo
3 Mimetismo criptico
4 Mimetismo mülleriano
5 Mimetismo batesiano
a Relazione in cui una specie trae vantaggio da un’altra senza danneggiarla.
b Mimetismo tipico di animali che assumono colorazioni accese per avvertire della loro pericolosità.
c Tipo di relazione alimentare in cui un animale cattura e si nutre di un altro. d Camuffamento in cui individui innocui assumono le colorazioni o l’aspetto di organismi pericolosi.
e Comportamento di un organismo per rendersi invisibile alla preda o al predatore.
1: 2: 3: 4: 5:
VERSO LE COMPETENZE
I pesci pagliaccio sono noti per la loro capacità di vivere associati agli anemoni di mare, nuotando tra i loro tentacoli urticanti senza subire danni.
Rispondi alle domande e poi ricerca in rete altre associazioni simili tra organismi marini.
1. Quale vantaggio trae il pesce pagliaccio rifugiandosi tra i tentacoli dell’anemone?
2. Quale vantaggio può ricavare l’anemone dalla presenza costante del pesce?
3. Di quale tipo di associazione si tratta?

7 Animali che imitano altri animali.
VISUAL

I licheni, sentinelle ambientali
Esistono organismi in grado di vivere sulla superficie della roccia nuda e senz’acqua? I protagonisti di questo processo di colonizzazione della vita è svolto dai licheni, un’associazione vincente di un’alga e di un fungo in grado di risolvere autonomamente ogni problema di soprav vivenza. È stato scoperto che questa “strana coppia” è una vera e pro pria sentinella ambientale capace persino di ridurre la concentrazione degli inquinanti dell’aria.
ORGANISMI SIMBIONTI
I licheni sono una simbiosi fra un organismo autotrofo e un fungo, un organismo eterotrofo. La maggior parte dei funghi presenti nei licheni appartiene al gruppo degli ascomiceti, mentre gli individui autotrofi possono essere alghe o cianobatteri, organismi unicellulari che non potrebbero vivere fuori dall’acqua senza adeguata protezione dalle radiazioni solari e dalla secchezza dell’aria.
L’organismo autotrofo, protetto dalla fitta matassa delle ife del fungo che ancorano il lichene alla superficie delle rocce, usa l’acqua e l’anidride carbonica per produrre le sostanze nutritive utili a entrambi gli organismi. Esistono anche licheni che si ancorano ad altri vegetali o che si appoggiano direttamente sul terreno.
parte intermedia: è la parte dove la struttura delle ife è meno compatta e si trovano le alghe o i cianobatteri che compiono la fotosintesi.
cortex inferiore: è la parte inferiore formata da ife fungine intrecciate a contatto con il substrato.









cortex superiore: è la parte superiore formata da ife fungine intrecciate che hanno la funzione di proteggere la parte interna del lichene.
medulla: qui la struttura delle ife è molto rilassata e lo spazio è occupato principalmente da acqua.



ASSOCIARSI IN FORME DIVERSE
Le specie di licheni attualmente riconosciute sono circa 13 000, di cui ben 2000 vivono in Italia. Esistono licheni crostosi 1 , che formano incrostazioni colorate che aderiscono alla superficie della corteccia degli alberi e delle rocce, licheni fogliosi 2 , che si presentano come lamine, parzialmente sollevate dal substrato di ancoraggio e licheni fruticosi 3 , formati da un tallo che si sviluppa in tre dimensioni, con forme pendenti, ramificate, coniche o a imbuto rovesciato.
ALLEATI CONTRO L’INQUINAMENTO
Non c’è ambiente terrestre nel quale i licheni non possano vivere, ma questi organismi non sopportano l’aria inquinata. Non tutti reagiscono allo stesso modo: alcuni muoiono se esposti a dosi minime di inquinanti, altri resistono a concentrazioni molto elevate, altri ancora prosperano in presenza di gas tossici. I licheni si comportano come vere e proprie “spugne” che trattengono nel loro intreccio di filamenti l’aria e l’acqua circolanti: essi sono capaci di assorbire sostanze pericolose, come gli idrocarburi clorurati contenuti nei diserbanti, i metalli pesanti e persino gli isotopi radioattivi. Inoltre, i licheni sono “in funzione” tutto l’anno, 24 ore su 24, e sono attivi anche d’inverno quando le piante sono a riposo.

INDICATORI BIOLOGICI AFFIDABILI
Le particolari caratteristiche dei licheni hanno convinto gli scienziati a usarli come indicatori biologici per capire quali zone sono più soggette all’inquinamento dell’aria, ma anche per verificare gli effetti delle misure adottate per ridurre tale inquinamento. Grazie al lavoro dei lichenologi, che analizzano in laboratorio frammenti prelevati dall’ambiente, oggi possediamo metodi rapidi ed economici per valutare su larga scala l’inquinamento atmosferico. Tuttavia, anche le sentinelle dell’ambiente sono in pericolo: da qualche anno molti licheni, specialmente quelli che vivono sugli alberi, sono stati inseriti in una lista rossa che comprende le specie più minacciate o a rischio di estinzione.

PROVE DI COMPETENZA
LA CRISI DELL’ISOLA
DI PASQUA
SKILL BOOK
1 Corteccia ricoperta da lichene crostoso.
2 Lichene foglioso sul tronco di un albero.
3 Tipica forma pendente dei licheni fruticosi.
I biomi TERRESTRI lezione 4
CARTA PENNA COMPUTER

Esplora l’oggetto interattivo, scegli un bioma e rispondi alle domande sul quaderno.
1. Che cos’è un bioma?
2. In quale area geografica si estende il bioma che hai scelto?
3. Quali sono le condizioni climatiche presenti in quel territorio?
4. Quali sono le caratteristiche dei vegetali del bioma? Quali animali ospita il bioma?
Metti in pausa il video nei seguenti punti.

5. Dai il nome agli animali rappresentati e descrivi il bioma in cui vivono.


1 Biosfera e biomi
La biosfera è l’insieme di tutti gli ecosistemi della Terra e comprende, quindi, ogni luogo in cui vi è vita sul Pianeta. In base alle caratteristiche ambientali, tuttavia, è possibile suddividere la biosfera in raggruppamenti più piccoli chiamati biomi 1 .

I biomi sono l’associazione delle comunità vegetali e animali che caratterizzano determinate aree geografiche con particolari condizioni ambientali.


















bioma polare tundra taiga foresta temperata foresta equatoriale o tropicale macchia mediterranea savana prateria deserto bio tun taig for for tr o ma saav pra r dees



































Oceano
1 La mappa dei biomi.
I biomi terrestri
ORA FERMA L’IMMAGINE!
L’agente che caratterizza i diversi biomi è il clima: i principali elementi climatici che influiscono sull’estensione dei biomi sono piovosità e temperatura. Le due principali tipologie di biomi sono i biomi terrestri e i biomi acquatici. I biomi terrestri comprendono il bioma polare, la tundra, la taiga, la foresta temperata, la macchia mediterranea, la prateria, il deserto, la savana e la foresta tropicale.
2 I biomi dei climi freddi
■ IL BIOMA POLARE
Il bioma polare è dominato dai ghiacci e dalle nevi perenni. A causa delle temperature bassissime la vegetazione è quasi assente. La fauna è rappresentata da foche, trichechi, pinguini (solo nell’emisfero meridionale) e orsi polari (solo nell’emisfero settentrionale).
■ LA TUNDRA
Neve e ghiaccio coprono la tundra per la maggior parte dell’anno. Esistono due tipologie di tundra: la tundra artica e la tundra alpina. La tundra artica si estende a latitudini comprese fra 75° di latitudine Nord e il circolo polare artico (66° 33’ N). Il clima è caratterizzato da estati fresche molto brevi con temperature comprese fra 0° e 10° C; il resto dell’anno le temperature sono sempre inferiori allo zero e toccano spesso punte di –70 °C. I venti soffiano intensi tutto l’anno e le precipitazioni sono scarse. Il terreno è ghiacciato anche in profondità (permafrost) e il ghiaccio dello strato più superficiale fonde solo d’estate. Queste condizioni climatiche rigide permettono lo sviluppo di una vegetazione a fusto basso formata da muschi, licheni, piante erbacee e piccoli arbusti. I mammiferi che vivono in questo bioma sono roditori, come il lemming, e mammiferi carnivori, come l’orso bianco. Altri animali come la volpe artica, le renne, i caribù, moltissime specie di uccelli e di insetti scelgono queste regioni per la riproduzione estiva. La tundra alpina è molto simile per associazioni vegetali a quella artica. Si trova alle alte altitudini, corrisponde al limite della vegetazione, oltre le praterie alpine, fino alle rocce nude o ai ghiacciai perenni.
■ LA TAIGA
La taiga ricopre le regioni a clima temperato freddo: occupa una fascia di circa 1500-2000 km tra il circolo polare artico e il 50° parallelo a nord dell’Equatore. Il clima è caratterizzato da una stagione estiva calda e da una stagione invernale molto fredda. La taiga è una foresta di conifere, cioè di sempreverdi, formata da pini, abeti e larici, con un rado sottobosco. La stagione di crescita degli alberi della taiga è l’estate, che è anche il periodo della riproduzione degli animali di questo bioma: insetti, molte specie di uccelli e mammiferi come lepri, orsi, lupi, porcospini, puzzole, alci e cervi.



BIOMA POLARE
TUNDRA
TAIGA
3
I biomi dei climi temperati
■ LA FORESTA TEMPERATA
Vaste aree delle regioni dell’emisfero settentrionale sono coperte dalla foresta temperata decidua. Il clima di questi territori è caratterizzato da temperature miti e precipitazioni abbondanti distribuite uniformemente. La vegetazione è formata da latifoglie come querce, faggi, aceri, betulle, castagni, che perdono le foglie in autunno e le riformano in primavera. Il sottobosco è fitto e caratterizzato da numerosi arbusti, come i noccioli, o piante antiche, come le felci.



Le foreste temperate sono popolate da numerose specie di animali. Tra i mammiferi troviamo scoiattoli, ghiri, lupi, volpi, cinghiali. Anche rapaci come gufi e civette e molte specie di uccelli canori trovano qui il loro habitat ideale. La foresta temperata è l’habitat ideale anche per la specie umana, che ne ha alterato notevolmente l’ambiente e ne ha ridotto l’estensione in modo significativo.
■ LA MACCHIA MEDITERRANEA
La macchia mediterranea è caratteristica delle regioni affacciate sul mare Mediterraneo, dove l’inverno è piovoso e l’estate molto secca.
La vegetazione è formata da arbusti sempreverdi con foglie dure e spesse e alberi piuttosto bassi. Qui vivono il coniglio selvatico, l’istrice, il cinghiale e molte specie di uccelli. Un bioma simile a quello mediterraneo è presente anche in California, dove prende il nome di chaparral, in Australia, dove è chiamato mallee, e in Cile, con il nome di matorral.
■ LA PRATERIA
All’interno dei continenti, dove le precipitazioni sono scarse e i periodi di siccità frequenti, si estende il bioma della prateria. La prateria assume nomi differenti nei diversi continenti: pampas o llanos in Sud America, steppa in Asia ed Europa centrale, veldt in Sud Africa.
La vegetazione è costituita da erbe, cespugli e, lungo i corsi d’acqua, da alberi ad alto fusto. In questo ambiente vivono grandi erbivori, come i cavalli, ma anche carnivori predatori, come il coyote e il lupo, e numerosi uccelli rapaci.
Un tempo le grandi praterie americane erano interessate da un’imponente migrazione di grandi erbivori, i bisonti. Oggetto di una caccia intensa e insensata alla fine dell’Ottocento, il bisonte sopravvive ormai in popolazioni residuali in alcune aree del Canada e degli Stati Uniti.
La prateria è l’ambiente maggiormente sfruttato dall’uomo. Le praterie del Nord America, dell’Europa e dell’Asia ospitano la più alta concentrazione di popolazione umana e di infrastrutture: abitazioni, città, strade, industrie.
FORESTA TEMPERATA
MACCHIA MEDITERRANEA PRATERIA
4 I biomi dei climi caldi
■ IL DESERTO
Nelle regioni a nord e a sud dei tropici si estende l’area dei grandi deserti, caratterizzata da precipitazioni annue scarse e irregolari e da elevate escursioni termiche giornaliere. La maggior parte sono deserti caldi, come il deserto del Sahara, in Africa, ma esistono anche deserti freddi a latitudini più elevate, come il deserto del Gobi, in Asia centrale. In questo ambiente così inospitale vivono piante grasse e animali in grado di sopportare condizioni climatiche estreme: rettili, ragni e insetti, e qualche mammifero come il fennec, il topo canguro, il dromedario e il cammello.
■ LA SAVANA
L’ambiente della savana è caratterizzato da un’ampia prateria erbosa, localizzata in Africa, America e Australia. Le precipitazioni si concentrano in due periodi dell’anno, corrispondenti alla stagione primaverile e autunnale. Nella savana africana vivono grossi erbivori come bufali, giraffe, zebre e antilopi, e i loro predatori, leoni, ghepardi e leopardi. Le savane, in particolare quella africana, sono interessate da imponenti migrazioni di milioni di erbivori, come gli gnu, che seguono le piogge da una zona all’altra, preferendo le erbe fresche a quelle secche.
■ LA FORESTA TROPICALE
È il bioma tipico delle regioni equatoriali, dove c’è un’unica stagione calda e le precipitazioni sono abbondanti per tutto l’anno. Le foreste tropicali più diffuse sono le foreste pluviali come la foresta amazzonica nell’America Meridionale, le foreste che occupano i bacini del Congo, del Niger e dello Zambesi in Africa, le foreste che coprono buona parte dell’India, del Madagascar, dell’Indocina, dell’Indonesia, del Borneo e della Nuova Guinea in Asia, e quelle che crescono nelle regioni orientali dell’Australia. Sugli alberi vivono moltissime specie di uccelli, insetti e scimmie, mentre il sottobosco ospita rane, serpenti, piccoli invertebrati, funghi e organismi decompositori. Nei climi monsonici, dove si alternano una stagione secca e una stagione di piogge abbondanti, la vegetazione tipica è quella della giungla, un insieme fitto di piante palustri, piante rampicanti, cespugli e alberi. È questo l’ambiente dove vive il più grande dei felini, la tigre. Le foreste tropicali sono caratterizzate da elevata biodiversità animale e vegetale, ma sono fra gli ambienti più minacciati dalla deforestazione a causa dello sfruttamento per ricavarne legname pregiato e dell’abbattimento degli alberi per estrarre le ricchezze minerarie presenti nel sottosuolo.
FISSA I CONTENUTI ESSENZIALI
Segna con una crocetta se è vero (V) o falso (F).
1. Il bioma è l’insieme di tutti gli ecosistemi della Terra.
2. Il bioma polare è dominato dai ghiacci e dalle nevi perenni.
3. La taiga è un bioma di clima tropicale.
4. La macchia mediterranea si trova solo intorno al Mar Mediterraneo.



5. Gli organismi del deserto hanno strutture adattate alla mancanza d’acqua.
6. La foresta pluviale si trova prevalentemente nelle zone equatoriali.
DESERTO SAVANA
FORESTA TROPICALE
I biomi ACQUATICI lezione 5
CARTA PENNA COMPUTER

1 Le acque del lago Natron nell’Africa orientale hanno pH = 9.

Guarda il video e scrivi le risposte sul quaderno.

Gli abitanti del mare
1. Quali sono le caratteristiche della zona fotica?
2. Perché la zona fotica è la maggiore produttrice dell’ossigeno terrestre?
3. Quali organismi vivono nella zona mesopelagica?
4. Qual è la differenza tra plancton e necton?
5. Quali tipi di adattamenti presentano gli organismi che vivono a grandi profondità?
6. Quali sono i fattori abiotici della zona pelagica?
1 La componente abiotica dei biomi acquatici
I biomi acquatici ricoprono quasi il 75% della superficie del Pianeta. Sono stati i primi biomi a comparire sulla Terra e sono alla base della vita di tutta la biosfera grazie alla fotosintesi compiuta dai cianobatteri, tra i principali costituenti del plancton
All’interno dei biomi acquatici le condizioni variano in funzione di diversi fattori abiotici:
• la luce rappresenta la fonte di energia principale degli ecosistemi perché è alla base della fotosintesi del fitoplancton, delle alghe, come il kelp, e delle piante acquatiche come la posidonia;
• la temperatura nei biomi acquatici varia in modo estremo, dalle fredde acque delle regioni polari a quelle calde delle regioni equatoriali. Molti organismi sopportano variazioni di temperatura molto limitate, come le foche che vivono nelle regioni polari e subpolari, mentre altri, come le balenottere, trascorrono una parte dell’anno nelle acque calde tropicali e una parte nelle acque polari;
• la pressione idrostatica aumenta con la profondità di 1 atm ogni 10 m. La maggior parte degli organismi sopporta piccole variazioni di pressione, mentre gli animali che vivono negli abissi hanno un corpo adattato a pressioni elevatissime;
• la salinità dipende dal contenuto di sali disciolti nell’acqua: quasi tutti gli organismi sopravvivono solo in condizioni di salinità costante, come i coralli, ma esistono anche pesci adattati a vivere sia in acque dolci sia in acque salate, come salmoni e anguille;
• la disponibilità di ossigeno disciolto nelle acque influenza notevolmente la vita animale. Alcuni pesci, come le trote di fiume, possono vivere solo in acque ricche di ossigeno, mentre altri, come i pesci gatto, riescono a sopravvivere in condizioni di ossigeno carente perché sono in grado di recuperarlo direttamente dall’aria;
• il pH dei biomi marini varia tra 7,5 e 8,5 a seconda della salinità, mentre quello dei biomi d’acqua dolce varia tra 6 e 8, a seconda delle condizioni locali. In alcune aree lagunari o in alcuni laghi, il pH è così elevato da rendere le acque altamente alcaline: una simile condizione può essere sopportata solo da alcuni organismi, principalmente batteri, ma anche da alcune specie di uccelli come i fenicotteri 1
La ricerca di Hasler
Altri fattori che influenzano i biomi acquatici sono i movimenti delle acque, l’azione delle correnti superficiali e profonde, ma anche il vento, che può causare tempeste e altri fenomeni meteorologici in grado di sconvolgere gli ambienti acquatici.
I biomi acquatici comprendono il ne tra i due non esistano confini netti.
2
Il bioma marino
In base alla profondità raggiunta dalla luce, il bioma marino è suddi viso in due zone: la (“ben illuminata”), che si estende dalla superficie fino a 200 m di profondità, corrispondente al limi te di penetrazione della luce, e la zona afotica
si estende da 200 m fino alle pro fondità abissali, dove non possono vivere organismi fotosintetici a causa dell’assenza di luce
Inoltre, si possono distinguere altre tre zone in funzione della posizione rispetto alla costa: la gico e il questi domini vivono diverse comunità di or ganismi.

Esiste davvero la seta di mare?
La seta di mare, o bisso marino, è un tessuto molto pregiato realizzato con una fibra proteica prodotta dalla Pinna nobilis, conosciuta anche come nacchera di mare, pinna comune o cozza penna. È il più grande bivalve del Mediterraneo: vive parzialmente infossata nei sedimenti del fondale marino ancorandosi tramite un fascio di filamenti di bisso, simile a quelli prodotti dalle comuni cozze. Un tempo questi filamenti venivano raccolti con cura e trasformati in fili sottilissimi attraverso un lungo ed elaborato processo. L’estrema leggerezza e impalpabilità, la lucentezza iridescente e la straordinaria resistenza hanno fatto del bisso marino un simbolo di ricchezza e potere. Per millenni questo tessuto venuto dal mare fu considerato un materiale prezioso utilizzato da egizi, greci e romani per tessuti di lusso, vesti sacerdotali e oggetti di grande valore.


■ LE COMUNITÀ DELLA ZONA COSTIERA
Gli ambienti principali sono il substrato roccioso e la spiaggia, di sabbia o ciottoli, laghi salmastri e estuari. Sono abitati da organismi che si muovono e nuotano, che costituiscono il necton, e da organismi sessili, che fanno parte del bentos Il substrato roccioso è un ambiente difficile perché è soggetto a escursioni di marea, che lasciano asciutta la roccia per ore, a escursioni termiche e alla forza dirompente delle onde. Gli organismi che abitano in queste aree, come alghe, gasteropodi, bivalvi, hanno sviluppato modi ingegnosi di restare attaccati alla roccia, mediante muscoli che agiscono come ventose, colle speciali o filamenti ad alta resistenza. Gli organismi mobili, come i granchi o i pesci, si spostano velocemente e sfruttano ogni piccolo anfratto per ripararsi.
Le spiagge sabbiose o a ciottoli sono sottoposte alla continua azione abrasiva prodotta dal moto ondoso e dai frammenti di roccia trasportati dall’acqua. Il nutrimento è in sospensione: molti bivalvi e vermi che vivono immersi nella sabbia, hanno sviluppato tecniche di sopravvivenza che permettono loro di prosperare. In questi ambienti la biodiversità è ridotta.
I laghi salmastri hanno una salinità diversa da quella marina: minore, se sono alimentati da flussi d’acqua dolce, decisamente maggiore, come nel caso delle saline naturali. Nei laghi salmastri vivono numerose specie di animali che sono in grado di adattarsi alle variazioni di salinità, dai molluschi, agli artropodi, fino ai vertebrati come i pesci. Nelle acque delle saline possono vivere microrganismi alofili, cioè che resistono all’alta concentrazione salina. Comunità simili di organismi vivono negli ambienti di estuario che sono soggetti al flusso di marea e alle piene fluviali.
■ LE COMUNITÀ DEL DOMINIO PELAGICO
La maggior parte della biodiversità marina si concentra nella zona eufotica, cioè nei primi duecento metri di profondità. Le comunità biologiche principali sono le comunità algali, le barriere coralline e il plancton.
Per comunità algali si intendono tutte quelle distese di alghe, come il kelp, o di piante acquatiche, come la posidonia, che creano habitat fluttuanti adatti alla vita di moltissime specie. Sono comunità con un equilibrio delicato: per esempio, la scomparsa delle lontre marine, sterminate dalla caccia, ha provocato la drastica riduzione di intere distese di kelp, che sono state divorate dai ricci di mare 3 .

Le barriere coralline costituiscono il luogo con la più elevata biodiversità del Pianeta. Le principali sono la grande barriera corallina australiana, la sequenza di barriere del Mar Rosso, moltissimi atolli e barriere minori sparsi in Polinesia, nell’Oceano Indiano e ai Caraibi. Le barriere coralline sono i luoghi di riproduzione per gran parte degli organismi marini. Si tratta, tuttavia, di ambienti molto delicati e in forte crisi a causa dell’aumento della temperatura globale, dell’innalzamento del livello dei mari e dell’inquinamento.
Il plancton costituisce la più grande biomassa della Terra. È formato da specie che sono trasportate principalmente dalle correnti marine: la parola greca plancton significa, infatti, errante. Il plancton è composto da fitoplancton, costituito da cianobatteri e altri organismi fotosintetici, e da zooplancton 4 , formato da larve, piccoli crostacei e meduse. Nel plancton fluttuano anche organismi pluricellulari come il krill o le larve di invertebrati e pesci che di plancton si cibano.
■ LE COMUNITÀ DEL DOMINIO BENTONICO
4 Piccoli crostacei che formano lo zooplancton.

Il dominio bentonico è popolato dal bentos, costituito da organismi che vivono fissati a un substrato o sono a contatto diretto con il fondale marino: il termine greco bentos significa, infatti, abisso. Sono organismi bentonici, per esempio, spugne, coralli, alghe e molluschi. Delle comunità bentoniche che vivono nelle profondità oceaniche sappiamo ancora poco, anche se le esplorazioni degli abissi compiute con i robot sottomarini abissali ci hanno rivelato l’esistenza di veri e propri ecosistemi che ospitano organismi che non dipendono dalla luce e si cibano dei resti di organismi che precipitano sul fondo dalla zona eufotica 5 .
3 I biomi d’acqua dolce
I biomi di acqua dolce sono costituiti dalle acque interne ai continenti e ricoprono circa il 2% della superficie del nostro Pianeta. Le tipologie principali sono due: i biomi di acqua ferma, di cui fanno parte i laghi, gli stagni, le paludi, e i biomi di acqua corrente, come fiumi, torrenti, ruscelli, sorgenti. Come nei biomi marini, anche in questi biomi di stinguiamo il plancton, formato da alghe microscopiche e microrganismi, il necton, costituito da pesci e crostacei come i gamberi d’acqua dolce, il bentos, che comprende polipi, come le idre, e bivalvi, come quelli che appartengono al genere Unio
FISSA I CONTENUTI ESSENZIALI
Abbina i termini con la definizione corretta.
1 Biomi acquatici
2 Pressione idrostatica
3 Microrganismi alofili
4 Comunità algali
5 Biomi di acqua corrente
5 Organismi che vivono a stretto contatto con il fondale marino.

a Organismi che resistono all’alta concentrazione salina.
b Distese di alghe, come il kelp, o di piante acquatiche, come la posidonia, che creano habitat fluttuanti.
c Comprendono fiumi, torrenti, ruscelli, sorgenti.
d Ricoprono quasi il 75% della superficie del Pianeta.
e Aumenta con la profondità di 1 atm ogni 10 m.
1: 2: 3: 4: 5:
CARTA PENNA COMPUTER DI

Rischi climatici
CIVICA
Il cambiamento climatico e gli effetti sulla biosfera
Esplora l’oggetto interattivo e scrivi le risposte sul quaderno.
1. Quali animali risentirebbero maggiormente dell’innalzamento di 2 °C della temperatura terrestre?
2. Che cosa rischiano gli oceani con l’aumento delle temperature terrestri?
3. Quali potrebbero essere gli effetti più gravi del riscaldamento globale per la popolazione umana?
Metti in pausa il video nei seguenti punti.


4. Dai un titolo ai due disegni e descrivi i fenomeni che rappresentano.
1 Il cambiamento climatico
Negli ultimi due secoli, lo sviluppo delle attività umane e l’uso sempre maggiore delle macchine hanno provocato un progressivo aumento delle concentrazioni atmosferiche dei gas serra, in particolare dell’anidride carbonica e del metano.
Attività umane indiscriminate, come la deforestazione, lo sfruttamento del suolo e l’impiego di combustibili fossili, hanno alterato la naturale capacità della Terra di far rientrare l’eccesso di anidride carbonica all’interno del ciclo naturale del carbonio, che reagisce cercando di raggiungere un nuovo equilibrio. Il tempo necessario perché il ciclo riesca a trovare un nuovo equilibrio varia in base a quanto velocemente cresce la concentrazione dei gas serra in atmosfera e oggi, purtroppo, le emissioni continuano ad aumentare, soprattutto nei paesi con economie emergenti.
La conseguenza più grave del fenomeno è il progressivo aumento della temperatura del Pianeta. Il riscaldamento globale, o Global Warming, è la causa principale del cambiamento climatico che interessa l’intero pianeta.
L’IPCC (Intergovernmental Panel on Climate Change), il gruppo di lavoro formato da scienziati di tutto il mondo, ha proposto una definizione di cambiamento climatico.
Il cambiamento climatico è un cambiamento dello stato del clima che può essere identificato (per esempio, utilizzando dati statistici) rispetto a cambiamenti nella media e/o nella variabilità delle sue proprietà.
ORA FERMA L’IMMAGINE!
Questa definizione è un po’ complessa, ma indica che il clima è un sistema che cambia continuamente e si modifica nel tempo. Gli scienziati tengono sotto controllo costantemente le concentrazioni dell’anidride carbonica nell’atmosfera, i valori delle temperature e la frequenza con cui avvengono fenomeni meteorologici estremi come, per esempio, periodi prolungati di siccità o, al contrario, di precipitazioni intense, in modo da raccogliere dati attendibili sul cambiamento dei climi della Terra che, a loro volta, influiscono direttamente sulle condizioni dei diversi biomi 1
■ LE COP
A partire dagli anni Novanta del secolo scorso la comunità internazionale ha cominciato a prendere atto del Global Warming e del cambiamento climatico: nel 1992, durante la Conferenza sull’Ambiente e sullo Sviluppo tenutasi a Rio de Janeiro, in Brasile, fu firmata la Convenzione Quadro delle Nazioni Unite sui Cambiamenti Climatici, il principale trattato ambientale internazionale in materia di contrasto ai cambiamenti climatici. In quella occasione si stabilì che ogni anno i paesi che avevano aderito al trattato partecipassero a una conferenza annuale, la COP, o Conferenza delle Parti, per unire i loro sforzi nel contrastare il cambiamento climatico e i suoi dannosi effetti. La prima Conferenza delle Parti, la COP1, si tenne a Berlino nel 1995: da allora le COP che si sono succedute ogni anno hanno definito metodi e procedure per ridurre le emissioni di gas serra. Per esempio, durante la COP27 del 2022, è stato ribadito l’intento di contenere l’aumento della temperatura entro 1,5 °C rispetto al periodo precedente all’avvento dell’industrializzazione; inoltre, è stato istituito un fondo internazionale per prevenire, minimizzare e affrontare le perdite e i danni associati agli effetti negativi dei cambiamenti climatici.
2 L’importanza della biodiversità
Il termine biodiversità è stato coniato nel 1985 dall’unione di due parole, diversità biologica
Con il termine biodiversità si indica la molteplicità di organismi viventi sul nostro pianeta, le loro relazioni e gli habitat in cui vivono.
La biodiversità può essere paragonata alla struttura che sostiene tutta la vita sulla Terra e che permette il funzionamento stabile ed equilibrato dell’atmosfera, dell’idrosfera e delle foreste.
Nel mondo sono state descritte circa 2 milioni di specie animali e vegetali, ma si ipotizza che negli habitat più inaccessibili, come le foreste tropicali e gli abissi marini, ci siano ancora molte specie da scoprire, il che porterebbe il numero totale a circa 10 milioni. Se da un lato abbiamo ancora molta biodiversità da scoprire, dall’altro ne perdiamo una buona parte ogni giorno. Le cause di questo fenomeno sono numerose: la distruzione e la frammentazione degli habitat naturali, l’inquinamento, la caccia, l’introduzione negli ambienti naturali di specie provenienti da altri habitat, le cosiddette “specie aliene”; tra tutte queste, però, il cambiamento climatico è la causa più grave. Nell’insieme, questi fattori stanno provocando la progressiva scomparsa delle specie viventi e quindi la perdita di biodiversità mondiale.
Nell’Agenda 2030, gli obiettivi dedicati alla conservazione della biodiversità sono ben tre: il n. 13, che prevede il contrasto ai cambiamenti climatici, il n. 14 e il n. 15, relativi alla conservazione della fauna e della flora negli ecosistemi acquatici e terrestri.
1 Nell’osservatorio meteorologico di Mauna Loa, dal 1958 si raccolgono i dati sulla concentrazione di CO2 nell’atmosfera.

Nord America, Centro America e Antille
2 Messico e America centrale
3 Caraibi
8 Provincia Floristica della California
26 Madrean pine-oak woodlands
Sudamerica
1 Ande tropicali
4 Foresta costiera del Brasile
5 Isole Galapagos ed Ecuador
6 Foresta amazzonica del Brasile
7 Cile centrale
Eurasia
14 Bacino del Mediterraneo
15 Caucaso
16 Malacca e Indonesia occidentale
17 Indonesia orientale
18 Filippine
19 Sud est Asia
20 Montagne della Cina sud-orientale
21 Sri Lanka e monti Ghati occidentali
30 Iran e Anatolia
31 Est dell’Himalaya
32 Zona tra l’India e la Cina
33 Giappone
Africa
9 Madagascar e isole dell’Oceano Indiano
10 Zona forestale della costa orientale dell’Africa
11 Foreste della Guinea
12 Regione floristica del Capo
13 Karoo succulento, regione desertica tra il Sudafrica e la Namibia
27 Regione del Maputaland-PondolandAlbany
28 Zone afromontane dell’est dell’Africa
29 Corno d’Africa
Oceania
22 Australia sud-occidentale
23 Nuova Caledonia
24 Nuova Zelanda
25 Oceania
34 Isole della Malesia 2 I punti caldi mondiali.
Gli studi di ecologia dimostrano che un ecosistema ricco di specie diverse è molto più stabile degli ecosistemi poveri di organismi, ed è anche più resiliente, cioè è in grado di tornare allo stato originario anche dopo episodi di distruzione come fenomeni meteorologici violenti, incendi o attacchi di parassiti.
La biodiversità, inoltre, è anche una fonte di beni, risorse e servizi, i cosiddetti servizi ecosistemici di cui beneficiano, direttamente o indirettamente, non solo le comunità umane, ma anche quelle animali e vegetali.
Per esempio, le specie selvatiche parenti di quelle domestiche sono un vero e proprio serbatoio di geni e possono essere sfruttate per difendere le piante dai parassiti o da ondate di caldo o siccità.
La perdita di biodiversità contribuisce all’insicurezza alimentare ed energetica, aumenta la vulnerabilità ai disastri naturali, diminuisce il livello della salute all’interno della società, riduce la disponibilità e la qualità delle risorse idriche.
3 I punti caldi di biodiversità
La biodiversità non è la stessa in tutti gli ecosistemi del Pianeta: i fattori geografici, climatici e morfologici rendono alcune aree della Terra più adatte a ospitare una grande varietà di organismi rispetto ad altre. Queste aree sono chiamate hotspot, punti caldi di biodiversità 2
Un punto caldo di biodiversità è una regione ricca di biodiversità e contemporaneamente fortemente minacciata dai cambiamenti climatici, dall’alterazione degli habitat e dalla perdita delle relative specie vegetali e animali.
Per identificare un luogo come punto caldo devono essere rispettati due criteri:
• deve contenere almeno 1500 specie endemiche, cioè specie che non si trovano in nessun altro luogo del Pianeta;
• deve avere perso almeno il 70% della sua vegetazione originaria.

Il primo a utilizzare questo termine fu lo scienziato Norman Myers nel 1988: inizialmente identificò solo 8 punti caldi sulla Terra, che poi divennero 25 e oggi sono 34. Queste zone rappresentano circa il 2,4% della superficie terrestre, ma ospitano più della metà delle specie vegetali endemiche e circa il 43% delle specie di uccelli, mammiferi, rettili e anfibi, anch’esse endemiche.
Purtroppo i punti caldi sono anche le aree più colpite dagli effetti del cambiamento climatico: danneggiare i punti caldi di biodiversità vuol dire aumentare il rischio di estinzione delle specie.
4 Biomi che migrano
Le trasformazioni ambientali conseguenza del cambiamento climatico hanno gravi conseguenze sugli esseri viventi, in particolare sulla vegetazione, che reagisce modificandosi e provocando un fenomeno chiamato migrazione dei biomi. Con questa espressione si indica lo spostamento dei biomi da zone più calde verso zone più fresche. Per esempio, il limite delle nevi perenni sulle montagne si sta spostando sempre più in quota, cosicché anche gli alberi, in particolare le conifere, raggiungono altitudini sempre maggiori. Anche gli animali si trovano ad affrontare nuove sfide per la sopravvivenza. Basta pensare all’orso polare, che non riesce più a cacciare le foche nelle distese di ghiaccio marino delle regioni polari e cerca prede terrestri spostandosi verso i ghiacciai perenni 3
Anche la distribuzione dei biomi marini sta cambiando. L’innalzamento della temperatura provoca l’aumento della salinità delle acque marine, un fattore che altera la distribuzione del krill e, di conseguenza, quella dei cetacei che si nutrono di questi minuscoli crostacei.

FISSA I CONTENUTI ESSENZIALI
Segna con una crocetta se vero (V) o falso (F).
1. L’IPCC è l’organizzazione scientifica che studia il cambiamento climatico.
2. Il riscaldamento globale non influisce sulle caratteristiche degli ecosistemi.
3. La ricchezza di biodiversità riduce la resilienza di un ecosistema.

Criosfera in pericolo
3 La sopravvivenza dell’orso polare è strettamente legata all’ecosistema dell’Artico.
4. I punti caldi sono regioni ricche di biodiversità. F V F V F V F V
CON LA SINTESI
lezione 1 DALL’AMBIENTE ALL’ECOSISTEMA
L’ecologia è la scienza che studia le relazioni che si instaurano tra gli organismi e l’ambiente nel quale vivono. L’ambiente è caratterizzato da fattori abiotici, come acqua, luce e temperatura, e da fattori biotici, che comprendono tutti gli organismi che vivono nello stesso luogo e le relazioni che li legano. Alcuni fattori ambientali, chiamati fattori limitanti, rallentano o impediscono la sopravvivenza degli organismi. L’insieme degli organismi e l’ambiente fisico con il quale interagiscono formano l’ecosistema. In ogni ecosistema si riconoscono numerosi habitat, cioè spazi in cui le condizioni ambientali sono adatte alla sopravvivenza di una particolare specie. La nicchia ecologica è il ruolo che una specie assume nel proprio habitat e il modo in cui essa sfrutta le risorse dell’ambiente. Gli organismi di una stessa specie formano una popolazione; popolazioni di specie diverse che vivono nello stesso luogo formano una comunità
lezione 2 COME FUNZIONA UN ECOSISTEMA
Le principali relazioni che si stabiliscono tra gli organismi sono quelle alimentari. In un ecosistema gli autotrofi costituiscono gli organismi produttori, mentre gli eterotrofi costituiscono gli organismi consumatori. I consumatori che si cibano direttamente dei produttori sono gli erbivori, mentre quelli che si nutrono di altri consumatori sono i carnivori. I saprofagi si cibano dei residui degli organismi morti. I funghi e i batteri sono organismi eterotrofi decompositori che trasformano le sostanze organiche in sostanze inorganiche. Le relazioni alimentari che legano gli organismi di un ecosistema sono dette catene alimentari; esse si intrecciano a formare una rete alimentare.
lezione 3 LE RELAZIONI TRA GLI ORGANISMI

Livello trofico Esempi di organismi Energia (kcal) consumatori terziari consumatori secondari consumatori primari produttori





La simbiosi è una relazione permanente tra specie diverse. Il parassitismo è una simbiosi tra due specie nella quale una ricava un vantaggio e l’altra è danneggiata. Nel commensalismo specie diverse vivono a stretto contatto ma solo una ne trae vantaggio senza che l’altra ne venga danneggiata; nel mutualismo entrambe le specie ricavano beneficio dalla relazione. Il mimetismo è la capacità di un organismo di confondersi con un elemento naturale o con un altro organismo per sfuggire ai predatori o per catturare le prede.


lezione 4 I BIOMI TERRESTRI
La biosfera è l’insieme di tutti gli ecosistemi della Terra. I biomi sono l’associazione delle comunità vegetali e animali che caratterizzano determinate aree geografiche con particolari condizioni ambientali. L’estensione dei biomi è determinata dal clima. I biomi dei climi freddi sono il bioma polare, la tundra, la taiga. I biomi dei climi temperati sono la foresta temperata, la macchia mediterranea, la prateria. I biomi dei climi caldi sono il deserto, la savana, la foresta tropicale.
lezione 5 I BIOMI ACQUATICI
I biomi acquatici comprendono il bioma marino e il bioma d’acqua dolce. Nei biomi acquatici i fattori limitanti sono la luce, la temperatura, la pressione idrostatica, la salinità, il pH e la disponibilità di ossigeno. Gli organismi dei biomi acquatici si distinguono in plancton, formato da specie che vengono trasportate dalle correnti marine, necton, costituito da organismi che si muovono e nuotano, e bentos, costituito da organismi sessili. In base alla profondità il bioma marino è suddiviso nella zona eufotica, che si estende dalla superficie fino a 200 m di profondità, e nella zona afotica, che si estende da 200 m fino alle profondità abissali.
lezione 6 EDUCAZIONE CIVICA
IL CAMBIAMENTO CLIMATICO E GLI EFFETTI SULLA BIOSFERA
Lo sviluppo delle attività umane ha prodotto un forte aumento delle concentrazioni di anidride carbonica e di altri gas serra nell’atmosfera terrestre. Ciò ha determinato il fenomeno del riscaldamento globale, responsabile a sua volta del cambiamento climatico in atto. Le variazioni della temperatura e del clima sono monitorate costantemente dagli scienziati dell’IPCC. Sulla base di questi dati sono prese le decisioni durante le COP, le conferenze annuali delle nazioni per il contrasto al cambiamento climatico e ai suoi effetti. La biodiversità, la molteplicità di organismi viventi e le loro relazioni e in particolare i punti caldi sono minacciati dal cambiamento climatico, dall’inquinamento e dalla distruzione degli habitat delle specie vegetali e animali.



CON LA MAPPA
Adesso che hai ripassato i contenuti essenziali con la sintesi, prova a completare la mappa con le parole chiave suggerite e a trovare le definizioni corrispondenti.
ambiente - biomi - commensalismo - parassitismo - prateria - terrestri
1. GLI ECOSISTEMI
che possono stabilire tra loro relazioni di tipo
10. simbiotico
8. organismi sono il risultato delle interazioni tra gli
e il loro
2. biosfera
che comprende diversi
che comprendono come

12. mutualismo
distinti in

a. Relazione simbiotica tra due specie diverse nella quale una trae vantaggio e l’altra è danneggiata.
b. È formata dall’insieme di tutti gli ecosistemi.
c. Possono essere biomi d’acqua dolce e salata.
d. Bioma costituito da vaste foreste di conifere.
5. acquatici
7. taiga fanno parte della
FISSA I CONTENUTI ESSENZIALI
lezione 1 DALL’AMBIENTE ALL’ECOSISTEMA
1 Segna con una crocetta se vero (V) o falso (F).
a. L’ecologia è la scienza che studia le relazioni che si instaurano tra gli organismi e l’ambiente nel quale vivono.
b. I fattori limitanti sono fattori che rallentano o impediscono la sopravvivenza degli organismi.
c. L’ecosistema è il particolare tipo di ambiente in cui vive ciascun organismo.
d. Gli organismi di una stessa specie che vivono nello stesso luogo formano una nicchia ecologica.
2 Scegli la soluzione corretta.
a. Tutti gli elementi non viventi di un ambiente sono definiti fattori:
1 fisici.
2 biologici.
3 biotici.
4 abiotici.
b. La concentrazione di ossigeno nell’ambiente acquatico è:
1 un fattore biologico.
2 necessaria per tutti gli organismi.
3 un fattore limitante.
4 un falso fattore limitante.
c. Gli organismi di una stessa specie che vivono nello stesso luogo formano una:
1 popolazione.
2 nicchia ecologica.
3 habitat.
4 ecosistema.
lezione 2 COME FUNZIONA UN ECOSISTEMA
3 Sottolinea il termine corretto tra i due proposti.
a. I vegetali sono in grado di trasformare le sostanze inorganiche in sostanze inorganiche/organiche

b. Gli organismi autotrofi/eterotrofi che si nutrono delle sostanze organiche già fabbricate da altri organismi costituiscono gli organismi consumatori.
c. Il motore del ciclo dell’acqua è l’energia solare/biochimica.
4 Abbina i termini con la definizione corretta.
1. Organismi produttori
2. Rete alimentare
3. Piramide dell’energia
4. Ciclo dell’acqua
5. Ciclo dell’azoto
a Circolazione dell’acqua attraverso l’intero sistema Terra.
b Producono sostanze organiche a partire da sostanze inorganiche.
c Rappresentazione dell’energia che passa da un livello trofico all’altro.
d Ciclo biogeochimico.
e Intreccio di diverse catene alimentari.
lezione 3 LE RELAZIONI
TRA GLI ORGANISMI
5 Segna con una crocetta se vero (V) o falso (F).
a. La predazione è un tipo di relazione alimentare in cui un produttore cattura una preda e se ne nutre.
b. Il parassitismo è una simbiosi tra due specie diverse nella quale una ricava vantaggio e l’altra è danneggiata.
c. Il mimetismo criptico è una simbiosi tra due specie diverse, nella quale entrambe ricavano beneficio.
d. Il mutualismo è un comportamento per rendersi invisibile alla preda o al predatore.
e. Nel mimetismo batesiano individui innocui assumono le colorazioni o l’aspetto di organismi pericolosi.
1. 2. 3. 4. 5.
lezione 4 I BIOMI TERRESTRI
6 Scegli la soluzione corretta.
a. Le associazioni delle comunità vegetali e animali che caratterizzano determinate aree geografiche con particolari condizioni ambientali si chiamano:
1 biosfera.
2 biomi.
3 clima.
4 taiga.
b. L’ambiente che si estende a latitudini comprese fra 75° di latitudine Nord e il circolo polare artico (66° 33’ N) è:
1 il bioma polare.
2 la taiga.
3 la tundra artica.
4 il bioma mediterraneo.
7 Inserisci accanto al nome del bioma il numero dell’immagine corrispondente.



a. Foresta temperata
b. Tundra artica
c. Macchia mediterranea
d. Taiga
e. Bioma polare


lezione 5 I BIOMI ACQUATICI
8 Segna con una crocetta se vero (V) o falso (F).
a. I biomi di acque ferme fanno parte dei biomi di acqua dolce.
b. Le idre sono organismi sessili.
c. La parola plancton significa “abisso”.
d. I microrganismi alofili resistono ad alte concentrazioni di sali.
9 Abbina i termini con la definizione corretta.
1. Habitat fluttuanti
2. Zona eufotica
3. Laghi salmastri
4. Barriere coralline
a Luoghi con la più elevata biodiversità del pianeta.
b Distese di alghe, come il kelp, o di piante acquatiche, come la posidonia.
c Si estende dalla superficie fino a 200 m di profondità, corrispondente al limite di penetrazione della luce.
d Laghi con salinità inferiore a quella marina al cui interno vivono organismi alofili.
1. 2. 3. 4.
lezione 6 IL CAMBIAMENTO CLIMATICO E GLI EFFETTI SULLA BIOSFERA
10 Completa le frasi con i termini corretti.
a. La racchiude la molteplicità degli organismi viventi sulla Terra e i loro habitat.
b. I biomi sono suddivisi in biomi marini e biomi d’acqua dolce.
c. I biomi risentono negativamente del provocato dal riscaldamento globale.
d. I sono regioni con elevata biodiversità.
INDIVIDUARE CARATTERISTICHE E SPIEGARE
1 Attribuisci il titolo corretto alle fotografie e rispondi alle domande.

Quali sono i produttori rappresentati nell’immagine?
Quali sono i predatori in cima alla rete alimentare descritta?

1 2 3

a. Xerofite, piante adattate ai climi aridi.
b. Idrofite, piante adattate nei climi umidi.
c. Piante acquatiche con foglie idrorepellenti.
Quali tipi di adattamenti hanno sviluppato le piante che vivono in ambienti aridi?
3 Osserva il grafico e rispondi.
I paesi europei hanno stabilito una serie di interventi per la corretta gestione dei rifiuti secondo uno schema di priorità rappresentato da questo triangolo.
RIUTILIZZO PREVENZIONE
Quali caratteristiche presentano le piante degli ambienti umidi?
Perché l’acqua è un fattore abiotico limitante?

RECUPERO ENERGETICO RICICLAGGIO
SMALTIMENTO (discarica)
INTERPRETARE UN MODELLO
2 Osserva la rete alimentare e rispondi alle domande.
Spiega perché gli interventi proposti nel triangolo hanno queste posizioni, perché la punta del triangolo è verso il basso e quali sono i comportamenti migliori per ridurre il più possibile i rifiuti.
OSSERVARE E RIFLETTERE
4 Osserva le immagini e rispondi alle domande.





Quale rapporto alimentare è rappresentato nell’immagine a?
Quale rapporto alimentare è rappresentato nell’immagine b?
Quale meccanismo di difesa è rappresentato nell’immagine c?
Quale rapporto alimentare è rappresentato nell’immagine d?
Quale rapporto alimentare è rappresentato nell’immagine e?
INTERPRETARE E TRARRE INFORMAZIONI
DA UN TESTO
5 Leggi il brano.
LE PIANTE ASSORBONO CO2, MA FINO A QUANDO?
Dall’inizio della rivoluzione industriale a oggi, la quantità di CO2 immessa nell’atmosfera dalle attività umane è aumentata drasticamente. In modo analogo, è aumentata la fotosintesi, di ben il 30%: le piante sono diventate più grandi, così come è aumentata la dimensione degli stomi presenti sulle foglie.
«Le piante terrestri stanno rimuovendo circa il 29% delle nostre emissioni che, se ciò non avvenisse, porterebbero a un’ulteriore crescita della concentrazione di CO2 in atmosfera. Esistono prove del fatto che gli alberi hanno più foglie e che c’è più legna», dice uno degli autori della ricerca. «E la legna è proprio il posto dove va a finire la maggior parte della CO2 assorbita dalle piante.» Nel corso di alcuni esperimenti le piante sono state esposte al doppio dell’anidride carbonica a cui erano abituate di norma. In condizioni così drasticamente diverse di CO2, la composizione dei tessuti delle foglie cambia leggermente: per gli erbivori diventa più difficile mangiarle e per le larve crescerci. Grazie all’azione delle piante l’innalzamento della temperatura del pianeta è ancora sotto controllo ma esiste un limite, ammoniscono gli scienziati: a un certo punto anche le piante non saranno più in grado di aiutarci.
(Adattato da National Geographic Italia) Rispondi alle domande.
1. In che modo le piante contribuiscono a ridurre la CO2 presente nell’atmosfera?
2. Perché viene citata la rivoluzione industriale?
3. Che cosa succede alle piante esposte a livelli elevati di CO2?
4. Perché l’eccesso di CO2 nell’atmosfera può favorire la crescita delle piante?
5. Dall’inizio della rivoluzione industriale la concentrazione media annua di CO2 nell’atmosfera è passata dalle 280 parti per milione (ppm) alle attuali 411 ppm. Quali sono i principali fattori responsabili di questo incremento?


THE CONNECTION
BETWEEN FORESTS AND SALMON POPULATIONS
British Columbia is home to five species of Pacific salmon. These salmon are anadromous, which means they hatch from eggs in freshwater streams and rivers, migrate to the ocean, where they mature into adults, and then return to where they started life, to spawn. This unique life cycle ties Pacific salmon to the health of the ocean and to the forests of Canada’s west coast. Researchers found that healthy forests support healthy fish populations. “Trees hold the stream banks together, provide shade over the stream, and create habitat for insects which the fish feed on. Then when big, old trees fall into a river they help to create pools and provide shelter and areas for fish to spawn.” The salmon in turn provide essential nutrients that fuel the growth of forest ecosystems. As salmon mature, they migrate from the streams and rivers of their youth to the ocean, where they feed on zooplankton, krill, and small fish. When adult salmon are ready to spawn, they migrate to the same freshwater rivers and streams where they were born. Here, the salmon spawn and die, and “spread these marine-derived nutrients throughout the watershed, feeding the forest” says Balfour, the director of the research group.
COMPREHENSION EXERCISES
Read the text and answer the questions.
a. What does anadromous mean?
b. Where do salmon reproduce?
c. Why do healthy forests support healthy fish populations?
d. What do salmon eat in the ocean?



HATCH uscire dall’uovo
SPAWN deporre uova
FUEL alimentare/rifornire
WATERSHED spartiacque lossario
L’etologia unità 8 VIVENTI
lezione 1
IL COMPORTAMENTO DEGLI ANIMALI
lezione 2
LE SOCIE tA ` ANIMALI
VISUAL


La danza delle api
LEZIONI POWERPOINT in


BUONE NOTIZIE PER IL FUTURO
Gli animali non sono oggetti!
Gli studi compiuti dagli etologi di tutto il mondo hanno messo in evidenza come gli animali siano esseri senzienti, cioè dotati della consapevolezza e dell’abilità mentale che li rendono capaci di provare emozioni simili alle nostre. Queste scoperte sono state all’origine dei numerosi movimenti civili per il benessere animale che hanno permesso di attuare delle leggi per la tutela degli animali selvatici, domestici e d’allevamento. della Costituzione italiana è stato modificato con l’introduzione di un nuovo contenuto per la salvaguardia degli animali come esseri senzienti. Le nuove parti di testo comprendono tutti gli animali, anche quelli allevati a scopo alimentare. Anche nei loro confronti la legge prevede che debbano essere rispettate le “cinque libertà” previste dalle norme dell’Unione Europea per la tutela del benessere animale: libertà dalla fame e dalla sete; libertà dai disagi ambientali; libertà dal dolore, dalle ferite e dalle malattie; libertà di manifestare comportamenti caratteristici della specie; libertà dalla paura e dallo stress. Il riconoscimento della tutela degli animali nella nostra Costituzione dimostra che è in atto un cambiamento di atteggiamento nei confronti della natura e nei prossimi anni sarà necessario aumentare gli sforzi perché le indicazioni di legge siano concretamente applicate.
Il comportamento degli animali lezione 1
CARTA PENNA COMPUTER

Il corteggiamento delle sule
Guarda il video e scrivi le risposte sul quaderno.
1. Dove vivono le sule?
2. In cosa consiste la loro alimentazione?
3. Come avviene il rito di corteggiamento?
4. Che cosa avviene dal momento della deposizione dell’uovo fino alla nascita del pulcino?
ORA FERMA L’IMMAGINE!
Metti in pausa il video nel seguente punto.
5. Spiega perché il colore delle zampe delle sule è importante nel rito di corteggiamento.
6. Illustra i vantaggi che offre la strategia delle sule di mantenere la coppia stabile.


I padri dell’etologia
DEBATE
ANIMALI DOMESTICI
ESOTICI
SKILL BOOK
1 L’etologia studia il comportamento degli animali
Per sopravvivere gli animali si procurano l’acqua e il cibo, si difendono con la lotta o con la fuga, si accoppiano (a volte dopo veri cerimoniali di corteggiamento), si riproducono, migrano quando le condizioni ambientali diventano sfavorevoli. Queste azioni, insieme a molte altre, costituiscono i comportamenti degli animali.
I comportamenti sono la risposta agli stimoli che l’animale riceve dall’ambiente in cui vive, come rumori, odori o i cambiamenti di temperatura e di luminosità, o dal suo stesso organismo, come la fame, la sete e il sonno.

L’etologia è la scienza che studia il comportamento degli animali.
2 Il comportamento innato
I comportamenti rappresentano delle vere forme di adattamento, senza le quali gli animali non potrebbero sopravvivere nel proprio ambiente.
I comportamenti che un animale possiede fin dalla nascita sono detti comportamenti innati o istinti
Gli animali mettono in atto questi comportamenti senza aver ricevuto alcun insegnamento né aver fatto pratica. I comportamenti innati sono
trasmessi da una generazione all’altra e caratterizzano ogni specie animale, distinguendola dalle altre. Mettono in atto comportamenti innati, per esempio, i ragni che tessono la tela, i cuccioli di mammifero che cercano la mammella della madre per succhiare il latte e il salmone che ritorna a deporre le uova nel luogo dove è nato. Gli etologi classificano i comportamenti innati in tre categorie: movimenti tattici, riflessi e schemi fissi d’azione 1 .

Movimenti tattici
Molti insetti notturni volteggiano istintivamente attorno a una sorgente di luce.
3
Riflessi
Quando sentiamo prurito, abbiamo il riflesso di grattarci.

Il comportamento appreso
1 Le categorie di comportamenti innati.

Schemi fissi d’azione Il riflesso di suzione di tutti i cuccioli di mammifero è un comportamento innato.
Tutti gli animali, in maniera più o meno elementare, sono in grado di imparare dall’esperienza.
Un comportamento appreso è fortemente influenzato dalle esperienze che l’animale fa durante la sua vita.
Il gatto che dà la caccia al topo, lo scimpanzé che usa un bastoncino per estrarre le termiti dal nido, il cane che accorre al richiamo del padrone sono alcuni esempi di comportamenti appresi.
Questo tipo di comportamento si verifica quando l’animale conserva il ricordo delle esperienze fatte e, in base a ciò, modifica il proprio comportamento, così da saper agire nel modo più adatto al momento opportuno.
Di solito i primi a insegnare comportamenti di questo tipo sono i genitori. Tra i mammiferi, specialmente quelli che vivono in gruppo, l’apprendimento può avvenire anche attraverso l’osservazione e l’imitazione di altri individui o con il gioco, in cui i giovani apprendono simulando situazioni reali.
L’apprendimento da parte degli animali può avvenire in modi diversi.
• L’apprendimento per assuefazione (cioè per abitudine) si verifica quando un animale impara a non reagire più a certi stimoli che si rivelano inutili. Alcuni uccelli, per esempio i passeri e i merli, imparano rapidamente a non temere lo spaventapasseri posto in mezzo ai campi per difendere le coltivazioni 2 .
2 Apprendimento per assuefazione.

Un topo introdotto in una gabbia con due porte, una nera e aperta dietro la quale c’è un pezzo di formaggio, e una bianca e chiusa, impara dopo vari tentativi a imboccare sempre la prima porta, ottenendo la ricompensa ai suoi sforzi.
Apprendere per prove ed errori.



I pulcini appena nati beccano qualsiasi macchia del terreno; crescendo, imparano a distinguere quali di queste macchie sono il cibo.
• L’apprendimento per imitazione si verifica solitamente all’interno dei gruppi di animali che vivono in società organizzate. Quando un animale sperimenta un comportamento che procura vantaggi immediati, viene imitato dai compagni. Il comportamento diventa così patrimonio di tutto il gruppo e viene trasmesso da una generazione all’altra.
• L’apprendimento per prove ed errori consiste nel ripetere quelle azioni che vengono premiate da una ricompensa, evitando invece quelle che non hanno avuto alcun esito o che hanno provocato sensazioni sgradevoli 3 .
• L’apprendimento per condizionamento si verifica quando un animale risponde a uno stimolo neutro con un comportamento uguale a quello prodotto da uno stimolo significativo, legato solitamente al cibo.
RACCONTO GENIALE

4 Apprendere per condizionamento.
Questa forma di apprendimento fu sperimentata per la prima volta dal biologo russo Ivan Pavlov (1849-1936). Lo scienziato aveva osservato che un cane produce molta saliva quando sente l’odore del cibo: così Pavlov decise di stimolare la salivazione dell’animale attraverso il suono di un campanello. Per alcuni giorni fece squillare un campanello tutte le volte in cui offriva al cane il suo pasto: dopo un certo numero di ripetizioni, Pavlov verificò che bastava il suono del campanello per provocare la salivazione del cane. L’animale era stato condizionato, cioè aveva appreso a dare, quando udiva il campanello, la stessa risposta provocata dall’odore del cibo 4
a. Sentendo l’odore del cibo, il cane produce molta saliva.

c. Il cane produce saliva quando sente il campanello. a b c
b. Un campanello squilla quando al cane viene dato il cibo.

4 L’imprinting
L’imprinting è stato scoperto e studiato dell’etologo Konrad Lorenz. Si tratta di un particolare tipo di apprendimento che avviene alla nascita dell’animale e rimane indelebile nella sua memoria per tutta la vita. Lorenz studiò a lungo l’imprinting nelle oche selvatiche, arrivando a sperimentare su se stesso questa forma di apprendimento: le oche che lo avevano visto al momento della nascita, lo seguivano come se fosse la loro madre 5 ! L’imprinting si verifica solo per alcune specie di animali: per esempio, i piccoli di molti uccelli, appena usciti dalle uova, ricevono un’impressione incancellabile dalla prima cosa in movimento, che iden tificano per sempre come la propria madre.
5 Intuito e ragionamento
Un’importante forma di apprendimento, tipica dei pri mati e della specie umana, è quella legata all’intuito Consiste nella capacità di trovare mentalmente la so luzione di un problema in modo nuovo, senza compiere faticosi tentativi ed errori e utilizzando le risorse forni te dall’ambiente. Un esempio di apprendimento per in tuito è rappresentato dall’orango che costruisce una scala di casse o utilizza un bastone per raggiungere delle banane 6

5 Konrad Lorenz seguito dalle sue oche.


6 I primati apprendono per intuito.
FISSA I CONTENUTI
ESSENZIALI

Segna con una crocetta se vero (V) o falso (F).

1. L’etologia è la scienza che studia le relazioni che si instaurano tra gli organismi.
2. I comportamenti che un animale possiede fin dalla nascita sono detti comportamenti innati o istinti.
3. L’intuito è la capacità di trovare la soluzione di un problema in modo nuovo.
VERSO LE COMPETENZE


Leggi il brano, liberamente tratto dal libro di Konrad Lorenz L’anello di Re Salomone. L’ochetta Martina fu la prima oca selvatica covata in incubatrice. Martina, al momento della schiusa dell’uovo, vide Lorenz come primo essere in movimento. Da quell’istante ogni tentativo di affidare la piccola a un’oca domestica fu vano. L’ochetta incominciò a seguirlo ovunque al punto che fu costretto a costruire un cestino per portarla sempre in spalla.
Rispondi alle domande.
1. Perché, secondo te, Lorenz ha messo l’uovo in un’incubatrice anziché farlo covare da una femmina d’oca selvatica?
2. Quale comportamento voleva sperimentare?
3. Che cosa è accaduto al momento della schiusa dell’uovo?
Le socie tA ` animali lezione 2
Esplora l’oggetto interattivo e scrivi le risposte sul quaderno.
CARTA PENNA COMPUTER
1 Quando vuole attaccare, un cane porta le orecchie in avanti, raddrizza la coda e mostra i denti.
1. A quale classe appartengono le termiti?
2. Di che cosa si nutrono?
3. Come è organizzata la società delle termiti?
4. Quali tipi di termiti vivono in una colonia?
5. In che modo si formano le colonie?

I biomi terrestri
ORA FERMA L’IMMAGINE!
Metti in pausa il video nei seguenti punti.

6. Dai un titolo a ciascuna immagine indicando a quale casta appartiene ogni termite.



2 Il canto degli uccelli è una forma di linguaggio complessa che i piccoli possiedono fin dalla nascita.

1
La comunicazione tra gli animali
Tutti i viventi stabiliscono relazioni gli uni con gli altri, sia con organismi della stessa specie sia con organismi di specie diverse. È questa la ragione per cui devono comunicare e scambiarsi diversi tipi di informazioni. Per esempio, dare l’allarme e segnalare un pericolo, cercare un partner per riprodursi, mettere in fuga un rivale, indicare la presenza di acqua o cibo agli individui della propria specie.
La comunicazione animale avviene attraverso diversi tipi di segnali: visivi, acustici, tattili e chimici.
• La comunicazione visiva è efficace solo se la distanza tra chi emette segnali e chi li riceve è breve. Segnali visivi caratteristici di molte specie animali sono la luce emessa dal corpo e i colori assunti dai maschi durante la stagione degli amori, oppure usati per la difesa. Un tipo particolare di comunicazione visiva è quella gestuale, che consiste in movimenti e atteggiamenti del corpo, come mostrare i denti, gonfiare il corpo e rizzare peli o penne 1 .
• La comunicazione sonora è la più diffusa tra gli animali: i messaggi sonori hanno il vantaggio di propagarsi a grande distanza in tutti gli ambienti. Attraverso i segnali acustici – versi, canti, fischi, grida – gli animali segnalano la propria presenza, delimitano il territorio in cui vivono, attirano la femmina o il maschio, mettono in fuga il nemico o lanciano l’allarme in caso di pericolo 2

3 Nei mammiferi la madre lecca i propri piccoli per poter individuare il loro odore e riconoscerli tra altri animali della stessa specie.

4 Le formiche producono diversi tipi di feromoni per guidare le compagne verso il cibo oppure come segnale d’allarme per attirare le altre formiche e combattere il nemico.
• La comunicazione tattile comprende tutte le forme di contatto tra due o più individui: il contatto diretto con le zampe o il becco, oppure il leccamento del pelo praticato soprattutto dalle madri dei mammiferi per riconoscere i propri piccoli. I segnali tattili sono molto usati dagli animali che vivono in gruppo, perché rafforzano i rapporti sociali tra i diversi componenti 3
• La comunicazione chimica è basata sull’odore di particolari sostanze, per la maggior parte feromoni, rilasciate dagli animali e riconosciute dagli individui della stessa specie. In molte specie i feromoni sono segnali chimici utili per l’accoppiamento, mentre altri animali utilizzano gli odori per riconoscersi e per delimitare il proprio territorio 4
2 Schiere e società
Gli animali che conducono vita solitaria sono rari: gli individui della stessa specie, infatti, hanno la tendenza a riunirsi in gruppi più o meno numerosi. La vita comunitaria garantisce molti vantaggi: permette ai diversi componenti di dividersi i compiti, difendersi con minore sforzo dagli aggressori, trovare più facilmente il cibo o un partner con cui accoppiarsi.
I gruppi più semplici di animali, che non hanno un’organizzazione interna, sono le schiere.
Banchi di pesci, stormi di uccelli, branchi di gnu sono esempi di schiere di individui, che convivono l’uno vicino all’altro e che spesso si spostano insieme per procurarsi il cibo, sfuggire ai pericoli o trovare condizioni ambientali migliori. Le società animali sono più stabili e complesse delle schiere. La vita comunitaria è basata sulla collaborazione dei componenti, che svolgono compiti diversi scambiandosi informazioni che favoriscono la loro sopravvivenza. All’interno di una società si manifestano spesso comportamenti di altruismo: per istinto un animale aiuta uno o più compagni, anche a rischio della propria vita. L’ape che punge una persona o un animale che si avvicina troppo all’alveare compie un’azione altruista difendendo il territorio, ma il prezzo che paga è molto alto: la sua morte.
SKILL BOOK
LAB STEAM
Nelle società animali il capobranco è sempre il maschio dominante?
SCIENZA
Non sempre il capobranco è il maschio più forte: questo ruolo può essere ricoperto da un individuo anziano che può essere anche una femmina.
I gruppi di elefanti africani hanno come capobranco una femmina anziana, la matriarca. Questo capita in molte altre società aperte, come nei branchi di lupi, di bisonti e di iene. Di recente gli etologi hanno potuto osservare questo fenomeno anche in un gruppo di macachi che vivono nell’isola di Kyushu in Giappone. Per la prima volta in 70 anni
Le società animali possono essere chiuse o aperte.
Nelle società chiuse ogni animale è specializzato a svolgere solo una funzione e nessun individuo estraneo è ammesso, anche se della stessa specie.
Le società chiuse sono tipiche degli insetti sociali come api, vespe, formiche e termiti. Esse funzionano come un unico grande organismo: ogni insetto non può fare a meno degli altri, e se viene separato dai propri simili, muore in pochi giorni. La vita sociale è regolata da leggi rigide e immutabili, e la specializzazione di ciascuno è determinata anche dalle caratteristiche anatomiche: in base alla struttura corporea e alle mansioni che svolgono, i membri sono ripartiti in gruppi sociali diversi. La società delle api è divisa in tre caste: una sola ape regina, i fuchi e le api operaie. L’ape regina, di taglia maggiore rispetto alle altre api, ha il compito di deporre le uova. La casta dei fuchi è costituita da qualche centinaia di maschi che hanno la funzione di fecondare l’ape regina. La casta delle api operaie è formata da migliaia di femmine sterili che producono la cera per costruire le celle dell’alveare, nutrono l’ape regina e le larve, raccolgono il polline e il nettare dai fiori.

Nelle società aperte i componenti mantengono un certo grado di autonomia e i vari ruoli specializzati non sono rigidi e immutabili.
In queste società tutti possono riprodursi, partecipare alla ricerca del cibo o alla difesa dagli aggressori. Spesso nelle società aperte esiste un ordine gerarchico dove ogni individuo occupa una posizione sociale riconosciuta e rispettata dagli altri membri del gruppo. Le società aperte sono tipiche dei mammiferi e di alcune specie di uccelli. Nelle società di scimmie, lupi e zebre, l’ordine gerarchico viene stabilito mediante una serie di lotte per il predominio all’interno del gruppo. Gli animali sconfitti accettano il rango inferiore e obbediscono al maschio dominante che diventa il capobranco.
3 Riproduzione e cura della prole
All’origine delle società animali vi è la riproduzione. Gli animali possono riprodursi per via asessuata o sessuata.
• La riproduzione asessuata consiste nella generazione di nuovi individui a partire da una parte del corpo dell’individuo genitore. Questo tipo di riproduzione sfrutta la divisione mitotica delle cellule: il figlio è quindi geneticamente identico al genitore. La divisione asessuata avviene per scissione, gemmazione, partenogenesi.
• La riproduzione sessuata avviene grazie alla fusione di due cellule sessuali, chiamate gameti, provenienti da individui di sesso diverso. I figli assumono caratteristiche
genetiche per metà materne e per metà paterne. Questo tipo di riproduzione prevede delle relazioni di vario genere fra gli individui di sesso diverso.
• La monogamia è la scelta di accoppiarsi e crescere i figli con un solo partner. Vi sono animali monogami per tutta la vita, altri monogami per la stagione riproduttiva. Le coppie monogame spendono molta energia nel corteggiamento, che segue danze complesse, e nell’allevamento dei figli 5 .
• La poligamia è la scelta di accoppiarsi con più femmine. È tipica di molti uccelli e mammiferi. Le femmine costituiscono un harem e i maschi si contendono il diritto di accoppiarsi dopo lotte cruente che possono portare al ferimento o alla morte dei contendenti. La poligamia con protezione delle femmine e dei piccoli è tipica di mammiferi come i leoni, in cui il maschio difende il territorio. La poligamia per raggruppamento è tipica di mammiferi come i cervi o uccelli come i galli cedroni: le femmine si raggruppano intorno alle arene, il maschio conquista il diritto di filiazione ma non protegge il gruppo.
• La poliandria è la scelta di accoppiarsi con più partner maschili. È tipica degli insetti, le cui femmine tendono ad accoppiarsi con numerosi partner e possono conservare gli spermatozoi intatti per un certo periodo, fino a quando le condizioni ambientali sono favorevoli alla deposizione delle uova.
4 Le strategie riproduttive e le cure parentali
Gli animali possono attuare due strategie riproduttive per garantire la propagazione della discendenza: puntare sul numero o prendersi cura dei piccoli. Gli invertebrati, molti insetti, pesci e anche alcuni rettili depongono un numero altissimo di uova nella speranza che alcuni dei piccoli sopravvivano. Questo tipo di strategia si chiama selezione R. Invece altri rettili, uccelli e soprattutto mammiferi attuano la selezione K, cioè si prendono cura dei loro piccoli. I piccoli possono essere relativamente numerosi, come nel caso delle anatre e dei conigli, oppure unici, come nel caso degli elefanti e dei rinoceronti. Minore è il numero di figli, maggiori sono il tempo e le energie spesi per la loro crescita e lo svezzamento. Questo comportamento si chiama cura parentale La cura dei piccoli può essere equamente ripartita fra entrambi i genitori, altrimenti un solo genitore si occupa dei piccoli 6 . Nel primo caso i genitori sono fisicamente simili, cioè non hanno dimorfismo sessuale. Nel secondo caso il genitore che si prende cura dei piccoli assume colorazioni mimetiche e meno appariscenti. In molti animali la cura dei piccoli è condivisa fra il gruppo di femmine del branco come negli elefanti e nei leoni.
FISSA I CONTENUTI ESSENZIALI
Completa le frasi con i termini corretti. distanza schiere aperte visiva
5 Danza di corteggiamento tra due fenicotteri.

6 Nei cavallucci marini è il maschio che genera e cura la prole.

1. La comunicazione è efficace solo se la distanza tra chi emette segnali e chi li riceve è ridotta.
2. La comunicazione sonora è la più diffusa tra gli animali: i messaggi sonori hanno il vantaggio di propagarsi a grande .
3. I gruppi più semplici di animali, che non hanno un’organizzazione interna, sono le
4. Nelle società i componenti mantengono un certo grado di autonomia e i vari ruoli specializzati non sono rigidi e immutabili.
VISUAL delle api La danza

Il comportamento delle api, il loro senso dell’ordine, l’organizzazione della loro società, i preziosi prodotti del loro lavoro come il miele, la cera e la propoli, hanno attirato l’attenzione degli esseri umani fin dall’antichità. L’etologo Karl von Frisch (1886-1982) e lo zoologo Martin Lindauer (1918-2008) hanno dedicato i loro studi alle forme di comunicazione messe in atto da questi straordinari insetti sociali per segnalare la presenza di fonti di cibo e di pericoli, ma anche l’abbandono dell’alveare e la cessione del ruolo alle regine. Grazie alle loro ricerche abbiamo compreso il significato della danza compiuta dalle api operaie per segnalare alla colonia la presenza e la posizione di una risorsa di cibo.

LA DANZA CIRCOLARE
Per segnalare la posizione del cibo in prossimità dell’alveare, le api non utilizzano una comunicazione sonora e neppure chimica, come avviene per altri insetti, ma utilizzano uno schema di movimento che ai nostri occhi appare come una vera e propria danza. Von Frisch fu il primo a identificare due diversi tipi di danza compiuti dalle api esploratrici una volta ritornate all’alveare. Se la fonte di cibo, per esempio fiori da nettare e polline, ma anche sorgenti d’acqua, si trova in prossimità dell’alveare, in genere entro i 100 metri, gli insetti iniziano una danza circolare che non indica una particolare direzione.
Il ritmo della danza e i movimenti delle api, una specie di “scodinzolamento”, forniscono informazioni sulla vicinanza della fonte di cibo e sulla sua abbondanza. La natura della fonte di cibo e le sue caratteristiche sono comunicate tramite l’odore di cui rimane impregnato il corpo dell’ape esploratrice.



LA DANZA DELL’INFINITO

muove verso l’alto, la nuova fonte di cibo è in direzione del Sole; se al contrario taglia verso il basso, le api sanno che devono volare in direzione opposta.
La danza, quindi, è regolata rispetto alla direzione del Sole. L’asse centrale dell’otto è progressivamente variato dall’ape danzante di circa 15° all’ora, in accordo con la posizione che la Terra assume rispetto al Sole nello stesso periodo di tempo. In questo modo si crea un angolo ideale tra la posizione da raggiungere e il Sole che indica con precisione millimetrica la direzione da prendere. Anche in questo










CON LA SINTESI
lezione 1 IL COMPORTAMENTO DEGLI ANIMALI
L’etologia è la scienza che studia il comportamento animale. Il comportamento è l’insieme dei processi con cui un animale risponde agli stimoli che riceve dall’ambiente in cui vive e dal suo stesso organismo. Il comportamento che un animale possiede dalla nascita è detto comportamento innato: è trasmesso di generazione in generazione e caratterizza ogni specie animale distinguendola dalle altre. Il comportamento appreso è un cambiamento del comportamento innato che è fortemente influenzato dalle esperienze che l’animale fa durante la sua vita. L’apprendimento degli animali può avvenire in modi diversi: per assuefazione, per imitazione, per prove ed errori, per condizionamento, per imprinting e per intuito e ragionamento.
lezione 2 LE SOCIETÀ ANIMALI

Gli animali comunicano tra loro attraverso diversi tipi di segnali: visivi, sonori, tattili e chimici. Gli animali hanno la tendenza a riunirsi in gruppi più o meno numerosi. I gruppi più semplici sono le schiere, che non hanno un’organizzazione interna. Sono schiere i banchi di pesci, gli stormi di uccelli e i branchi di gnu. Molti animali hanno sviluppato comportamenti sociali complessi basati sulla collaborazione dei componenti: si formano le società animali. Le società animali presentano un’organizzazione più complessa. Nelle società chiuse ogni individuo è specializzato a svolgere una funzione: un esempio è la società delle api. Nelle società aperte i componenti mantengono un certo grado di autonomia: possono avere un’organizzazione gerarchica ed essere guidate da un capobranco. All’origine delle società animali c’è la riproduzione che può avvenire per via asessuata o per via sessuata, che prevede la relazione tra due individui di sesso diverso: gli animali possono avere relazioni di monogamia, poligamia, poliandria. Tra gli animali si osservano due strategie riproduttive: la selezione R, quando vengono deposte numerose uova, nella speranza che alcune sopravvivano, e la selezione K, quando gli animali si prendono cura dei piccoli. Quest’ultimo comportamento si chiama cura parentale I genitori che si prendono entrambi cura dei piccoli sono fisicamente simili, in caso contrario quando la differenza fra maschio e femmina è molto evidente, si parla di dimorfismo sessuale.

CON LA MAPPA
Adesso che hai ripassato i contenuti essenziali con la sintesi, prova a completare la mappa con le parole chiave suggerite e a trovare le definizioni corrispondenti.
banchi - canto - chiuse - comportamento - società - tattile
1. L’ETOLOGIA è la scienza che studia il
che hanno forme di
4. comunicazione
di tipo
5. visiva
come il

8. chimica
degli
3. animali
che vivono per lo più in
come le 10. gruppi

per esempio 11. schiere 13. stormi
14. branchi
che possono essere
aperte

a. Sono tipi di società animali in cui i ruoli non sono rigidi.
b. Comunicazione basata sul riconoscimento di feromoni.
c. Sono schiere di uccelli.
d. Avviene sia tra organismi della stessa specie sia tra organismi di specie diverse.
6. sonora

lezione
1 IL COMPORTAMENTO
DEGLI ANIMALI
1 Segna con una crocetta se vero (V) o falso (F).
a. I comportamenti sono la risposta agli stimoli che l’animale riceve dall’ambiente in cui vive.
b. L’apprendimento per imitazione si verifica solitamente all’interno dei gruppi di animali che vivono in società organizzate.
c. L’apprendimento per condizionamento fu sperimentato per la prima volta dal biologo Karl von Frisch.
d. L’imprinting si verifica in tutte le specie di animali.
2 Scegli la soluzione corretta.
a. Quale dei seguenti non può essere definito un comportamento degli animali?
1 Procurarsi l’acqua.
2 Nascere.
3 Riprodursi.
4 Migrare.
b. Il comportamento appreso avviene:
1 grazie all’esperienza.
2 quando un animale impara a non reagire più a stimoli che si rivelano inutili.
3 attraverso la ripetizione di quelle azioni che vengono premiate da una ricompensa.
4 grazie all’intuito.
c. La comunicazione che avviene grazie riconoscimento di feromoni è di tipo:
1 visivo.
2 sonoro.
3 tattile.
4 chimico.
3 Abbina i termini con la definizione corretta.
1. Movimenti tattici
2. Apprendimento per assuefazione
3. Apprendimento per imitazione
4. Apprendimento per prove ed errori
5. Intuito
a Si verifica solitamente all’interno dei gruppi di animali che vivono in società organizzate.
b Tipo di comportamento innato.
c Avviene quando un animale impara a non reagire più a stimoli che si rivelano inutili.
d Consiste nella capacità di trovare mentalmente la soluzione di un problema in modo nuovo.
e Consiste nel ripetere azioni premiate da una ricompensa, evitando quelle che non hanno alcun esito o che provocano sensazioni sgradevoli.
1. 2. 3. 4. 5.
lezione 2 LE SOCIETÀ ANIMALI
4 Completa le frasi con i termini corretti.
a. La comunicazione è efficace solo se la distanza tra chi emette segnali e chi li riceve è breve.
b. Attraverso i segnali come versi, canti, fischi, grida, gli animali segnalano la propria presenza, delimitano il in cui vivono, attirano il , mettono in fuga il nemico o lanciano l’allarme in caso di .
5 Scegli la soluzione corretta.
a. Nelle società animali chiuse i membri sono ripartiti in gruppi sociali diversi, chiamati: 1 branchi. 2 schiere. 3 stormi. 4 caste.
b. I gruppi di bufali si chiamano: 1 stormi. 2 banchi. 3 mandrie. 4 schiere.
c. La strategia riproduttiva che prevede le cure parentali è chiamata:
1 selezione R. 2 selezione K. 3 poligamia. 4 dimorfismo sessuale.
FISSA I CONTENUTI ESSENZIALI
INDIVIDUARE CARATTERISTICHE E SPIEGARE
1 Dai un titolo alle fotografie e rispondi alle domande.




Rispondi.
1. Che cosa sono i movimenti tattici?
2. Che cosa si intende per riflessi?
3. Che cosa sono gli schemi fissi d’azione?
INTERPRETARE E COMMENTARE UN MODELLO
2 Illustra il tipo di comportamento messo in atto dal topo.


METTERE IN ORDINE E SPIEGARE UN FENOMENO
3 Attribuisci a ogni immagine la didascalia corretta e metti in sequenza le fasi dell’esperimento realizzato da Ivan Pavlov.




a. Il cane produce saliva al suono del campanello.


b. Sentendo l’odore del cibo il cane produce saliva.
c. Un campanello squilla quando al cane viene dato il cibo.
OSSERVARE E RIFLETTERE
4 Osserva l’immagine e rispondi alle domande.

a. Quale tipo di società è rappresentato nell’immagine?
b. Come si chiama la suddivisione fra individui con compiti assegnati tipica della società delle api?
c. In che modo sono suddivisi i compiti?
5 Rispondi.

Che tipo di comunicazione è messa in atto dalla rana?
SAPER STUDIARE E COMUNICARE
6 Scrivi le definizioni.
a. Comunicazione visiva:
b. Comunicazione sonora:
c. Comunicazione tattile:
d. Comunicazione chimica:
INTERPRETARE E TRARRE INFORMAZIONI DA UN TESTO
7 Leggi il brano.
LA COMUNITÀ DI MACACHI
L’isola di Köjima, in Giappone, ospita una comunità di macachi (Macaca fuscata) che è stata studiata dagli etologi a partire dagli anni Cinquanta del secolo scorso. Allora alcuni individui avevano preso l’abitudine di accettare cibo dagli esseri umani, in particolare patate dolci.
I ricercatori scoprirono che i macachi avevano imparato a lavare le patate nell’acqua prima di mangiarle: era stata una giovane femmina di sedici mesi, chiamata Imo, la prima a portare la patata nell’acqua di un ruscello per ripulirla della sabbia. Tale comportamento si diffuse largamente nella colonia, e nel giro di pochi anni divenne un’abitudine di gran parte del gruppo.
Rispondi alle domande.
a. Che tipo di apprendimento sta mettendo in atto il macaco Imo?
b. Che tipo di società è quella dei macachi giapponesi?
c. Spiega per quale ragione l’abitudine di lavare le patate è diventato un apprendimento. Può essere trasmesso alla discendenza?

COLLECTIVE ANIMAL NAMES
From social butterflies to solitary scavengers, virtually all animals gather into groups at some point in their lives. Safety in numbers is one reason for this, since a pack of prey is less vulnerable to attack by predators, but many animals also rely on collective wisdom to help them make better decisions. Some even blur the line between individual and group, while others limit their social time to the mating season.
Animal group names date back to medieval times when a list of collective terms for every type of animal appeared in The Book of Saint Albans, printed in 1486. These nouns were or hunting terms but have since extended into the everyday vernacular.
Some terms, however, are so odd that you would only find them in literature or poetry.
lossario
TO BLUR THE LINE BETWEEN rendere indistinto il confine tra qualcosa






COMPREHENSION EXERCISES
Answer the following questions.
a. Why is it safer for animals to live in groups?
b. Are collective terms for animals all used in everyday language?
c. What is a congregation?
d. What is the collective term for worms?



CONGREGATION
FLOCK
CONVENT, TUXEDO, COLONY, MUSTER, PARCEL, OR ROOKERY
Ecosistemi e cambiamento climatico

Se mettessi a confronto la foto o la rappresentazione di un ghiacciaio alpino realizzate nel secolo scorso con una foto attuale, ti accorgeresti subito del cambiamento profondo che è avvenuto e che è ancora in atto. Zone montane prima completamente ricoperte dai ghiacci, ora sono estensioni rocciose esposte agli agenti atmosferici che vengono progressivamente colonizzate da organismi vegetali e animali. In che modo gli scienziati studiano queste variazioni? In che modo gli ecosistemi si adattano a queste nuove condizioni? In questo percorso potrai conoscere le cause di questo grave fenomeno, le sue conseguenze sugli ecosistemi e gli interventi che è possibile realizzare per contrastare la perdita dei ghiacciai.
PREREQUISITI
Saper descrivere un ecosistema nelle sue componenti.
Sapere che cos’è l’ecologia. Conoscere la classificazione di piante e animali.
RISULTATI ATTESI
Consapevolezza delle variazioni climatiche in atto.
Comprensione delle capacità di adattamento degli organismi alle variazioni climatiche. Conoscenza delle principali tecniche di recupero ambientale.
RACCORDI interdisciplinari
Proponiamo alcuni approfondimenti che possono essere affrontati nel percorso interdisciplinare, ma la mappa suggerisce altri argomenti che possono essere sviluppati per integrare lo stesso percorso.
SCIENZE: l’arretramento dei ghiacciai modifica gli ecosistemi montani.
ARTE: la rappresentazione dei paesaggi alpini nell’arte del pittore Segantini.
EDUCAZIONE CIVICA: tecniche di ingegneria naturalistica per il recupero del territorio.
TECNOLOGIA: nuove tecnologie per ridurre la fusione dei ghiacciai italiani.
QUANDO I GHIACCIAI SI RITIRANO
SEGANTINI E LA RAPPRESENTAZIONE DEI PAESAGGI ALPINI
INGEGNERIA NATURALISTICA PER IL RECUPERO AMBIENTALE
PROTEGGERE I GHIACCIAI
SCIENZE
TECNOLOGIA
SCIENZE
Quando i ghiacciai si ritirano
I ghiacciai alpini si stanno riducendo a ritmi mai visti prima. Con il ghiaccio che arretra, anche la vita cambia. Sul ghiacciaio Carè Alto, nel Massiccio dell’Adamello, le specie abituate al freddo estremo, come gli insetti del genere Diamesa, si stanno riducendo, mentre altre, provenienti dal fondovalle, occupano i nuovi spazi dove le temperature sono diventate più miti. Questi piccoli invertebrati sono i primi pionieri della vita dopo il ritiro del ghiaccio: preparano il terreno per muschi, licheni e piante, che a loro volta ospiteranno decompositori, ragni e carabidi, insetti appartenenti all’ordine dei coleotteri. Così, in pochi decenni, un ambiente sterile si trasforma in un nuovo ecosistema, anche se molto fragile. Il riscaldamento globale accelera la scomparsa dei ghiacciai e minaccia le specie adattate al freddo, che rischiano di non trovare più ambienti dove rifugiarsi. Sono questi gli organismi che la scienza chiama “sentinelle del cambiamento climatico”: osservarli e monitorarli significa comprendere come la natura reagisca al riscaldamento della Terra.

DOMANDE GUIDA
a. Quali cambiamenti ambientali si verificano quando un ghiacciaio si ritira e in che modo questi influenzano la vita degli organismi che lo abitano?
b. In che modo il riscaldamento globale modifica gli equilibri tra le diverse specie presenti negli ecosistemi glaciali?
c. Perché gli scienziati definiscono gli organismi che vivono nei ghiacciai “sentinelle del cambiamento climatico”?
d. Quali azioni, individuali o collettive, possono contribuire a rallentare la perdita di biodiversità legata al ritiro dei ghiacciai?
Intelligenza Artificiale IA
Chiedi a un chatbot di intelligenza artificiale di fornirti informazioni sugli invertebrati che gli scienziati definiscono “sentinelle del cambiamento climatico”.
TECNOLOGIA
Proteggere i ghiacciai
I ghiacciai sono in continuo declino in tutto il mondo a causa del riscaldamento climatico globale: il tasso di fusione del ghiaccio è pari a 273 miliardi di tonnellate all’anno. Sulle Alpi si sta cercando di porre rimedio all’arretramento di alcuni ghiacciai utilizzando dei teli geotessili bianchi: si tratta di teli in fibra plastica (come propilene e poliestere), tessuti leggeri ma molto resistenti che sono posizionati sui ghiacciai in primavera e tolti in autunno. La loro funzione è quella di riflettere la radiazione solare, abbassare la temperatura sulla superficie glaciale e ridurre la fusione estiva del ghiaccio. Queste coperture sembrano funzionare sui ghiacciai coinvolti nel progetto, come il ghiacciaio della Marmolada, nelle Dolomiti, e il ghiacciaio Presena, sul massiccio dell’Adamello, ma sono interventi molto costosi e, al momento, coinvolgono solo una percentuale pari allo 0,08% dei ghiacciai italiani. Inoltre, gli interventi di copertura dei ghiacciai non risolvono il problema principale, il riscaldamento globale in atto. Solo applicando le indicazioni delle commissioni internazionali sarà possibile ridurre le emissioni di gas serra e intervenire a livello globale.
DOMANDE GUIDA

a. Quale fenomeno sta interessando i ghiacciai del mondo?
b. In che modo si sta intervenendo sulle Alpi per ridurre il fenomeno?
c. Che cosa sono i teli geotessili? In che modo aiutano a ridurre la fusione del ghiaccio?
d. Le coperture rappresentano un sistema valido solo a livello locale o anche globale?
e. Come pensi che la riduzione dei ghiacciai prodotta dalla loro fusione possa influenzare la vita delle persone e degli animali?
DIGITAL SKILLS PER APPROFONDIRE
Ricerca informazioni in rete sui principali protocolli climatici in atto e realizza una presentazione digitale per illustrarne le finalità.
TEMA
L ’ evoluzione alla luce della genetica VIVENTI
Un famoso biologo vissuto nel secolo scorso, Theodosius Dobzhansky, ha affermato: «Nulla in biologia ha senso se non alla luce dell’evoluzione».
Si parla continuamente di biodiversità come di un prezioso patrimonio da conservare e proteggere, ma per capire come mai esistano così tanti esseri viventi dalle forme più strane, capaci di vivere in ogni ambiente, anche in quelli più inospitali, è necessario comprendere i meccanismi con i quali l’evoluzione ha agito in passato e agisce ancora oggi. Le idee esposte nella teoria dell’evoluzione di Charles Darwin sono state più volte contestate, contrastate e discusse, ma hanno sempre ricevuto il sostegno di moltissime prove scientifiche provenienti da diversi settori della ricerca, dalla all’anatomia comparata fino alle più recenti scoperte della genetica e della biologia molecolare Sono queste le ragioni per cui, dal punto di vista scientifico, la teoria dell’evoluzione è oggi considerata un dato di fatto, anche se continua la ricerca, specialmente nell’ambito della genetica, per capire più in dettaglio come agisca sui viventi.
4





della vita L’evoluzione unità 9 della vita Il linguaggio unità 10
ANGELA DE BONIS, qualitycontrolanalyst

Angela ha conseguito la laurea in Biologia Molecolare della cellula e oggi lavora presso un’azienda farmaceutica dove svolge test chimici e microbiologici sui farmaci prodotti. Controlla la qualità delle materie prime e la quantità dei principi attivi contenuti, verifica l’assenza di patogeni in tutte le fasi di preparazione dei farmaci e ne verifica il comportamento fino alla loro data di scadenza.

JACOPO ZASSO, espertoincellulestaminali
Si è laureato in Biotecnologie del farmaco e oggi è esperto di cellule staminali. Jacopo collabora con un importante istituto di ricerca italiano che si occupa dello studio della biologia umana, in particolare del cervello. È membro della International Society for Stem Cell Research dove, insieme a scienziati di tutte la nazioni, si occupa dell’avanzamento della tecnologia delle cellule staminali.

VITTORIA POLI, ricercatrice


Dopo la laurea in Biologia Cellulare e Molecolare, oggi Vittoria è ricercatrice presso un importante istituto dove si occupa dei meccanismi molecolari che causano la trasformazione delle cellule della ghiandola mammaria in cellule tumorali. Con le sue ricerche Vittoria vuole capire il comportamento delle cellule in risposta agli stimoli genetici e ambientali, per contribuire allo sviluppo di terapie farmacologiche per la cura dei tumori.
Gregor Mendel
PARLA LA SCIENZA
della vita L’evoluzione unità

lezione 1
LA TEORIA DELL’ EVOLUZIONE
lezione 2
L’ ORIGINE DELLE SPECIE
lezione 3
LA STORIA DELLA VITA
lezione 4 LEZIONI
ORIGINE ED EVOLUZIONE
DELLA SPECIE UMANA


BUONE NOTIZIE PER IL FUTURO

processi evolutivi, pur soggetti a limiti ecologici e straordinaria capacità di risposta. Riconoscere e monitorare questi adattamenti offre non solo accompagnare gli ecosistemi nel loro percorso
la teoria delL’ evoluzione lezione 1
CARTA PENNA COMPUTER

Il viaggio di Darwin
Guarda il video e scrivi le risposte sul quaderno.
1. Quando è iniziato e quando è terminato il viaggio di Darwin?
2. In che modo lo scienziato ha tenuto nota delle sue osservazioni e scoperte?
3. Che cosa è successo all’isola di Capo Verde?
4. In che modo le osservazioni naturalistiche compiute alle Galapagos hanno influenzato il pensiero di Darwin?
5. Quale importante scoperta ha fatto Darwin alle isole Cocos?
1
Prima di Darwin
ORA FERMA L’IMMAGINE!
Metti in pausa il video nei seguenti punti.

6. Scrivi un breve testo che racconti le osservazioni compiute da Darwin a Bahia di San Salvador e in Australia.


Fino al XVIII secolo i naturalisti e i filosofi europei, in accordo con quanto era scritto nella Bibbia, erano convinti sostenitori dell’idea che le diverse specie animali e vegetali fossero state tutte create direttamente da Dio e che, da quel momento in poi, fossero rimaste sempre uguali nel tempo, senza subire alcuna modificazione. Queste idee erano alla base rispettivamente della teoria del creazionismo e della teoria del fissismo. I resti fossili che venivano ritrovati nelle rocce, tuttavia, suscitavano grande curiosità
Che cos’è l’epigenetica?
La ricerca scientifica ha dimostrato che esistono fattori ambientali, chimici, fisici, ma anche legati alla dieta, in grado di modificare l’espressione dei caratteri ereditari di un organismo, senza modificarne il suo codice genetico. L’epigenetica è il settore della biologia che studia proprio i fattori in grado di determinare differenze nelle caratteristiche di un organismo che possono trasmettersi alla prole. Un esempio dell’importanza della dieta nell’espressione dei geni è rappresentato dalle api: la pappa reale con cui sono alimentate alcune larve determina il loro sviluppo in api regine fertili, mentre le larve che non ricevono questo tipo di alimentazione diventano api operaie sterili. L’epigenetica ci ha insegnato che i nostri geni sono importanti, ma il modo in cui sono “letti” e “interpretati” è fortemente influenzato dall’ambiente e dal nostro stile di vita.

nel mondo scientifico, perché mostravano organismi spesso molto diversi da quelli attuali, contraddicendo le due teorie. Per spiegare l’esistenza dei fossili e confermare l’immutabilità delle specie, il paleontologo francese Georges Cuvier (1769-1832) propone una nuova idea, alla base della teoria delle catastrofi. Secondo questa teoria, i fossili sono i resti di organismi morti durante grandiose catastrofi naturali; dopo ogni distruzione, gli esseri viventi sono stati nuovamente creati perché ripopolassero la Terra.
2 L’ipotesi di Lamarck
Il primo a sostenere che le specie possono trasformarsi nel tempo e a proporre un’ipotesi per spiegare l’evoluzione degli organismi, è il naturalista francese Jean-Baptiste de Lamarck (1744-1829). Secondo Lamarck, sono i mutamenti dell’ambiente in cui vive una certa specie a provocare una corrispondente trasformazione della specie stessa. Piante e animali, grazie a una “spinta interna”, cercano di modificare alcuni dei loro caratteri per adattarsi meglio alle nuove condizioni dell’ambiente. La teoria di Lamarck si basa su due principi:
• l’uso o il non uso degli organi: l’impiego frequente di un organo lo rinforza e lo sviluppa, mentre il mancato utilizzo lo indebolisce fino a farlo scomparire;
• l’ereditarietà dei caratteri acquisiti: l’uso (o il non uso) prolungato e continuo di un organo determina, nel corso della vita dell’organismo, dei cambiamenti che possono essere trasmessi dai genitori ai figli.
Sulla base di questi due principi, Lamarck sostiene che le specie nuove compaiono nel corso di molte generazioni grazie all’acquisizione di nuovi caratteri o alla perdita di caratteri vecchi. Questo meccanismo, secondo Lamarck, può spiegare il lungo collo delle giraffe. Originariamente le giraffe avevano il collo corto, adatto a brucare le erbe dei prati. Gli sforzi compiuti nel tempo dagli animali per raggiungere le foglie degli alberi avrebbero provocato il progressivo allungamento del loro collo 1 .
3 Le osservazioni di Darwin
1 La lunghezza del collo delle giraffe secondo Lamarck è un carattere acquisito.

2 Appunti di Darwin nei quali inizia a costruire l’albero dell’evoluzione.
Il naturalista inglese Charles Darwin (1809-1882), grazie alle sue osservazioni e alle sue geniali intuizioni, fornisce per primo una teoria che spiega in modo convincente i meccanismi dell’evoluzione, ancora oggi accettata da gran parte del mondo scientifico. Darwin nasce in una ricca famiglia inglese: a 22 anni si imbarca su una nave della marina britannica, il brigantino Beagle, per partecipare a una spedizione intorno al mondo, allo scopo di eseguire rilevamenti cartografici, compiere osservazioni naturalistiche e raccogliere campioni di animali e vegetali. Durante il suo lungo viaggio, durato cinque anni, Darwin visita numerose zone del continente sudamericano, dell’Australia e molte isole dell’Oceano Pacifico dove raccoglie un’incredibile quantità di fossili, piante e insetti; inoltre riporta nel suo diario tutti i fenomeni naturali che osserva. Tornato in patria, impiega più di vent’anni per riorganizzare l’enorme quantità di materiali raccolti e per rivedere le sue osservazioni: questo lungo lavoro di revisione conduce Darwin, già profondamente convinto del fatto che gli organismi si modificano nel tempo, all’elaborazione della sua teoria dell’evoluzione. Nel 1859, in un libro intitolato L’origine delle specie, Darwin fa conoscere al mondo scientifico la sua rivoluzionaria teoria 2

RACCONTO GENIALE
4
L’evoluzione per selezione naturale
Secondo Darwin, il “motore” dell’evoluzione delle specie è la selezione naturale. L’intuizione gli viene osservando i risultati ottenuti attraverso la selezione artificiale operata da secoli dall’uomo per ottenere razze di animali domestici e piante utili. La differenza tra un cavallo da corsa e un cavallo da tiro, tra una mucca da latte e una da carne, tra varietà spontanee di piante e le corrispondenti coltivate sono dovute agli incroci effettuati da allevatori e contadini. Essi, nel corso dei secoli, hanno fatto riprodurre animali e piante con determinate caratteristiche, mentre hanno escluso dalla riproduzione gli organismi che si discostavano troppo dalle caratteristiche ricercate. In questo modo negli organismi si sono accumulate una serie di caratteristiche utili che li hanno resi sempre più diversi da quelli di partenza 3
Il meccanismo della selezione artificiale avviene perché sono gli esseri umani che scelgono i caratteri, ma come può accadere qualcosa di simile in natura? Chi opera la selezione dei caratteri?
La selezione naturale è un processo che avviene perché un organismo che, per effetto della variabilità, presenta qualche caratteristica anche solo lievemente vantaggiosa rispetto alle condizioni ambientali, ha più possibilità di sopravvivere e riprodursi e di trasmettere questa sua caratteristica alla propria discendenza. Le caratteristiche sfavorevoli, invece, vengono eliminate. È l’ambiente che opera una selezione degli individui, cioè “sceglie” quelli con caratteristiche più adatte a sfruttare le risorse e ad affrontare le avversità.
Nella lotta per l’esistenza sono avvantaggiati gli individui adatti a una particolare condizione ambientale: sono questi che sopravvivono, si riproducono e generano un maggior numero di discendenti.
SELEZIONE SULLE INFIORESCENZE


SELEZIONE SULLE INFIORESCENZE
3 L’originaria pianta selvatica di Brassica arvensis è stata modificata in numerose varietà selezionando variazioni del fusto, delle foglie e dei fiori.

SELEZIONE SULLE FOGLIE


SELEZIONE SUL FUSTO
cavolfiore broccoli
verza
BRASSICA ARVENSIS
cavolo rapa
5 I pilastri della teoria dell’evoluzione
Oltre che sulla selezione naturale, la teoria dell’evoluzione di Darwin è basata su altri quattro punti principali: il potenziale riproduttivo delle popolazioni, la lotta per l’esistenza, la variabilità tra gli individui, la discendenza da un antenato comune.
■ IL POTENZIALE RIPRODUTTIVO DELLE POPOLAZIONI
Tutti gli organismi tendono a riprodursi e a generare molti figli. Se tutti i nuovi organismi nati potessero sopravvivere e riprodursi, la Terra sarebbe in pochi anni popolata da un tal numero di individui che la vita stessa ne sarebbe impedita. Vediamo un esempio. Una coppia di topi si riproduce otto volte in un anno, mettendo al mondo ogni volta una media di sei piccoli che, dopo due mesi, sono in grado di riprodursi. Se tutti i nati da questa coppia si riproducessero con un tale ritmo, in un anno si avrebbe una popolazione superiore a 70 000 individui!
In natura, invece, le dimensioni delle popolazioni rimangono pressoché costanti e gli organismi non aumentano oltre un certo limite.
■ LA LOTTA PER L’ESISTENZA
Se il numero di individui di una popolazione di animali o vegetali rimane costante nel tempo, deve esistere un meccanismo che ne limita l’accrescimento: è la lotta per l’esistenza, che si scatena tra individui della stessa specie e tra specie diverse per assicurarsi il cibo, l’acqua, lo spazio o la luce necessari alla vita.
■ LA VARIABILITÀ TRA GLI INDIVIDUI
Fin dalla nascita, ogni individuo presenta variazioni delle caratteristiche tipiche della sua specie che lo rendono diverso da tutti gli altri 4 . Darwin ritiene che queste va riazioni avvengano in maniera del tutto casuale e che, quindi, non siano prodotte dall’ambiente, come aveva sostenuto Lamarck. Questi ca ratteri, inoltre, possono essere trasmessi di generazione in ge nerazione: sono caratteri ereditari
■ LA DISCENDENZA DA UN ANTENATO COMUNE
Ogni specie ha avuto origine da specie che l’hanno pre ceduta; queste, a loro volta, discendono da altre specie più antiche. Si può ritenere che tutte le specie viventi si siano originate a partire da un unico progenitore comu ne. Nel corso di milioni di anni, le specie hanno accumulato differenze così grandi da originare la straordinaria varietà di forme di vita che oggi conosciamo.
Segna con una crocetta se vero (V) o falso (F).
PROVE DI COMPETENZA
NELLE ISOLE DELLE GRANDI TARTARUGHE
4 In natura esistono 500 varietà di zucche legate alla differenza di rugosità e di colore della buccia.

1. George Cuvier è il padre della teoria delle catastrofi.
2. L’ereditarietà dei caratteri acquisiti è alla base della teoria del fissismo.
3. L’evoluzione dei caratteri acquisiti è comune sia alla teoria di Darwin sia a quella di Lamarck.
4. La selezione naturale è alla base della teoria del creazionismo.
5. La lotta per l’esistenza è uno dei pilastri della teoria di Darwin.
L’ 0rigine delle specie lezione 2
CARTA PENNA COMPUTER

Fringuelli famosi
Guarda il video e scrivi le risposte sul quaderno.
1. Che cosa significa “Galapagos”? Perché è stato dato questo nome all’arcipelago?
2. Quante specie di fringuelli che vivono sulle isole dell’arcipelago delle Galapagos sono state classificate da Darwin?
3. Quali caratteristiche differenziano i fringuelli delle Galapagos da quelli che vivono sul continente sudamericano?
4. In che modo i fringuelli hanno influenzato la teoria dell’evoluzione di Darwin?
1 Fossile di pesce di Bolca e pesce tropicale odierno.


ORA FERMA L’IMMAGINE!
Metti in pausa il video nel seguente punto.

5. Scrivi un breve testo per spiegare il fenomeno della radiazione adattativa.
1 Le prove a favore dell’evoluzione
A favore della teoria dell’evoluzione ci sono numerose testimonianze provenienti da diversi campi delle scienze naturali.
I fossili, resti di organismi vissuti nel passato conservati nelle rocce, studiati dalla paleontologia costituiscono la prova più forte e significativa della teoria di Darwin. I fossili contenuti nelle rocce più recenti mostrano maggiori somiglianze con organismi attuali rispetto a quelli contenuti nelle rocce più antiche: questo fatto è la prova che le forme di vita si sono sviluppate con gradualità attraverso modificazioni successive. Nel sito fossilifero di Bolca, vicino a Verona, sono stati trovati in perfetto stato di conservazione fossili di pesci risalenti a 55 milioni di anni fa. Dal loro studio i paleontologi hanno riscontrato numerose somiglianze con gli attuali pesci tropicali 1
Altre prove consistenti a favore della derivazione degli organismi da un unico progenitore sono fornite dall’anatomia comparata, un ramo della biologia che confronta le strutture anatomiche di organismi diversi. Come abbiamo già osservato illustrando i criteri alla base della classificazione moderna, la presenza di organi omologhi in gruppi di animali o piante apparentemente molto diversi tra loro è la prova che quegli organismi discendono tutti da antenati comuni dai quali si sono evoluti. Per esempio, confrontando l’arto di un pipistrello, che è un mammifero, con quello di una rana, che è un anfibio, si osserva che, indipendentemente dalla funzione che svolgono, i due arti presentano la stessa struttura ossea perché sono organi omologhi 2
Anche lo studio dello sviluppo embrionale dei vertebrati indica la presenza di un antenato comune. L’embrione di un pesce, di un anfibio, di un rettile, di un uccello e anche di un essere umano si assomigliano a tal punto, nelle fasi iniziali del loro sviluppo, da essere quasi indistinguibili 3
La teoria dell’evoluzione per selezione naturale ha segnato profondamente la storia della scienza e ha dato uno straordinario impulso allo sviluppo della biologia. Darwin, tuttavia, non conosceva l’origine della variabilità dei caratteri e soprattutto non era in grado di spiegare come essi si trasmettessero dai genitori ai figli. Lo sviluppo della ricerca avvenuto nel secolo scorso ha favorito la nascita di nuovi settori della biologia, in particolare la genetica e la biologia molecolare che si occupano dello studio del DNA e delle proteine cellulari. Entrambe le discipline hanno fornito una spiegazione dei feno meni evolutivi e hanno reso possibile la nascita della teoria sintetica dell’evoluzione, che ha integrato le idee della teo ria dell’evoluzione di Darwin con le nuove acquisizioni della ricerca scientifica.
fase di sviluppo
precoce


intermedio




























avanzato








2 Gli arti anteriori dei vertebrati sono organi omologhi.








3 Lo sviluppo embrionale dei vertebrati ripercorre le tappe della storia evolutiva.
pesce salamandra uccello uomo tartaruga
4 L’isolamento geografico.
2
Come nasce una nuova specie
Le continue modificazioni dell’ambiente sono le “spinte” più forti ai processi evolutivi che portano alla speciazione, cioè alla comparsa di nuove specie.
In biologia una specie è una popolazione di individui in grado di riprodursi tra loro e di dare origine a una prole fertile.
Il processo che porta alla comparsa di nuove specie dura milioni di anni ed è la conseguenza dell’isolamento prolungato di una popolazione di organismi: la nuova specie che si forma non ha più nulla in comune con quella originaria e gli individui delle due specie non possono più accoppiarsi e generare prole fertile.
La nascita di una nuova specie può essere dovuta a meccanismi diversi. Il più comune è l’isolamento geografico tra due popolazioni: due gruppi di individui di una stessa specie rimangono separati da una barriera fisica 4 . Durante il periodo di separazione, che può durare migliaia o milioni di anni, la selezione naturale aumenta le differenze tra le due popolazioni. Nell’arco di molte generazioni, le due popolazioni si adattano ai diversi ambienti e diventano gradualmente differenti. Se gli individui dei due gruppi si incontrano di nuovo, non sono più in grado di accoppiarsi e di generare una discendenza fertile: è avvenuto un isolamento riproduttivo e si sono formate due specie diverse.
La speciazione provocata da separazioni fisiche tra popolazioni è chiamata speciazione allopatrica
Due isole separate da un braccio di mare sono un esempio di isolamento geografico.


Le
di
La separazione di due bacini d’acqua determina anche la separazione tra specie.


Si può avere isolamento geografico anche senza separazione: la presenza di piante diverse può essere all’origine di preferenze alimentari diverse che creano isolamento geografico tra due popolazioni di una stessa specie.
a c b d
cime
una catena montuosa sono due ambienti separati.
Fenomeni di speciazione possono avvenire anche in assenza di barriere fisiche: per esempio, all’interno di una popolazione può comparire casualmente una caratteristica che impedisce l’accoppiamento tra gli individui. Con il passare del tempo si formano due specie di organismi che non possono più incrociarsi tra loro. Un interessante esempio è rappresentato dalla speciazione all’interno della popolazione di pesci ciclidi del lago Vittoria, nell’Africa orientale. La speciazione è il risultato della selezione dei maschi in base al loro colore, operata dalle femmine 5 . Questo tipo di speciazione basato sulla selezione sessuale è chiamato speciazione simpatrica


I CONTENUTI ESSENZIALI
Completa le frasi con i termini corretti.
5 La speciazione dei pesci ciclidi.
1. I studiati dalla paleontologia costituiscono la prova più forte e significativa della teoria di Darwin.
2. Lo studio dello dei vertebrati indica che questi animali hanno avuto un antenato comune.
3. In biologia la è una popolazione di individui in grado di riprodursi tra loro e di dare origine a una prole fertile.
4. All’interno di una popolazione può comparire casualmente una caratteristica che impedisce l’accoppiamento tra gli individui. Questo tipo di speciazione è detta
VERSO LE COMPETENZE
Le orche sono animali marini sociali, che vivono in piccoli branchi familiari in varie aree degli oceani. Da poco tempo, coloro che studiano le orche hanno scoperto che ogni gruppo di orche si è specializzato nella caccia a prede diverse: per esempio, le orche dell’Antartide cacciano pinguini, quelle della Patagonia cacciano leoni marini. Ogni membro di un branco comunica con gli altri per organizzare la caccia, ma ogni gruppo ha un proprio linguaggio caratteristico e diverso da quello degli altri branchi. Sembra, infatti, che i branchi siano incapaci di comunicare fra loro. Rispondi alle domande.
1. Quali indizi fornisce la comparsa di questi comportamenti nei diversi gruppi di orche?
2. Pensi che si stiano formando nuove specie?
3. Quale potrebbe essere la prova di questo fenomeno?

Ricerca in rete informazioni su fenomeni di speciazione simili a questo, per esempio quello che ha separato gli scimpanzé dai bonobo.
FISSA
La storia della vita lezione 3
CARTA PENNA COMPUTER

Sfoglia la galleria di immagini e scrivi le risposte sul quaderno.

Dalla generazione spontanea alla biogenesi

1 Esperimento di Miller e Urey.
Condensazione del vapore acqueo
CONTENUTI DIGITALI
1. Che cosa sosteneva la teoria della generazione spontanea?
2. Che cosa ha scoperto Redi con il suo esperimento?
3. Che cosa si proponeva Spallanzani con il suo esperimento?
4. In che modo Pasteur ha dimostrato che neppure i microrganismi nascono per generazione spontanea?
5. Pensi che questa spiegazione dell’origine della vita sia scomparsa dal pensiero comune?
1 L’origine della vita
I fossili più antichi che sono stati ritrovati indicano la presenza di vita batterica già 3,8 miliardi di anni fa, nelle acque degli oceani primordiali. Probabilmente si trattava di batteri estremofili, organismi unicellulari procarioti simili a quelli che si osservano ancora oggi intorno alle dorsali oceaniche.
Negli anni Cinquanta del secolo scorso due chimici statunitensi, Stanley Miller (19302007) e Harold Urey (1893-1981), hanno provato a riprodurre in laboratorio le condizioni ambientali della Terra primordiale 1

Scariche elettriche
Ammoniaca, metano, idrogeno, vapore acqueo
Acqua bollente
Raccolta campioni contenenti sostanze organiche
La Terra di allora era avvolta da un’atmosfera probabilmente formata da gas metano, ammoniaca, acqua e monossido di carbonio, e attraversata da scariche elettriche continue e raggi ultravioletti provenienti dal Sole. Le acque che formavano l’idrosfera erano bollenti e dalla loro superficie si alzavano nuvole di vapore che, condensando, davano origine a piogge acide. Il risultato di queste particolari condizioni fu la sintesi delle prime molecole organiche che contribuirono alla formazione di quello che la scienza definisce brodo primordiale. Miller, con il suo esperimento, ha effettivamente provato la possibile origine di composti organici, come gli amminoacidi, a partire da sostanze inorganiche, ma non ha mai ottenuto una qualche primitiva forma di vita. Secondo altre teorie la vita è arrivata dallo spazio. Sui frammenti rocciosi che formano le comete e sulla superficie delle meteoriti, infatti, sono state scoperte numerose tracce di molecole a base di carbonio, probabilmente catturati da questi corpi celesti durante i loro viaggi interstellari. I bombardamenti di meteoriti avvenuti nelle prime fasi della storia della Terra avrebbero portato le molecole organiche sul nostro pianeta e innescato le complesse reazioni che hanno permesso la comparsa delle prime forme di vita.
La ricerca di Hasler
L’esperimento di Miller
2 Dai batteri alla cellula eucariote
I fossili ci dicono che gli organismi più antichi erano eterotrofi unicellulari simili agli attuali batteri, capaci di demolire, per sopravvivere, le molecole organiche contenute nell’acqua senza ricorrere all’ossigeno, allora quasi assente. Si trattava, quindi, di organismi anaerobi perfettamente adattati ad ambienti privi di ossigeno.
Gradualmente, le sostanze nutritive presenti nelle acque si esaurirono, provocando la diffusione di organismi autotrofi fotosintetici, in grado di fabbricarsi da soli le molecole organiche, partendo da semplici molecole inorganiche ricavate dall’ambiente. Il progressivo aumento di ossigeno, liberato attraverso la fotosintesi nell’atmosfera primordiale, provocò a sua volta la comparsa di organismi aerobi , capaci di respirare, cioè di utilizzare l’ossigeno per ricavare energia dalle molecole organiche. Le protagoniste di questa prima e impegnativa fase della storia della vita sulla Terra sono state cellule dalla struttura molto semplice, ma capaci di adattarsi alle condizioni ambientali estreme: le cellule procariote
Sono ancora una volta i fossili che testimoniano la comparsa di organismi unicellulari eucarioti, circa 1 miliardo di anni fa. Come è avvenuto questo passaggio? Negli anni Settanta del secolo scorso la biologa americana Lynn Margulis (1938-2011) ha proposto la teoria dell’endosimbiosi , un termine che significa “vita insieme dentro” 2
Chi era L.U.C.A.?
CELLULA PROCARIOTE PRIMORDIALE
2 La teoria dell’endosimbiosi.
1,2 milioni di anni fa è avvenuta l’unione di cellule procariote primitive con cellule più semplici, i batteri simbionti. Con il tempo, i batteri inglobati hanno condiviso parte del materiale genetico con la cellula ospite e si sono trasformati in organuli cellulari.
La fagocitosi di batteri aerobi e di batteri fotosintetici che hanno stabilito una relazione simbiotica con la cellula ospite, ha generato i mitocondri e i cloroplasti.
In questo modo ha avuto origine la prima cellula eucariote, che poi si è differenziata nelle complesse cellule che oggi costituiscono animali, vegetali e funghi.
EUCARIOTE PRIMORDIALE
L.U.C.A. è l’acronimo di Last Universal Common Ancestor, che significa Ultimo Antenato Comune Universale. Per i biologi LUCA è l’organismo dal quale si ritiene che discendano tutti i viventi, la “radice” dell’albero della vita, il bis-bis-bis nonno di tutti noi! LUCA non è stato il primissimo organismo vivente apparso sulla Terra, ma è quello che ha dato origine a tutte le linee evolutive che sono sopravvissute fino ai giorni nostri (batteri, archea ed eucarioti, piante e animali). Gli scienziati cercano di ricostruire le sue caratteristiche esaminando le somiglianze che tutti gli organismi viventi condividono oggi (l’uso del DNA come materiale genetico, il codice genetico quasi universale, i ribosomi per la sintesi proteica, l’uso dell’ATP come moneta energetica). Si pensa che LUCA fosse un organismo anaerobico e autotrofo, vissuto in ambienti estremi tra 3,5 e 4,2 miliardi di anni fa. In sintesi, è da LUCA che noi viventi abbiamo ereditato tutte le caratteristiche fondamentali della vita.
CELLULA
batteri
batteri fotosintetici

3 I principali eventi delle ere geologiche
La storia della Terra è stata suddivisa in archi di tempo di durata differente, un po’ come un libro è suddiviso in capitoli e pagine. Le ere geologiche sono state distinte sulla base di eventi importanti accaduti in quei periodi di tempo, come la comparsa o l’estinzione di particolari organismi, la formazione di catene montuose o improvvise variazioni del clima. Vediamo insieme alcuni degli eventi più significativi.
3 Ricostruzione del mare di Ediacara.

4 Ricostruzione di una foresta del Carbonifero.

■ PRECAMBRIANO da 4,6 miliardi a 542 milioni di anni fa All’inizio della sua storia, la Terra è formata da rocce fuse che fuoriescono da vulcani in continua eruzione. L’atmosfera primordiale, ricca di idrogeno ed elio, diventa via via più densa, arricchita dal vapore acqueo derivato dalle esalazioni dei vulcani. Nell’atmosfera si formano le nubi dalle quali, per condensazione del vapore, cadono le prime piogge intense, che continuano per milioni di anni. Si formano così mari e oceani mentre le rocce fuse si raffreddano dando origine alla primordiale crosta terrestre. Le prime forme di vita fanno la loro comparsa circa 3,8 miliardi di anni fa: si tratta di microrganismi unicellulari simili agli attuali batteri estremofili. Intorno a 2,7 miliardi di anni fa compaiono i batteri capaci di compiere la fotosintesi, grazie ai quali l’atmosfera e l’idrosfera si arricchiscono di ossigeno, permettendo la formazione dello strato di ozono che protegge la Terra dalle radiazioni ultraviolette. Gli organismi unicellulari eucarioti compaiono circa 1,2 miliardi di anni fa. Circa 700 milioni di anni fa i mari si popolano dei primi organismi pluricellulari, simili alle meduse e alle spugne attuali. Un esempio di questi organismi è rappresentato dalla fauna di Ediacara , dal nome della località in Australia dove ne sono stati rinvenuti i fossili 3 .
■ ERA PALEOZOICA da 542 a 252 milioni di anni fa
L’inizio del Paleozoico è caratterizzato dalla comparsa di tutti i phyla degli organismi che oggi esistono sulla Terra. Compaiono i primi animali con il guscio e, circa 500 milioni di anni fa, i mari si popolano di pesci corazzati. Circa 400 milioni di anni fa i vegetali iniziano la conquista della terraferma. Dapprima microscopiche alghe verdi, poi psilofitali, piantine senza foglie e radici ma con un fusto sotterraneo, si adattano progressivamente all’atmosfera ricca di ossigeno ed evolvono nelle palme e nelle felci gigantesche delle grandi foreste del periodo Carbonifero, che ospitano molte specie di insetti e anfibi 4 . Alla fine del Paleozoico i movimenti delle placche litosferiche modificano profondamente la conformazione della superficie della Terra. Il supercontinente Pangea inizia a dividersi in due continenti: Laurasia , a nord, Gondwana , a sud. Le condizioni climatiche cambiano e causano estinzioni di massa . Le foreste di felci lasciano spazio alle foreste di conifere, gli insetti giganti scompaiono e quelli rimasti riducono le dimensioni, mentre gli anfibi si evolvono nei primi rettili.
■ ERA MESOZOICA da 252 a 65 milioni di anni fa
Un grande oceano, la Tetide , separa completamente Laurasia da Gondwana. In queste acque, nella prima parte del Mesozoico, si sviluppano grandi barriere per opera di coralli e organismi biocostruttori. Le acque si popolano dei primi organismi planctonici . I molluschi marini e le ammoniti si diffondono in tutti i mari e sulla terraferma compaiono le piante con i fiori e i primi mammiferi . Sulle terre emerse dominano le conifere e i rettili, soprattutto i dinosauri 5
L’era si conclude con l’ estinzione della maggior parte degli organismi a causa, probabilmente, della caduta di un enorme meteorite.
■ ERA CENOZOICA da 65 milioni di anni fa ai giorni nostri
Dopo la scomparsa dei grandi rettili, uccelli e mammiferi ripopolano le nicchie ecologiche rimaste vuote e le terre emerse si coprono di foreste di latifoglie 6 . Il Cenozoico è un periodo di grandi cambiamenti climatici , causati dalla frammentazione di Laurasia e Gondwana. Le masse continentali si spostano, i continenti prendono la forma che oggi conosciamo e si formano le grandi catene montuose: Ande e Montagne Rocciose in America, Alpi e Catena himalayana in Eurasia.
A partire da circa 20 milioni di anni fa, il clima terrestre si caratterizza per l’alternanza di fasi glaciali e fasi temperate. Le foreste africane subiscono espansioni e riduzioni continue. La savana si estende e anche il deserto occupa spazi sempre più ampi. Alcune scimmie antropomorfe scendono dagli alberi e si avventurano nella savana.
Circa 2 milioni di anni fa ha inizio il Quaternario, il periodo nel quale viviamo: compaiono le diverse specie del genere Homo tra cui l’ Homo sapiens , la specie alla quale noi apparteniamo.
VERSO LE COMPETENZE


Esplora l’oggetto interattivo per conoscere meglio gli avvenimenti più importanti della storia della vita sulla Terra e rispondi alle domande.
1. In quale era geologica comparvero i primi organismi unicellulari?
2. Quali furono gli organismi che iniziarono a vivere sulla terraferma?
3. Quale periodo è stato definito “l’età dei pesci”?
4. Quali furono gli animali che dominarono durante il Giurassico?
5. A quanti milioni di anni fa risale la fine dell’era mesozoica?
6. In quale era si affermarono i mammiferi?
7. Quando comparvero i primi ominidi?

5 Ricostruzione di un ambiente del Mesozoico.
6 Ricostruzione di un ambiente del Cenozoico.
La scala cronostratigrafica
Origine ed evoluzione della specie umana lezione 4
CARTA PENNA COMPUTER

L’uomo di Neanderthal

L’evoluzione dei primati
La recente classificazione dell’uomo moderno.
UOMO MODERNO
REGNO Animale
PHYLUM Cordata
ORDINE Primati
FAMIGLIA Hominidae (uomo moderno, gorilla, oranghi)
SOTTOFAMIGLIA Homininae (gorilla, scimpanzé, umani)
TRIBÙ Hominini (umani e progenitori estinti)
GENERE Homo
SPECIE Homo sapiens
Guarda il video e scrivi le risposte sul quaderno.
1. Dove furono ritrovati i resti dell’uomo di Neanderthal?
2. Secondo i ricercatori, si tratta di una specie diversa da Homo sapiens?
3. Esistono prove che Homo sapiens e Homo neanderthalensis abbiano avuto dei contatti?
ORA FERMA L’IMMAGINE!
Metti in pausa il video nel seguente punto.

4. Dai un titolo all’immagine.
5. Descrivi le differenze tra i crani dei due ominidi.
1 Le somiglianze tra scimmie antropomorfe ed esseri umani
Tra tutti i mammiferi, quelli che presentano le maggiori somiglianze con gli esseri umani sono senza dubbio gli animali che chiamiamo genericamente “scimmie”. In particolare sono le grandi scimmie, come oranghi, gorilla, bonobo e scimpanzé, a presentare le caratteristiche più simili alla nostra specie: non possiedono la coda, hanno mani capaci di afferrare e manipolare oggetti, hanno occhi frontali in grado di fornire una visione tridimensionale di quello che li circonda; inoltre, sono in grado di camminare sulle zampe posteriori, hanno un sistema nervoso molto sviluppato che determina comportamenti che possiamo definire “umani”, specialmente per quanto riguarda i rapporti sociali, la cura dei piccoli e la capacità di creare e manipolare utensili. In passato le grandi scimmie erano classificate come appartenenti alla famiglia dei Pongidae, in base ad alcune caratteristiche fisiche comuni, ma le analisi genetiche condotte negli ultimi anni hanno permesso di scoprire che solamente l’1% del DNA di gorilla e scimpanzé è diverso da quello umano. Sulla base di queste scoperte è stata apportata una sostanziale modifica alla classificazione dell’uomo moderno 1 Esseri umani e grandi scimmie appartengono tutti all’ordine dei primati e la famiglia degli ominidi comprende uomo moderno, gorilla, scimpanzé e oranghi. Sulla base delle somiglianze genetiche è stato introdotta la sottofamiglia degli Homininae che comprende gorilla, scimpanzé e umani e un’ulteriore suddivisione, la tribù degli ominini, a cui appartengono solo gli umani e i loro progenitori estinti. Nel testo continueremo a utilizzare la tradizionale denominazione di ominidi, che non è errata, in quanto gli ominini sono comunque ominidi.
2 Dalle foreste alla savana
I progenitori dei primati hanno popolato le foreste pluviali dell’Africa orientale per almeno 60 milioni di anni prima della comparsa degli ominidi. In quest’ambiente, dove conducevano una vita esclusivamente arboricola, i nostri antenati hanno sviluppato l’uso della mano e dei piedi prensili per aggrapparsi ai rami e raccogliere i frutti, ma anche una vista molto acuta, capace di fornire la visione tridimensionale dell’ambiente circostante. Circa 10 milioni di anni fa, il clima di questa zona dell’Africa muta radicalmente; la foresta pluviale si restringe e lascia il posto alla savana. Dalle scimmie che rimangono nella foresta si originano le scimmie antropomorfe Invece, le scimmie che sono costrette a vivere nell’ambiente ostile della savana cominciano ad acquisire le caratteristiche tipiche degli ominidi.
3 I nostri più antichi progenitori
Nel 1974, in una regione dell’Etiopia un gruppo di antropologi ritrovò i resti di uno scheletro incompleto, al quale fu dato il nome di Lucy. Studi successivi, eseguiti su altri ritrovamenti fossili compiuti nelle regioni dell’Africa orientale, hanno dimostrato che Lucy era un Australopithecus di sesso femminile vissuto 3 milioni e mezzo di anni fa. Veniva, quindi, confermata l’ipotesi che già prima di 4 milioni di anni fa in questa regione dell’Africa vivevano ominini appartenenti al genere Australopithecus.
La stazione eretta e l’andatura bipede permettevano agli australopitechi di esplorare la savana per trovare i frutti e i semi di cui si cibavano e per avvistare i predatori. La prova che gli autralopitechi avessero un’andatura bipede è stata fornita dal ritrovamento a Laetoli, in Tanzania, di due piste fossili formate dalle impronte di due individui che camminavano affiancati 2 . Camminare sugli arti posteriori consentiva anche di usare gli arti anteriori per afferrare e manipolare oggetti. Questi adattamenti hanno favorito l’evoluzione del cervello, che è aumentato in dimensioni e complessità, determinando lo sviluppo del linguaggio, del comportamento sociale e dell’apprendimento.
4 L’uomo che lavorava le pietre
Circa 2,8 milioni di anni fa, da un gruppo di australopitechi si è evoluto il genere Homo L’Homo habilis visse nelle regioni dell’Africa orientale in un periodo compreso tra 2,8 e 1 milione di anni fa. I frammenti di scheletro che sono stati ritrovati, dimostrano che l’Homo habilis può essere ri tenuto il primo vero essere umano. Il suo cervello era molto più voluminoso di quello degli australopitechi (circa 700 cm3) e sicuramente egli era in grado di fabbricare strumenti per tagliare, raschiare, incidere e cacciare. Il chopper, uno strumento in pietra scheggiato da una sola parte, era usato per raschiare e tagliare 3 a . L’amigdala, scheggiata su due lati e con un’estremità appuntita, era usata per colpire le prede 3 b

2 Le piste di Laetoli risalgono a circa 3,6 milioni di anni fa.


3 Due strumenti realizzati dall’Homo habilis
4 Cranio di uomo di Neanderthal.

5
Lo scopritore del fuoco
Il successore dell’Homo habilis, l’Homo erectus, compare circa 1,5 milioni di anni fa. La sua statura era paragonabile a quella di un piccolo adulto umano (140-160 cm), ma il cranio presentava dimensioni maggiori.
L’ Homo erectus costruiva strumenti piuttosto elaborati, si riparava in caverne o capanne, si copriva di pelli ed era in grado di usare il fuoco per difendersi e riscaldarsi. Si diffonde in Europa, in Asia e nel resto dell’Africa, probabilmente spinto dalla necessità di trovare nuove zone di caccia.
6 La specie scomparsa
5 Ricostruzioni facciali del genere Homo.

A partire da 2 milioni di anni fa, il clima subisce brusche variazioni di temperatura che determinano l’avanzata di immensi ghiacciai fino alle medie latitudini. Gli ultimi fossili di Homo erectus risalgono a circa 300 000 anni fa: accanto a lui si stava già affermando una nuova specie in grado di fronteggiare i problemi legati alla sopravvivenza perché dotata di un cervello più voluminoso dei suoi antenati. Il periodo compreso tra 70 000 e 35 000 anni fa vede come protagonista l’Homo neanderthalensis 4 . Nomade e cacciatore, aveva acquisito una notevole tecnica nella lavorazione della pietra scheggiata. Era capace di costruire palafitte e dava sepoltura ai morti. Gli uomini di Neanderthal scomparvero improvvisamente per motivi non ancora perfettamente chiariti, forse perché erano entrati in competizione con l’uomo moderno, l’Homo sapiens 5 .
RICOSTRUZIONE
DI Homo habilis
L’Homo habilis era alto circa 140 centimetri e pesava intorno ai 50 chilogrammi. Il suo cervello era un po’ più grande e complesso del genere Australopiteco. Aveva una testa più arrotondata, il volto piccolo, più lungo e stretto, la mascella meno sporgente e i denti più piccoli.

RICOSTRUZIONE
DI Homo neanderthalensis
L’uomo di Neanderthal aveva una corporatura robusta e raggiungeva un’altezza di circa 170 cm e un peso di 70 kg. La testa è allungata posteriormente e la fronte è bassa; ha grandi arcate sopraccigliari, una mascella sporgente e mento sfuggente.

RICOSTRUZIONE
DI Homo erectus
L’Homo erectus era alto circa 160 cm e pesava circa 65 kg. Aveva il cervello più sviluppato dell’Homo habilis. La sua caratteristica principale è quella di camminare e muoversi con sicurezza su due gambe e usare le mani per affinare le sue abilità manuali.

RICOSTRUZIONE
DI Homo sapiens
L’Homo sapiens, da cui deriva l’uomo moderno, era alto con una corporatura robusta, aveva un cervello molto più sviluppato rispetto ai suoi predecessori, mani robuste per tenere gli oggetti mentre li lavorava, e denti forti che gli servivano per strappare la carne.
7 L’uomo moderno
Circa 130 000 anni fa, inizia la diffusione della specie Homo sapiens, a cui appartiene l’uomo moderno. Essa si insedia rapidamente in tutti i continenti, giungendo nelle regioni del Nordamerica e in Australia. Circa 10 000 anni fa abbandona la sua attività di raccoglitore e cacciatore e comincia a praticare l’agricoltura e l’allevamento degli animali 6 . Dal momento della sua comparsa, l’evoluzione naturale dell’uomo non è ulteriormente progredita. L’evoluzione culturale è divenuta, invece, sempre più rapida, permettendo di migliorare straordinariamente le condizioni di vita e di occupare ogni regione del Pianeta.
L’evoluzione umana si è mossa in parallelo alla capacità di costruire strumenti sempre più complessi, che in un rapporto causa-effetto, ha contribuito a migliorare le capacità cognitive e sociali degli esseri umani.
AUSTRALOPITHECUS
FISSA I CONTENUTI ESSENZIALI
Segna con una crocetta se vero (V) o falso (F).
1. I nostri progenitori hanno abbandonato l’ambiente di foresta circa 10 milioni di anni fa.
2. Gli australopitechi più antichi scheggiavano le pietre.
3. Circa 4 milioni di anni fa è comparso il primo appartenente al genere Homo
4. L’uomo di Neanderthal è stato la causa di estinzione di altri esseri umani.
HOMO SAPIENS HOMO NEANDERTHALENSIS
VISUAL dell’evoluzione umana Il cespuglio

compare il genere
Homo in Africa. 2,8 milioni di anni fa
2,1 milioni di anni fa
Homo rudolphensis La capacità cranica è pari a 750 cm3
Homo di Denisova
Homo neanderthalensis
Homo heilderbergensis
3,5 milioni di anni fa
Comparsa dei primi ominini del genere Australopithecus; Camminano sugli arti inferiori ma mantengono la capacità di arrampicarsi sugli alberi. Hanno un’altezza di circa 1 m e un cervello di circa 450 cm3.
Australopithecus africanus
Homo rudolfensis
Australopithecus afarensis
Homo habilis
Antenato comune
Antenato comune molto simile allo scimpanzé. 6 milioni di anni fa
AFRICA
Homo sapiens
AFRICA
AFRICA
AFRICA
EUROPA
AFRICA
ASIA
Convive per un breve periodo con Homo sapiens
È sbagliato pensare all’evoluzione come a una linea in cui a una specie ne segue un’altra col passare del tempo. Tante specie diverse sono vissute allo stesso tempo! Quindi l’evoluzione si può rappresentare come un CESPUGLIO di cui noi conosciamo le specie, quelle che si sono estinte e quelle che sono andate avanti, ma non sappiamo esattamente quali sono i rami di collegamento tra di esse.
Paranthropus robustus
Paranthropus boisei
Specie che si trova solo nell’isola di Flores in Indonesia. 650 000
Paranthropus aethiopicus
3 milioni di anni fa
Ominini del genere
Paranthropus
Molto robusti, molto pelosi, con un cervello di circa 420 cm3 e con grandi muscoli per la masticazione di semi e radici.

CON LA SINTESI
lezione 1 LA TEORIA DELL’EVOLUZIONE
Fino al XVIII secolo i filosofi e i naturalisti sostenevano le teorie del creazionismo e del fissismo: le specie viventi sono state create da Dio e nel tempo sono rimaste sempre uguali. Il primo a sostenere che gli organismi possono modificarsi nel tempo è stato il naturalista Jean-Baptiste de Lamarck
La sua teoria si basa su due principi: l’uso o il non uso degli organi e l’ereditarietà dei caratteri acquisiti. Il naturalista inglese Charles Darwin fa numerose osservazioni sui viventi durante un lungo viaggio intorno al mondo intrapreso nel 1859. Secondo Darwin il “motore” dell’evoluzione è la selezione naturale, un processo che favorisce la sopravvivenza e la riproduzione degli organismi più adatti a determinate condizioni ambientali. I cinque pilastri della teoria sono: la selezione naturale, il potenziale riproduttivo delle popolazioni, la lotta per l’esistenza, la variabilità degli individui, la discendenza da un antenato comune

lezione 2 L’ORIGINE DELLE SPECIE
Le prove a sostegno della teoria dell’evoluzione di Darwin provengono dallo studio dei fossili, dall’anatomia comparata che analizza gli organi omologhi in animali molto diversi tra loro e dallo studio dello sviluppo embrionale dei vertebrati. Lo sviluppo della ricerca scientifica ha favorito la nascita di nuovi settori della biologia, come la genetica e la biologia molecolare che hanno fornito risultati che hanno permesso di elaborare la teoria sintetica dell’evoluzione, che conferma e amplia la teoria di Darwin. Una specie è una popolazione di individui in grado di riprodursi tra loro e di dare origine a una prole fertile. I processi di speciazione, cioè i processi che portano alla formazione di nuove specie, durano milioni di anni e avvengono attraverso meccanismi diversi. Quello più frequente è dovuto a un ostacolo fisico che divide due popolazioni di una stessa specie che con il tempo diventano sempre più diverse: in questo caso si parla di speciazione per isolamento geografico. In alcuni casi possono manifestarsi fenomeni di speciazione simpatrica quando la divisione in due specie diverse avviene in assenza di barriere geografiche, per esempio quando all’interno della popolazione compare casualmente una caratteristica che impedisce l’accoppiamento tra gli individui.


lezione 3 LA STORIA DELLA VITA
Gli esperimenti condotti negli anni Cinquanta del secolo scorso da Miller e Urey, hanno provato a spiegare come si sarebbero formati i primi composti organici, riproducendo in laboratorio le condizioni ambientali della Terra primordiale. La vita sulla Terra è comparsa nei primi mari miliardi di anni fa, sotto forma di organismi procarioti anaerobi. Le cellule procariote con il tempo si sono evolute in cellule eucariote secondo la teoria dell’endosimbiosi di Lynn Margulis. I principali eventi delle ere geologiche in cui è suddivisa la storia della Terra sono stati ricostruiti attraverso lo studio delle rocce e delle tracce che contengono. Durante il Precambriano si è formato il primo oceano e sono comparse le prime forme di vita, circa 3,8 miliardi di anni fa. I primi organismi pluricellulari sono rappresentati dalla fauna di Ediacara e risalgono a circa 700 milioni di anni fa. Nell’era paleozoica compaiono i primi animali con il guscio e i primi vertebrati. I muschi e i licheni, seguiti dalle felci, conquistano la terraferma, che in seguito viene colonizzata da insetti e anfibi. Durante l’era mesozoica si forma l’oceano della Tetide e compaiono i primi organismi planctonici, le piante con i fiori, i dinosauri, gli uccelli e i mammiferi. Nell’era cenozoica avvengono grandi cambiamenti climatici, dovuti allo spostamento delle masse continentali. Si diffondono i mammiferi e compaiono le scimmie antropomorfe.
lezione 4 ORIGINE ED EVOLUZIONE DELLA SPECIE UMANA
Circa 10 milioni di anni fa, a causa di una crisi climatica, alcune scimmie antropomorfe si avventurano nella savana, diventano bipedi e danno origine al gruppo degli ominini, al quale appartiene l’uomo moderno e i suoi antenati estinti. L’evoluzione dell’uomo è stata ricostruita grazie ai ritrovamenti fossili. Le tracce più antiche risalgono a circa 4 milioni di anni fa e sono state lasciate dagli ominini del genere Australopithecus. 2,8 milioni di anni fa compare l’Homo habilis, il primo ominino in grado di scheggiare le pietre. 1,5 milioni di anni fa compare l’Homo erectus, che impara a usare il fuoco e a costruire capanne, e si diffonde dall’Africa all’Europa e all’Asia. Tra 70 000 e 35 000 anni fa Homo neanderthalensis raggiunge la sua massima espansione e introduce la sepoltura dei morti. Circa 130 000 anni fa inizia la diffusione della specie Homo sapiens in tutti i continenti, che circa 10 000 anni fa diventa agricoltore e allevatore.


CON LA MAPPA
Adesso che hai ripassato i contenuti essenziali con la sintesi, prova a completare la mappa con le parole chiave suggerite e a trovare le definizioni corrispondenti. ambiente - Cenozoico - fossili - isolamento geograficoorgani omologhi - selezione naturale - specie
è sostenuta da prove che derivano dallo studio di

6. embrioni che hanno permesso di suddividere la




storia della Terra
1. L’EVOLUZIONE DEGLI ORGANISMI
determina la comparsa di nuove
attraverso meccanismi di

4. isolamento riproduttivo
avviene come descritto da
a. È l’era geologica del genere Homo.
b. Organismi in fase di formazione.
c. È un pilastro della teoria di Darwin.
d. Causa il fenomeno della speciazione allopatrica.
e. Sono studiati dall’anatomia comparata.
sotto la spinta della
15. adatte 14.
13. Darwin al loro
che favorisce gli individui con le caratteristiche più
16.
5. 7.
3.
9. Precambriano 10. Paleozoico 11. Mesozoico 12. in archi di tempo

lezione 1 LA TEORIA DELL’EVOLUZIONE
1 Segna con una crocetta se vero (V) o falso (F).
a. La teoria dell’uso e non uso degli organi è alla base della teoria di Darwin.
b. Darwin ha pubblicato la sua teoria sull’evoluzione appena finito il viaggio sul Beagle.
c. Il motore dell’evoluzione per Darwin è la selezione naturale.
d. Secondo Darwin si può ritenere che tutte le specie viventi si siano originate a partire da un unico progenitore comune.
2 Scegli la soluzione corretta.
a. Il principio alla base della teoria di Lamarck è:
1 il potenziale riproduttivo delle popolazioni.
2 la lotta per l’esistenza.
3 la variabilità tra gli individui.
4 l’ereditarietà dei caratteri acquisiti.
b. Darwin elaborò la sua teoria prendendo ispirazione:
1 dalla teoria del fissismo.
2 dal creazionismo.
3 dalla pratica della selezione artificiale.
4 dal principio dell’uso e non uso degli organi.
c. L’affermazione “In natura le dimensioni delle popolazioni rimangono pressoché costanti e gli organismi non aumentano oltre un certo limite” appartiene alla teoria:
1 del fissismo.
2 del creazionismo.
3 dell’evoluzione per selezione naturale.
4 del catastrofismo.
3 Completa il brano con i termini corretti.
a. Georges Cuvier propose la teoria delle .
b. Il naturalista sosteneva che le specie nuove compaiono nel corso di molte generazioni grazie all’acquisizione di nuovi o alla perdita di quelli vecchi.
c. a 22 anni si imbarcò su una nave della marina britannica, il brigantino Beagle
d. La è un processo che avviene perché un organismo, per effetto della variabilità delle sue caratteristiche, ne presenta qualcuna vantaggiosa per la sopravvivenza in particolari condizioni ambientali.
lezione 2 L’ORIGINE DELLE SPECIE
4 Abbina i termini con la definizione corretta.
1. Fossili
2. Anatomia comparata
3. Specie
4. Speciazione allopatrica
5. Speciazione simpatrica
a Ramo della biologia che confronta le strutture anatomiche di organismi diversi.
b È provocata da separazioni fisiche tra popolazioni.
c Resti o tracce di organismi vissuti nel passato conservati nelle rocce.
d Popolazione di individui in grado di riprodursi tra loro e di dare origine a una prole fertile.
e È provocata dalla selezione sessuale.
1. 2. 3. 4. 5.
5 Sottolinea il termine corretto tra i due proposti.
a. Se gli arti di due o più mammiferi, indipendentemente dalla funzione che svolgono, presentano la stessa struttura ossea, sono organi omologhi/analoghi.
b. L’isolamento riproduttivo/geografico avviene quando gli individui appartenenti a due gruppi di una stessa specie non sono più in grado di accoppiarsi.
c. Nei pesci ciclidi la speciazione è il risultato della selezione dei maschi operata dalle femmine in base al colore/alle dimensioni
6 Scegli la soluzione corretta.
a. Quale delle seguenti condizioni è indispensabile per definire una specie?
1 Isolamento geografico.
2 Generazione di prole fertile.
3 Selezione sessuale.
4 Isolamento riproduttivo.
b. Quale tipo di speciazione è illustrata nel disegno?

1 Speciazione allopatrica.
2 Speciazione simpatrica.
3 Speciazione per selezione sessuale.
4 Speciazione in assenza di barriere fisiche.
3 LA STORIA DELLA VITA
7 Osserva il disegno e inserisci accanto a ogni termine il numero corrispondente.






8 Segna con una crocetta se vero (V) o falso (F).
a. Gli esperimenti di Miller e Urey hanno permesso di individuare i batteri estremofili.
b. Lynn Margulis ha elaborato la teoria dell’endosimbiosi.
c. Durante il Paleozoico sono comparse le prime forme di vita.
d. Le prime forme di vita furono unicellulari eucarioti.
e. Nel Cenozoico comparvero le diverse specie di Homo.
lezione 4 ORIGINE ED EVOLUZIONE
DELLA SPECIE UMANA
9 Scegli la soluzione corretta.
a. La specie umana ha il 99% del DNA in comune con:
1 tutte le scimmie antropomorfe.
2 i babbuini.
3 i macachi.
4 gli scimpanzé.
b. Gli ominini si sono sviluppati in: 1 Africa.
2 Europa. 3 Asia. 4 America.
c. La specie umana più antica è stata:
1 Australopithecus
2 Homo erectus. 3 Homo habilis 4 Homo sapiens.
10 Abbina i termini con la definizione corretta.
1. Homo habilis
2. Australopithecus
a. Batteri aerobi

b. Batteri fotosintetici
c. Cellula eucariote vegetale
d. Cellula primordiale
e. Batteri con flagello
f. Cellula eucariote animale

3. Homo erectus
4. Homo neanderthalensis
5. Homo sapiens
a Ha soppiantato tutte le altre specie umane.
b Costruiva strumenti in pietra scheggiata.
c Costruiva palafitte e dava sepoltura ai morti.
d È considerato lo scopritore del fuoco.
e Aveva stazione eretta, era bipede e raccoglitore di semi e frutti.
1. 2. 3. 4. 5.
lezione
INTERPRETARE UN MODELLO E SPIEGARE UN FENOMENO
1 Osserva il disegno e rispondi alle domande.

a. A quale ipotesi si riferisce il disegno?
b. Che cosa rappresenta?
c. Quale didascalia scriveresti se lo stesso disegno si riferisse alla teoria dell’evoluzione per selezione naturale di Darwin?
ELABORARE INFORMAZIONI DA UN TESTO
3 Leggi il brano.
LE PITTURE RUPESTRI IN INDONESIA
Nell’isola indonesiana di Sulawesi ci sono delle grotte che conservano testimonianze di un passato molto remoto. Un centinaio di grotte furono decorate dagli uomini del Pleistocene, con “stencil” di mani e pitture rupestri di animali selvatici, dipinti così bene che si può capirne anche il genere, come nel caso di un babirussa (una specie di cinghiale) femmina. Quei dipinti erano stati segnalati nel 1906 da due naturalisti svizzeri, e nel 1950 l’archeologo olandese H.R. van Heereken descrisse per la prima volta le pitture rupestri, che però furono datate a 10 000 anni fa. Una ricerca congiunta di un team australianoindonesiano ha stabilito, grazie a test con uranio radioattivo, che le impronte delle mani risalgono approssimativamente a 39 900 anni fa, e sono quindi coeve, o di poco antecedenti, a quelle trovate in Europa (databili fino a 41 000 anni fa). Un’altra analogia temporale riguarda la raffigurazione di animali che, sia in Indonesia sia in Europa, furono realizzate in un arco temporale che va dai 38 000 ai 20 000 anni fa. La scoperta dimostra che la creatività umana non è nata in Europa, per poi diffondersi in altre parti, ma è molto più antica: probabilmente era già presente in Africa, prima che la nostra specie si diffondesse negli altri continenti.
Rispondi alle domande e svolgi le attività proposte, da solo o in gruppo con i tuoi compagni.
SPIEGARE UN FENOMENO
2 Osserva l’immagine e rispondi.


Come si può spiegare la somiglianza tra il gliptodonte, un antico mammifero estinto, e l’attuale armadillo?
a. Qual è l’argomento principale del brano?
b. Dove si trovano i dipinti?
c. Che cosa raffigurano?
d. A quando risalgono?
e. Perché sono importanti le nuove datazioni di questi dipinti?
f. Spiega perché è possibile affermare che l’arte era già presente in Africa, prima della migrazione di Homo sapiens negli altri continenti.
DIGITAL SKILLS
Ricerca il significato di “Pleistocene” e “test con uranio radioattivo”. Ricerca in rete le principali raffigurazioni rupestri nel mondo.
Le Galapagos: un piccolo mondo a sé stante
10 ottobre 1835, arcipelago delle Galapagos
Mi piace davvero stare alle Galapagos! Qui la fauna selvatica è straordinaria e ci sono molti e diversi animali. E quando si trova lo stesso animale in due diverse isole dell’arcipelago, bisogna assicurarsi bene che i due siano proprio uguali. Il signor Darwin mi ha spiegato che tutto dipende dalle diverse condizioni di vita che gli animali trovano nelle diverse isole. I fringuelli, per esempio, hanno becchi più grandi e più forti se devono cibarsi di semi con un gusci più duri. Un animale comune nell’arcipelago è l’iguana. Le iguane sono grandi rettili che sembrano dei piccoli draghi. Sono brutti e io cerco di tenermi a distanza da loro, così sono sicuro che non possono mangiarmi!

Ma gli animali che mi piacciono di più sono le tartarughe. Alcune di loro sono enormi. Si muovono così lentamente che io posso anche cavalcarle.
Le tartarughe, però, hanno un becco robusto: una di loro ha appena provato a mordermi. Forse le tartarughe sono più feroci delle iguane...


Darwin
Il15 settembre siamo sbarcati su queste straordinarie isole vulcaniche. L’arcipelago è un po’ un piccolo mondo a parte. Si trova tra 500 e 600 miglia dalla costa americana. Sono davvero molto eccitato per tutte le cose che sto per vedere. La storia naturale di queste isole è decisamente curiosa e degna di attenzione. La maggior parte della vita organica è autoctona, e questo significa che gli organismi appartengono a specie che non si possono trovare in nessun’altra parte del mondo. Le specie sono simili a quelle che vivono in Sudamerica, ma presentano alcune caratteristiche diverse. E ci sono anche differenze tra specie e specie su ciascuna isola. L’unico mammifero che vive nelle isole è il topo, tutti gli altri animali sono rettili e uccelli. Ora sto osservando i fringuelli. Noto che i loro becchi cambiano da isola a isola a seconda del tipo di cibo che mangiano. Io penso che ogni gruppo di uccelli si sia evoluto in modo diverso per adattarsi all’ambiente. Inoltre, anche le tartarughe giganti e le iguane sono differenti. Alcune iguane vivono sulla terraferma, mentre altre vivono in mare e mangiano alghe! Quindi, sia nello spazio sia nel tempo, ci troviamo in qualche modo vicini a quel grande evento, il mistero dei misteri: la prima comparsa di nuovi esseri viventi su questa terra.
ORA RACCONTA TU!
a. Descrivi con le tue parole le emozioni che prova Syms incontrando gli strani animali che vivono sulle isole Galapagos, e quelle che prova Darwin
b. Metti a confronto i due personaggi: ti sembra che l’atteggiamento di Syms e dello scienziato siano simili? In che cosa differiscono?
c. Quali osservazioni fa Darwin osservando gli esemplari di fringuello che vivono nelle diverse isole?
d. Spiega perché le osservazioni compiute da Darwin alle Galapagos gli hanno permesso di gettare le basi della sua teoria dell’evoluzione delle specie.
Con l’aiuto dell’insegnante chiedi a un chatbot di intelligenza artificiale di proporti delle attività STEM, da realizzare da solo o in classe con i tuoi compagni, sulle osservazioni compiute da Darwin alle isole Galapagos. Formula le domande in modo che le attività siano adatte alla tua età e che i materiali per realizzarle siano facili da reperire. Scrivi per ciascuna attività una scheda di laboratorio, oppure scatta fotografie o realizza dei video delle diverse fasi da inserire in un PowerPoint da presentare alla classe.
Intelligenza Artificiale IA
VIVENTI
unità
10 della vita Il linguaggio
lezione 1
GLI ACIDI NUCLEICI : IL DNA
lezione 2
LA SINTESI DELLE PROTEINE
lezione 3
LE LEGGI DI MENDEL
lezione 4
GENI E CROMOSOMI
lezione 5
LA GENETICA UMANA
lezione 6
LE BIOTECNOLOGIE
EDUCAZIONE CIVICA
Curare con le cellule staminali

LEZIONI POWERPOINT in


BUONE NOTIZIE PER IL FUTURO
Non solo DNA, IL FUTURO PASSA PER L, RNA!
Quando si parla di ingegneria genetica, si pensa subito al DNA, la celebre molecola a doppia elica che contiene tutte le informazioni genetiche che rendono ciascuno di noi un individuo unico. Ma negli ultimi anni, l’attenzione della ricerca biotecnologica si è spostata sempre più verso l’altro acido nucleico: l’RNA. A differenza del DNA, l’RNA è formato da un solo filamento e può essere manipolato in modo più flessibile e sicuro. Oggi le tecnologie più innovative riguardano soprattutto l’RNA messaggero, che svolge un ruolo fondamentale nel determinare quali proteine vengono prodotte dalle cellule. Una delle novità più importanti è che oggi si possono regolare i geni in modo preciso ma non permanente, evitando modifiche dirette al DNA. Questo rende le terapie a base di non solo altamente specifiche, ma anche reversibili e adattabili a diversi tipi di patologie. Dopo i vaccini a RNA sviluppati contro il Covid-19, sono in fase avanzata terapie sperimentali per malattie metaboliche, come diabete e obesità, disturbi neurodegenerativi, come la sclerosi multipla, malattie rare e tumori.
Nel 2024 sono stati annunciati i primi risultati positivi di terapie a RNA contro alcune forme di cancro al fegato e al pancreas, mostrando un potenziale rivoluzionario anche in oncologia.
Queste tecnologie stanno aprendo la strada a una nuova era della medicina, in cui si potrà intervenire a livello molecolare con precisione, rapidità e minor rischio di effetti collaterali.
GLI ACIDI NUCLEICI : IL DNA lezione 1
LAB TINKERING
COSTRUIAMO UN MODELLO DI DNA
La molecola del DNA ha una struttura piuttosto complessa che può essere paragonata a quella di una scala a pioli arrotolata a spirale. I pioli della scala sono formati dall’unione di due molecole organiche, le basi azotate, che si uniscono a due a due sempre allo stesso modo grazie a legami chimici. Realizza il modello e lo capirai!
MATERIALI
• due vecchi cavetti per computer
• cannucce colorate che rappresentano il gruppo fosfato e il desossiribosio
• mollette di quattro colori diversi che rappresentano le basi azotate
• cartoncini rettangolari




■ REALIZZA L’ESPERIMENTO
PROCEDIMENTO
1. Scegli delle cannucce dello stesso colore e tagliale in modo da ottenere pezzetti lunghi 5 cm.
2. Prendi una cannuccia, infilala su uno dei cavetti e falla scorrere fino al fermo.
3. Stabilisci a quale base azotata corrispondono le mollette di un certo colore. Per esempio, le mollette gialle sono la base adenina, le mollette verdi sono la citosina, le mollette rosse la guanina e quelle rosa la timina.
4. Prendi una molletta colorata, per esempio verde, e applicala sul cavetto alla parte superiore della cannuccia.
5. Infila una seconda cannuccia sul cavetto e falla scorrere fino alla molletta.
6. Applica una seconda molletta di colore diverso. Ripeti le operazioni fino alla fine del cavetto.
7. Con il secondo cavetto ripeti le stesse operazioni, ma fai attenzione ai colori. Alla molletta verde sul primo cavetto devi far corrispondere quella rossa sul secondo, alla molletta gialla sul primo fai corrispondere quella rosa sul secondo.
8. Scegli cartoncini dello stesso colore e ritaglia dei rettangoli delle dimensioni di 2 cm per 5 cm.
9. Quando hai completato i due cavetti, unisci tra loro le mollette corrispondenti pinzando i cartoncini.
■ OSSERVA E RISPONDI
1. Perché devi appaiare le mollette a due a due sempre nello stesso modo?
2. Che cosa rappresentano i rettangoli di cartoncino?
3. Che forma devi dare alla tua costruzione di mollette per renderla simile alla molecola di DNA?

1 Il “libretto” delle informazioni genetiche
In tutte le cellule è presente un importante database di informazioni scritte in un particolare linguaggio chimico: sono le informazioni genetiche.
Le informazioni genetiche forniscono alle cellule le istruzioni necessarie per “costruire” un nuovo individuo con caratteristiche proprie.
La molecola che contiene tali informazioni è l’acido desossiribonucleico, o DNA
2 La molecola del DNA
Il DNA è una molecola biologica classificata tra gli acidi nucleici. Questo nome fornisce due indicazioni: il suo sito, cioè il nucleo della cellula, e le caratteristiche acide. Il DNA è un polimero, costituito da due lunghi filamenti, ciascuno formato dall’unione di unità che si ripetono, i nucleotidi. Ogni nucleotide è formato da tre parti:
• una molecola di desossiribosio, uno zucchero;
• una molecola di acido fosforico;
• una base azotata.
Le basi azotate nel DNA sono quattro: adenina (abbreviata con A), guanina (G), citosina (C) e timina (T). Esistono perciò quattro tipi diversi di nucleotidi a seconda della base azotata che contengono 1 I nucleotidi di ogni filamento sono uniti tra loro attraverso la molecola di acido fosforico, mentre i due filamenti sono tenuti assieme da legami chimici che si stabiliscono tra due basi azotate 2 a . Questi legami non sono casuali, perché ogni base azotata può accoppiarsi solo con la sua base complementare: l’adenina si unisce alla timina, la guanina si unisce alla citosina. Si dice perciò che l’adenina è la base complementare della timina e che la guanina è la base complementare della citosina. Questa stretta corrispondenza tra le basi rende complementari anche i due filamenti; ciò significa che se è nota la sequenza di un filamento, conosciamo automaticamente anche la sequenza dell’altro. I due filamenti si arrotolano l’uno intorno all’altro a formare una doppia elica 2 b
acido fosforico
nucleotide di DNA zucchero (desossiribosio)
base azotata
Questa struttura può essere paragonata a una scala a pioli attorcigliata su se stessa 3 : i montanti laterali della scala sono i due filamenti di DNA costituiti dalla successione degli zuccheri e dei gruppi fosfato; i pioli sono formati dall’unione di due basi azotate complementari.
3 Una scala a pioli attorcigliata ricorda il modello a doppia elica del DNA.
1 Rappresentazione di un nucleotide.AT basi azotate CG acido fosforico nucleotide di DNA zucchero (desossiribosio) AT basi azotate CG acido fosforico base azotata zucchero


filamenti di nucleotidi a b

















2 La struttura del DNA.
4 Gli scopritori della doppia elica del DNA; da sinistra: Watson, Crick e Franklin.
La forma a doppia elica del DNA è stata scoperta nel 1953 dai biologi James Watson (1928) e Francis Crick (1916-2004), con il contributo fondamentale della chimica Rosalind Franklin (1920-1958) 4 .



La molecola del DNA è molto lunga: quella contenuta nelle cellule del corpo umano raggiunge la lunghezza di 2 metri! Come può un filamento di queste dimensioni stare all’interno del nucleo cellulare, che misura circa 6-9 micron? Per compattare il lungo filamento intervengono delle proteine, gli istoni
5 Una lunga molecola impacchettata.
Gli istoni si legano strettamente al DNA e il complesso DNA-istoni si avvolge su se stesso formando una spirale 5 . Un ulteriore ripiegamento porta alla formazione di lunghe fibre, la cromatina, visibile nel nucleo della cellula. Quando la cellula si riproduce, le fibre di cromatina si compattano ulteriormente dando origine a strutture a forma di bastoncino, i cromosomi.
basi azotate complementari cromosoma
3 La duplicazione del DNA
di cromatina complesso DNA-istoni
La complementarietà dei due filamenti del DNA permette alla molecola di formare una copia di se stessa, cioè di duplicarsi. Questo processo prende il nome di duplicazione o replicazione del DNA e avviene durante la mitosi.

Quando una cellula si riproduce, si divide in due per dare origine a due nuove cellule figlie: ciascuna cellula figlia riceve una copia completa delle informazioni genetiche della cellula madre, perciò è necessario che la cellula originaria, prima di dividersi, duplichi il proprio DNA 6

fibra
istoni
nucleo cellulare
La duplicazione del DNA è il processo con il quale la cellula duplica il materiale genetico contenuto nel DNA per trasmetterlo alla generazione successiva.
Il DNA si duplica con estrema precisione e in media si verifica un errore ogni miliardo di coppie di basi: questi piccoli errori sono responsabili di mutazioni genetiche. Il risultato di una mutazione è che la nuova molecola di DNA non è più identica a quella dalla quale si è duplicata.
molecola originaria del DNA
2. Le basi azotate che sporgono dai due filamenti servono da “stampo” per la formazione di altri due nuovi filamenti: i nucleotidi che sono liberi nel nucleo si appaiano con le basi complementari di ciascun filamento stampo (A con T e C con G).
nuovo filamento
vecchio filamento
5. Le due doppie eliche che ne risultano sono identiche e costituite da un filamento vecchio e uno nuovo.

DNA polimerasi
nucleotidi
FISSA I CONTENUTI ESSENZIALI
Segna con una crocetta se vero (V) o falso (F).
6 Le tappe della duplicazione del DNA.
1. Un enzima rompe i legami tra le basi azotate complementari e separa i due filamenti di DNA, spostandosi lungo la doppia elica come se stesse aprendo una cerniera lampo.
3. L’enzima DNA polimerasi scivola lungo i due filamenti preesistenti di DNA e lega tra loro i nucleotidi.
4. Alla fine della duplicazione si sono formati due nuovi filamenti, complementari allo stampo e che si avvolgono a elica insieme ad esso.
1. Le informazioni genetiche forniscono alle cellule le istruzioni necessarie per “costruire” un nuovo individuo.
2. La base azotata adenina (A) è complementare con la guanina (G).
3. La scoperta della forma a doppia elica del DNA è da attribuire unicamente a James Watson e Francis Crick.
4. Gli istoni sono le proteine che compattano il filamento di DNA.
5. La duplicazione è il processo con il quale la cellula duplica il materiale genetico del DNA.
VERSO LE COMPETENZE
Dividetevi in piccoli gruppi e realizzate l’esperimento descritto nello SKILL BOOK. Stabilite quali fasi ciascun gruppo dovrà eseguire. Ogni gruppo può realizzare un video o scattare fotografie che documentino le diverse fasi dell’esperienza.
la sintesi delle proteine lezione 2
LAB STEM
UN CODICE DA DECIFRARE
Il codice segreto con il quale gli acidi nucleici comunicano con le proteine è stato scoperto dagli scienziati Marshall Nirenberg (1927-2010) e Gobind Khorana (1922-2011). Gli scienziati hanno capito che a una o più combinazioni di tre basi azotate corrisponde uno specifico amminoacido.
Per i risultati delle loro ricerche Nirenberg e Khorana hanno ricevuto nel 1968 il premio Nobel per la medicina.
Nel disegno di questa pagina è rappresentato un sistema pratico e veloce per passare dal linguaggio delle basi azotate a quello degli amminoacidi e viceversa. Le basi azotate sono quelle che compongono il DNA, a eccezione dell’uracile che sostituisce la timina nella molecola di un altro acido nucleico, l’RNA, responsabile della costruzione degli amminoacidi.
Vuoi provare a usare il codice segreto delle cellule?
■ OSSERVA E RISPONDI
1. Quali amminoacidi corrispondono a una sola combinazione di tre basi?
2. Quante combinazioni di tre basi azotate corrispondono alla prolina?
triptofano
3. Quali combinazioni di basi corrispondono all’informazione di STOP?
4. Perché la maggior parte degli amminoacidi corrisponde a più combinazioni di tre basi? Sei capace di formulare una possibile spiegazione?
1 DNA e proteine
Le proteine svolgono ruoli importanti nel nostro organismo: sono i “mattoni da costruzione” delle cellule, attivano e controllano tutte le reazioni chimiche che rendono possibile la vita delle cellule. Anche tutte le caratteristiche di una persona dipendono da specifiche proteine, che sono prodotte sulla base delle informazioni contenute nel DNA.

DNA e proteine, tuttavia, sono molto diversi dal punto di vista chimico: la molecola di DNA è formata da una sequenza di nucleotidi, mentre le proteine sono formate da lunghe catene di amminoacidi, legati tra loro in una precisa sequenza: in che modo i due linguaggi chimici possono comunicare tra di loro?
AU
2 La molecola dell’RNA


Rappresentazione di un nucleotide di RNA e del filamento.
AU
basi azotate CG acido fosforico nucleotide
basi azotate CG acido fosforico
I mattoni per formare una nuova proteina, cioè gli amminoacidi, sono presenti nel citoplasma della cellula e provengono dalla demolizione delle proteine contenute nei cibi. Le informazioni necessarie per costruire correttamente la proteina, invece, sono contenute nel DNA, all’interno del nucleo. La molecola che mette in comunicazione il nucleo con il citoplasma portando le informazioni per assemblare le proteine è un altro acido nucleico, l’acido ribonucleico, o RNA.
Come il DNA, anche l’RNA è formato da una sequenza di nucleotidi, ma la molecola è costituita da un solo filamento; lo zucchero nei nucleotidi è il ribosio; le basi azotate sono adenina, guanina, citosina e al posto della timina è presente l’uracile (U) 1
AU

nucleotide di RNA zucchero (ribosio)
base azotata

basi azotate CG acido fosforico
Nelle cellule sono presenti tre tipi di RNA ognuno con una specifica funzione:
• l’RNA messaggero mRNA), che porta l’informazione del DNA dal nucleo al citopla sma 2 ;
• l’RNA ribosomiale rRNA), che è il costituente fondamentale dei ribosomi 3 ;
• l’RNA di trasferimento (o tRNA), presente nel citoplasma, che trasporta gli ammino acidi sui ribosomi. Esistono 20 tipi di tRNA, uno per ogni amminoacido 4 .
2 RNA messaggero.

sito di legame per il tRNA
subunità maggiore
subunità minore sito di legame per l’mRNA











3 RNA ribosomiale.






nucleotide di RNA zucchero (ribosio)
base azotata
tripletta che si lega a uno specifico amminoacido
anticodone che si lega a una tripletta dell’mRNA


4 RNA di trasferimento.
Fenilalanina
Leucina
Leucina Serina Prolina
Isoleucina
Metionina Codone di inizio
5 La tabella riporta le 64 triplette e gli amminoacidi corrispondenti.
Tirosina Cisteina
Codone di stop Codone di stop Codone di stop Triptofano
Istidina
Glutammina
Arginina
Asparagina Serina
Acido aspartico
Acido glutamminico Lisina
Arginina
3
Il codice genetico
Il DNA può essere paragonato a un “linguaggio” in cui, invece delle lettere dell’alfabeto, si usano i nucleotidi. Si tratta dunque di un alfabeto formato solo da quattro lettere: A, T, G e C. Le proteine invece utilizzano un linguaggio in cui le lettere dell’alfabeto sono i 20 amminoacidi esistenti in natura. Perciò non è possibile che a un singolo nucleotide corrisponda un amminoacido. Anche due coppie di nucleotidi non bastano per indicare tutti e 20 gli amminoacidi, perché le combinazioni possibili sono solamente 16; di conseguenza rimangono esclusi 4 amminoacidi. Per specificare i 20 amminoacidi sono necessari tre nucleotidi, cioè una tripletta o codone : infatti, prendendo i nucleotidi tre a tre, si ottengono 64 triplette diverse.
La corrispondenza tra le diverse triplette e gli amminoacidi costituisce il codice genetico.
Il codice genetico è formato dalla sequenza di 3 basi azotate (le triplette), ciascuna delle quali corrisponde a (codifica per) un amminoacido 5 . 64 triplette sono eccessive per 20 amminoacidi: il fatto è che ogni amminoacido è rappresentato da più di una tripletta. Tre delle 64 triplette, inoltre, non corrispondono a nessun amminoacido, ma segnano la fine della catena proteica; una tripletta, invece, funziona da segnale d’inizio ed è associata all’amminoacido metionina . Si dice che il codice genetico è ridondante , perché più triplette possono corrispondere a un singolo amminoacido. Il codice genetico è anche universale : ogni tripletta porta le informazioni per la sintesi di un determinato amminoacido in qualunque essere vivente.
4 La trascrizione, la sintesi dell’RNA messaggero
Come si costruisce una proteina? La figura 6 riassume schematicamente tutto il processo.
L’informazione contenuta nel DNA viene riprodotta sull’RNA messaggero con un meccanismo simile a quello della duplicazione del DNA. Il tratto della doppia elica di DNA che porta le informazioni per una determinata proteina si apre e su uno dei due filamenti si agganciano i nucleotidi di RNA presenti. Questo filamento di DNA funziona da stampo per la costruzione del filamento complementare di RNA. In questo processo avviene la trascrizione dell’informazione.
La trascrizione è il passaggio dell’informazione dal DNA all’RNA messaggero.
Quando la trascrizione è terminata, l’mRNA si stacca dal filamento di DNA, che si chiude. La doppia elica si ricompone.
Treonina
Valina Alanina
Glicina
5
La
traduzione delle informazioni e la sintesi delle proteine
L’mRNA esce dal nucleo attraverso i pori della membrana nucleare, si muove nel citoplasma e va a fissarsi sui ribosomi. A questo punto entra no in gioco le molecole di tRNA. Le triplette presenti sul tRNA si legano al corrispondente amminoacido. La molecola di tRNA con il suo amminoacido si aggancia, grazie all’anticodo ne, alla tripletta complementare dell’mRNA. I vari amminoacidi allineati si saldano tra di loro, formando la proteina richiesta che, una volta completata, abbandona il ribosoma.



La traduzione è il processo di costruzione di una proteina sulla base delle informazioni contenute nell’RNA messaggero.

Il messaggio dell’mRNA, scritto come sequenza di triplette, viene tradotto in una sequenza di amminoacidi, cioè in una determinata proteina. Ogni cellula contiene l’intero patrimonio gene tico, ma solo i tratti di DNA che servono davve ro alla cellula vengono trascritti nell’mRNA. Per esempio, il segmento che codifica per le proteine actina e miosina necessarie nella contrazione muscolare viene trascritto solo nelle cellule muscolari.



6 La sintesi delle proteine.
FISSA I CONTENUTI ESSENZIALI
Completa le frasi con i termini corretti.
1. Le proteine attivano e controllano le che rendono possibile la vita delle cellule.
2. La molecola di contiene la base azotata uracile.
3. Il è costituito dalla corrispondenza tra le diverse basi azotate e gli amminoacidi.
4. Il passaggio dell’informazione dal DNA all’mRNA prende il nome di
VERSO LE COMPETENZE
Osserva con attenzione la figura 6 . Rispondi alle domande.
1. Dove sono contenute le informazioni per la sintesi di una particolare proteina?
2. Dove avviene la fase di trascrizione?
3. Quale funzione svolge l’mRNA?
4. Su quale organulo cellulare avviene la fase di traduzione?
5. Quale funzione svolge il tRNA?
citoplasma
La sintesi delle proteine
Le leggi di mendel lezione 3
Guarda il video e scrivi le risposte sul quaderno.
CARTA PENNA COMPUTER

I meccanismi dell’ereditarietà
1. Perché Mendel scelse la pianta di pisello per i suoi esperimenti?
2. Quale caratteristica della pianta di pisello ha sfruttato Mendel per ottenere delle linee pure?
3. Quali caratteristiche presenta un organismo di linea pura?
4. Quali sono stati i risultati dei suoi esperimenti?
ORA FERMA L’IMMAGINE!
Metti in pausa il video nei seguenti punti.


5. Dai un titolo a ciascuna immagine.
6. Descrivi le caratteristiche delle piante della generazione F1 e di quelle della generazione F2.
1 Il padre della genetica
Seconda metà dell’Ottocento: mentre Charles Darwin, nella tranquillità della sua casa di campagna, elabora la teoria dell’evoluzione, nell’orto del monastero di Brno, in Moravia, il monaco Gregor Mendel (1822-1884) esegue i suoi esperimenti sulle piante di pisello per comprendere come si trasmettono i caratteri ereditari.
I due grandi scienziati vivono nello stesso periodo storico ma non si incontrano mai: Mendel, però, legge i libri di Darwin, mentre Darwin non viene mai a conoscenza dei risultati delle sperimentazioni di Mendel, che, probabilmente, gli avrebbero permesso di risolvere il punto debole della sua teoria, cioè l’ereditarietà dei caratteri.
Allora si pensava che le caratteristiche di un organismo fossero il risultato del rimescolamento dei caratteri dei genitori, che potevano passare ai figli miscelati in proporzioni variabili. Mendel, invece, elabora l’ipotesi che i caratteri ereditari siano determinati da “fattori” che passano dai genitori ai figli come unità distinte, stabili e indipendenti.
Nel 1866 Mendel pubblica Esperimenti sulle piante ibride, l’opera nella quale espone le conclusioni delle sue osservazioni compiute su più di 28 000 piantine di pisello. Il libro non ha successo e la maggior parte degli scienziati non comprende le idee di Mendel: il suo lavoro viene riscoperto solo nel 1900.
Oggi Mendel è ritenuto il fondatore di un nuovo settore della biologia, la genetica
La genetica è il settore della biologia che studia i meccanismi con cui i caratteri ereditari sono trasmessi da una generazione all’altra.
2
Il metodo di Mendel
Gregor Mendel affronta lo studio della trasmissione dei caratteri ereditari utilizzando i criteri del metodo scientifico.
■ LA SCELTA DELL’ORGANISMO DA USARE NEGLI ESPERIMENTI
Mendel sceglie la pianta di pisello, Pisum sativum, perché offre molti vantaggi: è facile da coltivare, cresce e si riproduce rapidamente. Inoltre ne esistono diverse varietà con caratteri ben definiti: piante con il fusto lungo e piante con il fusto corto, con i fiori viola e con i fiori bianchi 1 , con i semi lisci e con i semi rugosi.
■ LA SCELTA DEL METODO DI OSSERVAZIONE
Lo scienziato decide di osservare un carattere per volta della pianta di pisello, in modo da interpretare con chiarezza i risultati ottenuti dagli incroci.


1 I caratteri della pianta di pisello.












forma del seme
colore del fiore viola bianco colore del seme


colore del seme
colore del seme


giallo


■ LA RIPETIZIONE DEGLI ESPERIMENTI PER OTTENERE IL MAGGIOR NUMERO DI RISULTATI POSSIBILI


colore del fiore viola bianco
colore del fiore viola bianco
forma del seme
Per ogni incrocio Mendel fa in modo di ottenere tantissime piantine per verificare i risultati in un gran numero di casi.





■ L’INTERPRETAZIONE MATEMATICA DEI RISULTATI
giallo liscio verde
forma del seme

liscio verde
Mendel interpreta i risultati ottenuti facendo uso della statistica e del calcolo delle probabilità, per arrivare a formulare delle leggi che spieghino la regolarità della trasmissione dei caratteri ereditari.


colore del fiore viola bianco
forma del seme
forma del seme





colore del fiore viola bianco colore del seme
colore del fiore viola bianco colore del seme


colore del
colore del
colore del
giallo liscio verde verde rugoso
giallo liscio verde verde rugoso
lunghezza dello stelo
giallo liscio verde verde rugoso
lunghezza dello stelo
lunghezza dello stelo
colore del baccello forma del baccello
colore del baccello forma del baccello
colore del fiore


















colore del seme




forma del seme

lungo corto

3 Linee pure e ibridi







lungo corto
lungo corto

giallo verde irregolare pieno rugoso
giallo verde irregolare pieno rugoso
bianco
lunghezza dello stelo posizione dei fiori

lunghezza dello stelo posizione dei fiori
lunghezza dello stelo


colore del seme

La pianta di pisello presenta un’altra caratteristica vantaggiosa: l’autoimpollinazione. Nei fiori gli stami e i pistilli sono completamente avvolti dai petali, perciò il polline di un fiore può facilmente fecondare gli ovuli dello stesso fiore. Quando l’autofecondazione si ripete per molte generazioni si ottengono piante di linea pura, cioè piante che presentano sempre gli stessi caratteri. Mendel era un abile botanico e sapeva in che modo praticare l’ impollinazione incrociata per impedire l’autoimpollinazione. Per ottenere un incrocio tra piante di pisello con caratteristiche diverse, per esempio piante di linea pura con i fiori viola e piante di linea pura con i fiori bianchi, si comportava in questo modo 2 (a pagina seguente): dai fiori di una pianta toglieva le antere prima che su di esse maturasse il polline e poi, con un pennellino, cospargeva i fiori privati delle antere con il polline dell’altro tipo di pianta da lui scelta. In questo modo otteneva degli ibridi , figli di genitori di due diverse linee pure che presentavano solo alcuni caratteri.








colore del baccello forma del baccello










lungo corto assiale terminale
forma del seme giallo liscio verde giallo verde irregolare pieno rugoso
lunghezza dello stelo




posizione dei fiori



lungo corto assiale terminale



colore del






liscio verde rugoso





1. Si rimuovono le antere di un fiore.

piante di linea pura
piante di linea pura







3. Si sviluppa un bacello contenente i semi.























2. Con un pennellino, si cosparge sul pistillo il polline prelevato da un altro fiore.
4 La prima legge di Mendel














Prima legge di Mendel.






4 Seconda legge di Mendel.








4. I semi vengono piantati.
Mendel era interessato a osservare i risultati dell’impollinazione incrociata. Per questa ragione incomincia i suoi esperimenti incrociando tra loro due piante di linea pura che presentano due forme distinte di uno stesso carattere: per esempio, piante di pisello che da molte generazioni hanno solo fiori viola e piante di pisello che da molte generazioni hanno solo fiori bianchi. Egli chiama queste piante generazione parentale e le indica con il simbolo P. Successivamente chiama gli ibridi prodotti dall’incrocio prima generazione filiale e li indica con il simbolo F 1 . Al momento della fioritura, Mendel osserva che i fiori della generazione F 1 sono tutti uguali e di colore viola. Mendel definisce dominante il carattere “colore del fiore viola” che si manifesta nella prima generazione e recessivo il carattere “colore del fiore bianco” che non compare. Ripete lo stesso esperimento per altri caratteri (seme liscio e seme rugoso, seme giallo e seme verde, fusto lungo e fusto corto) e ottiene sempre lo stesso risultato: uno compare nella pianta e l’altro no. Sulla base di queste osservazioni, Mendel formula la prima legge dell’ereditarietà o legge della dominanza 3
La prima legge di Mendel afferma che incrociando individui appartenenti a linee pure che differiscono per un carattere, si ottengono individui che presentano uno solo dei caratteri, quello dominante, mentre quello recessivo non si manifesta.
5 La seconda legge di Mendel
Mendel prosegue i suoi esperimenti e lascia che le piante della prima generazione si autofecondino. La seconda generazione filiale, indicata con il simbolo F2, risulta composta all’incirca per il 75% da piante che presentano il carattere dominante (fiore viola, seme giallo e liscio) e per il 25% da piante in cui compare il carattere recessivo (fiore bianco, seme verde e rugoso). Mendel formula allora la seconda legge dell’ereditarietà o legge della segregazione dei caratteri ereditari 4 .
La seconda legge di Mendel afferma che negli individui della seconda generazione filiale i due caratteri compaiono secondo il rapporto costante 3 : 1.
ibridi
ibridi
Per spiegare i risultati ottenuti Mendel formula alcune ipotesi, confermate da successivi risultati sperimentali:
• in ogni pianta di pisello c’è una coppia di fattori cui corrisponde un determinato carattere (per esempio il colore del fiore);
• i due fattori presenti in una pianta si separano quando vengono prodotti i gameti (polline e ovuli), perciò ogni gamete riceve un solo fattore;
• per ogni coppia di fattori che determina un carattere della pianta di pisello ce n’è sempre uno dominante e uno recessivo.
6 La terza legge di Mendel
Mendel realizza altri esperimenti in cui incrocia due piante di pisello di linea pura che presentano, rispettivamente, due caratteri dominanti, per esempio semi gialli e lisci, e i due caratteri recessivi, cioè semi verdi e rugosi. Come previsto dalla prima legge, Mendel ottiene una prima generazione interamente composta da piante con i semi gialli e lisci, cioè con entrambi i caratteri dominanti. Lascia che queste piante si autofecondino e attende la maturazione dei frutti delle piante di generazione F2: su 356 semi prodotti, 315 sono gialli e lisci, 102 sono gialli e rugosi, 108 sono verdi e lisci, mentre solo 32 sono verdi e rugosi. I risultati di questo esperimento indicano che, incrociando due piante ibride, si ottengono una parte di esemplari con entrambi i caratteri dominanti, una parte con caratteri dominanti e recessivi combinati in un nuovo modo e una minima parte con entrambi i caratteri recessivi, in un rapporto di 9 : 3 : 3 : 1. I caratteri giallo-liscio e verde-rugoso, che inizialmente erano combinati nelle piante di linea pura, si comportano come se fossero del tutto separati gli uni dagli altri. Mendel formula così la terza legge dell’ereditarietà o legge dell’indipendenza dei caratteri 5



semi gialli lisci
La terza legge di Mendel afferma che i caratteri sono trasmessi da fattori indipendenti l’uno dall’altro e liberi di comparire nei discendenti in combinazioni diverse da quelle presenti nei genitori.
FISSA I CONTENUTI ESSENZIALI
Abbina i termini con la definizione corretta.
1 Genetica
2 Legge della dominanza
3 Legge della segregazione dei caratteri ereditari
4 Legge dell’indipendenza dei caratteri
1: 2: 3: 4:
semi gialli rugosi


semi
a I caratteri sono trasmessi da fattori indipendenti l’uno dall’altro e liberi di comparire nei discendenti in combinazioni diverse da quelle dei genitori.
b Settore della biologia che studia i meccanismi con cui i caratteri ereditari si trasmettono da una generazione all’altra.
c Negli individui della seconda generazione filiale i due caratteri compaiono secondo il rapporto costante 3 : 1.
d Incrociando individui appartenenti a linee pure che differiscono per un carattere, si ottengono individui che presentano solo il carattere dominante, mentre quello recessivo non si manifesta.
P
F1
5 Terza legge di Mendel.
geni e cromosomi lezione 4
Guarda il video e scrivi le risposte sul quaderno.
CARTA PENNA COMPUTER

La nascita della genetica moderna
1. Quali vantaggi offre l’utilizzo della Drosophila per gli esperimenti di genetica?
2. Chi è stato il primo genetista a utilizzare la Drosophila?
3. In che anno sono iniziati gli studi di genetica?
4. Quanti cromosomi si osservano nella Drosophila?
5. Qual è il colore dominante degli occhi della Drosophila?
ORA FERMA L’IMMAGINE!
Metti in pausa il video nei seguenti punti.

6. Dai un titolo a ciascuna immagine.

7. Scrivi un breve testo per spiegare come i risultati degli esperimenti di Morgan abbiano dimostrato la validità delle leggi di Mendel.
1 Dai fattori di Mendel ai geni
1 In alcune cellule si riconoscono dei filamenti: sono i cromosomi. In altre si osserva una “matassa”: è la cromatina.
Mendel aveva chiamato “fattori” le unità che contengono i caratteri ereditari e individuato le leggi che ne regolano la trasmissione dai genitori ai figli. Egli, tuttavia, non sapeva dove fossero collocati e neppure di che cosa fossero fatti. Lo sviluppo delle tecniche di osservazione delle cellule ha permesso, all’inizio del ventesimo secolo, di identificare nei cromosomi i depositari dei “fattori” mendeliani. Durante il processo di divisione cellulare, nel nucleo di qualsiasi cellula è possibile osservare la formazione di filamenti che si appaiano a due a due. A questi filamenti è stato dato il nome di cromosomi , che significa “corpi colorati”, vista la facilità con la quale si colorano a contatto con particolari sostanze 1 .

Così trattati, i cromosomi appaiono striati e suddivisi in bande di diversa larghezza, collocate nella stessa posizione su ciascuno dei cromosomi appaiati.
È stato facile riconoscere in queste coppie di bande i fattori identificati da Mendel. Successivi esperimenti eseguiti sui grandi cromosomi del moscerino della frutta hanno confermato che a certe striature dei cromosomi corrisponde la comparsa di specifiche caratteristiche nell’organismo: erano stati identificati i geni
Un gene è un segmento di cromosoma nel quale è contenuta l’informazione per la sintesi di una particolare proteina.
2 Cromosomi, alleli e caratteri
In tutti gli individui della stessa specie, e in ogni loro cellula, il numero di cromosomi è costante ed è tipico di quella specie: per esempio le cellule di zanzara possiedono 12 cromosomi, le cellule del pesce rosso ne possiedono 94, quelle del cane 78 e quelle umane 46 1 Tab.
Può capitare che alcune specie abbiano lo stesso numero di cromosomi: per esempio il gorilla e la patata hanno 48 cromosomi nelle loro cellule, ma ovviamente le informazioni che contengono sono molto differenti. Il numero di cromosomi si mantiene costante nelle cellule di un individuo grazie a due importanti meccanismi di divisione cellulare: la mitosi e la meiosi. Il processo di divisione cellulare che distribuisce alle cellule figlie una copia esatta delle informazioni genetiche della cellula madre è la mitosi .
La meiosi è il processo mediante il quale un organismo produce le cellule riproduttive, cioè i gameti maschili (spermatozoi) o i gameti femminili (ovuli). I gameti contengono solo la metà dei cromosomi in modo tale che, alla fecondazione, si ricompone il numero di cromosomi tipico della specie 2 . I cromosomi che sono simili tra loro per dimensioni e forma, appaiati a due a due costituiscono coppie di cromosomi omologhi , in cui un cromosoma è di origine paterna e l’altro è di origine materna.
Sul cromosoma di ciascuna coppia si trovano geni simili, situati su tratti corrispondenti: sono gli alleli , responsabili di uno stesso carattere 3 . Gli alleli possono essere identici tra loro oppure diversi. Per esempio possono contenere entrambi le informazioni per il carattere “colore occhi azzurri”: in questo caso si dice che l’or ganismo è omozigote per quel carattere. Oppure, possono portare l’uno l’informazione per il carattere “colore occhi az zurri”, l’altro per il carattere “colore occhi marroni”: in questo caso l’organismo viene detto eterozigote per quel particolare carattere.

2 La fecondazione.



















cellula del corpo









3 Una coppia di cromosomi omologhi con alleli per caratteri diversi per la pianta di pisello.


liscio
allele per il colore del baccello
allele per la lunghezza dello stelo verde lungo
rugoso giallo
corto
ovulo
spermatozoo
ovulo ovulo



Un allele è dominante quando i suoi effetti su un certo carattere mascherano gli effetti dell’allele corrispondente, il quale invece viene detto recessivo. Gli alleli di uno stesso carattere vengono indicati con due lettere uguali dell’alfabeto: maiuscole se sono alleli dominanti, minuscole se sono recessivi.
Per esempio, R indica l’allele dominante per il colore rosso del fiore, r l’allele recessivo. RR indica un individuo omozigote dominante per il colore del fiore; rr indica un individuo omozigote recessivo; Rr un individuo eterozigote.
La combinazione degli alleli che un individuo possiede ed è in grado di trasmettere alle successive generazioni costituisce il suo genotipo. Il fenotipo indica, invece, l’insieme delle caratteristiche osservabili dell’individuo, ovvero il modo in cui i caratteri si manifestano.
I gemelli monozigoti sono perfettamente somiglianti: nascono da un singolo ovulo fecondato che ha dato origine a due embrioni. Il loro fenotipo identico è dovuto al fatto che possiedono lo stesso genotipo.
4 La spiegazione della prima legge di Mendel.
3 L’interpretazione delle leggi di Mendel




SCIENZA






La scoperta dei cromosomi e dei geni ha confermato le leggi enunciate da Mendel che oggi sono così interpretate. Gli individui della linea pura possiedono due alleli uguali per uno stesso carattere, sono cioè omozigoti. Le piante di pisello che producono semi gialli hanno un genotipo GG, mentre le piante che producono semi verdi hanno un genotipo gg 4 . I gameti prodotti da due individui della linea pura hanno un solo tipo di allele: G per le piante a seme giallo e g per le piante a seme verde.
La fecondazione produce uno zigote ibrido, con un allele dominante e uno recessivo, da cui si svilupperà un organismo eterozigote per un determinato carattere (avrà, per esempio, come genotipo Gg e produrrà solo semi gialli). Ciascuna pianta ibrida produce sia gameti con l’allele domi -
È
vero che tutti i gemelli sono identici?
No, è una falsa credenza. Dal punto di vista biologico, sono gemelli le persone nate contemporaneamente. I gemelli perfettamente uguali, perché presentano caratteristiche fenotipiche identiche, si sono formati a partire da un solo ovulo fecondato da un unico spermatozoo e si chiamano gemelli omozigoti. Dalla fecondazione di due ovuli, per opera di due spermatozoi diversi, hanno invece origine i gemelli dizigoti (o eterozigoti) che possono essere dello stesso sesso, di sesso diverso, possono assomigliarsi oppure no, proprio come tutti i fratelli e le sorelle, in quanto non hanno gli stessi cromosomi e gli stessi geni.
nante (G), sia gameti con l’allele recessivo (g). Per risolvere i problemi di genetica, cioè per sapere come si trasmette un carattere facendo incrociare due organismi, si usa una rappresentazione grafica chiamata quadrato di Punnett 5 .
Il quadrato di Punnett è un diagramma che permette di determinare la probabilità di fenotipi e di genotipi che compaiono nella prole generata da un particolare incrocio.

CODING
IL QUADRATO DI PUNNET
SKILL BOOK
Su un lato del quadrato si riportano i gameti prodotti da un genitore e sull’altro quelli prodotti dall’altro genitore: nelle caselle che rimangono si scrivono i risultati degli incroci dei gameti. Il quadrato di Punnett
5 L’interpretazione delle leggi di Mendel con il quadrato di Punnett.
Prima legge: incrocio tra due linee pure di pisello con semi gialli e semi verdi.

SCIENZE & MAT
GRUPPI SANGUIGNI E GENETICA
SKILL BOOK
Seconda legge: incrocio tra due ibridi di pisello.

Terza legge: incroci tra ibridi che differiscono per più di un carattere. In questo caso il colore (giallo-verde) e la superficie (liscia-ruvida).

FISSA I CONTENUTI ESSENZIALI
Segna con una crocetta se vero (V) o falso (F).
1. Il termine cromosoma significa “corpo bianco”.
2. Un gene è un segmento di cromosoma nel quale è contenuta l’informazione per la sintesi di qualsiasi proteina.
3. Un individuo è omozigote quando possiede alleli identici per un carattere.
4. Il genotipo indica l’insieme delle caratteristiche osservabili dell’individuo.
5. Il quadrato di Punnett è un diagramma usato per risolvere i problemi di genetica.
La genetica umana lezione 5
CARTA PENNA COMPUTER

1 Il cariotipo umano.
Esplora l’oggetto interattivo e scrivi le risposte sul quaderno.

1. Quando è iniziato il Progetto Genoma Umano?
2. Che cosa si prefiggeva il Progetto Genoma Umano?
3. Quanti sono i geni umani attualmente mappati?
4. Perché l’invecchiamento dei geni può provocare malattie?
5. Qual è il futuro della ricerca in questo campo?
6. Che cos’è il “genoma spazzatura”?
1 I cromosomi che determinano il sesso
Tutte le caratteristiche di un organismo sono controllate da geni presenti sui cromosomi. La rappresentazione ordinata dei cromosomi di un organismo, con i cromosomi omologhi appaiati, è chiamata cariotipo
Nella specie umana, il cariotipo è costituito da 46 cromosomi, cioè 23 coppie di cromosomi omologhi: 22 coppie sono uguali sia nei maschi sia nelle femmine, e i cromosomi che le compongono sono detti autosòmi; la ventitreesima coppia è diversa nei maschi e nelle femmine ed è costituita dai cromosomi sessuali 1 .
I cromosomi sessuali sono indicati con le lettere X e Y per la loro forma: nei maschi la coppia di cromosomi sessuali è composta da un cromosoma X e da un cromosoma Y (XY), mentre le femmine presentano due cromosomi X (XX).


La ricerca di Hasler
cromosoma X
cromosoma Y
Il Progetto Genoma Umano
2 La determinazione del sesso
Nella specie umana, le cellule che formano l’organismo (cellule somatiche) contengono l’intero cariotipo, cioè 46 cromosomi accoppiati in 23 coppie di omologhi. Le uniche cellule che fanno eccezione sono i gameti, cioè le cellule riproduttive (spermatozoi e ovuli): esse contengono solo 23 cromosomi, uno per ogni coppia di cromosomi omologhi. Come sai, il processo che dimezza il numero dei cromosomi e porta alla formazione dei gameti è la meiosi. La meiosi avviene all’interno dell’apparato riproduttore del maschio e della femmina. Grazie a questo processo, nelle femmine si formano ovuli con 22 autosomi e un solo cromosoma sessuale X, mentre nei maschi vengono prodotti spermatozoi che contengono 22 autosomi e, nel 50% dei casi il cromosoma X, nell’altro 50% il cromosoma Y.
Nella nostra specie, il sesso del nascituro è determinato dal gamete maschile durante la fecondazione della cellula uovo: uno spermatozoo portatore del cromosoma X, unendosi alla cellula uovo darà origine a una femmina (XX), mentre uno spermatozoo portatore del cromosoma Y darà origine a un maschio (XY). In ogni caso, vi è la stessa probabilità (50%) che si verifichi la combinazione XX o la combinazione XY 2 .
3 I caratteri mendeliani nella specie umana
2 Come viene determinato il sesso.

gameti femminili (cellule uovo)
cellule che danno origine ai gameti
Y gameti maschili (spermatozoi)


Alcuni caratteri della nostra specie sono la manifestazione di una sola coppia di alleli, dominanti o recessivi, presenti sui cromosomi: la loro trasmissione segue le leggi di Mendel e perciò vengono chiamati caratteri mendeliani. Sono caratteri di questo tipo le lentiggini, alcune malattie come l’albinismo, la malattia di Huntington e il profilo del naso 3 La maggior parte dei caratteri, tuttavia, sono il risultato dell’azione di più geni. Il colore della pelle, per esempio, è un carattere poligenico perché è determinato da almeno tre geni disposti in posizioni diverse sui cromosomi.
Nella specie umana, l’allele “naso aquilino” è dominante rispetto a quello “naso dritto”. Indichiamo con A l’allele dominante e con a l’allele recessivo.




Individuo omozigote dominante: genotipo AA e fenotipo “naso aquilino”.
Individuo eterozigote: genotipo Aa e fenotipo “naso aquilino”.


I colori della pelle
3 Che forma avrà il naso?
Da due genitori eterozigoti per il naso aquilino nascono individui con tre possibili genotipi ma solo due fenotipi nel rapporto 3 : 1 della seconda legge di Mendel.

Individuo eterozigote: genotipo Aa e fenotipo “naso aquilino”.


Individuo omozigote recessivo: genotipo aa e fenotipo “naso dritto”.
È vero che l’albinismo è una grave malattia che può essere contagiosa?
SCIENZA

No, la perdita di melanina da parte della pelle non è una malattia infettiva, ma una malattia genetica, chiamata albinismo, causata da un’alterazione dei numerosi geni (circa 11!) implicati nella produzione della melanina, la proteina che pigmenta pelle, capelli e occhi. Le persone albine hanno la pelle molto chiara, i capelli e i peli quasi bianchi e l’iride rosa. Se entrambi i genitori sono affetti da albinismo, anche i figli manifestano questa patologia. La malattia può anche essere scatenata da una mutazione puntiforme del gene che codifica per l’enzima tirosinasi, senza il quale l’organismo non produce più melanina. Malgrado la scienza abbia chiarito le cause dell’albinismo, in molte parti del mondo le persone albine sono discriminate e spesso perseguitate. Organizzazioni internazionali e associazioni lavorano instancabilmente per proteggere i diritti delle persone albine e per diffondere informazioni corrette, contrastando la discriminazione e offrendo supporto.
4
Le malattie genetiche autosomiche
I cromosomi e i geni che essi contengono possono subire delle mutazioni
Una mutazione è un cambiamento del patrimonio genetico di un individuo e può essere ereditata dalle cellule figlie.
Le cause delle mutazioni sono numerose e molte sono ancora sconosciute: possono essere degli “errori” che avvengono durante la mitosi o la meiosi, oppure possono essere provocate da agenti mutageni , come i raggi X, le radiazioni ultraviolette, la nicotina del tabacco, molti tipi di sostanze inquinanti, conservanti e coloranti alimentari.
Le mutazioni determinano un cambiamento nel patrimonio genetico della cellula. A seconda del tipo di cellula mutata, si possono avere due casi:
• se la mutazione riguarda una cellula somatica, essa sarà ereditata solo dalle cellule che discendono dalla cellula mutata per mitosi;
• se la mutazione riguarda una cellula riproduttiva, essa sarà trasmessa alla discendenza secondo le leggi di Mendel, provocando una malattia genetica ereditaria.
Se la mutazione interessa un allele dominante si manifesta sia nell’individuo omozigote, che possiede entrambi gli alleli con la mutazione, sia nell’individuo eterozigote. Malattie genetiche di questo tipo sono il nanismo, la malattia di Huntington e la distrofia muscolare. Quando invece la mutazione si trova su un gene recessivo, si manifesta solo nell’individuo omozigote. L’individuo che ha un solo allele mutato è detto portatore sano: non è ammalato ma può trasmettere l’allele difettoso e quindi la malattia. Sono malattie genetiche di questo tipo la fibrosi cistica e l’anemia mediterranea.
5 Le malattie genetiche portate dai cromosomi sessuali
Il cromosoma Y è lungo circa un terzo del cromosoma X, di conseguenza la maggior parte dei geni del cromosoma X non hanno il loro corrispondente nel cromosoma Y. Nei maschi, pertanto, un allele recessivo presente sull’unico cromosoma X si manifesta sempre, perché manca il corrispondente allele dominante sul cromosoma Y. Alcuni di questi alleli recessivi presenti sui cromosomi sessuali sono causa di malattie genetiche che si manifestano con maggiore frequenza nel sesso maschile, come il daltonismo e l’emofilia.
Il daltonismo è una malattia dovuta a un’alterazione delle cellule della retina sensibili alla luce. Si manifesta con una ridotta capacità di distinguere i colori, soprattutto il rosso e il verde che appaiono come grigi.
La malattia è provocata da un gene recessivo, situato sul cromosoma X, che solitamente viene indicato con X+. Nei maschi, non essendo presente un altro cromosoma X che impedisca l’espressione dell’allele recessivo difettoso, la malattia si manifesta sempre, mentre le femmine sono portatrici sane 4 L’emofilia è una grave malattia che determina la difficoltà del sangue di coagulare; di conseguenza, le persone emofiliache soffrono di emorragie provocate da ferite anche lievi.
4
La trasmissione del daltonismo.
Da una madre daltonica e un padre sano, nasceranno femmine tutte portatrici sane e maschi tutti daltonici.
Da una madre portatrice e un padre sano, nasceranno per il 25% femmine portatrici, per un altro 25% femmine sane, per il 25% maschi daltonici e per il rimanente 25% maschi sani.
madre daltonica
madre daltonica
padre sano
padre sano
madre portatrice
madre portatrice
padre sano
padre sano
FISSA I CONTENUTI ESSENZIALI
Abbina i termini con la definizione corretta.
1 Cariotipo
2 Cellule somatiche
3 Carattere poligenico
4 Mutazione
5 Portatore sano
(femmine portatrici)
(femmine sane)
XX (femmine sane)
(maschi daltonici)
X+Y (maschi daltonici)
(maschi sani)
XY (maschi sani)
a Rappresentazione ordinata dei cromosomi di un organismo, con i cromosomi omologhi appaiati.
b È determinato da almeno tre geni situati in posizioni diverse sui cromosomi.
c Cambiamento del patrimonio genetico ereditabile dalle cellule figlie.
d Individuo che possiede un solo allele mutato.
e Contengono l’intero cariotipo di un organismo.
1: 2: 3: 4: 5:
VERSO LE COMPETENZE
Leggi il testo, completa il quadrato di Punnett e rispondi alla domanda. Il gruppo sanguigno di due genitori è rispettivamente di tipo A (genotipo A0) e di tipo AB (genotipo AB). I caratteri A e B (gruppo sanguigno A, gruppo sanguigno B) sono dominanti, mentre il carattere 0 (gruppo sanguigno 0) è recessivo.
Quali possono essere i gruppi sanguigni dei figli?
Le biotecnologie lezione 6
Esplora l’oggetto interattivo e scrivi le risposte sul quaderno.
CARTA PENNA COMPUTER

Le biotecnologie
1. Quando gli esseri umani hanno iniziato a selezionare specie animali e vegetali?
2. In che cosa consiste la tecnica del DNA ricombinante?
3. Che cosa sono gli enzimi di restrizione?
4. In che modo sono utilizzati i plasmidi?
ORA FERMA L’IMMAGINE!
Metti in pausa il video nei seguenti punti.

5. Scrivi una didascalia a commento di ogni immagine.


Dalla selezione artificiale all’ingegneria genetica
1 La grande varietà di razze canine è frutto di una lunga serie di incroci controllati.
Circa 11 000 anni fa la nostra specie ha iniziato a dedicarsi all’agricoltura e all’allevamento, imparando a sfruttare a proprio vantaggio la grande varietà di caratteristiche genetiche di piante e animali. Incrociando tra loro solo organismi che possedevano certe caratteristiche, per esempio cereali che producevano le spighe più grosse e compatte, o pecore con il pelo più lungo e folto, si favorì l’affermazione di geni particolarmente vantaggiosi e si ottennero cambiamenti nei genotipi, agendo esclusivamente sui fenotipi. Attraverso queste tecniche di biotecnologie tradizionali gli esseri umani hanno manipolato il DNA e hanno determinato la comparsa di numerosissime razze di animali da allevamento e di varietà di piante coltivate 1 .



Nel secolo scorso, la scoperta del DNA ha segnato l’inizio di una rapidissima evoluzione della ricerca nel campo della genetica, permettendo di mettere a punto numerose tecniche per intervenire direttamente sul genotipo degli organismi. I pesci d’acquario chiamati GloFish, per esempio, sono il risultato di una manipolazione del loro DNA che li ha resi fluorescenti 2
Le biotecnologie avanzate, o tecniche di ingegneria genetica, intervengono direttamente sul DNA di alcuni organismi per modificarne le proprietà naturali.
2 La tecnica del DNA ricombinante
Una delle tecniche di ingegneria genetica più diffusa è quella del DNA ricombinante. Un gene, che contiene l’informazione necessaria per produrre una specifica proteina, viene estratto e successivamente inserito nel patrimonio genetico di un batterio. Il trasferimento del gene avviene tra due specie che in natura non si incrociano e il risultato è una molecola “artificiale” di DNA, chiamata DNA ricombinante . La cellula batterica che riceve il DNA ricombinante duplica i nuovi geni “estranei” e sintetizza le proteine che essi codificano.
Oggi questa tecnica viene usata con successo nella produzione di molte sostanze utili in medicina, come l’insulina umana, un ormone necessario per la cura delle persone malate di diabete 3 . I batteri, posti nelle condizioni adatte, si riproducono velocemente per mitosi e producono grandi quantità di insulina in breve tempo. In precedenza questo ormone veniva estratto da maiali e bovini, ma si trattava di una molecola molto simile a quella umana, non identica e, in alcuni casi, provocava gravi effetti collaterali.
1. Si interviene su una cellula umana: il gene per l’insulina viene isolato ritagliandolo dal DNA grazie agli enzimi di restrizione che funzionano come “forbici molecolari”.

cellula umana
cromosoma batterico


2 Un prodotto dell’ingegneria genetica.

3 La produzione di insulina con DNA ricombinante.
4. Il batterio si duplica ripetutamente e i plasmidi ricombinanti sintetizzano l’insulina, che viene estratta e purificata.


























umano plasmide
estrazione e apertura del plasmide gene per l’insulina
2. Si interviene su un batterio: si estrae il plasmide, un filamento di DNA chiuso ad anello normalmente presente nella cellula batterica.















3. Il plasmide viene tagliato con gli enzimi di restrizione e al suo interno è inserito il gene dell’insulina: diventa un plasmide ricombinante







plasmidi che contengono il gene per l’insulina


3 Gli OGM
L’applicazione delle tecniche di ingegneria genetica ha permesso la produzione di organismi geneticamente modificati , conosciuti come OGM.
Gli organismi geneticamente modificati sono piante e animali che acquistano caratteristiche nuove grazie all’inserimento, nel loro materiale genetico, di geni di altre specie.
Le piante per l’alimentazione umana vengono geneticamente modificate per diventare più resistenti alla siccità, ai parassiti o a certi tipi di erbicidi e pesticidi e possono essere coltivate anche in territori con condizioni ambientali particolarmente difficili. La soia OGM, per esempio, è ampiamente coltivata nel mondo per l’alimentazione umana e la produzione di mangimi e biodiesel 4 a . Il riso dorato è una pianta geneticamente modificata che deve il suo colore giallo alla presenza di beta-carotene, una sostanza che l’organismo può trasformare in vitamina A 4 b
Interventi di ingegneria genetica sono stati fatti anche su animali da allevamento, come mucche, pecore, capre e maiali, per migliorare la produttività di carne e latte. La discussione relativa ai vantaggi e ai rischi legati al consumo di cibi OGM e all’impatto che questi organismi possono avere sull’ambiente è molto viva e contrappone opinioni diverse a livello internazionale. Le piante geneticamente modificate assumono caratteristiche di alta produttività e resistenza, ma riducono notevolmente la biodiversità a scapito di quelle tradizionali. Spesso le piante geneticamente modificate non si riproducono ed è quindi necessario rivolgersi ai produttori per le nuove semine, innescando un rischio di monopolio dei prodotti. È ancora in corso il dibattito sugli eventuali rischi per la salute umana riguardo l’uso di OGM: in Italia ne è vietata la coltivazione, se non per uso scientifico, ma non la vendita.
4 La clonazione
La clonazione è una tecnica di manipolazione genetica che, partendo da cellule di un individuo adulto, consente di ottenere dei cloni , cioè organismi uguali tra loro e perfettamente identici a quelli di partenza.
È vero che la nostra salute è in pericolo perché mangiamo organismi geneticamente modificati?
SCIENZA

Molte autorità scientifiche e di sicurezza alimentare, come l’Organizzazione Mondiale della Sanità (OMS) affermano che gli organismi geneticamente modificati (OGM) approvati per il consumo sono sicuri per la salute umana. Tuttavia, ci sono anche discussioni e studi in corso per monitorare eventuali effetti a lungo termine. Esistono anche preoccupazioni per possibili rischi ambientali o per la biodiversità, ma fino a oggi non ci sono prove concrete che gli OGM approvati siano pericolosi per l’ambiente. In Italia esiste il divieto di coltivare o allevare organismi geneticamente modificati, ma è consentita l’importazione da altri paesi di derivati degli OGM, solo dopo l’autorizzazione da parte di organi competenti. Gli OGM autorizzati e commercializzati sono soprattutto vegetali, come mais e soia, che a seguito di modificazioni genetiche hanno sviluppato alcune caratteristiche, quali la resistenza a certi insetti o la tolleranza ad alcuni erbicidi. I recenti progressi nell’ambito delle biotecnologie hanno portato alla nascita di nuovi OGM, ottenuti tramite tecniche di ingegneria genetica avanzata ma che, secondo gli studi condotti, hanno caratteristiche del tutto simili agli organismi presenti in natura.
4 Piante OGM.
La tecnica consiste nel prelevare una cellula appartenente a qualsiasi tipo di tessuto di un organismo adulto. Dalla cellula si estrae il nucleo per inserirlo, in seguito, in una cellula uovo, a sua volta senza il nucleo, proveniente da una femmina della stessa specie. L’uovo, così modificato, viene fatto crescere fino a un certo stadio, poi viene impiantato nell’utero di una femmina portatrice; questa, dopo una normale gravidanza, partorisce un clone. L’animale clonato possiede lo stesso patrimonio genetico dell’individuo che ha donato la cellula da cui è stato tolto il nucleo. La prima clonazione di un mammifero è stata realizzata nel 1996 da un gruppo di ricercatori scozzesi, guidati da Ian Wilmut, che hanno clonato una pecora, diventata famosa con il nome di Dolly 5 e 6 .
La clonazione permette di ottenere animali di razza selezionata tutti con le stesse caratteristiche, ma anche organismi geneticamente modificati che producono sostanze utili. Il dibattito etico sulla clonazione di animali è acceso e delicato. Al momento è vietato produrre cloni umani e incroci tra mammiferi, ma è in atto la clonazione di animali in via d’estinzione come il bisonte indiano, lo stambecco sardo, il gatto selvatico africano e un tipo di macaco.
Negli ultimi anni si è sviluppata la ricerca e la sperimentazione sulla clonazione terapeutica di tessuti a partire dalle cellule staminali , cellule non ancora differenziate, capaci cioè di dare origine ai diversi tipi di tessuti che formano l’organismo.
si estrae il nucleo dalla cellula uovo
nucleo
Pecora donatrice della cellula da clonare.
clone
Pecora che porta a termine la gravidanza.

FISSA I CONTENUTI ESSENZIALI
Segna con una crocetta se vero (V) o falso (F).
5 Ian Wilmut (1944-2023) e la pecora Dolly.


La pecora Dolly, il
6 Come è nata la pecora Dolly.
Pecora donatrice della cellula da fecondare.
cellula uovo modificata
1. Le prime biotecnologie sono state applicate 11 000 anni fa.
2. La tecnica del DNA ricombinante utilizza i virus.
3. Gli organismi OGM acquistano caratteristiche nuove grazie all’inserimento di geni di altre specie.
4. I cloni sono organismi uguali tra loro e perfettamente identici a quelli di partenza.
primo animale clonato
EDUCAZIONE CIVICA
Curare con le cellule staminali
L’uso delle cellule staminali ha aperto nuove frontiere nella terapia medica: presto le cellule staminali potranno essere impiegate nella cura di numerose malattie, come i tumori, il morbo di Parkinson, l’Alzheimer ma anche l’ictus, il diabete e le malattie cardiache.
1 Da dove provengono le cellule staminali
• Le cellule staminali embrionali sono le cellule “dal destino ancora incerto” che si formano nei primissimi stadi di vita, quando l’organismo è ancora un embrione. Sono anche chiamate totipotenti, perché in grado di differenziarsi in qualsiasi tipo di cellula che forma un organismo 1 .
• Le cellule staminali fetali provengono da tessuti di feti abortiti e presentano caratteristiche a metà strada tra cellule embrionali e cellule adulte: sono generalmente pluripotenti e non totipotenti, perché sono preposte all’accrescimento di specifici tessuti nell’embrione.

1 Alcuni tipi di cellule differenziate ottenibili da cellule staminali.
• Le cellule staminali da cordone ombelicale sono prelevate direttamente dal sangue del cordone ombelicale al momento della nascita. Sono cellule multipotenti, perché in grado di dare origine solo a cellule del sangue e, per questa ragione, vengono usate principalmente per curare forme di leucemia nei bambini. Possono anche essere trapiantate in persone affette da leucemia, in alternativa al trapianto di midollo osseo. Le cellule staminali da cordone ombelicale suscitano grande interesse nel mondo scientifico: infatti, per ciascun neonato si potrebbero creare banche di queste cellule, utilizzabili anche dopo molti anni per curare malattie insorte nella vita adulta dell’individuo.
cellule staminali
cellule nervose
cellule del sangue
cellule del muscolo cardiaco
cellule del fegato
• Le cellule staminali adulte possono essere usate per il mantenimento di tessuti in condizioni fisiologiche e per la loro riparazione. Un’interessante fonte di cellule staminali adulte è il midollo osseo: queste staminali adulte sono capaci di differenziarsi in globuli rossi nell’arco dell’intera vita di un individuo, ma si ritiene che, attraverso la manipolazione genetica, sarà possibile ottenere anche cellule cerebrali, epatiche, cardiache e nervose.
LE APPLICAZIONI TERAPEUTICHE DELLE CELLULE STAMINALI
Sistema nervoso
Sperimentazioni per la cura del Parkinson, della Sla e delle lesioni al midollo osseo.
Biotecnologie applicate alle cellule staminali
Occhio
Farmaci a base di cellule staminali per curare le ustioni della cornea.
Pelle
Produzione di lembi di pelle da impiantare a chi ha subito un’ustione.
Cuore
Miglioramento della funzionalità del cuore dopo un infarto.
Sangue
Interventi su difetti di funzionamento del sistema immunitario.
Pancreas
Produzione di insulina da staminali del pancreas.
Intestino
Ricostruzione dei villi e delle mucose intestinali.
Muscoli
Sperimentazione per la cura della distrofia muscolare.
Le cellule pluripotenti embrionali (provenienti da un embrione a uno stadio molto immaturo dello sviluppo) e anche le cellule multipotenti possono essere coltivate in laboratorio. Tuttavia, l’uso di cellule umane nella ricerca e nella terapia medica ha sollevato, nell’opinione pubblica e non solo, molti dubbi dal punto di vista etico. Nel 2012 lo scienziato britannico John Gurdon e il giapponese Shinya Yamanaka hanno ricevuto il premio Nobel per gli studi condotti sulla clonazione e sulle cellule staminali. A Gurdon è stata riconosciuta l’importanza dei risultati dei suoi esperimenti di clonazione operata per la prima volta su una rana nel 1962, che di fatto lo hanno reso l’ideatore di questa tecnica di ingegneria genetica, mentre Yamanaka ha dimostrato che, partendo da cellule adulte, è possibile ottenere cellule staminali pluripotenti indotte (IPSC), con caratteristiche del tutto simili a quelle embrionali. La possibilità di creare le IPSC risolve il problema etico e apre nuovi scenari per il loro futuro impiego in diverse terapie. In un futuro non troppo lontano, a partire da una cellula di un paziente, si potrebbero ricreare tessuti danneggiati da ritrapiantare e curare malattie come alcuni tipi di cecità o di lesioni spinali. Le IPSC, inoltre, potrebbero essere impiegate anche nella terapia genica: si preleva una cellula adulta da un paziente affetto da una malattia genetica, si inserisce una copia del gene funzionante e si converte la cellula così modificata in IPSC; a questo punto si induce la cellula staminale modificata a differenziarsi nel tipo cellulare che si desidera, che infine viene reinserito nel corpo del paziente.

SHINYA YAMANAKA
JOHN GURDON
CON LA SINTESI
lezione 1 GLI ACIDI NUCLEICI: IL DNA
Le informazioni genetiche sono contenute nell’acido desossiribonucleico, o DNA, formato da nucleotidi. Ciascun nucleotide è composto da una molecola di zucchero desossiribosio, da una di acido fosforico e da una base azotata. Le basi azotate sono quattro: adenina (A), guanina (G), citosina (C), timina (T). Le basi azotate sono complementari: l’adenina si unisce sempre con la timina e la citosina sempre con la guanina. Il DNA è formato da due filamenti di nucleotidi avvolti a doppia elica. La duplicazione del DNA, che avviene durante la mitosi, è il processo con il quale la cellula duplica il proprio materiale genetico per trasmetterlo alla generazione successiva.
lezione 2 LA SINTESI DELLE PROTEINE
Le informazioni per la sintesi delle proteine sono contenute nel DNA. La molecola che porta dal nucleo cellulare al citoplasma queste informazioni è l’acido ribonucleico, o RNA. L’RNA è formato da un solo filamento di nucleotidi, contiene lo zucchero ribosio e la base azotata uracile al posto della timina. L’RNA messaggero è coinvolto nella trascrizione delle informazioni contenute nel DNA; l’RNA ribosomiale è il costituente dei ribosomi; l’RNA di trasferimento partecipa al processo di traduzione delle proteine. Tre nucleotidi, cioè una tripletta, corrispondono a uno specifico amminoacido. Esistono 64 triplette diverse per 20 amminoacidi: la loro corrispondenza costituisce il codice genetico. Il codice genetico è ridondante, perché più triplette possono corrispondere a un singolo amminoacido, e universale, perché una stessa tripletta corrisponde allo stesso amminoacido in tutti gli organismi viventi.
lezione 3 LE LEGGI DI MENDEL
Gregor Mendel è il padre della genetica, la scienza che studia la trasmissione dei caratteri ereditari. Mendel ha effettuato le sue ricerche incrociando differenti varietà di piante di pisello e ha formulato tre leggi che regolano la trasmissione dei caratteri ereditari. Legge della dominanza quando si incrociano linee pure che differiscono per un solo carattere, nella nuova generazione (F1) si manifesta solo il carattere dominante. Legge della segregazione dei caratteri ereditari: incrociando individui F1 si ottengono individui della seconda generazione (F2) in cui i caratteri dominante e recessivo si manifestano secondo il rapporto costante 3 : 1.






















Legge dell’indipendenza dei caratteri: i caratteri sono trasmessi da fattori indipendenti l’uno dall’altro e si manifestano nei figli in combinazioni diverse da quelle dei genitori.
lezione 4 GENI E CROMOSOMI
I cromosomi sono filamenti di DNA che si trovano nel nucleo della cellula. I cromosomi omologhi sono cromosomi appaiati a due a due, uno di origine materna e uno di origine paterna: su ogni coppia si trovano geni simili, chiamati alleli, che contengono le stesse informazioni ereditarie. La combinazione degli alleli di un individuo determina il suo genotipo; l’insieme dei caratteri esteriori è il suo fenotipo. Un allele è dominante quando i suoi effetti mascherano gli effetti dell’allele corrispondente che, per questo, è chiamato recessivo. Il quadrato di Punnett è un diagramma che permette di determinare la probabilità con cui fenotipi e genotipi compaiono nella prole generata da un particolare incrocio.
lezione 5 LA GENETICA UMANA
La rappresentazione ordinata dei cromosomi è chiamata cariotipo. Le cellule somatiche umane contengono 46 cromosomi organizzati in 23 coppie di cromosomi omologhi; i gameti, invece, contengono solo 23 cromosomi, uno per ciascuna coppia di cromosomi omologhi, che si separano durante il processo di meiosi. I cromosomi sessuali sono l’unica coppia di cromosomi diversa nei maschi e nelle femmine. Un carattere controllato da una sola coppia di alleli è detto carattere mendeliano; quando più geni intervengono per determinare un carattere si parla di carattere poligenico. Mutazioni nel patrimonio genetico della cellula sono la causa delle malattie genetiche.
lezione 6 LE BIOTECNOLOGIE
Le tecniche di ingegneria genetica, intervengono sul DNA degli organismi per modificarne le proprietà naturali. La più diffusa è quella del DNA ricombinante: un gene che codifica per una specifica proteina è estratto e successivamente inserito nel patrimonio genetico di un batterio, che potrà produrre proteine non sue, come l’insulina. La clonazione è una tecnica di manipolazione genetica che, partendo da cellule di un individuo adulto, consente di ottenere dei cloni, organismi uguali tra loro e perfettamente identici a quelli di partenza.



CON LA MAPPA
Adesso che hai ripassato i contenuti essenziali con la sintesi, prova a completare la mappa con le parole chiave suggerite e a trovare le definizioni corrispondenti. basi azotate - cromosomi - DNA - legge della dominanza - geni - Gregor Mendel
1. LA TRASMISSIONE DEI CARATTERI
è stata studiata da avviene grazie alla
che ha formulato la
3. legge della segregazione dei caratteri ereditari
4. legge dell’indipendenza dei caratteri 2.
5.
che è il costituente dei

8.
che contengono le
6. duplicazione
9. informazioni genetiche del
all’interno dei
13. 10. 7.
a. Porzioni di cromosomi che contengono le informazioni genetiche.
b. È la prima legge di Mendel.
c. È lo zucchero del DNA.
d. È la terza legge di Mendel.
e. Sono formati da acido fosforico, base azotata e uno zucchero.










formato da due filamenti di

11. nucleotidi
che contengono
12. zucchero desossiribosio
14. acido fosforico
lezione 1 GLI ACIDI NUCLEICI: IL DNA
1 Segna con una crocetta se vero (V) o falso (F).
a. Le basi azotate sono sei.
b. L’adenina è la base complementare della timina.
c. Gli istoni compattano il DNA nella cromatina.
d. La duplicazione del DNA avviene durante la meiosi.
e. Durante la duplicazione del DNA possono avvenire delle mutazioni geniche.
2 Scegli la soluzione corretta.
a. La base complementare della citosina è: 1 adenina.
2 timina. 3 guanina. 4 uracile.
b. Durante la duplicazione, la formazione di un nuovo filamento di DNA avviene grazie: 1 all’enzima DNA polimerasi.
2 agli istoni.
3 alle basi azotate. 4 al cromosoma.
lezione 2 LA SINTESI DELLE PROTEINE
3 Sottolinea il termine corretto tra i due proposti.
a. Nell’RNA le basi azotate sono adenina, guanina, citosina e timina/uracile
b. Esistono 16/20 tipi di tRNA, uno per ogni amminoacido.
c. Quando la trascrizione/duplicazione è terminata, l’mRNA si stacca dal filamento di DNA che si chiude.
4 Scegli la soluzione corretta.
a. Lo zucchero contenuto nei nucleotidi dell’RNA è il:
1 ribosio.
2 desossiribosio.
3 fruttosio.
4 destrosio.
b. Il codice genetico è costituito da:
1 20 triplette.
2 22 triplette.
3 16 triplette.
4 64 triplette.

lezione 3 LE LEGGI DI MENDEL
5 Segna con una crocetta se vero (V) o falso (F).
a. Mendel è considerato il padre della biologia molecolare.
b. Il libro pubblicato da Mendel si intitolava Esperimenti sulle piante ibride
c. La tecnica dell’autoimpollinazione permette di creare linee pure.
d. La prima legge di Mendel si chiama legge dell’indipendenza dei caratteri.
e. La terza legge di Mendel si chiama legge della segregazione dei caratteri.
6 Scegli la soluzione corretta.
Il disegno rappresenta i risultati:
1 della prima legge di Mendel.
2 della seconda legge di Mendel.
3 della terza legge di Mendel.
4 dell’impollinazione incrociata.
lezione 4 GENI E CROMOSOMI
7 Scegli la soluzione corretta.
a. Un segmento di cromosoma nel quale è contenuta l’informazione per la sintesi di una particolare proteina si chiama:
1 istone.
2 acido ribonucleico.
3 gene.
4 cromosoma.
b. I geni simili che si trovano sui tratti corrispondenti dei cromosomi di ciascuna coppia sono:
1 i cromosomi omologhi.
2 i caratteri.
3 gli alleli.
4 gli istoni.
c. Il fenotipo è:
1 l’insieme delle caratteristiche osservabili di un individuo.
2 la combinazione di alleli che un individuo può trasmettere ai figli.
3 il numero di cromosomi di una specie.
4 il numero di nucleotidi di un filamento di DNA.
lezione 5 LA GENETICA UMANA
8 Osserva l’immagine.
Segna con una crocetta se vero (V) o falso (F).
a. L’allele dominante è B.
b. Gli individui BB e bb sono entrambi omozigoti.
c. Il fenotipo prevalente è quello con occhi azzurri.
d. I genitori sono entrambi omozigoti per il carattere colore degli occhi.
e. Il quadrato di Punnet rispecchia quanto previsto della seconda legge di Mendel.
9 Scegli la soluzione errata.
Il daltonismo:
1 è una malattia genetica autosomica.
2 è una malattia genetica portata dai cromosomi sessuali.
3 è una malattia causata da un’alterazione della retina dell’occhio
4 è provocato da un gene recessivo sul cromosoma X.
lezione 6 LE BIOTECNOLOGIE
10 Abbina i termini con la definizione corretta.
1. DNA ricombinante
2. Biotecnologie avanzate
3. OGM
4. Clonazione
5. Cellule staminali
a Prevedono l’intervento diretto sul DNA di alcuni organismi per modificarne le proprietà naturali.
b Organismo Geneticamente Modificato.
c Cellule non ancora differenziate, capaci di dare origine ai diversi tipi di tessuti che formano l’organismo.
d Tecnica usata per la produzione di molte sostanze utili, come l’insulina umana.
e Tecnica di manipolazione genetica che, usando cellule di un individuo adulto, consente di ottenere individui identici a quello di partenza.
1. 2. 3. 4. 5.
11 Sottolinea i termini errati presenti nel brano.
La replicazione è una biotecnologia che permette di ottenere animali di razza selezionata tutti con le stesse caratteristiche, che derivano dalla manipolazione genetica di una cellula uovo di un organismo adulto. Il dibattito questa tecnica di ingegneria etica di animali è acceso e delicato. Negli ultimi anni si è sviluppata la ricerca sulle cellule embrionali, cioè cellule non ancora differenziate, in grado di dare origine ai diversi tessuti dell’organismo.
VERSO L’ESAME: INTERPRETARE MODELLI E SPIEGARE
1 Illustra con un breve testo il processo rappresentato.


SPIEGARE UN FENOMENO
3 Osserva il disegno e metti nella sequenza corretta le fasi del processo rappresentato.
DNA polimerasi
METTERE IN ORDINE E SPIEGARE UN FENOMENO
nucleotidi
Molecola originale di DNA
DNA polimerasi
a. Un enzima rompe i legami tra le basi azotate complementari e separa i due filamenti di DNA, spostandosi lungo la doppia elica.


piante di linea






2 Osserva il disegno e descrivi le fasi dell’impollinazione incrociata.















b. Al termine della duplicazione si sono formati due nuovi filamenti, che si avvolgono a elica insieme al filamento stampo.
c. Le basi azotate che sporgono dai due filamenti servono da “stampo” per la formazione di altri due nuovi filamenti: i nucleotidi che sono liberi nel nucleo si appaiano con le basi complementari di ciascun filamento stampo.
d. Le due doppie eliche che ne risultano sono identiche e costituite da un filamento vecchio e uno nuovo.
e. L’enzima DNA polimerasi scivola lungo i due filamenti di DNA e lega tra loro i nucleotidi.








VERSO L’ESAME: COMPRENDERE UN TESTO SCIENTIFICO
4 Spiega il significato dei termini evidenziati nel brano.
Il messaggio dell’mRNA, scritto come sequenza di triplette, viene tradotto in una sequenza di amminoacidi, cioè in una determinata proteina. Ogni cellula contiene l’intero patrimonio
ibridi
pura
genetico, ma solo i tratti di DNA che servono alla cellula per la sintesi delle proteine sono trascritti nell’mRNA. Per esempio, il segmento che codifica per le proteine actina e miosina necessarie nella contrazione muscolare è trascritto solo nelle cellule muscolari.
RICAVARE INFORMAZIONI DALL’ANALISI DI UNO SCHEMA
5 Risolvi i seguenti problemi di genetica.
ELABORARE INFORMAZIONI DA UN TESTO
7 Leggi il brano
DNA SULLA SCENA DEL DELITTO
Nelle scienze forensi, si parla di DNA fingerprint, cioè dell’impiego del DNA come un tempo si utilizzavano le impronte digitali per valutare l’eventuale presenza di una persona sulla scena del delitto: il DNA può, per esempio, essere presente sulla scena del delitto nelle tracce di liquidi organici (come la saliva rimasta sui mozziconi delle sigarette). Queste tracce sono una buona fonte di cellule epiteliali o di globuli bianchi da cui è possibile estrarre il DNA.
a. Calcola le percentuali di fiori rossi che possono nascere dall’incrocio tra una pianta di linea pura “fiori rossi” e una di linea pura “fiori bianchi”. RR = rossi rr = bianchi
b. Calcola le percentuali di fiori rossi che possono nascere dall’incrocio di due piante ibride.
INTERPRETARE E COMMENTARE UN’IMMAGINE
6 La fotografia mostra una pianta di tabacco OGM, risultato dell’inserimento del gene della lucciola responsabile della bioluminescenza dell’insetto.
Rispondi alle domande.
a. Quali caratteristiche ha acquisito la pianta di tabacco?

b. Quale tecnica è stata usata per inserire il gene dell’insetto nel DNA del tabacco?
c. Per ottenere piantine di tabacco identiche a quella OGM si usa la clonazione: in che cosa consiste questa tecnica?
Per stabilire se due campioni di DNA appartengono alla stessa persona, la polizia scientifica fa riferimento a sequenze che variano da individuo a individuo, dette marcatori genetici, che sono tanto più simili tra loro quanto più due individui sono imparentati. Nella maggior parte dei casi, il DNA, appartenente a eventuali sospetti, è presente in quantità irrisorie e deve essere “amplificato”; in seguito, viene tagliato con particolari enzimi e i frammenti, disposti secondo la loro lunghezza, sono resi visibili e successivamente confrontati. L’attendibilità di questi test è molto elevata tanto che, statisticamente, si può dire che le probabilità di trovare due individui non imparentati che abbiano lo stesso profilo di DNA è così bassa che “la prova del DNA” è accettata come vera nel mondo giuridico e della scienza. In realtà, però, il metodo non è né infallibile né di facile applicazione; al momento della raccolta, infatti, può capitare di inquinare i campioni di DNA con DNA estraneo, vanificando i risultati del test.
Rispondi alle domande. Svolgi l’attività proposta, da solo o insieme ai tuoi compagni.
a. In che cosa consiste la tecnica del DNA fingerprint?
b. Che cosa sono i marcatori genici? Quale caratteristica presentano?
c. Perché si prelevano campioni organici sulla scena di un delitto?
d. Una persona può essere considerata sicuramente colpevole sulla base della prova del DNA?


REWILDING EUROPE: THE
lossario
TAUROS PROGRAMME
The auroch is the ancestor of all cattle and is a very important animal in the history of humanity. It played a vital role in European ecosystems but was hunted to its extinction in 1627. However, parts of its DNA are still alive and can be found in some ancient original cattle breeds “The Tauros Programme” wants to bring back the aurochs by carefully breeding its closest living relatives to create a similar wild animal again. Today strands of its DNA remain alive, and can be found in several ancient cattle breeds that continue to exist across Europe. In 2013, Rewilding Europe, together with the Dutch Taurus Foundation, began a programme to bring the auroch back to life. The aim of the Tauros Programme is to recreate an animal that went extinct a long time ago. The principal technique is “back-breeding”: by combining cattle breeds with desired characteristics, a bovine can be created with physical attributes, behaviour and genetics that are very similar to those of Europe’s original wild auroch.
Today, many old European cattle breeds still have genetic similarities to the auroch. Following the selection of six or seven of these breeds from an original list of more than 30, the first animals were purchased and transported to the Netherlands for breeding. Apart from natural breeding in social (family) groups, artificial insemination techniques are also used in the initial phase to accelerate the breeding process and enable highly specific genetic combinations. The breeding programme is founded on a broad, multidisciplinary scientific approach, including geneticists, ecologists, molecular biologists, archaeologists, archaeozoologists, historians, isotope experts, cattle experts and European cattle breeding organisations.
COMPREHENSION EXERCISES
Read the text and answer the questions.
a. Why is the auroch considered important?
b. When did the auroch become extinct?
c. How will scientists bring the auroch back to life again?
d. How many breeds have been selected for this project?



Pittura rupestre a Lascaux, in Francia.
Il DNA racconta il mondo

Lo studio della genetica non ha applicazioni solamente in biologia e in medicina, ma anche in molti altri ambiti, dalla storia, alla geografia, alla linguistica. La genetica delle popolazioni è cambiata nel tempo a causa di migrazioni, isolamento e altri eventi storici e geografici, e questo si collega alla linguistica poiché lo studio del DNA può rivelare legami tra gruppi di persone che parlavano lingue simili. Il percorso proposto intende focalizzare l’attenzione sulle molteplici applicazioni dello studio del DNA e di come anche l’alimentazione svolga un ruolo importante sul nostro patrimonio genetico.
PREREQUISITI
Conoscere la composizione degli acidi nucleici.
Descrivere le struttura del DNA.
Sapere che cosa sono i geni.
Spiegare di che cosa si occupa la genetica.
RISULTATI ATTESI
Conoscenza dei meccanismi epigenetici legati alla nostra alimentazione.
Comprensione delle ragioni delle migrazioni delle popolazioni umane.
Consapevolezza di come le lingue umane vengano influenzate dall’incontro tra i popoli.
RACCORDI interdisciplinari
Proponiamo alcuni approfondimenti che possono essere affrontati nel percorso interdisciplinare, ma la mappa suggerisce altri argomenti che possono essere sviluppati per integrare lo stesso percorso.
SCIENZE: l’espressione dei geni può essere modulata da sostanze che introduciamo con l’alimentazione.
ITALIANO: il DNA è un indizio delle contaminazioni linguistiche.
STORIA: l’analisi del DNA permette di ricostruire la storia delle popolazioni umane.
GEOGRAFIA: le migrazioni dei popoli.
IL CIBO ALLA BASE DEL NOSTRO BENESSERE
IL DNA E CONTAMINAZIONI LINGUISTICHE
L’ANALISI DEL DNA ANTICO
RIVELA MIGRAZIONI
FINORA SCONOSCIUTE
LE MIGRAZIONI NEL XX SECOLO
Il cibo alla base del nostro benessere
Mangiare bene non è solo nutrirsi, significa anche dialogare con il proprio DNA. Alcuni alimenti, infatti, influenzano l’attività dei geni: tè verde, broccoli, curcuma o soia contengono molte sostanze, come i polifenoli, in grado di attivare o bloccare l’attività dei geni, proprio come interruttori che
SCIENZE
ITALIANO
SCIENZE
GEOGRAFIA
STORIA

accendono o spengono la luce. Queste sostanze possono modulare gli enzimi responsabili della metilazione, un processo che regola l’espressione del DNA. Un gruppo metilico è una parte di una molecola di metano (CH4), formata da un atomo di carbonio (C) legato a tre atomi di idrogeno (H). La sua formula chimica è –CH3: si può immaginare come una specie di “tappo” chimico che può attaccarsi ad altre molecole, per esempio al DNA o a una proteina. Nel processo di metilazione il gruppo metilico si attacca al DNA e può cambiare il modo in cui il DNA viene letto, senza modificarne la sequenza. La metilazione è uno dei meccanismi alla base dell’epigenetica: essi non cambiano il codice genetico, ma ne guidano l’utilizzo, aiutando l’organismo a reagire meglio allo stress, a ridurre l’infiammazione e a rallentare l’invecchiamento. In questo modo, ogni scelta a tavola diventa una forma di comunicazione con il nostro DNA, un modo per proteggere l’organismo, mantenerlo in equilibrio e favorire il benessere nel tempo.
DOMANDE GUIDA
a. In che modo il cibo può influenzare il nostro codice genetico?
b. Come si chiamano i meccanismi che guidano l’utilizzo del DNA?
c. Che cos’è un gruppo metilico e da quali atomi è formato?
d. Che cosa succede quando un gruppo metilico si attacca al DNA?
e. Quali benefici porta la metilazione all’organismo?
Intelligenza Artificiale IA
Chiedi a un chatbot di spiegarti con parole semplici il significato di epigenetica.
STORIA
L’analisi del DNA antico rivela migrazioni finora sconosciute
Migliaia di anni fa, al termine dell’ultimo periodo glaciale, le popolazioni umane conobbero una grande mobilità, spostandosi in molte regioni del pianeta fino ad allora poco esplorate a causa delle temperature molto rigide. L’Asia centrale fu un crocevia importante per i transiti delle popolazioni umane da una parte all’altra dell’Asia e dall’Europa verso la Siberia. Grazie a tecniche di indagine del DNA, un gruppo di ricerca dell’Università di Tubinga, in Germania, ha analizzato il genoma, l’insieme di tutto il materiale genetico, di 10 individui di una popolazione di cacciatori-raccoglitori vissuti nella regione di Altaj circa 7500 anni fa. Lo studio ha dimostrato che gli Altaj si sono uniti con individui appartenenti a molte popolazioni presenti nello stesso periodo nell’Asia centrale e, successivamente, in tutta l’Asia settentrionale, dimostrando quanto fosse grande la mobilità di quelle comunità. Tutto questo suggerisce come le migrazioni e le mescolanze umane fossero la norma e non l’eccezione anche per le antiche società di cacciatori-raccoglitori.
DOMANDE GUIDA

a. Che cosa accadde al termine dell’’ultimo periodo glaciale?
b. Come vivevano le popolazioni di cacciatori-raccoglitori?
c. Che cos’è il genoma? In che cosa differisce dal DNA?
d. c. Che cosa ha dimostrato lo studio del genoma dei 10 individui appartenenti alla popolazione Altaj?
DIGITAL SKILLS PER APPROFONDIRE
Utilizza l’app di Google Earth per localizzare la regione dell’Altaj e tutti i paesi a cui oggi appartiene.
Ricerca informazioni in rete sulla Repubblica dell’Altaj.
Coordinamento redazionale: Marco Mauri
Responsabile editoriale: Martina Mirabella
Redazione e revisione scientifica: Martina Mirabella, G.E.M.
Art director: Enrica Bologni
Revisione linguistica: Lisa Suett
Progetto grafico e impaginazione: G.E.M.
Copertina: G.E.M.
Ricerca iconografica: Martina Mirabella, Paola Bollani
Disegni: Daniele Gianni
Immagini di copertina: Shutterstock
Si ringrazia Federico Zanni per la collaborazione redazionale.
Referenze iconografiche: Shutterstock, Alamy
Tutte le altre immagini provengono dall’Archivio Principato-Gruppo Editoriale ELi. Per le riproduzioni di testi e immagini appartenenti a terzi, inserite in quest’opera, l’editore è a disposizione degli aventi diritto non potuti reperire, nonché per eventuali non volute omissioni e/o errori di attribuzione nei riferimenti.
Font: leggimi©Sinnos - www.sinnos.org
Contenuti digitali: bSmart labs
Prima edizione: gennaio 2026
Printed in Italy
RINGRAZIAMENTI
Per la collaborazione alla realizzazione della rubrica
Le professioni del tuo futuro si ringraziano: Sarah Caronni, Sara Castellazzi, Angela De Bonis, Francesco Delvillani, Fabio Mologni, Giacomo Rosa, Noemi Rota, Lisa Marie Talia, Roberta Tota, Jacopo Zasso.
© 2026 - Proprietà letteraria riservata. È vietata la riproduzione, anche parziale, con qualsiasi mezzo effettuata, compresa la fotocopia, anche ad uso interno o didattico, non autorizzata. Le fotocopie per uso personale del lettore possono essere effettuate nei limiti del 15% di ciascun volume dietro pagamento alla SIAE del compenso previsto dall’art. 68, commi 4 e 5, della legge 22 aprile 1941 n. 633. Le riproduzioni per finalità di carattere professionale, economico o commerciale o comunque per uso diverso da quello personale, possono essere effettuate a seguito di specifica autorizzazione rilasciata da CLEARedi (Centro licenze e autorizzazioni per le riproduzioni editoriali), corso di Porta Romana 108, 20122 Milano, e-mail autorizzazioni@clearedi.org e sito web www.clearedi.org.
L’editore fornisce – per il tramite dei testi scolastici da esso pubblicati e attraverso i relativi supporti nel sito www.gruppoeli.it materiali e link a siti di terze parti esclusivamente per fini didattici o perché indicati e consigliati da altri siti istituzionali. Pertanto l’editore non è responsabile, neppure indirettamente, del contenuto e delle immagini riprodotte su tali siti in data successiva a quella della pubblicazione, dopo aver controllato la correttezza degli indirizzi web ai quali si rimanda.
Principato, Gruppo Editoriale ELi www.gruppoeli.it Viale E. Jenner 17 - 20159 Milano e-mail: info@gruppoeli.it
La casa editrice attua procedure idonee ad assicurare la qualità nel processo di progettazione, realizzazione e distribuzione dei prodotti editoriali. La realizzazione di un libro scolastico è infatti un’attività complessa che comporta controlli di varia natura. È pertanto possibile che, dopo la pubblicazione, siano riscontrabili errori e imprecisioni. La casa editrice ringrazia fin da ora chi vorrà segnalarli a: Servizio clienti Principato-Gruppo Editoriale ELi e-mail: info@gruppoeli.it
Stampa: Tecnostampa - Pigini Group Printing Division - Loreto - Trevi 26.85.008.0